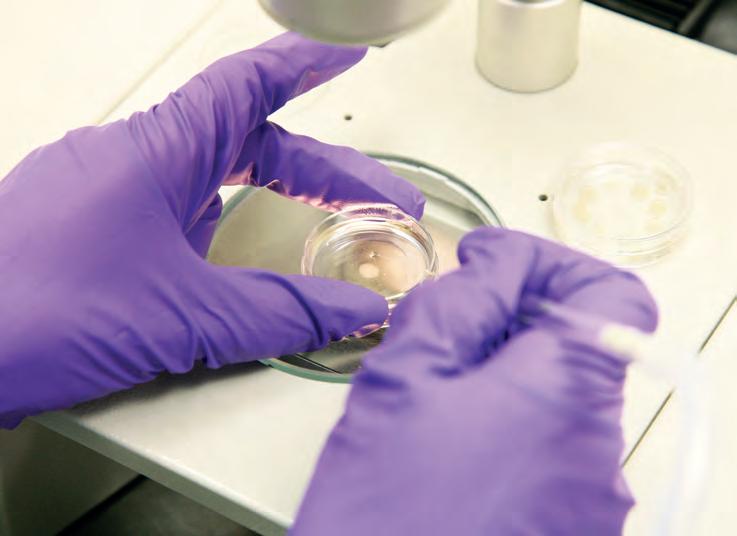

![]()














Belgian Research in Europe
R&D, Technology, Innovation
Editorial and Administration
Rue de la Presse, 4 B-1000 Brussels
Tel : +32 (0)2 882 81 00 E-mail: redaction@publicommb.com
Publication Manager
Georges FRANCO
Editorial co-ordination
Carine CHEVAL
Journalists
Carine CHEVAL, Koen MORTELMANS
Impression / Printing
Publisher






Health research, circularity and social innovation are major strengths in the Brussels region
An interview with Mrs Barbara TRACHTE, Secretary of State for the Brussels-Capital Region,
An interview with Ms Julie LEROY, President of the Science Policy Council of the Brussels-Capital Region (CPSRBC), Innovation expert at Agoria 80
Stimulating scientific excellence and pioneering ideas
An interview with Dr Marius GILBERT, Vice-rector for research and development, ULB
Probing the universe at the largest and smallest scales
An interview with Prof. Barbara CLERBAUX, Professor, FNRS Research Director (emeritus), Director of the Elementary Particle Physics Department at the ULB Faculty of Science


Encouraging research and innovation for a society in transition
An interview with Mr. Stefaan SONCK THIEBAUT, Managing Director of Innoviris 84-85
Vrije Universiteit Brussel (VUB) Multidisciplinary
A widely recognized expertise in interdisciplinarity An interview with Prof. Isabelle HACHEZ, Vice-rector of UCLouvain Saint-Louis Bruxelles
Innovative Approaches in Radiation Oncology: The Promise of FLASH Therapy at the Brussels University Hospital By Dr. Sébastien PENNINCKX, Head of Preclinical Radiobiology Research Unit, Radiotherapy and Medical
Investing in strategic sectors such as the energy transition, digital technologies, health and industry
An interview with Mr Pierre-Yves JEHOLET, Vice-Chairman and Walloon Minister for the Economy, Industry, the Digital
Wallonia: a region where research is growing
An interview with Mr Jean-François HEUSE, Public Service of Wallonia Economy, Employment, Research, Department of Research and Technological Development
Restructuring, simplifying and adding value to boost R&D&I in Wallonia Interview with Mr Jean-François DELAIGLE, President of the Science Policy Pôle (PPS), Wallonia
ISSeP - Scientific Institute of Public Service £Supporting Wallonia’s ecological transition
interview with Mrs Rose DETAILLE, Managing Director of ISSeP
opportunities: the services of NCP Wallonia 106-107
Focusing on international technological missions and sustainable transition
An interview with Ms. Pascale DELCOMMINETTE, CEO, Wallonia Export & Investment Agency (AWEX) and Wallonie-Bruxelles International (WBI)




Wallonie Entreprendre, a key partner in the regional strategy for Life Sciences
Innovation, an essential lever for the redeployment of Wallonia
An interview with Mr Pierre MOTTET, President of AKT for Wallonia
BioWin: Growing a vibrant life sciences and health ecosystem in Wallonia An interview with Mrs Sylvie PONCHAUT, Managing Director of the BioWin health cluster
GSK - Science, technology and talent come together to deliver the vaccines of tomorrow
CODIBEL: a leader in conscious beauty and sustainability in health and beauty products
GIGA - Advanced medical solutions for research and health
Combating emerging strains resistant to antifungal treatments
An interview with Prof. Marie-Pierre HAYETTE, ULiège Faculty of Medicine, Department of Biomedical and Preclinical Sciences, Bacteriology, Mycology, Parasitology, and Virology, Interdisciplinary Drug Research Centre (CIRM) 126
Promising solutions for treating patients suffering from oncodermatology
An interview with Prof. Dr. Arjen F. NIKKELS MD, PhD, ULiège Faculty of Medicine, Department of Clinical Sciences, Department of Dermatology and Vererology 127 Dendrogenix - Addressing unmet medical needs in neurology
CM4CURE: We develop new high-efficiency antimicrobials combined with advanced polymer chemistry for simultaneously preventing thrombotic and infectious complications of coated medical devices 130-131
Department of Clinical Psychology of Delinquency - ULiège Human and Psychological sciences at the service of public policy
Research Unit for a life-Course perspective on Health and Education - RUCHE - ULiège A wide range of expertise for different care perspectives 134
Mass Spectrometry Lab (MSLab) - ULiège A unique expertise in Mass Spectrometry and Optical Spectroscopy 135
Center for Education and Research on Macromolecules - CERM Polymers to serve health and environment 136-137
Chemical Engineering Research Unit Liege University - ULiège Working towards sustainable transformation processes 138-139


Laboratory of Medical Chemistry - ULiège Towards a better understanding of tumour development in the intestine 140-141
NanoChem group - ULiège
A pioneer in single-molecule force spectroscopy and mechanochemistry on small synthetic molecules
A better understanding of the mechanisms of inflammatory and locomotor pathologies in horses
An interview with Prof. Didier SERTEYN, Faculty of Veterinary Medicine, ULiège, Equine Teaching and Clinical Department (DCE), Equine surgery, FARAH: Comparative Veterinary
Group of Research and Applications in Statistical Physics (GRASP) - ULiège The unsuspected applications of soft matter
CiTOS & FloW4all - Micro- and mesofluidic processes for organic synthesis
GreenWin, the Walloon Innovation Cluster for CleanTech, chemical engineering and sustainable / ecoresponsible construction materials
An interview with Mr Dominique PIERARD, Managing Director (a.a.) of the GreenWin
CAP Construction - Technological innovations for more collaboration and integration
Renovating buildings while reducing the environmental footprint of the construction sector
An interview with Mrs Anne-Michèle JANSSEN, Director of the Eco-construction Cluster 155
Digitisation of companies for the benefit of Walloon competitiveness An interview with Mr. Jean-Philippe PARMENTIER, Director of the INFOPOLE ICT
An interview with Mr. Bernard PIETTE, Managing Director of Logistics in Wallonia
The MecaTech cluster: a link between innovative Walloon SMEs and European innovation ecosystems
An interview with Mr. Anthony VAN PUTTE, Managing Director of the MecaTech cluster 160-161




Skywin: Taking on a new dimension
An interview with Mr. Étienne POURBAIX, Managing Director of the Skywin competitiveness cluster And Mr. Stéphane GUALANDRIS, Project Manager at Skywin
Centre Spatial de Liège – CSL – Liège Space Centre
the production and use of sustainable energy
An interview with Ms. Louise SAMAIN and Mr. Renaud DACHOUFFE, Project
Fundamental strategic research in the service of health and sustainable transition
An interview with Mrs Vinciane GAUSSIN, Managing
Innovation and research excellence in relation to transition and service to society
An interview with Prof. Françoise SMETS, Rector
UNamur, a comprehensive University with interdisciplinarity as its DNA in research By Prof. Carine MICHIELS, Vice-Rector
Wagralim: Innovation and collaboration for the Walloon agri-food industry
An interview with Mr Emmanuel VANZEVEREN, Co-Director of Wagralim

An interview with Mr Thomas DERMINE, State Secretary for Economic Recovery and Strategic Investments, Science Policy, attached to the Minister for the Economy and Labour
What are Belgium’s strengths in terms of R&D?
By 2022, Belgium’s investments in R&D have reached 3.43% of its GDP, putting it in the lead in the EU, and just behind Israel, South Korea, Taiwan and the United States worldwide. This success is the result of great public investment and the efforts of businesses. It is also based on a strong belief, shared by public and private players, that these investments improve the quality of life and create meaningful jobs.
Belgium has positioned itself as a competitive player in the biopharmaceutical sector, being the world’s third largest exporter with an annual export amounting to €78 billion in 2023. The sector employs more than 40,000 people directly, with an even more substantial indirect impact. Collaboration between industry and the public sector is a key s- factor for success, and the RFF plan has allowed us to make progress on a number of projects such as VirusBank and the ehealth platform. We have also supported the BiotechValley of the Future initiative to strengthen our position in biopharmaceutical R&D and production.Every year, my administration approves hundreds of research projects, attracting talent and companies to the pharmaceutical sector in Belgium.


Last May, the federal government earmarked more than €4 million for the preparatory phase of the Einstein telescope project. Can you tell us more about this?
Belgium, the Netherlands and North Rhine-Westphalia are jointly preparing their bids to host the Einstein Telescope in the tri-border region. The budget set aside by the federal government is financing geological feasibility and civil engineering studies, as well as preparing the legal, environmental and international communication aspects.The engineering and environmental studies are progressing well, and the initial geological results are promising. This will pave the way for the next government’s decision on the feasibility and cost of this infrastructure.
Signed last April, the Belspo/Defence protocol earmarks €100 million for the development of dual-use applications for ESA space programmes. What applications exactly?
Dual-use applications in the space sector cover a wide range of fields, such as earth observation and space safety, which have been selected as the main areas of focus by Belgian Defence. The first activities consist of defining the future space missions of the Belgian Defence and identifying the necessary technologies, such as artificial intelligence, microelectronics and radar and optical imaging. This collaboration with Defence is enabling Belgium to remain a major contributor to ESA, despite budgetary constraints.
How would you assess your policy of renovating and redeploying museums?
The Belgian and international public continues to visit the federal scientific establishments, but the infrastructures of certain museums, with the exception of the Royal Museum for Central Africa, have not been renovated for 25 years. Since the beginning of the legislature, we have launched renovation projects to revitalise federal museums,
such as the upgrading of the Parc du Cinquantenaire and the renovation of the Royal Museums of Fine Arts of Belgium. I can also mention the recent partnership with local actors in Brussels aiming at converting the Porte de Hal / Hallepoort into a hotspot for intangible cultural heritage.These initiatives aim to preserve our heritage and attract new visitors. Museums are places for reflection and debate on identity and cultural diversity, playing a crucial role in education and social cohesion.
What strategy should be put in place in the next legislature to enhance the value of science policy?
We must continue to invest in science policy, with a 2024 budget of €630 million, including €250 million for the ESA. Our space strategy must be one of continuity, as Belgium is a key player in the ESA. Our investments guarantee a fair return for our companies and strengthen our position in the international space ecosystem. We must also continue our efforts to develop STEM (science, technology, engineering and mathematics) fields. Future generations will need to be well equipped to meet the challenges of tomorrow, and the State has a role to play. Initiatives such as the Bing Bang conferences have already produced encouraging results, particularly in encouraging young girls to take up technical and scientific subjects. This is an important step towards a more egalitarian society, and science, like culture, is a driving force for change.I hope that the next government will continue the efforts already underway to strengthen our space ecosystem and encourage high added-value R&D activities.

Accurate species identification of biological material is required to assess and understand biodiversity and ecosystems but also to, for example, implement animal and plant (including wildlife) trade regulations, prevent infectious disease outbreaks, screen the food chain, or deploy agricultural pest control programs. In response to the recurrent societal need for reliable species identifications of biological specimens and products of socio-economic relevance, the Belgian Science Policy (BELSPO) has been supporting and financing two initiatives which are carried out by two Federal Scientific Institutions (FSIs), the Royal Belgian Institute of Natural Sciences (RBINS) and the Royal Museum for Central Africa (RMCA).

BopCo, the Barcoding Facility for Organisms and Tissues of Policy Concern was established in 2015 within the framework of the EU RI LifeWatch. Recently it evolved into a BELSPO-financed Centre of Expertise: BopCo-CE. BopCo-CE aims at identifying biological material like Invasive Alien Species, CITES-listed species, agricultural and horticultural pest species, human and veterinary disease organisms (including parasites) and their vectors, organisms of the food chain, species of forensic interest, quarantine species, indicator and sentinel species (e.g., ecotoxicological test species), species of hygienic concern, species of pharmaceutical importance, species with economic impacts, species that damage or pose risks to human infrastructures and activities, beneficial species (e.g., biological pest control, pollinators), and others of societal relevance.
ENFORCE is a new Belgian Centre of Expertise for forensic wood research established in 2022. The forensic wood centre is part of the BELSPO relance and transition program to strengthen federal scientific research capacity. It is based at the RMCA and its main objective is to provide scientific support in the combat against illegal timber trade. As about one third of all commercial tropical timber enters the European Union through Belgium, such a centre was deemed essential in order to allow companies, NGOs and government agencies to check the correct species and origin of wood and wood products.
As BopCo-CE and ENFORCE are based at RBINS and RMCA, they have access to a broad taxonomic expertise, international networks, methodological know-how and scientific infrastructure for species identifications, including fully equipped DNA and microtome

laboratories, (stereo)microscopes, Scanning Electron Microscopes, DART-TOFMS spectrometry, µCT scanners, huge natural history collections like the internationally important xylarium (wood collection), high-resolution photographic equipment, and extensive libraries. In this way, species identifications can rely on morphology-based taxonomic know-how and unique specimen collections available at both FSIs in combination with DNA-based methods and a network of external experts. DNA-based methods are especially useful when morphological identifications are difficult or impossible (e.g., early life stages, processed food items, cryptic species, degraded or fragmented specimens). Apart from classical wood anatomy, ENFORCE is equipped with the first Belgian DART Time-Of-Flight mass spectrometer. This method reveals the chemical fingerprint from a single sliver of wood. The combination of both methods often permits to upgrade identifications up to the species level, which is particularly important for casework dealing with CITES-listed species.
Since their establishment BopCo-CE and ENFORCE have grown significantly in numbers of users, partners and portfolio of expertise, techniques and offered services. In order to further strengthen and expand their capacity to offer customer-oriented and up to date species identification services, they need scientific support through the development and exploration of novel methodologies to identify organisms and derived products or to trace the origins of biological materials, i.e. to act as a wildlife forensics service in the broadest sense. For BopCo-CE this scientific support is provided by JEMU, the Joint Experimental Molecular Unit. JEMU is a BELSPO-financed unit that started in 2007 and that is shared by RMCA and RBINS. It aims at conducting and supporting fundamental and applied scientific research in the fields of molecular systematics, i.e. phylogeny,

phylogeography, DNA barcoding, species delimitation and population genetics, with a particular focus on the use of old DNA and the valorisation of natural history collections for this type of research. As such, JEMU and BopCo-CE go hand in hand, with JEMU conducting innovative, fundamental and society relevant molecular systematic research, the results of which are used by BopCo-CE to provide species identification services. ENFORCE currently has an internal research component that focuses on improving and combining the routine techniques used in service delivery, as well as exploring new identification techniques for analysing wood-based products such as fibreboard, plywood or charcoal, rather than solid timber samples.
The growing demand for reliable species identifications drives BopCo-CE, JEMU and ENFORCE to foster new scientific opportunities and to expand (inter-)national collaborations and partnerships. In view of these common challenges and policies, and given their similar aims and scientific complementarity, it has been decided to coordinate the activities of the three entities under a common umbrella. As such, the research strategies and operational plans of RBINS and RMCA have been aligned with respect to the development of a joint Centre of Excellence on Species Identification and Molecular Taxonomy. Such a joint centre will facilitate access to, and visibility of, the expertise, facilities and services that BopCo-CE, JEMU and ENFORCE and their host institutions can offer. As a first step, the synergy between the identification services of BopCo-CE and ENFORCE, as well the activities of JEMU, are advertised via a joint website presenting the Belgian network for species identification services, “speciesID”: https://speciesid.be
A further integration of BopCo-CE, JEMU and ENFORCE, will be realized by a formal Memorandum of Understanding between RBINS and RMCA and through the development of a joint workplan. Regarding the latter, against the increasing recurrent need for species identifications, the objectives within this workplan are centred along three inter-related axes (i) the exploration and implementation of new species identification tools resulting from recent technological innovations (e.g., eDNA, Next Generation and Oxford Nanopore Sequencing, qPCR, AI-driven identification tools to screen timber
shipments using portable equipment), (ii) the development of a comprehensive federal unit covering the identification of a broad range of policy concern organisms through a synergistic and collaborative work with other institutional units providing complementary identification services and building new or expanding existing reference databases to compare incoming cases against them, and (iii) the upgrading of the virtual and physical communication tools (e.g., renewed website, folders, social and public media, participation in scientific conferences and outreaching events).
Altogether, the establishment of the joint Centre of Excellence on Species Identification and Molecular Taxonomy will not only provide the various governmental, regional and public stakeholders with a more versatile and customer friendly service to deal with societal challenges, policies and actions, but will also allow for a stronger scientific synergy, increased visibility and a more structural future sustainability of the consortium

On December 5 2024, the two PROBA-3 satellites were launched into space from the eastern Indian coast. It marks the end of a very complex development that started 21 years earlier, mainly in Belgium and Spain. During the next two to three years, the two satellites will demonstrate precise formation flying, and at the same time observe unexplored regions of the solar corona with unprecedented precision.
Duringthe nineties of the previous century, a small company near Antwerp started for the first time to work on the development of a Belgian-made satellite in the context of the ESA technology programmes. It was called PROBA (Project for On-Board Autonomy) and contained a highly innovative avionics system controlled by a powerful new type of on-board computer, and a new generation of on-board software. Launched in 2001, it is still functioning and is the longest surviving ESA satellite, thereby convincingly proving its exceptional reliability. The first one having been baptised PROBA-1, PROBA-2 followed in 2009 and PROBA-V followed in 2013, and both are also still operational today.
Shortly after the initial success of the first PROBA satellite in orbit, the idea emerged to develop a new double PROBA satellite aimed at demonstrating precise formation flying in space. The potential applications of formation flying are numerous, ranging from satellite
in-orbit servicing to precise gravitational measurements and to telescopes with large focal length. But the realisation of another promising application provided a breakthrough in defining the PROBA-3 concept: if one satellite could block the bright light coming from the solar disc, a second one at some large and precisely controlled distance away can observe the solar corona down to much closer distances to the solar disc than can be done with a single and therefore much shorter telescope. The reason is that avoiding straylight caused by diffraction off the occulter’s edges is paramount during observations because the corona is so faint. And the further away the occulter is from the coronagraph that measures the light, the less straylight reaches the instrument. A large distance between the occulter and the observer thus minimises straylight, allowing the scientists to obtain more precise measurements and observe closer to the solar disc where all the disturbing light comes from.

Why is it important to observe the solar corona? Because the corona of the Sun is a very intriguing place which interests us from two perspectives. First, while the temperature of the solar disc is ‘only’ 5800°C, the corona is heated up to a few million degrees. We know it extends a few million kilometres in outer space and that it is composed of a thin plasma of material ejected from the Sun. However, we don’t know which mechanism causes the coronal heating, except that magnetic fields must play a role and that the heating happens in the inner corona, close to the solar disc. We also know that the acceleration of the solar wind, which fills the entire Solar System, originates in the corona, but the exact physics behind this process remains unclear. In summary, studying the inner corona is crucial for understanding how our Sun works.
The second reason why the corona is so important is related to our own safety on Earth. The inner corona is where solar eruptions occur, ejecting radiation and energetic particles that regularly reach the Earth’s atmosphere. Scientists call this phenomenon ‘Space Weather’ and it poses a threat to sensitive technologies in space, astronauts’ safety, navigation and telecommunication accuracy, power grid operations, etc. To protect ourselves from these dangers, we need to be able to predict these eruptions as early as possible and since they originate in the inner corona, it is there that we must point our telescopes.
The PROBA-3 concept is therefore an ideal tool to learn more about how our Sun works and to predict Space Weather phenomena more timely. Additionally, it allows ESA to demonstrate its expertise in
precise formation flying technologies. And the latter is not an easy job. The two satellites will be at a distance of 150 metres from each other, and their relative position needs to be maintained in longitudinal and lateral directions with an accuracy of a few millimetres. To achieve this, PROBA-3 is equipped with a laser and a shadow metrology system with mm accuracy, as well as a high precision propulsion system capable of rapidly and precisely correcting the unavoidable drift of both spacecrafts as they orbit Earth. All this must be controlled in real time by a powerful on-board computer and associated efficient software. The launcher rocket placed PROBA-3 in a highly elliptical orbit, ranging from 600 to 60000 kilometres distance from Earth, and with a period of almost 20 hours. Formation flying will only take place during the furthest distances from Earth where the disturbing gravity gradient is smallest. Both spacecrafts will autonomously acquire their formation flying positions every 20 hours and maintain it during 6 hours.
The PROBA-3 satellites are of the ‘minisat’ type, with a rectangular shape measuring about 2 metres in diameter and each satellite weights about 250 kilograms. The development of PROBA-3 was in the hands of a consortium of companies, led by the Spanish company SENER. Key contributions to the platforms came from the Belgian companies Redwire Space and SPACEBEL and from the Spanish companies Airbus and GMV. The coronagraph instrument (called ASPIICS) is a purely Belgian endeavour, built by an industrial consortium led by the Centre Spatial de Liège (CSL) and scientifically led by the Royal Observatory of Belgium (ROB). The latter will also be responsible for the science operations during the two years nominal lifetime of the mission. The Mission Operations Centre is located in the ESA site of ESEC (European Space Security and Education Centre) in Redu in Belgium, specialised in the operations of small satellites.

© The European Space Agency (ESA)
In addition to the main coronagraph, PROBA-3 also embarks two additional scientific instruments. The first is 3DEES (3-Dimensional Energetic Electron Spectrometer) which will measure the amount of energetic particles and their incoming direction as they are ejected by the Sun and arriving in our neighbourhood. It was designed by researchers of the University of Louvain-la-Neuve and built by Redwire Space together with the Belgian Institute for Space Aeronomy in Uccle. The second instrument is DARA (Davos Absolute Radiometer). It will continuously measure the total amount of energy from the Sun reaching the Earth, also known as the ‘total solar irradiance’. This quantity, and especially its variation in time, is an essential ingredient in climate studies. The instrument was designed and built in Switzerland but Belgian researchers from the Royal Meteorological Institute will also have access to the data.
This is in a nutshell the exciting PROBA-3 story, but nothing comes for free. The total cost of PROBA-3 amounts to 166 million euro, of which Belgium paid 63.4 million. This budget, as well as the PROBA-3 administrative management at Belgian level, was provided by the Federal Science Policy Office (BELSPO), and was implemented through two ESA Programmes: GSTP (General Support Technology Programme) and PRODEX (Programme for the Development of Scientific Experiments). Going to space is not cheap, but once you are there, the laboratory you have access to is unique and allows breakthroughs in science and technology that can never be achieved from the Earth’s surface. Go PROBA-3!
What are Sciensano’s key figures?
In 2023, Sciensano had 937 employees, including 500 scientists, 158 laboratory technicians and 175 support staff. We had 103 peer-reviewed publications (type A1) and 109 scientific reports (type E publications), 8 doctoral theses defended and 98 doctorates in progress. We have worked on 152 scientific projects in collaboration with more than 40 universities, around twenty scientific institutes and more than 60 public organisations. 450 contracts were drawn up or reviewed. In addition, our monitoring mission resulted in almost 150,000 analyses being carried out for around 1,300 different customers. Finally, nearly 150 of our researchers are working on our ‘One Health’ focus and its 8 themes: antimicrobial resistance, vector-borne diseases, respiratory diseases, food-borne pathogens, the multiple exposure or ‘exposome’, monitoring zoonoses, climate & health and innovative and generic One Health approaches.
What are your main areas of expertise?

We coordinate the infectious disease surveillance networks, which continuously report the incidence of a range of human and animal pathogens. We also monitor non-communicable diseases, focusing on the ‘Quintuple Aim’ (improving health at population level, quality of care, efficient use of resources, well-being of care providers, accessibility for everyone), and biological, chemical and physical health risks.
Could you give us a few examples of the research projects currently underway at Sciensano?
Our research projects illustrate the important role played by science and research at Sciensano. For example, ADD4KIDS (2024-2025) aims to accelerate demand-driven tools for the uptake of paediatric innovations in Europe, EUVABECO (2024-2026) focuses on vaccination in Europe beyond COVID-19, OriON (2024-2025) is a joint action on contributing to the cancer inequalities register for monitoring national cancer policies, HYPIEND (2024-2028) seeks to understand

and prevent the impact of endocrine disruptors on the hypothalamus-hypophysis axis in sensitive populations, while JA PreventNCD (2024-2027) is a joint action on the prevention of cancer and other non-communicable diseases (action on health determinants).
Could you tell us about the Health Status Report? How does Sciensano’s work help to improve healthcare and public health?
Sciensano is mainly directly active in the field of public health through its multidimensional surveillance activities. In addition, the Health Status Report takes stock of the population’s health approximately every four years through the Belgian Health Survey. It enables the authorities (political or administrative) to take the most appropriate measures on the basis of robust and recent data. It looks at health inequalities and lifestyle (alcohol, smoking, physical activity, etc.). The data can also be used to check whether measures have had a ‘supposed’ impact. We are also conducting a survey of food consumption, the results of which are expected to be used to take measures to improve the eating habits of Belgians. A recent report commissioned by Flanders also highlighted food swamps (the ‘unhealthy’ nature of the food environment based on the density of outlets selling ‘unhealthy’ food) and food deserts (no supermarkets within 1,000 metres and no bus/tram stops within 500 metres). It has been well documented that this food environment plays a role in diet, and therefore in overweight and obesity, and consequently in health. What’s more, the areas with the lowest socio-economic status are also the worst off in terms of the food environment and in terms of publicity for fast-food products, reinforcing the health inequalities identified in the Belgian health survey. Our action therefore has an indirect impact on healthcare, as our advice and recommendations will mainly concern the prevention of health problems and the promotion of good health. In the field of healthcare, we control the quality of vaccines and blood products before their marketing and we monitor the quality of supplied batches of medicines and the services provided by clinical biology laboratories.


Could you remind us of the NIHDI’s mission and key figures?
The NIHDI is a key player in the Belgian social security system. We manage the public and national pole of health care insurance and indemnity insurance related to temporary or long-term work incapacity due to a non-occupational disease or accident.
In 2024, the budget for health care insurance was more than 42 billion euros and that for indemnity insurance almost 15 billion, making these two insurance policies the second and third largest social protection items after pensions. These budgets allow for the integration of useful innovations to benefit patients and companies.
By providing qualitive and accessible care, we reduce the risks of disability or mortality. For patients in the labor active age this means that we support them in returning to the labor force once dropped out. This supports our economic model, which in turn feeds social security. A win-win situation between social protection and economic development.
What developments in terms of obesity care?
In 2023, a first step to address childhood obesity was realised through an outcome-based stepped care model on the 3 levels of care, with regular follow-up. As a first phase, we have provided for the pooling of expertise with specialised care through the establishment of about 20 Paediatric multidisciplinary obesity centres where children aged 2 to 17 with obesity can receive outpatient and multidisciplinary care. In addition, we expanded the existing rehabilitation nomenclature concerning dietetics and abolished the co-payment for these services, thereby increasing access to care for these children in the first line as well. In a second phase, the first level should be further developed, which will include efforts to provide specialised care closer to home.
Vulnerable families are a focus here. This second phase is currently being developed with the federated entities within the framework of integrated care.
What developments in terms of drugs reimbursement?
Since 2022, we have been developing an innovative policy on medicines to guarantee sustainable access to high-quality pharmaceutical specialities.
The main goal of the various changes is to:
• provide faster access to innovative care with (potential) added value;
• implement a more demand-driven reimbursement process;
• implement a better assessment of added value and scientific evidence;
• streamline, simplify and increase the efficiency and transparency of procedures;
• consider new developments in the European policy on medicines;
• increase patient involvement;
• allocate public resources in a more goal-oriented and efficient way;
• mobilise government agencies in a goal-oriented and efficient way, and enable cooperation between them, if possible also with stakeholders from outside the public sector.
What is the NIHDI’s role in the Belgian Presidency of the Council of the EU, the ministerial meeting OECD and the WHO Novel Medicines Platform?
The NIHDI focused on responding to the Presidency’s agenda in the field of health and social protection. Thematically, we have taken charge of issues relating to social protection, in particular health professionals in Europe, access to care, antimicrobial resistance, unmet needs, and digital health literacy. We have taken part in preparatory works such as workshops on these issues which were then debated during the Presidency’s meetings, conferences and events. We have also played an active role in some events, with thematic contributions and interventions at conferences or meetings. Finally, we have contributed to communication at events organized during the Presidency.
Through the Minister of Health, Belgium was the chair of the OECD ministerial meeting of January 2024 in Paris. We closely worked with the OECD Secretariat, the Policy Unit and the FPS Health and Social Security to support and prepare the meeting.
NIHDI chairs the Working Group 1 “Transparency” of the WHO Novel Medicines Platform launched in December 2023. In this capacity, we participated in the consensus-building meeting held in July 2024 in Copenhagen, where overall progress and technical proposals were presented and discussed.

How does the FAMHP, as regulatory agency, facilitate research and development in Belgium?
As the CEO of the FAMHP, I can confirm that our agency is committed to making safe and effective innovative therapies available to patients and healthcare professionals in a timely manner. We offer an attractive environment for clinical trials by maintaining short timelines for mononational phase I trials and taking a leading role in an important part of the multinational clinical trial procedures. We aim to keep in direct contact with the stakeholders and informing them when needed. We furthermore are investing a lot in our European commitment, as stakeholder for initiatives to keep Europe attractive for conducting clinical trials.
Another important aspect is that before the submission of a clinical trial procedure, all sponsors can request scientific and technical/regulatory advice (STA) for medicinal products, drug-device combination products, in vitro diagnostics (IVDs), as well as blood, cells and tissues through our National
Innovation Office and Scientific Technical Advice Unit. For medical devices this service has been available since 1 January 2025. In specific cases of national STA, we foresee active patient expert engagement to ensure that innovative medicinal products and healthcare products that are being developed, would address the most relevant patient needs and that the clinical research conducted, would generate maximum outcomes.
The FAMHP is also actively involved in the simultaneous national scientific advice pilot procedures which offer joint scientific and regulatory advice from different authorities at an early stage of development and at the same time, optimising the quality and consistency of the advice. Our agency has handled 22% of those requests in Europe as lead national competent authority and 22% as participating authority. We also participate in a pilot project for multinational regulatory advice just before the submission of a clinical trial, providing advice from the member states concerned in the clinical trial.
Through active participation in the European innovation network and in EU funded projects initiatives, we specifically support small and medium enterprises and academia. We offer 75% fee reductions for small and medium enterprises, academia seeking national STA and a full fee waiver for national STA requests in relation to future clinical trials to be conducted in Belgium. Additionally, the FAMHP is also actively involved in the ACT EU initiative which aims to facilitate and accelerate large, multinational clinical trials across Europe.
To ensure that the patients have continued access to the medicines, after clinical trials have ended and while awaiting the marketing authorisation and commercialisation, we offer compassionate use programs for groups of patients with a chronically, seriously debilitating or life-threatening disease, who cannot be treated satisfactorily by an authorised and reimbursed medicinal product.
To facilitate R&D for substances of human origin (such as blood, cells and tissues) we have a dedicated service that coordinates the exchange of information between the relevant services of the FAMHP. This service acts as a bridge to advanced therapy medicinal products (ATMPs) or stable derivatives of blood and plasma. Strategically, it is important to note that we are actively involved in the R&D Bioplatform, an initiative of the Belgian government aimed at making Belgium an even more attractive biopharmaceutical hub.
What are the main challenges for the FAMHP in its role as facilitator of R&D?
Since 2021 many challenging European regulations went into force such as the Clinical Trial Regulation (CTR), the Medical Device regulation (MDR), the In Vitro Diagnostic Regulation (IVDR) and the New Veterinary Regulation. The implementation of these required major updates of processes and procedures. Simultaneously new EU portals (Clinical Trial Information System, Eudamed) and EU databases (Union Product Database) are in development or have been released.
We provide feedback during the development of these portals and once finalised, we need to integrate the new regulations in our processes This requires additional capacity and collaborations with external partners, such as ethics committees.
A specific challenge for the CTR has been, and still is the transition of clinical trials from the old legislation to the new one. For the MDR and the IVDR, a coordinated assessment still needs to be established. Additionally, together with the other member states we aim to facilitate the submissions of combined trials (CTR-MDR and CTR-IVDR).
Other new EU Regulations (e.g. SoHo, HTA and EHDS) and legal acts (e.g. AI and Cybersecurity) that may impact the agency’s future way of working, are carefully being followed up proactively in order to prepare the FAMHP in a timely manner. Regarding the ongoing general review of the pharmaceutical legislation, we support the focus on need-driven developments to address important unmet medical needs.
As the life science sector and healthcare climate rapidly evolve, the FAMHP needs to keep its expertise up to date within several domains such as digitalisation (use of real-world data), ATMPs, complex clinical trials and drug/device combination products.
In this context the FAMHP is currently developing a new and unique IT expertise management system in collaboration with the Federal Public Service for Health, Food Chain Safety and Environment. This system will facilitate the scientific and regulatory core tasks of the FAMHP in the next ten years and expand the external expertise networks of the FAMHP.
Ensuring timely and safe access for patients to important innovative medicinal products or medical devices and IVDs remains the primary drive for the FAMHP.
This is particularly crucial as we face three major challenges: medicine shortages, the need to have medical devices, including IVDs, on the market in spite of a new, longer, certification process, and antimicrobial resistance, which compels us to have as many antibiotics available as possible to use as little as possible.
During the Belgian presidency, the FAMHP organised a two-day meeting with the other European competent authorities for medical devices and IVDs. In one of the sessions, the FAMHP and KU Leuven focused on the regulatory challenges that the new European IVD Regulation brings for rare disease diagnostic tests and more specifically for hospital developed diagnostics. Additionally, the FAMHP will participate in the development of a European guidance on in vitro diagnostics for orphan/rare diseases.
How does the FAMHP position itself in a European context?
The FAMHP is a strong partner within the European Medicines Regulatory Network (EMRN) and collaborates very actively with the European Commission, the European Medicines Agency, the Heads of Medicines Agencies, the Medical Devices Coordination Group. The agency closely follows the new developments such as accelerated clinical trials in Europe, CT Cure and Safe CT, Big Data, shortages, antimicrobial resistance and drug repurposing.
The FAMHP is also actively involved in several EU4Health Joint Actions, particularly the Joint Action on capacity building “IncreaseNET” that aims to optimise and enhance collaboration and interactions with other National Competent Authorities operating in the EMRN.
The FAMHP has selected fields of excellence: vaccines which is already in place and ATMPs which is being prepared. Moreover, further reflexion is ongoing to develop a field of excellence regarding medical devices.
This strategic focus is essential for the agency to serve patients effectively in a rapidly changing environment.
By Prof. Pascal VERDONCK, Member of the Royal Flemish Academy of
Belgium
for Sciences
and Arts, Board member of the Belgian & European Association of Hospital Managers, Chairman of the board of
Abstract
Hospitals and healthcare services need to become significantly more proactive in leading the transformation to net zero carbon emissions. This will build climate resilience and sustainability into their services, working with and for the communities they serve. The impact on quality of life, resilience, and the wellbeing of communities will improve health for all. The journey to net zero will also reduce the burden on hospitals and health systems according the Geneva Sustainability Center.
Maria Middelares Hospital

Prof. Pascal Verdonck
Since January 1, 2024, AZ Maria Middelares Hospital and AZ Sint-Vincentius Deinze Hospital merged into one non-profit organization Maria Middelares member of the E17-hospital network. The merger includes two hospitals and two medical centres, facilitating the exchange of medical knowledge and expertise, with a focus on providing high quality, innovative, and sustainable care for the patients.
In 2022, Maria Middelares integrated sustainability visible into its strategic objectives, publicly committing to environmental stewardship and sustainable healthcare practices. Under the motto “Caring Today for Tomorrow,” employees at all levels are urged to integrate eco-conscious practices, championed by the Greenteam and supported by the Board.
This includes adopting energy-efficient infrastructure, staff training and engagement, board involvement and the appointment of a chief sustainability officer, installing a green travel plan, implementing waste reduction strategies, transitioning to renewable energy sources, low-carbon procurement, and establishing recycling programs. The commitment to sustainability benefits the environment and enhances patient care, fostering a healthier, greener community.
framework
Based on extensive review of both leadership and sustainability literature review a key summary can be made of the leading principles that help hospitals evaluating towards net zero. Hereby, 4 different categories can be detected: leadership & governance, clinical practice, operations and supply chain.
Green infrastructure by building a new hospital as starting point
During the preparation and construction of the new hospital (20102015), the new building of Maria Middelars on the Ghent site offered huge opportunities to incorporate state-of-the-art technology to grow as a greener and more sustainable organisation. Sustainable building techniques such as climate control systems, optimized insulation,
green roofs, heat pumps, and light sensors were implemented, resulting in annual electricity savings of 535,756 kWh despite increased activity levels.
In 2020 the inception of the Greenteam, an employee-driven initiative started. In 2022, the “Caring Today for Tomorrow” program was initiated and included a double materiality assessment to identify ESG issues that have the largest impact on the hospital, employees, patients, operations, community and environment. This analysis identified issues and challenges through comprehensive assessments of the institution’s environmental impact and healthcare practices.
Quantitative data was gathered on energy consumption, waste generation and segregation, carbon emissions, and resource utilization. Qualitative assessments involved stakeholder consultations, surveys, and feedback mechanisms to gauge perceptions and concerns regarding sustainability practices. Key challenges included high energy consumption, excessive waste generation and reliance on non-renewable resources. Quantitatively, data revealed significant energy consumption levels, leading to high operational costs and carbon emissions. Waste audits highlighted the excessive generation of non-recyclable and hazardous materials, posing environmental risks. Qualitatively, staff and community feedback indicated a growing awareness of environmental issues and a desire for more sustainable practices.
By addressing these challenges, the sustainability initiative aimed to mitigate environmental impacts, enhance patient care, and promote community well-being. Quantitative targets were set to reduce energy consumption, waste generation, and carbon emissions by specific percentages over a defined timeframe. Qualitatively, success was measured by staff engagement levels, patient satisfaction with eco-friendly practices, and community perceptions of the institution’s environmental responsibility.
However, by 2023, the Steering Committee, presided by the CEO and supported by the Board, had formulated a sustainability strategy, delineating 16 priority ESG-topics in alignment with the Corporate Sustainability Reporting Directive (CSRD) of the European Commission, and based on international and industry benchmarks, stakeholder surveys and interviews. Key Performance Indicators (KPIs) were specified for each prioritised topic, enabling systematic tracking and reporting.
The prioritized ESG topics underwent assessment and categorisation to evaluate whether existing initiatives adequately align with the ambitions set for each topic. The analysis aimed to determine if

In September 2024, Maria Middelares Hospital was rewarded with the International Hospital Federation (IHF) Award.
supplementary actions were necessary to achieve the desired objectives. Results indicated that for half of the selected topics, additional measures would be necessary to fulfil both short- and long-term goals and ambitions.
The “Caring Today for Tomorrow”-project focuses on ESG themes. Specifically for Environment, 5 material topics were identified: Climate change (mitigation and energy, and adaptation), Pollution of water, Circular economy (Resources inflows, including resource use, and Resource outflows, related to products and services). Consequently, the Steering Committee swiftly advanced in identifying KPIs for these topics, aiming to establish a standardised reporting framework, formulate necessary actions, and measure progress for internal and external reporting purposes
The Board’s forward-thinking approach to designing the new hospital was evident in its investment in various energy-efficient technologies, including advanced climate control systems featuring ice-water cooling, LED-lighting, a borehole-energy field, etc. Despite an average yearly 2,7% increase in activity over the past 5 years, these initiatives collectively resulted in a total energy-saving of 5.4% annually.
Several noteworthy accomplishments merit discussion: board engagement and establishment of the Steering Committee to devise strategic sustainability objectives; implementation of sustainable construction practices during the building phase of the new hospital; transition from grey to green energy sources (solar panels and heat
pumps); introduction of behavioural change programs targeting employees; rollout and integration of teleconsultation and telemedicine services, etc.
The efficacy and cost-effectiveness of these measures are evidenced through rigorous monitoring and measurement mechanisms, which ensures that these initiatives not only contribute to environmental sustainability but also uphold standards of efficacy and efficiency within healthcare delivery.
The project has elicited favourable responses from diverse stakeholders within the organisation. Moreover, Maria Middelares has committed to sustainable healthcare practices by signing the Greendeal Sustainable Healthcare initiative led by the Flemish government, a commitment communicated transparently to stakeholders. The hospital’s dedication to sustainability has been duly recognized, receiving the “Sustainable Enterprise” laureate from VOKA (an entrepreneurial network) in both 2022 and 2023.
It all starts with a vision. But once the board and management took initiative, employees get incentives and tools, you get the right engagement for a collective change of the hospital towards a greener and smarter hospital.
In September 2024, Maria Middelares Hospital was rewarded with the International Hospital Federation (IHF) Award, the Ashikaga-Nikken Excellence Award for Low-Carbon Healthcare and the bronze medal. A brochure presenting details of each of the Award-winning initiatives is available online to inspire hospital leaders and healthcare professionals around the world: https://ihf-fih.org/what-we-do/ ihf-awards/ihf-awards-winning-stories/

What are essencia’s key figures and missions?
An interview with Mr Yves VERSCHUEREN, Managing Director essenscia
The chemicals, plastics and life sciences sector is a very important industrial sector in Belgium. In 2023 it represented 100,000 direct jobs, 250,000 indirect jobs, 75.1 billion € turnover, and 25.2 billion € in trade surplus. In addition, the chemicals and life sciences sector remains the undisputed leader in innovation. The amount spent on research and development (R&D) in Belgian chemicals, plastics and pharmaceuticals more than doubled in the last decade to 6.3 billion € in 2023, a new record. The sector accounts for two thirds of all industrial expenditure on R&D in Belgium, mainly due to the high R&D intensity of life sciences companies active in pharmaceuticals and novel biotechnologies.
Innovation is undoubtedly a key element in ensuring the sustainable anchoring of the sector in Belgium. No wonder that essenscia’s mission is to ensure a stimulating framework for companies to keep innovating for a more sustainable future. Our world is facing important challenges in the use of energy, the protection of natural resources, and the provision of food, water and health for its growing population. Chemistry and life sciences are essential to making the world’s development sustainable. Its innovative research is crucial to the development of new products, applications and services. The chemistry innovation agenda is broadly structured around a so-called double twin transition: the industry has to become climate neutral and circular, transition to more safe and sustainable products, and simultaneously digitize its (production) processes at a rapid pace. The capture and storage or utilization of CO2, the development of a hydrogen economy, the electrification of production processes, the use of bio-based raw materials or the chemical recycling of plastic waste: all these technologies have the potential to contribute to a more sustainable economy and society.
In life sciences, the aim is to accelerate the development of new medicines and vaccines, using pioneering technologies such as messenger RNA, plasmid DNA, genome editing, biosensors, cell and gene therapy and the use of monoclonal and polyclonal antibodies. This should lead to more targeted treatments and personalised medicine tailored to the patient.
What services do you offer your members in terms of information, training and advice?
In the field of information, we offer discussions in working groups on strategic priorities as well as information sessions on hot topics. As regards formation, let us mention VLARIP (Vlaanderen REACH Implementation Project in Flanders) and WALRIP (Wallonie REACH Implementation Project in the Walloon region) for REACH and CLP, along with annual seminars on product policy, crisis communication and social themes. With the Process Safety Academy and the Security Club we provide several in depth training sessions on process safety. The essenscia Patent Cell offers free advice and information on intellectual property management, including technology trend watching. essenscia also offers tailored advice, expertise and advocacy on new legislation and strategic priorities.
Could you present essenscia’s activities in terms of innovation and patents?
Innovation is at the core of our federation and numerous initiatives have been launched: the essenscia Patent Cell, the Innovation Award (the most prestigious award in Belgium for industrial innovation, with the 6th edition coming up in 2025 and the Innovation Fund (39 investments in promising companies).What is more, essenscia has engaged in innovation clusters in Flanders (Catalisti) and Wallonia (GreenWin, BioWin). essenscia is also the main shareholder in BlueChem, the first incubator for sustainable chemistry in the Benelux that has opened its doors in 2020. And let us not forget that our federation was the driving force behind the foundation of the National Fund for Scientific Research in the 1920s. A decade characterized by an innovative alliance between science and industry, which resulted in the famous Solvay Conferences and world conferences on chemistry in Belgium.
Could you give us some examples of new products, applications or services developed by the chemical, plastics and life sciences industries to address major global challenges?
Let me first mention that the chemicals, plastics and life sciences sector is a solution-provider to tackle climate change. In that prospect, it is designing insulation materials for energy efficient construction and household appliances, lightweight materials for sustainable transport, components for renewable energy and electric car batteries. It is also striving to turn CO2 into a valuable resource, to integrate plastics in a circular economy and to boost the industrial application of hydrogen. On the other hand, Belgium has become an internationally renowned ‘health and biotech valley’. Our country hosts some of the largest vaccine production sites in the world. At the same time, we can count on a high concentration of pharmaceutical and biotech companies that are working on - and already have come up with - breakthrough medicines, therapies and production processes that can help patients worldwide.

pharma.be, the umbrella organisation for some 130 innovative pharmaceutical companies operating in Belgium, published its Pharma Figures 2022 on 30 June 2023, an annual overview of the sector’s economic footprint. The figures show once again that the biopharmaceutical sector remains in full development. However, this is no guarantee for the future.
Competition with other countries is fierce, Europe needs to take steps to strengthen its position internationally, and the search for talent remains a challenge. The threat of introducing restrictions that make it more difficult for patients to access new therapies persists at national level.
Some key figures for 2022:
- In 2022, 43,501 people were directly employed in biopharmaceutical companies in Belgium. This represents an increase of 18.8% over the last five years. The sector’s impact on employment in our country goes even further: for every job in the Belgian biopharmaceutical sector, two other jobs are created in the Belgian economy.

- Investment in research and development (R&D) amounts to more than €15 million a day, for a total of €5.7 billion, up 14.7% on last year. The number of researchers working in the sector has risen by 25.5% over the last five years.
- For the first time, total exports of medicines and vaccines exceeded €100 billion, representing 17% of total Belgian exports. Every day, the Belgian sector exports €275 million.
- Finally, the biopharmaceutical industry is one of the few sectors to generate a significant trade surplus (€19.4 billion) by exporting medicines and vaccines.


“Although the figures for 2022 show that the Belgian pharmaceutical sector is strong, this is no guarantee for the future. Our sector remains one of the most dynamic in the Belgian economy, but the environment remains fragile. The Belgian Pharma Valley is facing serious competition from other countries that are strongly supporting their own biopharmaceutical sector.
What’s more, we are seeing a worrying trend: more and more R&D activities in the pharmaceutical industry are leaving Europe for the United States or Asia. 25 years ago, around half of all new medicines came from Europe. Today, only a fifth remains. To halt this trend, Europe - and certainly Belgium - needs to take urgent action.
For pharma.be and its members, health is essential. Our mission is to transform knowledge into solutions and bring them to market so that patients can benefit from them. Although Belgian companies invest heavily in the research and development of innovative medicines, all too often these drugs are not available quickly enough for patients in our country.
This is a structural problem that places our country in the European average, far behind neighbouring countries where patients have obtained reimbursement for these innovations. An important detail in this respect is the fact that spending on drugs has increased much more slowly than other spending in the NIHDI INAMI-RIZIV health budget over the last decade.
The latest figures for the pharmaceutical industry demonstrate the importance of this sector for our country. We need to maintain this engine of growth, employment and innovation, because patients and society as a whole will benefit from it.”
Caroline Ven, CEO pharma.be
pharma.be vzw | asbl
Terhulpsesteenweg 166 Chaussée de La Hulpe Brussel 1170 Bruxelles | T 02 661 91 33 | F 02 661 91 99 www.pharma.be | info@pharma.be
Ondernemingsnummer/Numéro d’entreprise 0407.622.902
RPR Brussel
Sirris is where Belgium’s technological industry comes together to innovate, grow, and lead. Founded by Agoria and managed by the industry itself, Sirris bridges the gap between research and real-world application. From AI to sustainability, from Industry 4.0 to the energy transition, we empower companies to tackle the challenges of tomorrow with the tools of today.

Artificial Intelligence (AI) is a powerful tool for Belgian industry, with applications ranging from predictive maintenance to quality control on production lines. The rise of Generative AI (GenAI) marks a significant shift in possibilities. Unlike traditional AI, GenAI creates new content from digital work instructions and production plans to AI-driven customer support, enabling automation, cost reduction, and increased agility.
At Sirris, we don’t just explore the possibilities of GenAI. Our applied research ensures that GenAI tools are tailored to the specific needs of each business. By integrating these technologies responsibly, we help companies automate complex tasks, streamline processes, and gain a competitive edge in an ever-evolving industrial landscape.
Innovation is rarely an individual effort. At Sirris, collaboration is key. By connecting companies with expertise, infrastructure, and a network of partners, we enable organisations to move from concept to implementation. With industrial labs, multidisciplinary experts, and close links to industry, Sirris creates a space where ideas are tested, refined, and brought to life.
Whether it’s adopting AI-driven tools, improving production processes, or integrating sustainable energy solutions, we ensure that businesses can address the challenges of today while preparing for the demands of tomorrow. This collaborative approach has been the foundation of our work for decades and remains central to its mission moving forward.

The energy transition is a major challenge, but also a unique chance for innovation. Belgian industries face the “energy trilemma”; balancing affordability, reliability, and sustainability. Sirris offers strategic guidance and hands-on expertise to help companies optimize energy efficiency, adopt cleaner fuels, and explore technologies like carbon capture and renewable e-fuels. This ensures they are ready and empowered to lead this critical transformation.
innovation@sirris.be

In a world where societal challenges are multiplying, the role of applied research is more crucial than ever. In the Wallonia-Brussels Federation, hundreds of researchers from Universities of Applied Sciences and associated Research Centres are working to provide concrete and innovative solutions to the emerging needs of our society. At the heart of this dynamic ecosystem, SynHERA, the applied research support network, plays a fundamental role in fostering the development of ambitious scientific projects while facilitating their integration into the socio-economic environment.
A unique network for tangible results
SynHERA is supported by a network of 19 Universities of Applied Sciences and 10 Research Centres, each specialized in diverse disciplines such as agronomy, health, technology, humanities and social sciences. In contrast to the classic image of a researcher isolated in a lab, the research projects supported by SynHERA are multidisciplinary and grounded in real-world challenges. Researchers in this network collaborate with industry players, businesses and public institutions to co-create solutions tailored to local, regional, and international issues.
A strategic and financial support
Access to funding is a cornerstone of research project success. Across Europe, various programs, such as Horizon Europe, Interreg and innovation support mechanisms like Eurostars and the EIC provide essential resources to researchers. SynHERA positions itself as a strategic facilitator.

Not only does it guide researchers in drafting and submitting funding proposals, but it also helps them identify the most relevant opportunities for their projects. This support goes beyond mere administrative assistance: SynHERA forms a true partnership with

researchers, leveraging its expertise to maximize their chances of success, thus contributing to the emergence of innovations that benefit society.
People at the core of research
The diversity of profiles and expertise within SynHERA’s network is a crucial strength. Whether focusing on education, territorial divides, sustainability or industrial innovation SynHERA fosters an environment where researchers can collaborate and share knowledge. This collaborative approach extends beyond Belgium’s borders: SynHERA builds bridges between researchers in the Wallonia-Brussels Federation and their European and international peers, enabling them to broaden their networks and acquire new skills through mobility programs.
Valorization: from research to tangible innovation
Supporting research is important, but valorizing it is even better! SynHERA understands this well and focuses on promoting scientific discoveries to economic actors and the general public. Participating in international events and specialized trade fairs is part of its strategy to increase the visibility of applied research projects. However, SynHERA does not just spotlight these efforts; it acts as a bridge between the academic and private sectors, creating opportunities for fruitful and innovative collaborations. This valorization process helps translate research findings into practical solutions for businesses, institutions, and citizens.
A vision for the future of applied research
SynHERA embodies a new way of conducting research: as a network, grounded in local realities while embracing international opportunities. In a world where economic, social, and environmental challenges continue to evolve, researchers from the Universities of Applied Sciences and associated Research Centres, supported by SynHERA, demonstrate that applied research can play a driving role in societal transformation.
Ultimately, by investing in applied research and providing researchers with tailored tools, SynHERA ensures that today’s discoveries become tomorrow’s solutions. With its ability to unite researchers, businesses, and financial partners, the SynHERA network is an essential actor in addressing European challenges while promoting innovation for the benefit of all.
More info: https://www.synhera.be

As we move beyond two decades of socio-economic valorisation of research and successful university-business collaborations, the LiEU Network reaffirms its pivotal role in establishing and strengthening connections between Research, Industry and Society in Wallonia and Brussels.

Since its foundation in 2003, the LiEU Network (Liaison Entreprises-Universités) has steadily evolved, adapting to the ever-changing landscape of innovation, knowledge transfer and socio-economic development. Founded by the Council of Rectors of the universities in the Wallonia-Brussels Federation (CRef) and supported by the Walloon Region, the Network was initially created to facilitate the transfer of knowledge between universities and businesses.
Nathalie Burteau, President of the LiEU Network emphasises that: “More than 20 years later, the Network has grown into a robust and multidisciplinary system with teams composed of more than 80 experts and advisors. We remain committed to driving innovation in the Region and consolidating collaborations between universities, businesses and all key players of our innovation ecosystem.”
The LiEU Network was designed to address the need for a structured approach to transferring research results to industry and society. This includes the creation of spin-offs, fostering partnerships, and promoting intellectual property rights to protect innovations. Today, it has become the cornerstone of knowledge transfer in the Region. Its operational director, Eric Wyart, notes: “The LiEU Network plays a vital intermediary role between academic research and socio-economic stakeholders in Wallonia, helping to shape innovation across sectors.”
The Network has introduced strategic advisors who specialise in areas aligned with Wallonia’s innovation priorities and strategic axes. These experts work closely with businesses to ensure research results generate tangible socio-economic impact, contributing to the Region’s competitiveness and growth.
The journey toward a professionalised network of Knowledge Transfer Offices (KTOs) was gradual but significant. More than twenty years ago, few knowledge transfer structures existed within the French-speaking universities of Belgium. However, in 2003, under the CRef’s guidance, these scattered entities were consolidated into the LiEU Network, marking a turning point for research valorisation in Wallonia and Brussels.
In 2008, the LiEU Network took another significant step through its first European Social Fund (ESF) project called “Mise en Réseau de la Valorisation – MIRVAL”. This project helped to further structure and professionalise the Network, consolidating its position as a key player for research valorisation in Wallonia. This development laid a strong foundation for what the network represents today: a cohesive and multidisciplinary force supporting innovation at all levels.

The LiEU Network has firmly established itself as a gateway to the resources and findings of academic research, fulfilling the mission laid out by the CRef. This mission stresses that universities must not only conduct research and transmit knowledge, but also engage meaningfully with society.
Within the Network, the 5 universities count more than 10,000 researchers and hundreds of research units and laboratories. Their research can be made accessible to businesses, associations and organisations, thereby reinforcing their competitive position in the socio-economic landscape and positively impacting the development of the Walloon and Brussels Regions.
Eric Wyart highlights: “The LiEU Network has been instrumental in creating numerous success stories. One example is the development of spin-offs and licenses that bring university innovations to market, benefitting local businesses, organisations and the wider economy. Additionally, the Network offers a wide range of services, including a dedicated intellectual property service through the PATLIB unit, along with trainings and concrete tools for researchers on intellectual property and valorisation”.
The LiEU Network also plays a prominent role in showcasing the technological offerings and resources of its universities at key international events such as BIO Europe, BIO US, BIOVARIA, Space Tech Expo, and the Assises de la Francophonie Scientifique.

As the LiEU Network enters its third decade, it faces a dynamic and evolving landscape of challenges and opportunities. The Network has adapted its operations to meet the growing needs of its partners, both in Wallonia and internationally. For instance, in 2023, a portion of the network’s activities was integrated into the Wallonie Entreprendre programme, a key initiative aimed at generating more value for the Region through innovation-driven projects.
At the core of the Network’s valorisation activities is its multidisciplinary team supported by a combination of regional, academic and private funding. This diverse group of scientific advisors, experts in valorisation, business developers, communication specialists, data managers, legal experts, patent managers, investment funds, and more, are all working together to drive and support innovation. Additionally, the LiEU Network has established a solid governance framework and an organised operational structure, supported by management bodies, steering committees and a system of coordinators.
This multidisciplinary and structural approach enables LiEU to continue evolving, providing tailored and coordinated solutions to external partners, while fostering close collaboration between each KTO and the researchers of their institution. Mutual trust and cooperation between the KTOs of different universities have been a defining factor in the Network’s success. According to Nathalie Burteau, “Over the past 20 years, we have developed a spirit of collaboration that transcends competition between institutions. This trust allows us to offer coordinated responses to
our partners, strengthening our position as a key player in research and innovation.”
As the LiEU Network continues to mature, its commitment to fostering innovation remains unwavering. Looking forward, the Network aims to expand its impact by embracing new technologies, enhancing collaboration with external partners, and ensuring that Wallonia remains at the forefront of research-driven socio-economic development.
With its strong foundation of collaboration, expertise, and vision, the LiEU Network is well-positioned to navigate the evolving demands of the knowledge transfer landscape, ensuring the region continues to thrive in an increasingly competitive global economy.
For more information on the LiEU Network and its activities, visit: www.reseaulieu.be
Every year, the LiEU Network delivers results, including...
• 40 patents filed
• Over 1,100 research proposals submitted in response to Walloon funding calls
• 10 new spin-offs created
• 140 licenses concluded with companies and organizations
These achievements are made possible thanks to the constantly renewed involvement of the teams and the unwavering support of the authorities of our institutions, the SPW Research, the ERDF, Wallonia-Brussels International and the office of the Minister of the Economy, Research and of Innovation in the Walloon Region.
See also our 2023 Activity Report: https://reseaulieu.be/ en/2024/06/27/2023-business-review/
The LiEU Network brings together the Knowledge Transfer Offices (KTOs) of the 5 French-speaking universities of the Wallonia-Brussels Federation:
• Université catholique de Louvain: https://uclouvain.be/ fr/chercher/innover-et-entreprendre-ti.html
• Université libre de Bruxelles: https://www.ulb.be/fr/ la-recherche/innovation-services-aux-entreprises
• Université de Liège: https://www.recherche.uliege.be/ cms/c_9006501/fr/recherche-innovation
• Université de Mons: https://web.umons.ac.be/fr/nos-missions/recherche/
• Université de Namur: https://www.unamur.be/recherche






What are Belnet’s key services?
For the last 30 years, Belnet has made its infrastructure available to universities, colleges, federal scientific institutions (FSIs), and public or private specialized research centres of all sizes. In addition to our network, which allows academic researchers and students to share large amounts of data securely, we offer a range of services: eduroam, which connects them to the wifi networks of other participating organisations across Europe without having to request specific access, DMPonline.be, which allows researchers to generate and manage their data management plans, and our Storage service, which offers secure, bespoke cloud hosting for research data and other data. In the area of cyber security, we have launched an anti-DDoS platform that over 50 customers use to track daily attacks and vulnerabilities in real time. We are also keen to relieve universities of certain ICT-related tasks as part of our Campus Solutions offering. Thanks to its partnership with Belnet, the UMONS Wi-Fi network will be upgraded by 2025. 800 wireless access points across 13 sites will be replaced, and the WLAN (wireless local network) will be powered by artificial intelligence. UMONS is the first Belgian university to benefit from this new solution, and several other institutions are already interested.

and aims to develop an optical network for time & frequency (T&F) transfer in Belgium and connect it, via France, to the European metrological network. Led by the Royal Observatory of Belgium (ROB), it started at the end of April 2023 and will run until the end of 2026. The technical requirements to be met to transport the ultra-stable time & frequency signal over the Belnet fibre optic network are being explored in close consultation between the ROB, Belnet, UCLouvain, REFIMEVE, the Observatoire de Paris, the Laboratoire de Physique des Lasers (LPL, Paris) and GÉANT. This new way of delivering the correct time, down to the nanosecond, is of interest not only to researchers, but also to 4G and 5G operators and weather forecasters. All that remains to be done is to find the funding to sustain this useful service for society as a whole beyond 2026.
What are Belnet’s upcoming projects?
Belnet is playing a key role in the Belgian open science landscape. Could you tell us about your current initiatives?
As part of the EOSC (European Open Science Cloud) programme, which aims to give the EU a global role in research data management and to ensure that European scientists enjoy all the benefits of data-driven science, Belnet has been assigned to lead the FedOSC project, which represents the implementation of the open science concept at federal level. Between April and July 2024, an initial exploratory phase involved 42 bilateral roundtables with FSIs to sound out their expectations, and a benchmark with stakeholders in Belgium and Europe. These exchanges enabled us to formulate a proposal: to first develop an open science platform and tools for the less mature FSIs at this level. We are also working with BELSPO to recruit 3 data stewards to guide researchers in this new way of working.
Belnet is fully engaged in a number of strategic innovation projects, such as BeQCI and BOOSTED. Could you tell us a bit more about these projects?
The BeQCI project brings together partners from R&E and industry to implement and test a Quantum Key Distribution network, i.e. a combination of optical fiber links and Quantum Key Distribution (QKD) boxes, which use the effects of quantum physics to generate a stream of random data at both ends of the optical fiber. This guarantees that this way of exchanging cryptographic keys is perfectly secure, and always will be. After phase 1 (implementation of the boxes in Ghent, Brussels and Redu), and phase 2 (receptions of the new use cases), Belnet and imec have joined forces to launch a call for projects to capitalize on the expertise acquired in this area. With regard to the BOOSTED project, it stands for ‘Belgium Optical network for Optical frequency Standards and TimE Dissemination’
As part of our new 2025-2029 strategy, we will be even more attentive to the specific needs of the various user communities, and will keep innovation at the heart of our activity. Beyond the connectivity layer, our basic foundation, we will propose a scalable offering with our Cloud services in our own data centers, next to the cloud solutions portfolio OCRE (Open Cloud for Research & Education), as well as our Trust & Security services for connectivity and data protection. We will also adapt and let evolve our AAI (Authentication and Authorization Infrastructure) services and are evaluating the possible roll-out of SOC (security operation center) services. So many exciting projects!

WTC III
Boulevard Simon Bolivar 30 B 2
1000 Bruxelles
Tel.: +32 (0)2 790 33 33
E-mail: info@belnet.be
https: //www.belnet.be

Can you provide an overview of the key outcomes from the economic missions in 2024?
The economic mission to Norway, held from June 16th to 19th, was a notable success. Led by HRH Princess Astrid, the delegation consisted of 450 participators from various sectors, including renewable energy, life sciences, and the circular economy. This mission was instrumental in forging new partnerships and resulted in the signing of 18 agreements. These accords underscore the mutual interest and potential for cooperation between Belgium and Norway, particularly in areas like the blue economy and sustainable technologies.
The most recent mission to Brazil, which took place from November 22nd to December 1st, was aligned with Belgium’s strategic focus on fostering international collaboration in high-potential sectors. The mission emphasized renewable energy, agriculture, and transport/ infrastructure - areas where Belgium’s expertise significantly contributed to and benefited from Brazil’s dynamic market. By leveraging these sectors, we strengthened our economic ties and explored new avenues for growth and innovation. A total of 405 participants registered for this mission, highlighting Belgium’s strong presence and interest in Brazil.

a comprehensive sectoral publication on Belgian Defence. This publication will provide insights into the industry’s key stakeholders and emerging trends and will be available by the time this article is published.
What are the future plans for Belgian economic missions? Looking ahead, we have set our sights on two prominent economic missions for 2025. In the spring, we plan to explore opportunities in India, a market known for its rapid growth in sectors such as clean tech, life sciences, and defence. Later in the year, our focus will shift to the West Coast of the United States, particularly San Francisco and Los Angeles. These missions, also led by HRH Princess Astrid, aim to bolster Belgium’s presence in these key regions and foster partnerships that align with our strategic interests in technology, innovation, and sustainable development.
How has Belgium’s trade landscape evolved in recent years, particularly in light of global economic trends?
The global economic landscape has seen considerable shifts, and Belgium has adeptly navigated these changes. Despite a general slowdown in global merchandise trade, as reflected in a 1.2% decline in 2023, Belgium’s trade performance has remained robust. Our country continues to be a major player in international markets, ranking 12th in exports and 14th in imports. This resilience is a testament to the strength and adaptability of Belgian businesses and their ability to maintain high levels of trade activity even in challenging times. For those interested in a more detailed analysis, the full report on World trade and Belgium trade can be accessed on our website.
Could you highlight a specific sector where Belgium’s innovation is making a global impact?
Belgium has made remarkable strides in the field of nuclear medicine, positioning itself as a global leader. Our nation’s unique infrastructure, including the Belgian Reactor BR2, plays a crucial role in producing medical radioisotopes, which are indispensable for diagnostic and therapeutic procedures worldwide. Moreover, the innovation and expertise demonstrated by Belgian companies and research institutions in this sector significantly contribute to the advancement of global healthcare solutions.
For those interested in an in-depth analysis, the sectoral publication on nuclear medicine, detailing the major players and federations, is available on our website. Additionally, recognizing the increasing importance of defence in the current global context, we are preparing





On September 30, 2024, Mathias Diependaele not only assumed office as the new Flemish Minister-President, he also took on the responsibilities of foreign affairs, economy, industry, innovation, digitalisation and facility management. In the previous legislature, he served as Minister of Finance, Budget, Housing and Immovable Heritage.

The new Flemish government is determined to strengthen Flanders’ position as a European leader in innovation and even to advance to the world top, by increasing government investments in innovation to 1% of GDP and, together with the business community, increasing joint investments in R&D to 5% of the GPD. Innovation is the engine for sustainable economic growth and higher productivity of Flemish industry. Driven by new geopolitical and social challenges, we will respond to promising innovative developments, such as sustainable energy and mobility, biotechnology or digital technologies.”
For the first time, industry is a separate ministerial responsibility.
“It is not without reason that, as a specialist minister, I have taken on the powers of economy, innovation and industry. We cannot take our prosperity for granted. More than ever, our industrial fabric is under pressure from fierce international competition in a rapidly changing world. We are a world leader in innovation and, for instance, our chemical and pharmaceutical clusters are known far beyond Flanders, but we realise that we must do everything we can to maintain and strengthen that international position. That is why we offer our industry the necessary growth opportunities and we strive to be strategically anchored worldwide.”
Where does Flanders stand within Europe?
“Compared to other European countries, we are one of the fastest growing regions for start-ups. This often happens in collaboration
with our universities and other educational institutions. Flanders needs skilled workers for our added value and economic growth. If we want to continue to deliver good profiles to our labour market, we must reconnect with the international top in terms of education. Flanders is also an SME region. We are a nation of entrepreneurs and we must continue to support this as a government. We improve the competitiveness and productivity of our companies by, among other things, focusing strongly on administrative simplification and a legally secure and faster licensing policy.”
“During the current legislature, we are focusing on the sustainable strengthening of the productivity and competitiveness of our economy and industry with the policy focused on economy, science, innovation and industry. This also includes investments in research, development and innovation, education, human capital, digital skills, lifelong learning and infrastructure.”
During the last legislative term, Flanders rose from 46th to 23rd place on the EU Regional Innovation Scoreboard.
“An important achievement, but we have not yet achieved the goal of being in the top 5 of innovative knowledge regions. Moving up the rankings requires sustained investment impulses and further optimisation of the R&D ecosystem. In the meantime, Flanders is generally known as an attractive knowledge region for research into the latest digital technologies or the development of new digital applications. The above-average scores for Flemish
stakeholders in EU programmes such as Horizon Europe and the Digital Europe Programme - in which Flanders receives approximately 4% of the resources for digitalisation, while representing 2% of the EU’s GDP - proves this.”
In the most recent measurement (2022), the Flemish R&D intensity was 3.52%.
“This makes Flanders a European leader, but this is no reason for complacency. Both within the EU (Finland and Sweden) and outside it (Japan and Iceland), countries have already set a target of 4%. Within the long-term target for joint investments in R&D to 5% of our GDP, we are taking further steps towards 1% for the government itself. With this, we want to push through to the world top and strengthen our position as innovation leader in the European Regional Innovation Scoreboard. We are spreading these additional resources evenly over non-targeted or fundamental research and targeted or applied research. We are not forgetting the research capacity of the universities of applied sciences. At the same time, we are looking at the desirability of rationalising the various financing channels, so that efficiency gains can be achieved from them. Because of the importance for our innovative strength, we are consulting with the federal government about maintaining the partial exemption from payment of withholding tax for R&D.”
“At the same time, we endorse the importance of fundamental and academic research as a basis for future technological breakthroughs. Crucial is the insight that new applications with economic or social added value are unthinkable without free, non-directed research. We are strengthening the support for knowledge valorisation at the five associations of Flemish universities and colleges through the internationally unique duo of Flemish subsidies: the industrial research funds and interface activities. With these instruments, we provide higher education institutions with resources with which their knowledge and innovations can evolve to a higher technology and commercial readiness level through subsequent steps in strategic basic research and applied research.”
In recent years, the Flemish spearhead clusters (Catalisti, The Blue Cluster, Flanders’ Food, Flux50, Medvia and Vil) have proven that, as neutral partners, they connect companies, knowledge institutions, citizens and governments to create economic and social added value through innovation.
“In the meantime, it has also been demonstrated that companies that are members of a cluster organisation realise higher added value and productivity than the sector average. The spearhead clusters are therefore determined to further strengthen their role together. In the Flemish government, they find a strong partner to increase their business-driven social and socio-economic impact. This includes improving the accessibility of SMEs, focusing on guiding start-ups and scale-ups, strengthening internationalisation, and scaling up connections to European funds. Furthermore, administrative simplification should lead to companies gaining easier access to innovations and to resources for innovation being used in a more targeted manner.”
Do Flemish public investments in knowledge development also benefit small players?
“However, this strong knowledge base can only have an impact if there is a smooth flow of knowledge. To this end, we stimulate interdisciplinary interaction between researchers and with companies and social actors. We are moving up a gear in making

new innovative technologies and knowledge from universities, colleges and strategic research centres accessible to a broad group of SMEs. We are providing an accessible offer for small companies that want to integrate these technologies and innovative methods into their business processes and we are developing accessible measures for the implementation of innovative technologies and methods. We are also further exploiting the attractiveness and assets of our strategic research centres imec, Vib, Vito and Flanders Make. We are also continuing to develop Flanders Technology and Innovation (FTI).”
How does Flanders position itself in the dossier of the allocation of the future Einstein telescope for fundamental research into gravitational waves?
“Top-level scientific research increasingly requires high-performance and specific research infrastructure. Flanders will therefore continue to invest in research infrastructure. The Flemish government supports the candidacy of the Euregio Meuse-Rhine for the construction of the telescope and provides the necessary resources. A decision about the location of the telescope will be taken during the current term of office. In anticipation of this, we already will make available 200 million euros. We will continue to contribute to the necessary feasibility studies that are being carried out at Flemish, Euregio Meuse-Rhine and European level.”

What are EWI’s core tasks?
The Department of Economy, Science and Innovation (EWI) is responsible for policy preparation, policy follow-up and policy evaluation for the sectors of economy, science and innovation within the Flemish government. In this framework, our most important goal is to allow Flanders to evolve into one of the most progressive and prosperous regions in the world.
Our three levers in this are the promotion of excellent scientific research, an attractive and sustainable business climate and a creative, innovative and entrepreneurial society. EWI strives towards excellence in fundamental research, strategic knowledge development and the exploitation of this knowledge. Prerequisites for this are human capital and research infrastructure. In addition, we follow up the policy themes that are related to the development of an attractive and sustainable business climate and the stimulation of innovation and entrepreneurship.
The focus of the Flemish cluster policy is on a limited number of large-scale and ambitious spearhead clusters. These spearhead clusters will develop and implement an ambitious long-term strategy and competitiveness programme for the Flanders strategic domain, in collaboration with companies, knowledge centres and the government. Catalisti is our spearhead cluster for sustainable chemistry and synthetics, Flux50 in energy, VIL in logistics and transport. For agrifood we have Flanders Food as our spearhead cluster. Blue Cluster is focussing on blue growth. Medvia - the most recent cluster, founded in 2021 - crossovers in biotech, medical and digital technologies or, more generally expressed, in health and care. It aims to develop and promote economic activities in the health tech domain, in particular the development of an internationally leading ecosystem around the convergence of technologies at the interfaces between biotechnology, medical technology and digital technologies. The four themes Medvia focuses on are personalized medicine, digital medicine, disruptive health solutions and value-based efficient health and care.
How does EWI carry out fundamental and strategic basic research? Excellence is very much the keyword in scientific research. The ambition of Flanders is to finance the most excellent research using this criterion. Flanders has a number of different instruments for the funding of fundamental and strategic
basic research at the Flemish public knowledge institutions such as universities, strategic research centres and other research institutions. Based on this, the EWI department implements a clear policy, coordinates and evaluates these funding mechanisms.
Assignment of a specific grant or subsidy to a researcher takes place through the knowledge institutions themselves or through our agency FWO. In addition to this funding, it is naturally also important to be able to have excellent researchers and research infrastructure. For this reason, we are also investing in our human capital and in state-of-the-art research infrastructure in Flanders and internationally.
Can you give some examples of research funds/programmes?
The Industrial Research Fund (IRF) is an internal designation fund of a university association (a university and one or more colleges) whose resources are used for strategic basic research and applied scientific research. The objectives of an IRF are - in the short to medium term - to stimulate the interaction between the association and the business world and to build up a portfolio of application-oriented knowledge within the association. In the medium to long term, an IRF must result in better coordination of the strategic basic research and applied scientific research with the economic needs and the application and exploitation of the profile of business knowledge built up. The IRF thereby fits into the broader whole of efforts to strengthen the interaction between higher education institutes and economic players.
The Odysseus programme aims to bring researchers with a foreign career to Flanders via early-stage funding for scientific research. This may involve both leading researchers with international recognition - who lead the way and have a post at a foreign university – and researchers who have the potential to be among the world’s best in the near future. For a period of five years, they are able to build up their own research group. The organisation of the Odysseus programme is in the hands of the Fund for Scientific Research - Flanders. Universities take the initiative to nominate candidates. They provide an academic position, the infrastructure, offices etc. Universities can also nominate a candidate together. Approved projects receive between 100,000 and 1,500,000 euros a year for a five-year period.
What is the importance/added value of strategic research centres?
Strategic research centres (SRCs) have formed thanks to the excellent and relevant results of academic scientific research in a wide range of scientific fields in micro- and nano-electronics, biotechnology, digital technologies, environmental topics and our manufacturing industry. With a view to economic and social valorisation, we continually strive for an appropriate balance between targeted and non-targeted research. In that regard, the strategic research centres have
an important bridging function between fundamental and applied research. SRCs therefore also play an important role in the transformation of the Flemish economy. The marketing of their knowledge through the (co)-creation of spin-offs forms an important part of this. In addition, in other sectors - such as clusters in the agri-food industry, sustainable chemistry & synthetics, energy, logistics & transport, blue economy and health - Flanders also applies an integrated support, research and knowledge policy. Flanders has 4 SRCs that are world leaders in their field. VIB for biotechnology, imec for nanoelectronics and digital technology, Vito for cleantech and sustainable development and Flanders Make for the manufacturing industry and industry 4.0.
Can you evaluate the result of these efforts on the international place and reputation of Flanders?
In Belgium, almost 81% of the total public R&D&I support is managed by the Communities and Regions. Flanders counts for 58% of all Belgian public R&D support. The European Commission ranked Flanders in the Region Innovation Scoreboard 2023 as an ‘innovation leader.’ Flanders spends about 3,65% of its GDP in R&D. The Organisation for Economic Co-operation and Development (OECD) maintains a ranking, which compares the R&D-efforts of its country members. In the most recent list, Flanders was ranked first, before Sweden, Belgium, Austria and Germany.
Several international rankings in which academic or knowledge institutes are listed, provide an indication of their relative strength in an international perspective. All Flemish universities score very high on these different ranking. On almost each ranking they belong to the top 3% worldwide. KU Leuven and Ghent University even rank in the top 1% in each of the three major rankings. Each ranking uses different criteria with different weights in their calculation of the ranking position.

Vlaamse overheid Departement Economie, Wetenschap & Innovatie (EWI) Koning Albert II-laan 35, bus 10 B-1030 Brussel info.ewi@vlaanderen.be www.ewi-vlaanderen.be twitter.com/Departement_EWI www.linkedin.com/company/departement-economiewetenschap-en-innovatie-ewi

Driven by a commitment to continuous improvement, the AugmentX team members aim to increase the standard of living of workers exposed to high physical stress.
AugmentX provides a unique ecosystem for augmentation technologies.” says coordinator Tom Turcksin. “In collaboration with academics, we help to develop the next generation of sensors and methodologies that enable better biomechanical analysis.” “This enables analysis and optimization of physical augmentation solutions.” explains developer, prof. Ilias El Makrini.
In 2021 Flanders Make VUB and Ugent set the stage for the establishment of two state-of-the-art facilities, dedicated to explore and enhance human-robot interactions, providing a robust platform for contemporary and future research, the AugmentX Research Lab in Brussels and the AugmentX Validation and Demonstration Lab in Kortrijk. “Both sites have similar infrastructure. In Brussels, we focus on smaller weights but high precision. In Kortrijk we showcase technology in a more industrial environment.”

AugmentX offers a suite of industrial services designed to meet the needs of enterprises seeking to enhance their operations with human augmentation technologies. This includes multi-modal human tracking, ergonomics assessment, biomechanical analysis, exoskeletons evaluation and cobot demonstrators.

The initiative provides in advanced motion capture, physiological and force measurement techniques. The team developed software to bundle data from different sensors over the network into one synchronized data stream, resulting in a simple and modular approach.
Development and testing of custom hard and software components can be performed making use of our infrastructure and academic network. In this way, investments in equipment and specialized knowledge can be mitigated, reducing risks when introducing augmentation technologies.
Through a range of exoskeleton related services including rental, workshops, pilot projects and acceptance studies, companies can get unfiltered taste and knowledge of these technologies.
AugmentX actively engages in research and development partnerships with enterprises. Through Flanders Make, they have access to a large number of Belgian companies. Collaborations are aimed at solutions that address specific industry challenges. By partnering with AugmentX, enterprises gain access to cutting-edge research, state-of-the-art facilities, and a network of robotic and biomechanical experts.
The initiative and its activities are deeply embedded in the research systems of VUB (Vrije Universiteit Brussel) and UGent (Ghent University), fostering a rich environment for collaboration and innovation. The AugmentX initiative is actively involved in international partnerships - such as the European H2020-ICT10 project Sophia - enhancing the initiative’s impact and facilitating the exchange of knowledge and expertise on an international level.
The Flanders Make AugmentX initiative represents a convergence of innovation, research, and industrial application. Through state of the art biomechanical analysis, the initiative is setting new standards. AugmentX offers unparalleled expertise and state-of-theart solutions.

AugmentX Research Lab
Boulevard de la Plaine 9 B-1050 Ixelles, Brussels-Capital
AugmentX Validation and Demonstration Lab
Graaf Karel de Goedelaan 16/18 - B-8500 Kortrijk www.augmentx.be Tel.: +32 (0)486 34 37 06

The Biomechanics Research Unit, an entity of both University of Liège and KU Leuven brings together researchers working at the GIGA research institute in Liège, and the faculties of Engineering and Medicine in Leuven. Inspired by nature and driven by technology, they develop in silico and in vitro tools to increase understanding of skeletal pathophysiological processes and design novel treatment strategies.
We apply a strong interdisciplinary and integrative approach,” explains principal investigator Prof. Dr. Liesbet Geris. “Our tools encompass multiple time and length scales, various biological application domains and all research and development phases from fundamental to applied.” The research team is composed of international researchers with backgrounds ranging from biomechanical engineering over biomedical sciences to medicine. Being a diverse and open group, they actively collaborate with international academic partners, clinical partners, industry, patient organisations, regulators and policy makers to ensure the transition of their science from bench to bedside and from bit to bedside.

“We focus on skeletal diseases, degeneration and regeneration, more specifically osteoarthritis, non-healing bone fractures, large skeletal defects and bone metastases,” says Prof. Geris. “In this context, we also investigate the role of the immune system and the lymphatic network.” The Biomechanics Research Unit collaborates with the Bone4Kids fund, a KU Leuven university fund started by the parents of children with congenital non-healing bone defects.
The regulation of cellular programs is a complex system, driven by numerous biological signalling pathways. “Predicting the biological effects of specific cell culture conditions or additions of growth factors is nearly impossible. From in-house experiments and literature, we collect bulk and single-cell data to create a skeletal cell atlas, which
Preparing the transition from computer screen to the patient, or from bit to bedside, requires collaborative action by all relevant stakeholders. Prof. Geris and her team are very active in several international organisations which aim to ensure that in silico technologies, and the digital evidence they create, are universally adopted and effectively used in both research and the clinic. Particularly noteworthy is their work as coordinator of the Ecosystem for Digital Twins in Healthcare (EDITH) project. This multi-partner international consortium is tasked by the European Commission to develop a vision and draft the corresponding roadmap for the realisation of the Virtual Human Twin concept and a comprehensive federated public infrastructure, facilitating the development and credibility assessment of digital twins in healthcare. This task encompasses frequent contacts with industrial and academic players from all relevant communities in the ecosystem, mostly in Europe but with an increasing interest and participation from around the globe.
we use as a biological blueprint to design and evaluate our tissue engineering strategies and to improve our understanding of specific signalling pathways.”
The team has developed a series of computational models targeting different types of biomaterials, using a variety of methods. “We developed computational models of bioinks and bioprinting set-ups. This allows us to ensure a better biological outcome of bioprinted implants. Other models enable the identification of suitable biomaterials for a specific condition and suggest possible routes for biomaterial optimization. The research team applied the developed methodology on various material classes, including calcium phosphate-based materials and biodegradable metals. The researchers also created additional tools for design and optimization for both material classes. “Several biomaterial solutions passed the preclinical testing stage and now get evaluated to transition to human trials in various clinical applications, such as orthopedics and dentistry.”


Onderzoekscentrum voor Skeletale
Biologie en Engineering ON1 Herestraat 49 - bus 813
B-3000 Leuven
Tel.: +32 (0)16 37 26 90
Email: liesbet.geris@kuleuven.be www.biomech.ulg.ac.be www.vph-institute.org www.virtualhumantwins.eu

The Flemish Advisory Council for Innovation and Entrepreneurship – VARIO – is an independent body which advises the Flemish Government and Parliament on matters related to research, innovation and entrepreneurship. VARIO publishes its advisory reports both on its own initiative and on request. The Council consists of ten experts from the scientific world and the business community, who take part in a personal capacity. Lieven Danneels chairs the council.

From left to right: Danielle Raspoet (director) and council members Dirk Van Dyck (vice-chair, UAntwerpen), Reinhilde Veugelers (KU Leuven) (until July 2024), Koen Vanhalst (De Clercq & Partners), Lieven Danneels (chair, Televic Group), Wim Haegeman (UGent), Katrin Geyskens (Capricorn Partners) and Vanessa Vankerckhoven (Novosanis). Not in the picture are council members Johan Martens (KU Leuven) and Marc Van Sande (Umicore) (until July 2024);
Media Campaign on the VARIO memorandum 2024-2029 (Spring 2024)
At the end of 2023, ahead of the Flemish elections of June 2024, VARIO presented its priorities for the next Flemish Government in relation to science, innovation and entrepreneurship in the form of a memorandum. To keep the messages under attention, in the weeks prior to the elections, through the VARIO website, newsletter and social media, interviews were spread with four top innovators who reflected on how Flanders can strengthen its position as an innovation leader.
Towards an ambitious European industrial policy (Advisory report 34; Januari 2024)
VARIO received a request for advice from Flemish Minister of Economy and Innovation Jo Brouns regarding the concept note ‘Towards an ambitious European Industrial policy’ that sets out strategic guidelines for a forward-looking and proactive European industrial policy. VARIO largely agrees with this concept note, which is very much in line with previous VARIO recommendations. To reinforce it, VARIO added some messages that are relevant for discussions in the context of the Belgian Presidency of the Council of European Ministers and policy debates on future European industrial policy.
Transformative Innovation Policy: A governance framework for Flanders (Advisory report 35; April 2024)
Transformative Innovation Policy is a new generation of innovation policy that plays a crucial role in system change or system transitions that might help the world overcome the urgent and interconnected societal challenges requiring fundamental change. It addresses so-called transition failures. These occur when structural resistance - such as restrictive legislation, taxation or market power of established playersprevent a fundamental change of direction. Based on a country review
in collaboration with VARIO’s Dutch counterpart, AWTI, and a separate background report, VARIO developed a participatory governance framework for Transformative Innovation Policy for the Flemish Government, together with 8 recommendations.
The future of Flemish cluster policy – Green Paper (Advisory report 36; May 2024)
VARIO was also asked for advice by minister Brouns regarding the green paper ‘The future of Flemish cluster policy’. According to VARIO, spearhead clusters have an obvious place and role in contemporary innovation policy in Flanders. As for the future, VARIO prefers a cluster policy with a continued focus on economic valorisation, but in addition also a role in tackling the societal challenges with a strong link to Transformative Innovation Policy. In answer to a specific question of the minister, VARIO suggested setting up an open call for new strategic themes with rigorous selection but avoiding ad hoc initiatives.
Towards higher productivity growth (Advisory report 37; November 2024) Productivity growth has been declining in Flanders for two decades, more than in comparable economies. Higher productivity growth allows more financial resources to be generated, making new investments permanently possible, especially in innovation and infrastructure, to realize sustainable transitions. VARIO made an international overview of policy advice on productivity. VARIO wants to help shape Flanders‘ productivity agenda and therefore calls for a better study of Flanders’ productivity performance, for a sharpening of R&D&I policy and for other policy domains to be involved in transverse innovation policy.
Opportunities and needs for the Flemish defence industry and -innovation (Advisory report 38; November 2024)
“The geopolitical reality has changed drastically in the recent years. Partly because of that we saw an increase in the number of initiatives at federal, European and international level related to the security and defense industry and innovation. These developments are also important for Flanders, given the interfaces and overlap of all this with Flemish (economic) interests and strengths”, Flemish Minister for Innovation Brouns argued, asking VARIO for advice in April 2024. In the meantime, the new legislature has commenced. For the first time, the Flemish Coalition Agreement 2024-2029 includes defence as a strategic sector. VARIO believes that the commitment in the Flemish Coalition Agreement must now quickly lead to a clear, consistent, and stimulating policy framework for the defence industry and innovation. Several barriers need to be removed and certain elements facilitated.

Simon Bolivarlaan 17, bus 345 - 1000 Brussel Tel.: 02 553 24 40 - vario@vlaanderen.be - www.vario.be
The Council of Flemish Universities of Applied Sciences and Arts (Vlaamse Hogescholenraad) wants to collaborate internationally in education and research domains within European university consortia and further develop and implement their international strategies.
In 2023, the Flemish Government decided to support these ambitions with a subsidy. Thanks to this subsidy, the following activities were carried out:
Strengthening the capacity of the central research services
The research service was expanded in all thirteen Flemish universities of applied sciences and arts (UASA). In all institutions, people were appointed as the single point of contact (SPOCs) for research groups. This strengthened capacity was aimed at developing or further expanding international networks, increasing participation in international subsidy projects and building up knowledge about internationalisation and transferring it.
Strategic plan for internationalisation of research & innovation (R&I)

Ria Bollen, Policy Advisor Research & Innovation at the Council of the Flemish Universities of Applied Sciences and Arts
The vision for the internationalisation of R&I was developed through participatory processes within the UASA. Some institutions set up internal working groups with the participation of central and decentralised support staff. During the meetings, UASA shared information, knowledge and experiences. Research groups discovered each other’s international activities, often resulting in increased coordination and collaboration. UASA implemented process optimizations and established or refined internal agreements for researchers planning to submit new project proposals or undertake mobility activities. Some UASA improved their English-language websites or created new English-language web pages, making them more accessible for international partners to discover UASA expertise. Some also made significant efforts to register or join a European University Alliance. In these institutions, an internal committee was established to prepare project proposals for successful submission. All UASA submitted their multi-year strategic plan to the board to strengthen their R&I capacity.

A series of generic indicators has been developed in consultation with all institutions. A dashboard on the indicators was created and implemented in the thirteen UASA. This allows better monitoring and enables institutions to follow up more closely their international activities in R&I and to provide input for the follow-up and optimization of their policies.
The first sessions focused on exchanging ideas, knowledge and experiences regarding the development of the strategic plans. They inspired each other in areas such as mobility, participation in European Universities Alliances and strengthening the capacity of central and decentralized services. In December they organised a learning network with five thematic topics.
The Council of Flemish Universities of Applied Sciences and Arts coordinated the project. Despite the fact that the project only ran for one year, it created an important leverage effect to strengthen the internationalization of R&I in a very short time. There were noticeable increases in the number of project proposal partners, the number of submitted project proposals, professionalization, mobility of researchers and participation in the EUI.
Thanks to the subsidy, the organizational capacity for R&I could be increased and there was room to develop a shared vision and strategy for the internationalization of research and innovation. The necessary foundations for the success of these plans were laid in 2023 and will be further strengthened in the coming years. Today, the UASA are ready to develop international partnerships with greater ambition that contribute to the quality of education and the transfer of knowledge to the regions. And all of this is valuable for European progress.

Council of the Flemish Universities of Applied Sciences and Arts
www.vlaamsehogescholenraad.be/en/
Contact: Ria Bollen - Policy Advisor Research & Innovation
Tel.: +32 (0)476 31 00 90
Email: ria.bollen@vlaamsehogescholenraad.be www.vlaamsehogescholenraad.be/nl/contactpersoon/ria-bollen https://www.linkedin.com/in/bollenria/
What services do you provide to entrepreneurs?
VLAIO is the agency of entrepreneurship and innovation of the government of Flanders. Its clients are the companies in Flanders. Thanks to our own front office, we can answer their questions, deliver guidance, send advisors to the company’s location to discuss business cases as a whole and innovation in particular, and match them with the relevant members of our network of partners. On top of that we can give companies in Flanders some basic advice on intellectual property, a key aspect of innovation, and we also provide them with financial support for their projects, be it directly or indirectly via other Flemish agencies. Since we have a wide portfolio of grants and subsidies, most of the financial support to companies is given by VLAIO. Subsidies can be granted to professionalize the staff of SMEs or help their growth; they can also be allocated to bigger companies wishing to make an investment to reduce their ecological footprint. Last but not least, our subsidies are mostly focused on R&D and innovation. And let us not forget the fact that VLAIO is an internationally oriented agency: as such, we are the coordinator of the European Regional Fund for Development in Flanders and we also act as contact point for European subsidies in the framework of Horizon Europe and other European research programmes.

How do you help foreign entrepreneurs and investors to establish or expand business in Flanders?
This task is carried out in close collaboration with FIT (Flanders Investment & Trade): with about hundred officers around the world, FIT enjoys a strong connection with potential foreign investors. When one of them shows interest to settle down in Flanders, VLAIO and FIT join hands to give that potential foreign investor advice and provide him with the right partner. In terms of advice VLAIO proves to be a privileged partner considering the amount of information we have about subsidies for investments. Since foreign companies are often willing to carry out R&D activities in Flanders, VLAIO can connect them with universities and other knowledge institutions. We can also help them to find a location with the close cooperation of municipalities, project developers, realtors and (air) port authorities.
What support do you offer for research & development?
We offer direct financial support for R&D activities and encourage companies to collaborate with universities and other institutions and/ or companies. This incentive is in no way compulsory but it remains interesting given that R&D is a hazardous process: it can fail to yield the expected business results. That is why cooperation enables risk sharing while subsidies encourage risk taking by companies.


There are two kinds of subsidies. The first one covers research projects with a lower TRL, i.e. a focus on knowledge generation that implies a bigger support; higher development projects with a higher TRL, closer to the market and therefore less risky (which implies a smaller support); joint projects between companies or between companies and universities; and incentives for PhD students and postdocs to work in a company (this incentive has been very successful over the last years). The second kind of subsidies is related to the various European networks (Eurostars, European partnerships, Eureka…) in which VLAIO funds Flemish players in international consortia supporting international collaboration and creating a leverage to European cofunding. In addition, in its function as national contact point, VLAIO guides companies to join European programmes such as Horizon Europe.
How do you help innovation clusters in Flanders to increase their competitiveness?
Clusters are an important instrument to promote cooperation and innovation within the same value chain. We mainly support six spearhead clusters: Catalisti (sustainable chemistry), Flanders Food, VIL (logistics), Flux50 (energy innovation), Blue Cluster (economy and innovation in the North Sea) and the youngest one, Medvia (healthcare innovation). VLAIO grants subsidies for cluster projects. For instance, Blue Cluster has recently launched the project Blue Marine with the aim to develop technologies for growing plants in the North Sea: these sea farms are interesting for various sectors, such as the pharmaceutical industry and the textile industry. Thanks to this project, different sectors work together via a very innovative, atypical approach which can benefit everyone. VLAIO also supports smaller innovative business clusters (eleven at the moment), which are bottom-up initiatives launched by companies active in drones, offshore energy, etc.
Recent developments
As of 2020, VLAIO has taken an active role in supporting enterprises during the COVID-19 crisis by providing funds to alleviate the direct financial impact. In the recent period, the emphasis has shifted from mitigating the impact of the crisis to the relaunch and recovery of the economy. VLAIO managed several projects within the Flemish Resilience Plan, partially funded through the European Recovery and Resilience Fund (RRF), and has opened a call within the RePowerEU initiative. In this relaunch Flanders actively supports the evolution to a low emission economy, sustainability, digitisation etc. and pays attention to working in missions. VLAIO did provide funding for projects in European value chains in the context of the Important Projects of Common European Interest (IPCEI) to support industrial transitions focussed on climate and digital transition and committed support for the European Chips Joint Undertaking with a major Pilot Plant in Flanders as an eye-catcher. VLAIO also takes up an active part in the newly established governmental frame to support Flemish companies affected by the rising energy prices and works on new formats for funding such as contracts for difference in which funding is determined by the amount of emission reduction realized.



Howest, the University of Applied Sciences is more than just a place where young people come to learn. As a knowledge institution, one of the key roles is to act as a research and service partner for organizations and companies in West Flanders and beyond. Last year, there was a significant increase in projects funded by European resources for projects who help companies transition to a sustainable future.


Anticipating the future is what Howest, the University of Applied Sciences, has in mind. This vision is reflected in the education of more than 11,000 students, but also in practice-oriented research and valorisation efforts, designed to benefit companies and society. Our researchers continuously monitor new trends and technologies. This way, we can provide companies and organizations with innovative yet highly practical solutions.
Howest is involved in 180 running research projects, both in collaboration with companies, other universities, non-profit and social organizations. Remarkably, 2023 saw a significant increase in projects funded by European resources, including those through the Flemish ERDF program (EFRO). This program aims to strengthen the sustainable growth and competitiveness of Flanders, while simultaneously accelerating the transition to a low-carbon, circular, and energy-efficient economy. Howest contributes to this through research projects such as R3PACK, Manufacturing Excellence 4.0, and Resilient. These projects focus on smart solutions that help companies transition to a sustainable future, with particular attention to circular processes and technological innovation.

R3PACK stands for Reduce, Reuse, Rethink Packaging. With new European legislation for companies, the challenge of extensive recycling is becoming increasingly urgent. One of the measures

is the Packaging and Packaging Waste Regulation (PPWR), which defines targets related to reuse, recycling rates, and the implementation of recycled content in packaging. ‘The focus here is on non-household packaging, from industrial packaging to beverage cups,» says Howest researcher Katrijn Sabbe from the Howest Circular Solution Lab. Such packaging often stays under the radar but is crucial for achieving European recycling targets because of its large volume.
With the R3PACK project, Howest - in collaboration with Ghent University and industry partner Centexbel - aims to support companies in implementing the various targets. «We are developing cases where solutions are presented to companies, showing that the Packaging Waste Regulation offers many opportunities and doesn’t necessarily have to be seen as a threat,» says Sabbe. «We support companies with tailored advice on recycling and the implementation of reusable packaging concepts. Together, we are building a sustainable future for the textile and plastics processing industries in West Flanders.»
Manufacturing Excellence: industry 4.0 transformation

For the manufacturing industry, the transformation to Industry 4.0 is crucial. To remain competitive, production companies aim for manufacturing excellence, continuously improving in terms of quality, cost, reliability, and sustainability. Many tools are already available, but there is no standard approach or one-size-fits-all solution.
Therefore, Howest is working with Ghent University, Sirris, and POM West Flanders on the Manufacturing Excellence 4.0 (ME) project, where research infrastructure is installed to conduct measurement and experimental campaigns at SMEs to validate production innovations. This equipment enables the demonstration of expertise and technology on-site at companies. «For example, the measurement infrastructure will make it possible to create a digital twin of the entire company network,» says Howest researcher Jonathan Maes from the Howest Business Innovation Lab. «Or to test whether a private 5G network can offer improvements over Wi-Fi in certain cases, save electricity through insights from energy sensors, and enable employees to receive efficient and effective operator support and training via Extended Reality (XR). This helps production companies integrate the latest Industry 4.0 technologies and methods.”
VEG-i-TEC Resilient: accelerating the energy transition

Howest is also contributing to innovation in the food industry, which is well-represented in West Flanders. The Smart Food Hub VEG-iTEC - a collaboration between Howest and Ghent Universityserves as an accelerator to help food companies innovate and meet their energy- and water-related KPIs, become less dependent on energy and water prices, and control raw material shortages and production costs. All this is achieved without compromising the quality and safety of the finished product.
«In the Resilient VEG-i-TEC project, in collaboration with TUA West and POM West Flanders, research is conducted on how new fixed and mobile infrastructure and advanced smart energy and water management can lead to optimizations in water, electricity, and heat in agri-food companies,» says Howest researcher Jurgen Van Ryckeghem from the Howest Energy Lab. «This way, we achieve more resilient, sustainable, and smarter food processing in the West Flemish region, allowing innovative scientific solutions to find their way into the industry more quickly.»
On March 27, 2025, the kick-off of mission-driven research at Howest will take place, where we aim to create even more societal impact. We invite researchers, partners, companies, and others for an inspiring day full of innovation in our new campus in Brugge. Curious? More info at www.howest.be
University of Applied Sciences
Marksesteenweg 58 - 8500 Kortrijk
Tel.: +32 (0)498 67 16 54

Email: research@howest.be http://www.howest.be


The early years of this decade have starkly highlighted the complexity and fragility of supply chains, underscoring our world’s deep interconnectivity and how swiftly disruptions can occur. Concurrently, the imperative for widespread decarbonization across all facets of society has become clear, essential for ensuring a liveable planet for future generations.


In this landscape, VIL, Flanders’ leading cluster for logistics innovation, along with its over 700 members, two-thirds of which are SMEs, rises to these challenges. VIL actively explores, supports, and engages in innovative and sustainable logistics projects.
“Our primary focus is on pioneering logistics projects and their subsequent implementation. Together with our members, VIL has identified four key areas for these projects: digital transformation, last mile delivery, hinterland connectivity, and green logistics,” states managing director Liesbeth Geysels. “VIL also serves as a facilitator, bringing together various key stakeholders around critical innovation pathways and fostering collaboration.”
Matchmaking: LogiLAUNCH®
With LogiLAUNCH, VIL supports Flemish startups with disruptive logistics innovations by organizing speed-dating sessions with mature cluster members, shippers and logistics service providers. This initiative is designed to help startups scale up their operations and bring their solutions to market.
LogiLAUNCH offers a structured pathway for growth, encompassing mentorship, networking opportunities, and access to VIL’s extensive knowledge and resources. Through LogiLAUNCH, VIL aims to foster a dynamic ecosystem where innovative logistics solutions can thrive, contributing to Flanders’ position as a leading logistics hub in Europe.
VIL is deeply committed to international initiatives, emphasizing coordination and collaboration with global cluster organizations while providing guidance to its members. VIL actively participates in European projects, either directly or by supporting its members through joining various consortia in European-funded programs. One notable example is the DISCO project (Data-driven, Integrated, Synchromodal, Collaborative, and Optimized), involving 48 European partners working together to create sustainable solutions
for on-demand city logistics and exploring secure data-sharing opportunities via data spaces in urban logistics.
“In collaboration with the city of Ghent, IMEC, and Be-Mobile, VIL leads the living lab to develop the Dynamic Access Control concept. This concept integrates access rules information into transporters’ planning systems, transforming it into a practical and applicable system in Ghent’s city centre,” says Kris Neyens, manager of internationalization.
Showcasing innovation at Log!Ville
Log!Ville, VIL’s state-of-the-art logistics demonstration and experience centre, stands out as a unique facility in Europe. Companies can visit and explore real innovations in the physical demonstration area, where Log!Ville partners showcase mature yet not widely adopted solutions ready for implementation. The Digital Experience Centre at Log!Ville invites visitors to delve into the future of logistics, focusing on groundbreaking technologies that help companies become future-proof. Here, visitors can explore the potential of tube logistics with the hyperloop, the extensive applications of AI, dark warehouses, future fuels, and much more.
Log!Ville targets both the trends of the coming decades and market-ready innovations. As a living laboratory, Log!Ville provides a unique environment for demonstrating and testing advanced solutions in sustainability, digitization, and automation. By inspiring and supporting companies in discovering efficient and eco-friendly technologies, Log!Ville plays a crucial role in transforming logistics.
And, new in september 2025, will be the additional immersive room around circular logistics.

In the next thousand years, science may take us far away. At the same time, it can also make sure we have a home to return to. A world where we use resources wisely. Where we don’t change the climate, but adapt to it. And where humanity thrives just as much as the environment we live in. At VITO we accelerate breakthrough innovation, turning scientific insights into practical technologies and real-world applications.

We accelerate technological breakthroughs and mobilise the power of science & engineering to achieve innovations that foster sustainability. Expert scientists are organised in unique domains and cross-disciplinary research programs within VITO and its partner networks. Leveraging our unique test and scale-up infrastructure, we test and improve the viability and scale-up potential of sustainable innovations and reduce their adoption risk. By valorising our solutions worldwide and creating and supporting start-ups, we enable their adoption in viable economic, industrial and societal networks to ensure benefits get reaped in the real world.
In a sustainable future, people, nature and economy are always in balance. With knowledge, innovations and technology, we can make a difference in the transition towards a regenerative economy, resilient ecosystems and a healthy environment.
VITO is a driving force in the transition towards an economy where the focus is on the sustainable management and use of natural resources. In the sustainability transition, well-integrated ecosystems are aligned, allowing them to reinforce each other. Think of the exchange of waste heat between companies so it does not go to waste, integrated management of water or the use of waste products as raw materials. Circularity, bio-economy, water and energy are our spearheads within the broad raw materials domain.
We want to shift from the current economic models towards an economy that fully operates on sustainable resources and enhances environmental, social and economic conditions simultaneously.
We map climate risks, provide technological solutions and develop scenarios for a resilient future. This is needed in response to the increasingly erratic and unpredictable climate of today and tomorrow. The end goal remains limiting temperature rise and carbon neutrality in Europe by 2050. Adaptation and resilience are key spearheads here for VITO, to deal with the impact of climate change and to act decisively in the event of a crisis.
We create resilient ecosystems that are designed to withstand and adapt to various challenges, reducing our vulnerability to calamities and enhancing our safety.
A nice, healthy and sustainable environment for everyone to live in is a key element of VITO’s vision. Health, social justice and economic prosperity are central to this. VITO contributes to this by, among other things, developing models and technologies for measuring and minimising the harmful impact on people and the environment (water, soil, air) and realising a viable urban infrastructure. In the small, densely populated region of Flanders, this challenge is great, but by starting from different areas of expertise, we can develop integrated solutions.
We want to create healthy environments and living conditions to support human health and well-being. Ensuring clean air, water and soil. And ensuring access to nutritious food and safe, decent, and affordable housing in smartly organised public space.

VITO NV
Boeretang 200 - 2400 Mol E-mail: vito@vito.be http://www.vito.be
Voka Health Community is an ecosystem of more than 600 welfare and care institutions, businesses, knowledge centres and patient groups. Within the Voka Health Community they work together to create and valorise added value through innovative solutions in (health)care.
Voka Health Community focuses on three major building blocks:
- Integrated and high-quality care and care delivery that focuses on prevention and health promotion
- Innovative business development around care organisation, technology and digital transformation
- Solidarity-based social security with financing that stimulates doing what is right following the value-based healthcare principles.
A contemporary (health)care system that is adapted to the future needs is possible: a more digital care with a focus on prevention and an alignment of tasks with respect and motivation for the care profession will help us move forward and help us to tackle the challenges in welfare and healthcare.
Staff shortages are the number one. The ageing of the population is a triple challenge: with the increasing number of elderly people, our care needs are becoming not only larger, but also more chronic and complex. Our care system must therefore meet both a greater volume and more intense care needs. The third effect is due to the ever-shrinking active population. In 1991, the care and financing of 1 elderly Belgian was carried by 4 pairs of active shoulders. In 2050 that number will have halved to 2. We will have to bear the greater number of elderly people and their complex care needs with fewer and fewer people. The labour market on fire? You ain’t seen nothing yet.
Therein lies a great paradox: according to the Organisation for Economic Co-operation and Development (OECD), Belgium has a quarter more active nurses than the OECD average. Generally, they appear to be better educated than in other countries. The diagnosis: our health personnel lose time with administration, logistics and household tasks while the norms keep the door open for support staff. The shortage of personnel in the healthcare sector is causing major and justifiable headaches.
This brings us to digitisation. The care sector is still walking around in the digital 90s. Paper forms have been replaced by exactly the same digital ones. So, a lot of opportunities remain unavailable. A digital transformation goes further: besides collecting data, you also have to analyse and evaluate them and adapt your way of working. Digitalisation must support healthcare staff in organising and coordinating care efficiently, instead of frustrating them – and their patients – endlessly.
The key to achieve a digital transformation in health is not to develop the necessary technology. Smartphones, apps, mobile sensors: the technology is already there. The challenge lies in regulating and implementing that technology so that it supports

the goals around quality and affordability. Europe is leading the way here with the European Open Data Area. In Belgium, hospitals and home care institutions are already working to make their data not only available but also FAIR: findable, accessible, interoperable and reusable. With some investment in capacity and digital competences, this will receive an enormous boost. With Voka Health Community we will commit to implementing technology and innovation in the health and care sector.
Besides digitalisation, focusing on self-care and prevention is a no brainer. Today, Belgium spends 1.6% of its health budget on prevention, while the World Health Organisation’s target is 5%. Investing in prevention prevents up to 80% of cardiovascular diseases and diabetes, and up to 40% of cancers. People who do not fall ill, fall ill less or fall ill later, need less care.
Within the Voka Health Community, we set to work together. We use the evolutions in science, innovative ideas and the experiences of our members to move forward. You can find information about Voka Health Community, our activities and our publications on www.voka.be/healthcommunity.
Daan Aeyels
+32 475.298.377
Daan.Aeyels@voka.be www.voka.be/healthcommunity

In its sustainability report for the technology industry in Belgium, published in 2023, Agoria informs about the progress of the sector in the field of sustainability.
With this report, realised in cooperation with its 2,000 members and stakeholders, Agoria fulfils its responsibility to communicate transparently its sustainability strategy, with clear engagements and the impact of the sector. The report can be considered as a baseline measurement, the indicators and data of which Agoria will continue to supplement in the coming years. “With our sustainability report, we want to inspire companies within and outside our sector to integrate sustainability even more into their business operations. Committing to sustainable change will be the decisive factor for the future of our companies,” says Jolyce Demely, general director of Agoria Flanders.
“Technological innovation is the driving force of our industry. Our motivation to innovate stems from the ambition to continue creating added value for society, including in the long term. The manufacturing industry is the engine of Belgian export and prosperity. Every job in the manufacturing industry creates at least one other in related service sectors. Almost one in four Belgians earns his or her income thanks to the industry. But high labour costs, the automatic index and inflation put pressure on the added value and competitiveness of Belgian manufacturing companies. Furthermore, the current energy crisis makes it even more difficult for our companies to grow and invest. Research and development are crucial to continue creating added value and jobs from the technology industry and the manufacturing industry in particular. Only by transforming into ‘factories of the future’ - agile, digital, technological and people-oriented u,ndertakings - can our manufacturing companies embed production activities sustainably in a hyper-competitive global economy. Continuous innovation is therefore a necessary precondition to securing the long-term future of the manufacturing industry in our country,” says Demely.

Demely, general director of Agoria Flanders
In 2023, only 7% of Agoria member companies were working on a circular project. “We want to significantly increase this to at least 50% by 2030. We also want 95% of our member companies to have a cybersecurity plan by 2030. Agoria insists that companies are well prepared for a cyber attack. In terms of digitalisation, we aim for a top 3 position within the EU in the integration of digital technologies in 2025. In 2023, Belgium occupied the 6th place on the European DESI index for that indicator.”
“In our sustainability report, we commit ourselves to create a net 40,000 additional jobs compared to 2020 and fill them by 2030. In addition, we make sure that employees in our sector know what competencies are needed for their jobs in 2030 and that they receive the necessary training. Currently, the technology industry employs more than 328,000 workers in Belgium. Between 1 January 2021 and the end of March 2023, the Belgian technology industry created a total of 18,000 new jobs. This comes down to 32 additional jobs per day. Having already created 18,000 of the promised 40,000 jobs, we are well on track to achieve our goal by 2030.”
Jolyce Demely Jolyce.demely@agoria.be www.agoria.be
Agoria’s commitments:
• We focus on ‘workable employment’ to keep employees in the sector.
• By 2030, we aim to employ 40,000 more people than in 2020.
• We make sure that employees in our sector can ascertain the skills they will need for their job in 2030 and we provide them with the necessary training.
Technology not only creates economic value, but also helps society in many other areas. For example, technology plays a key role in improving traffic safety, strengthening healthcare, fighting and dealing with pandemics and tackling the increasing ageing population. Technological innovations are also vital to the success of the green transition, just think of CO2 capture and storage, smart energy grids or electric vehicles. In short: without technological innovation, we would live in a less safe, comfortable, healthy, sustainable and connected society. “From our sector, we strive to maximize all such positive impact of technology, while keeping an eye on related concerns, such as the ethical use of AI, the impact of technology on organizations, universal access to digitization and ensuring privacy,” she adds.
• We strive for annual improvement in the male/female ratio in the technology industry, and have set a target of 25% women in leadership positions by 2030.
• We support activation programmes for older employees, young women, and youth: Not in Education, Employment, or Training (NEET).

An interview with Mr Luc VAN DEN HOVE, President & CEO, imec

What are the key figures of R&D at imec?
As a global team of over 5,500 talented employees from more than 100 nationalities, we are headquartered in Flanders, Belgium and have distributed R&D groups at a number of Flemish universities, as well as in the Netherlands, the USA, and representation in 3 continents. Our collaborative approach bridges the gap between academia and industry, facilitating the rapid transfer of knowledge and technology from the research lab to the market.
Could you introduce your expertises?
The combination of top talent, unique infrastructure, and our worldwide partner network makes us a world leader in nanoelectronics and digital technologies. Since our inception, 40 years ago, we are at the forefront of advancing semiconductor technology to smaller nodes at higher performance at affordable cost and more sustainable. Every smartphone includes microchip technology invented by imec.
While microchip technology is at the core of what we do, our impact extends significantly across key application domains. We play a vital role in advancing innovation in health, automotive, agritech and energy. Our R&D expertise is dedicated to driving disruptive changes and advancements within these crucial application domains and beyond.
How is imec collaborating with companies across the world?
We offer R&D partnerships as well as innovation services. We firmly believe in the synergy of R&D collaboration. Together with universities, companies and public stakeholders, we aim to
maximize knowledge and expertise to push technology forward. All our R&D partners benefit from the unique assets that imec offers such as our state-of-the-art infrastructure, our top-of-the-class international talent with multidisciplinary scientific background, our unique IP, and our one-of-a-kind ecosystem of local and global partners including universities and world-leading companies from a multitude of industries.
Our unique environment ensures more interactions, higher creativity and better integrated technologies. Next to our R&D program offering, we also work together with companies on a bilateral basis, for private research. This can be an R&D collaboration supporting companies with the development of technological solutions to innovate their products and services. But this is not limited to R&D support: we offer support throughout the entire lifecycle of the innovation process. Whether it is hardware, software, or both. And for innovators from around the world, as well as for local initiatives in Flanders.
In 2024, imec announced that it received funding from the EU and from the Flemish Government to install the NanoIC pilot line. What is the NanoIC pilot line?
The NanoIC pilot line is an initiative set to boost Europe’s economy, aligned with the European Chips Act’s vision of achieving global leadership in semiconductor innovation. It entails the design of a beyond-2nm system-on-chip (SoC) pilot line to develop advanced logic, novel memories, and innovative interconnects to enable future compute systems that will significantly impact critical markets such as automotive, consumer electronics, high-performance computing, and healthcare. The NanoIC pilot line will provide the semiconductor ecosystem access to these advanced technologies at a higher TRL level compared to imec’s current R&D offering. By doing so, European innovation and competitiveness across the value chain can be ensured - from semiconductor materials, equipment and design to systems and applications.
How does the NanoIC project foster collaboration across Europe?
We are proud to partner with top European research institutes CEA-Leti, Fraunhofer, VTT, CSSNT-UPB, and Tyndall for the NanoIC pilot line. Together, we will accelerate R&D and advance technologies. The project also invites collaboration from foundries, IDMs, material suppliers, equipment suppliers, and system companies to jointly develop the materials, process modules, and integration flows necessary for beyond-2nm SoC technology. Additionally, the NanoIC pilot line offers training programs, internship opportunities, and access to affordable design tools and prototyping services to build a skilled EU semiconductor workforce.

Becetel combines more than sixty years of expertise, total independence and extensive testing facilities, which is unique in Europe. A wide range of companies, organisations and certification bodies call on the services of this ISO 17025 accredited laboratory for testing plastics pipes and fittings.
The Belgian Centre for Technological Research on Pipes and Fittings started as a spin-off of Ghent University. By now, it has grown into a test laboratory with international allure. “We limit our field of activity to testing plastics pipes and fittings,” says general manager Joris Vienne. “Things however changed over the years. In our early years there was only PVC, today a wide range of plastics is used in piping. Initially we only worked with piping materials for potable water and gas. Today, you can find plastics piping in all utilities, industrial processes, rainwater infiltration, waste water treatment and construction… By participating in international symposia, training and research, our knowledge also evolved. As a result, Becetel has become one of the few laboratories with extensive knowledge in this specialized field - something highly valued by our customers, most of whom are based outside Belgium. With the evolution of PE 100 to ‘slow crack growth resistant’ PE 100-RC materials, Becetel has also invested in specific testing equipment for this new generation of materials.”
Becetel always proactively translated its knowledge into test equipment. “We continuously invest in new solutions”, says Vienne. “Thanks to our in-house expertise and creativity, we regularly succeed in creating our own solutions. For example, we have our own installations for the accelerated Notch Pipe Test (aNPT), the Plain Strain Grooved Tensile (PSGT) test and various creep tests. These solutions are developed either in cooperation with equipment suppliers or in our own mechanical workshop with equipment for turning, milling, drilling, sawing and welding and a CNC milling machine.” A recent extension is the capacity to perform complex pressure cycling tests.
Of course, Becetel has a lot of other test infrastructure: large water tanks for hydrostatic pressure testing, pressure stations, universal testing machines with load ranges from 0,5 kN to 400 kN and equipped with extensometers (contact and video non-contact), temperature chambers, impact testers, pressure cycling units, data-logging equipment, ultrasonic thickness gauges, hardness testers, flow meters, fusion machines, torque wrenches, dimensional measuring equipment, height and strain gauges, thermocouples… “We have a temperature conditioned lab for the dimensional measurements, creep testing and multiple universal testing machines for determination of tensile, flexural and compressive properties,” Vienne explains. “In our multifunctional hall we perform hydrostatic pressure tests, impact tests, leak tightness tests, temperature cycling tests… There is also a lab for physical properties, such as MFR, DSC, Vicat, thermal stability testing, IR analysis… And microscopic facilities for failure analysis. We can handle various pipe diameters, from 8 till 2000 mm.”

Today, Becetel mainly performs mechanical tests on plastics pipes, including fusion joints, connections and accessories. “We also have an extensive experience in performing rapid crack propagation (RCP) tests, formerly with the full-scale test site and since decades with the S4 (Small-Scale Steady State) test,” says Vienne. Furthermore, Becetel developed software to perform the Standard Extrapolation Method analysis described in ISO 9080. “Because we have built or modified some of our testing equipment ourselves, we can even perform tests that fall outside the standards. We also accumulated experience in the testing of elastomers (ageing, compression set...). Becetel also acts as a partner in various standardisation and certification systems and we are actively involved in the international standardisation committees of CEN and ISO. It is regularly called in as an expert in the event of claims related to failures in plastics.”

Becetel vzw
Gontrode Heirweg 292
B-9090 Merelbeke - Melle
Tel.: +32 (0)9 272 50 70
E-mail: info@becetel.be http://www.becetel.be


-The emerging field of nano-science and nano technology has been driven by and requires the development of innovative tools and techniques for observations at nanoscale. Single molecule microscopy is a prominent tool with a high non-invasive character for this kind of research. It also is the speciality of the Hofkens Laboratory at KU Leuven.
Over the past decades, optical spectroscopy and microscopy at the ultimate limit of a single molecule have grown into extremely powerful techniques for exploring the individual nano-scale behaviour of molecules in situ and in real time in complex local environments,» says lab leader Prof. Dr. Johan Hofkens. «Observing a single molecule removes the usual ensemble average, allowing the exploration of hidden heterogeneity in complex condensed phases as well as direct observation of dynamic changes.»


The best description of the Hofkens laboratory research vision is a quote from ‘Chemistry for the next decade and beyond,’ commissioned by the UK Engineering and Physical Research Council: «New insight is generated in laboratories where unique instrumentation is being developed.» The Hofkens lab not only is an active proponent of this view, it also has gone way beyond building unique equipment by applying the instrumentation on a wide variety of timely and societal relevant topics.

«The physical laws governing light diffraction restrict the view with traditional fluorescence microscopes to length scales well above 250 nm. As the biomolecular actors which regulate the fundamental processes of life are typically in the few nanometres range, our ability to gain insights into many biological systems is severely compromised. Expansion microscopy obtains a higher resolution by physically expanding the sample. This results in resolutions up to 10x better than with traditional microscopy.» While expansion microscopy has shown its potential, the technique is still in its infancy. Problems such as signal loss due to poor crosslinking need to be solved.» The Hofkens Lab is working
towards a linker chemistry approach that allows the simultaneous readout of different cellular biomarkers, while better crosslinking individual molecules to the polymer matrix. Linkers and protocols are shared with colleagues worldwide for fast progress in this field.
Another research line involves metal halide perovskites. «These semiconductor materials attracted considerable attention, because of their high compositional freedom and unique electro-optical properties, in combination with low-cost fabrication,» Hofkens explains. «They are extremely promising for applications such as solar cells, LEDs and photodetectors. Fundamental understanding of their properties is key to understand why they work so well. Establishing the structural changes and the charge carrier dynamics of metal halide perovskites under influence of external stimuli (light, temperature, humidity) at high spatial and temporal resolutions will further improve their efficiency.» This research is conducted in tight collaboration with KULeuven colleagues Debroye and Roeffaers as well as with the Max Planck Institute for polymer research in Mainz.

Currently the Hofkens laboratory works on optical trapping, also known as optical tweezers. This microscopy technique allows literally ‘catching (or trapping)’ of small objects (nano particles, cells...) in solution, much like a tweezer, and resulted in a Nobel

prize for its inventor, Prof. Ashkin. “We observed that the trapping surprisingly vastly expands beyond the focused laser spot when applying this technique at interfaces, resulting in nanoparticles that move like swarms of birds, a completely new phenomenon,” Hofkens explains. Through purpose build advanced microscopy, they start to understand the underlying physical principles. Together with imec and partners from other European universities the Hofkens team now investigates if these insights can be used to build cheap and ultra-high density colloidal memories (through funding from EIC, Pathfinder FastComet), highly needed with the widespread digitization of business operations, healthcare, science and personal devices, with an expected 181 zettabytes of data generated by 2025.
A decade ago, the Hofkens Lab developed Fluorocode, a new metagenomic approach for the rapid and high-performance profiling of the microbiome. Due to its -still not fully deciphered - interplay in human health and disease, the human microbiome has been a topic of extensive research during the past two decades. The discovery of new biomarkers, therapeutic targets, drugs as well as routine testing require high volumes of high-quality data to cut through the noise. Better, faster, and cheaper analytical technologies are needed to unlock insights and tap into the microbiome’s full potential for health and wellness such as the one Hofkens and his team develop.
The Hofkens Lab repurposed methyltransferases and developed in-house a method to fluorescently modify the enzymes’ substrate S-Adenosyl Methionine (SAM), to fluorocode metagenomic DNA. Fluorescence along DNA fragments >20kbp form robust taxonomic barcodes with strain-level resolution. This code can be resolved using optical mapping using fluorescence microscopy. Through proprietary analysis code, these fluorescent barcodes are scanned and assigned to the source organism, as such profiling the microbiome with throughputs easily ranging in the gigabase scale. The research efforts, originally funded by an ERC Advanced Grant, resulted in establishing the company Perseus Biomics. This spin-off biotech company is developing DynaMAP, the technology platform based on Hofkens research. Perseus Biomics develops DynaMAP both as a metagenomic service and an integrated benchtop laboratory device.

Double star
Perseus owes its name to a binary star. «It is a reference to us from a joint project between the Hofkens Laboratory for Photochemistry and Spectroscopy at KU Leuven and the École polytechnique fédérale de Lausanne. This started in 2012 and led to the creation of Perseus four years later. Meanwhile, it already employs 25 people. Thanks to a recent round of investment, this could become 35 in the near future. Most employees are postdoctoral researchers or working on their PhDs. There are also lab technicians and some engineers, of course.» In addition to its headquarters in Tienen, Perseus has an IT department in Poland.

Hofkens Lab - KU Leuven
Celestijnenlaan 200F - bus 2404 Chem & Tech Building - B-3001 Heverlee Tel.: +32 (0)16 32 78 04
Email : johan.hofkens@kuleuven.be https://www.hofkenslab.com/
Perseus Biomics
https://www.perseusbiomics.com


“We immediately
As a specialised third-line hospital, the Antwerp University Hospital (UZA) stands for innovation and the latest techniques and treatments. In addition, the hospital is a reliable partner for cooperation with other healthcare providers and medical companies. The UZA also conducts groundbreaking scientific research with an international dimension. “Sharing expertise and resources offers many advantages. First and foremost for the patients.”
With 593 beds and some 620,100 consultations and 51,600 day admissions annually, the UZA is a midsize hospital by Belgian standards. «As a university hospital, we have a wide range of specialized treatments. Much of our added value comes from top expertise for complex and rare syndromes. In doing so, we play a pioneering role in the wider region, both in diagnosis and treatment,» says CEO Prof. Dr. Marc Peeters. «In addition, we promote ‘evidence-based medicine:’ medicine based on scientific evidence. Science, training and innovation are essential, which also ensures that our health care delivery improves for every patient.»

In fact, according to the UZA, the quality of care improves by working together with other hospitals and care partners. Since 2018, UZA is part of Helix, a network of hospitals. The hospitals within Helix are committed to bring a full range of high-quality and value-driven care to patients in the Antwerp region. The future is all about synergy. “Not only with hospitals, but also with education, research institutions and companies operating in the medical sector. In 2023, Antwerp Health Harbour was set up: an innovative health hub in which all healthcare actors in the region work closely together. This is the first step towards the further development of a unique ecosystem in the digital health sector.
For a university hospital, the training of health care workers is also a core task. «Not only for doctors, but also for nurses and paramedics. That is why we have a close relationship with the University of Antwerp and its Faculty of Medicine and Health Sciences, as well as with the associated faculties.»


Besides care and training, basic and translational research is also a main task in a university hospital. «When we conduct research, we immediately take the results into practice. To treat patients better, but also to enrich education. The ‘bench to bedside and back’ principle applies here to the maximum extent. The time and resources needed to ensure continuous training and research are structurally embedded in our organisation. Furthermore, our staff takes on social responsibility from their clinical, pedagogical and/or scientific expertise.»
In 2023, 545 clinical studies were registered at the Clinical Trial Center. 12 UZA employees defended their PhDs in medical sciences at the University of Antwerp. «That year, we also participated in 44 externally funded projects. A total of 226 academic and 206 commercial studies were conducted.»
Over the years, the UZA built a strong reputation on oncology research. Some examples are the research into new biomarkers and microtumours and CAR-T cell therapy.
The university’s Drie Eiken campus connects to that of UZA. Cooperation between the hospital and the university manifests itself in joint project teams, such as oncogenetics. The common aim of the university hospital and the university is to intensify their cooperation

on research and innovation. «On the joint campus, there is still plenty of space available for new initiatives,» Peeters says. «Not only for spin-offs, but also for infrastructure for sports physiology research.»
During 2022, the UZA opened the University Clinical Research Centre Antwerp (Uniccra), the renovated centre for early clinical studies. It is twice the size of the former research unit. “Here we follow up the very first treatments with new drugs. In addition to a completely new day hospital, the centre has an integrated laboratory and more space to bring together specialised teams. The aim is to give patients access to drugs that often won’t come on the market for several years.”
The centre is the dedicated centre for clinical trials. “We do focus on phase 1 and phase 2 studies. These early studies are very labour-intensive and require specific expertise from our study staff. Obviously, it is our priority to put the safety and welfare of our patients first.»
Uniccra is equipped with a completely new day hospital with a monitoring system, an integrated laboratory and a kiosk that allows patients to measure their own blood pressure, pulse, oxygen saturation and weight. Currently, the majority of phase 1 studies consist of cancer studies. «But we want to make the centre available to researchers and patients from all disciplines, both internal and external. The research centre should be an incubator that helps us bring even more studies to our region.»
In 2022, the University of Antwerp opened the research centre Vaccinopolis on their campus in Edegem, specially built for testing vaccines against numerous infectious diseases, such as RSV, dengue or whooping cough. This can further accelerate the fight against new and existing diseases - such as influenza. Study participants first receive a vaccine or placebo and then a reduced dose of a pathogen. This allows researchers to test whether and how a particular vaccine candidate works in an accelerated manner. There is no comparable facility of that size in continental Europe. Vaccinopolis has thirty beds. In some studies, test subjects will spend several weeks in complete quarantine. This is done for safety reasons: the pathogens must obviously not be allowed free rein in society.
Care teams at UZA examine more than 15,000 patients with rare diseases every year. Prof. Dr. Marc Peeters stresses that UZA is strongly committed to their diagnosis and treatment. «According to European research, patients with a rare condition give care a higher rating when a multidisciplinary care team participates in a disease management programme. We therefore share our expertise and knowledge on rare diseases in 15 of the 24 European Reference Networks (ERNs). When healthcare providers share expertise and experience, the faster and better they can help their patients.»




Drie Eikenstraat 655 - B-2650 Edegem
Tel.: +32 (0)3 821 30 00
Email: vragen@uza.be - https://www.uza.be/

The University of Antwerp awards about 250 PhDs every year. It has 23,000 students, 17.5% of whom are from other countries. Together, its nine faculties offer 154 programmes, 29 of which are entirely English-spoken. Together, they also pool a wide range of fundamental and practice-oriented research.

The University of Antwerp has 15 research excellence consortia (OEC), active in various scientific disciplines. They are international signposts that bring together consortia of outstanding researchers. Each OEC has a research manager who supports the consortium’s research strategy and plays a crucial role in identifying and raising funding opportunities,” says Maarten Weyn,” recently (2024) elected vice rector research and impact.
“The core facilities are bundled per area of expertise, but for other equipment a distributed setting proved more appropriate. Although the core facilities are concentrated within certain strategic research groups, other researchers can also use their infrastructure. This fits in with our multidisciplinary approach. The next years, we will focus more than before on infrastructure. After all, this is an important criterion for attracting financing and is also beneficial for external partners. Internal needs will continue to be decisive in these investment decisions. But we will focus more on the coherence between the various investments and on long-term use. This includes immediately building in provisions for possible replacement and deploying this infrastructure for external users, so that this equipment can generate external income.”
Internationally, UAntwerpen focuses on certain research areas. “For example, our EMAT team is a global leader in materials research and electron microscopy. Our expertise in infection and vaccination research within the Vaxinfectio group is also world-class. Consider, for instance, the brand-new vaccine research centre Vaccinopolis, a unique facility in continental Europe. In genetic and cancer research, environment and climate, sustainable chemistry, digital data and communication, social and political policy, we are also very strong. In the Times Higher Education World University Rankings, we have been moving up considerably in recent years. We are now ranked 161 worldwide there. For a university of our scale and young history, that
is a place we can be very satisfied with. Our international appeal is also reflected in our participation in various European Union-supported research projects by academic institutions and partners from different countries, and the increasing visibility and impact of UAntwerpen in society. Our investments in buildings and infrastructure where researchers and companies can think and work together such as BlueApp and The Beacon will further strengthen this in the future.”
In Flanders itself, research is further underpinned by collaborations with federal and regional institutes and agencies, and increasingly with industry. As far as applications are concerned, such collaborations are mainly via the Industrial Research Fund (IOF). This way, we do not stop at continuous fundamental research, but immediately create openings to practical applications. “The research conducted at the University of Antwerp has a strong fundamental basis. In some fields, we are among the best in the world. However, it is equally important for us to translate scientific knowledge and insights into applications of social and economic importance. Today’s society has numerous challenges both at the level of ecology, health, sociology and economy,” says vice rector valorisation and development Steven Van Passel.
“In the past, the link between research and practice was too loose,” Weyn explains. “I want to strengthen that link. That is why my title of vice-rector research has been expanded to include research and impact. We will continue to support the existing centres of excellence, but at the same time we will also focus more on bottom-up free research, so that researchers have more space and variety to collaborate with internal and external partners. This will happen without any obligation to do so. In this way, they will continue to be among the top in fundamental research. Focusing purely on valorisation would detract from this, because then the aspect of knowledge acquisition could come to a standstill every time a practical result is achieved.”

“Financiers such as the Flemish government and the European Union often impose certain themes through their calls, but free research is an absolute condition for creating innovations,” explains Van Passel. “But a good balance between fundamental and applied is necessary to create more valorisation.”
“We are not only going to stimulate collaboration with external partners, but also strengthen that between our Centres of Research Excellence. They sometimes functioned too much as islands,” says Weyn. “That is why we are strongly investing the BOF resources in research projects and in research leaders who can bring several people with them, not with identical, but with complementary spheres of interest. We prefer to embed them in groups, so that they can adopt each other’s good practices. A broader composition of these groups stimulates the exchange of visions.”
“This approach also entails changes in internal communication. Our employees should not only be aware of the research of their colleagues in other disciplines, they should also be proud of it. This benefits the external impact of the entire university. One of the means to do this is to organize more events were people from different areas come together to exchange ideas, knowhow and experiences,” Weyn emphasizes.
Gold nanoparticle research and fashion
Most people wouldn’t suspect there’s a link between supermodel Claudia Schiffer and the powerful electron microscopes at the University of Antwerp. Yet, a recent campaign from fashion house Versace features images of gold nanoparticles, partly made in Antwerp.
The Electron Microscopy for Materials Science (EMAT) research group at the University of Antwerp specialises in studying nanomaterials down to the scale of individual atoms. “Versace came to us through the CIC BiomaGUNE laboratory in San Sebastian, Spain. We’ve been working together with our Spanish colleagues for many years now. They send us nanomaterials, and we then characterise the structure and composition of those materials in great detail,” says professor Sara Bals.
“Gold at the macro level, as we know it, is a very stable material. But at the nano level it’s a different story: the gold particles change colour, a bit like a chameleon, depending on their shape and size. It’s amazing how accurately different shapes can be made. And particles that have the same shape will tend to arrange themselves, a bit like an antique mosaic.”
Versace became intrigued by the changing properties of gold nanoparticles. “The fashion house developed a campaign titled ‘Gold: Versace to the last atom.’ The 2024-campaign emphasised the similarities between the patterns of the gold nanoparticles and those in the fashion brand’s clothing and accessories. Supermodel Claudia Schiffer is one of the models showing an ensemble adorned with a ‘nanoprint’.”
“We love seeing our images used this way. “Obviously fashion isn’t exactly our core business as scientists, but we’re certainly very proud of this collaboration with the fashion world.”
AIPRIL
Antwerp Interdisciplinary Platform for Research into Inequality
CASCH
Catalysis for sustainable organic chemistry
DIGITAX
Digitalisation and Tax
EXPOSOME
From exposome to effect assessment of contaminants in human and animal models
GCE
Global Change Ecology
GENOMED
GENOmics in MEDicine
GOVTRUST
Trust and distrust in multi-level governance: causes, dynamics, and effects
INFLA-MED
Fundamental and translational research into targets for the treatment of inflammatory diseases
IPPON
Integrated Personalized & Precision Oncology Network
µNeuro
Multidimensional analysis of the nervous system in health and disease
MST
Microbial Systems Technology
NANOLAB
Bringing nanoscience from the lab to society
PLASMA
Plasma for environmental, medical, analytical chemistry and materials applications
RCRC
Research Centre on Representatives and their Communication
VAX-IDEA
Vaccine & Infectious Disease Institute
In its more than two hundred years of existence, Ghent University has built up a solid scientific reputation. It invests in both fundamental and high-risk as well as applied research. Consequently, Ghent University is highly regarded internationally for its expertise in life sciences, (animal) medicine, materials science, agricultural and sports sciences, psychology and history.

The top can count on a solid basis: thanks to the universities’ bottom-up research policy, young researchers are given the necessary opportunities to grow. Thanks to the excellent performance of its entire research community, the university has been ranked since 2010 in the top 100 of the Shanghai Ranking - a worldwide ranking based on research indicators - for many years. It is also exploring new horizons in interdisciplinary research. This interdisciplinary approach is mainly expressed in the ten specific interdisciplinary research centres (IDC) established within Ghent University.
The most recent list of scientists who have the most highly cited publications within their research field(s), includes 26 Ghent University scientists. They may call themselves ‘Highly Cited Researcher.’ Worldwide, this honour falls to only 1 in 1,000 scientists. Since 2001, Clarivate Web of Science annually compiles this list. The list is organized by field, but there is also an overarching category. The expertise of the 26 Ghent scientists covers a wide range; from plant biotechnology to biostatistics, often with a strong interdisciplinary approach. The current list includes 95 scientists with a primary affiliation with a Belgian university or research centre. 24 of them are primarily affiliated with Ghent University. For 2 scientists, Ghent University is the second affiliation.
The IDCs are funded through the university’s Special Research Fund. In addition to interdisciplinarity, they also pursue transdisciplinarity and cocreation with non-academic stakeholders. Thus, the IDC Psync is a model for a new form of research collaboration on mental health. Gray (Ghent University Research for Aging Young) is an IDC aimed at boosting healthy ageing through translational research,


social impact and valorisation of new solutions, interventions, products and services. This IDC brings together expertise in the biology of ageing, health promotion, healthy behaviour (exercise, nutrition, mental wellbeing and cognitive behaviour), geriatrics, environments that encourage healthy ageing and the use of adaptive technologies within the field of ageing.
In addition to the IDCs, there are the IOF platforms. These platforms stand at the intersection of different research domains and have an eye for the innovation needs of industry. In this way, they meet the growing social and economic importance of interdisciplinarity. The IOF network consists of a number of business development centres that bring together complementary research departments per application area or domain of expertise. Each centre is responsible for technology transfer within its area of competence.
The Belgian zone of interest in the North Sea is much smaller than that of the other coastal states, but it is intensively used. By shipping, for various submarine cables, for fishing, mussel farming, sand extraction and for offshore electricity production by wind turbines. Ghent University is actively involved in researching the various economic and ecological aspects of the blue economy. On its Ostend campus, the university invests in labs and personnel through the company Bluebridge. In addition, together with the port and the province of West Flanders, the university has founded Ostend Science Park, a ‘blue’ science park. By allowing more expertises to work together and linking them, the university wants to reconcile the values of ‘good for the ecosystem’ and ‘good for the economy’. Among other things, it is trying to find out whether artificial oyster reefs break the waves, so that it would no longer be necessary to blow up sand to keep the Flemish coast intact.
Ghent University is currently ranked as the top Belgian University and fifth European university in acquiring European Research Council (ERC) funding. This means that the success rate of Ghent University applications (28%) is twice as high as the European success rate (14%).
The list with 255 names of outstanding research leaders, announced by the ERC during the spring of 2024, includes four researchers based at Ghent University. The funding is amongst the EU’s most prestigious and competitive, providing leading senior researchers with the opportunity to pursue ambitious, curiosity-driven projects that could lead to major scientific breakthroughs.

Over the last decade, misinformation (including disinformation and malinformation) has become a main concern of policy makers, the media, academic researchers, and the general public. In the ERC-project Vigilia, Tijl De Bie investigates a novel strategy to address the so-called post-truth challenges.
The Vigilia approach is axed around the detection and mitigation of triggers of cognitive biases and heuristics in humans and societies when consuming and sharing information, whether true or false. Human activities undeniably contribute to global warming through the release of greenhouse gases. Approximately 2% of these emissions stem from the chemical industry, primarily from the production of fundamental chemicals like ethylene and propylene. These chemicals are crucial for manufacturing a vast array of materials, including polymers, which are utilized in massive quantities worldwide each year.

In the ERC-project e-Cracker Kevin Van Geem and his team pave the way to avoid more than 200 Mt CO2/year emissions with a scalable, flexible, step-by-step implementable technology driven by renewable electricity. Rather than relying on conventional combustion methods, their vision is focussed on pioneering a groundbreaking Power-toHeat (P2H) reactor.
Combined with insight in the pressure-dependence of the cracking chemistry this will allow to avoid undesired side reactions and to increase olefin yields from ethane and from plastic waste derived naphtha cracking, when applying alternative P2H such as resistive heating.
By studying sources in other languages than Latin and Greek, The New Polities project, coordinated by Peter Van Nuffelen, will use late-antique ideas, for example about equality, hierarchy and tolerance, to engage in critical dialogue with current discussions. This way, it will not only revise the position of Late Antiquity in the history of political thought but also rewrite the way history is usually presented.
Assumption-lean (Causal) Modelling and Estimation
Statistical models help to gain insight into data by simplifying a complex reality into its most essential components. However, this simplification can lead to significant distortion of associations and effects. In the ERC project Assumption-lean (Causal) Modelling and Estimation Stijn Vansteelandt will develop an innovative paradigm for statistical modelling, aiming to increase the quality of data analyses by enriching statistical modelling with machine learning techniques and recent insights from causal inference.
The mathematical framework behind statistical modelling ensures maximum interpretability, even with an incorrect model, and enables the attainment of honest confidence intervals that take model uncertainty into account. Standard machine learning techniques however are optimized for prediction and fall short when evaluating associations and effects. This project will therefore develop and optimize adjusted machine learning techniques for this purpose.

The new Coastal & Ocean Basin (COB) in the Flanders Maritime Laboratory in the Ostend Science Park is a versatile test facility to support the scientific community and the industry in their efforts to tackle climate change and come up with countermeasures to protect coastal communities and offshore investments, such as wind turbines or infrastructures for the breeding of oysters and mussels.
The COB is a joint initiative of Ghent University, KU Leuven and Flanders Hydraulics (FH). This wave tank is able to reproduce wave, current, and wind conditions, offering an unprecedented opportunity for researchers and industry to take a closer look at ocean hydrodynamics, and the structural response of coastal and offshore structures. It also enables them to advance offshore renewable energy technologies and to validate numerical models.

Acceleration in sea level rise and increased intensity of storms have put coastal populations at risk, and pushed the scientific community to come up with better solutions through designing coastal protection structures, developing new offshore renewable energy technologies, or implementing nature-based solutions. «In any case, designers have to go through the integrated research methodology, which combines both numerical and experimental scale modelling,» says Prof. Peter Troch (Ghent University), who coordinated the COB’s design and construction.
«Flanders has experimental test facilities at Ghent University and FH, with a limitation to relatively small-scale experiments. Therefore, and to cope with the emerging needs, a consortium led by the civil engineering department at Ghent University, in partnership with KU Leuven and FH secured funding for a new state-of-the-art test facility. The COB is designed to cover a wide range of experimental modelling needs while minimizing operating costs. This results in a large range of opportunities for academic research and for governmental and private sector projects.»
«Starting with coastal engineering, scale model experiments will offer valuable data on the wave impact loading of structures, the prediction of wave overtopping over dikes and breakwaters and damage to coastal structures. Emerging offshore renewable energy technologies including offshore wind, floating photovoltaics and tidal and wave energy converters will be also tested in the COB. Moreover, interdisciplinary work that combines marine ecology with engineering will help shape the role of seagrass vegetation and natural reefs with their habitants. The civil engineering department at Ghent University focuses on these applications. Traditional work of this department concerned wave overtopping, wave energy converters and scour protection. It also pioneers in coastal defences and wave attenuation by vegetation.»



Currently, the COB collaborates with the Spanish company ECOncrete, a specialist in solutions supporting biodiversity and a healthy ecosystem in ports, breakwaters, and other concrete marine infrastructures. «We support ECOncrete in testing its technology for a novel scour protection solution placed around offshore wind turbine monopiles. By performing these experimental model tests, we are able to assess the static and dynamic hydraulic stability of this nature-inclusive scour protection design on a sandy bottom, by testing it for a range of representative 3D environmental load conditions,» says Prof. Streicher.

The Flanders Maritime Laboratory also hosts a towing tank (174 m x 20 m). This combination offers a unique opportunity to perform multipurpose tests within the same facility, which will create strong research synergies.
The COB laboratory consists in a large technical facility housing the basin and the accompanying systems to operate it. The main wave and current basin covers an area of 900 m² (30 m x 30 m). It is operated by four components: a wave generator, a current generator, a wind generator and a water transfer system. «A fully automated data acquisition system ensures smooth and perfectly controlled set-up, start-up and management of all testing scenarios. Auxiliary systems that improve the efficiency of the experiments have been also installed. These include an access bridge, a crane, an operation control room and a workshop.»
The wave generator is a crucial mechanical system for the COB. «This system is composed of relatively narrow wave paddles, capable to generate very realistic waves in any direction. The L-shaped configuration of the wavemaker covering two sides of the basin, enables to test a large variation of short-crested wave angles. Coupled with the current generation system, it can achieve any desired relative angle between the generated current and waves, offering a unique generation system. The COB offers a variable water depth ranging from 0.4 to 1.4 m, enhanced by a central pit with a maximum water depth of 4.0 m. Multi-directional wave generation with a maximum height of 0.55 m is achieved,» Peter Troch explains.
The current generation system is a tailor-made solution, dimensioned by the dominating flow conditions in the Belgian coastal waters, characterized by tidal currents with a typical depth-averaged flow velocity of about 1.0 m/s in full scale. «Considering a maximum scaling factor of about 1:8, the flow velocity in the model is scaled down to 0.4 m/s, requiring a total discharge of approximately 11 m³/s. The current is introduced in the basin through a set of guiding grids flush-mounted in the basin floor. Each grid can be replaced by a lid when the current system is not being operated,» says COB Director Prof. Maximilian Streicher.
The SoilTwin project is a collaborative effort between Ghent University and Vrije Universiteit Brussel, funded by the Belgian Energy Transition Fund and VLAIO. It aims to unravel the intricacies of soil behaviour around offshore monopile foundations through in-situ monitoring data and experimental and numerical modelling.
For the SoilTwin experimental model tests, the central pit in the COB tank floor was successfully filled and compacted with sand for the first time, providing a unique dataset of pore pressure measurements, combining geotechnics with hydrodynamics. «This is a significant milestone in our quest for innovative solutions in coastal and offshore engineering,» underlines Peter Troch.

Devices designed to harness wave energy and convert it to electricity are called Wave Energy Converters (WECs). Industry and academia spend considerable efforts to bring WECs, and WEC arrays, into the commercial stage. They need available real-life data to validate their numerical models used for design. However, publicly available databases from WEC array experiments are limited, due to the high conducting costs and complexity.
The WECFarm project, initiated by Ghent University, aims to improve the understanding of interactions between the individual WECs within an array, and addresses the need for experimental data on WEC array tests. A team from the Coastal Engineering Research Group performed experiments focused on the extraction of wave energy using an array of five-point absorber WECs. Similar to offshore wind turbines, multiple point absorber WECs are installed in an array configuration, to increase the total capacity, and to benefit from the economies of scale.
The point-absorber WECFarm WEC consists of a floating buoy to capture energy from waves coming from different directions. It is equipped with a permanent magnet synchronous motor for optimal control. The WEC array control and data acquisition are realized with a Speedgoat real-time target machine.


Prof. Peter TROCH, Head Management Committee
Prof. Maximilian STREICHER, Director COB
Coastal & Ocean Basin - Flanders Maritime Laboratory
Wetenschapspark 8 - B-8400 Ostend
Tel.: +32 (0)9 264 54 89
Peter.Troch@UGent.be - Maximilian.Streicher@UGent.be https://www.cob.ugent.be


Our world is a microbial world and the evolution of life over millions of years took place in a constant backdrop of microbes. Several biogeochemical processes on planet Earth are driven by microbes and unsurprisingly, all living creatures on this planet have developed mechanisms to either cope with microbes, or adopt strategies to tolerate, harbour or even rely on endogenous microbes for maintaining an optimal health status.
The Center for Microbial Ecology and Technology (CMET) is part of the Faculty of Bioscience Engineering at Ghent University. CMET is specialized in the study of microbial ecosystems in their natural environments or in human-engineered reactor technologies.


Within CMET, Prof. Tom Van de Wiele heads the Host Microbe Interaction (HMI) Technology group. Referring to the trillions of microorganisms that can be found in and on different sites of our bodies, the human microbiome has become an important field of study over the last 2-3 decades. The finding of clear associations between the microbiome and health status is indicative of a dynamic and intricate microbe-host interplay. The HMI research group studies host-microbe interactions and works on the development of innovative in vitro enabling technology that allow studying human-derived microbiota in an experimental setting that is representative of different human body sites.
“The difficult accessibility of certain body sites, the lack of control over microbiome-modulatory parameters within the body or the ethical constraints of (frequent) sampling of in vivo body locations are limiting us from getting a mechanistic understanding of how the microbiome operates within our body. We have therefore designed in vitro technology platforms, such as SHIME (Simulator of the Human Intestinal Microbial Ecosystem) that enable us to mimic the different stages of the human gastrointestinal tract. Our most important developments include the study of the mucosal microbiome – the microbiota that colonizes the slime layer in the human gut. Our technology allows us to monitor the microbiome in its response to changes in the gut, to dietary shifts or to disease phenomena and it helps us understand how the microbiome modulates human health, either through the production of specific metabolites, establishing colonization resistance against pathogens, modulating immunity or triggering local inflammation. Such dynamic human gut models also allow the screening of a wide variety of candidate drugs, functional foods and/or feeds before a narrower selection enters the stage of in vivo trials,” Van de Wiele explains.
Van de Wiele’s in vitro technology platform does not operate on its own. “The base of all of our research projects starts from human in vivo observations. Unfortunately, as human microbiome research
often relies on stool samples or – occasionally – on gut biopsies, it is nearly impossible to capture healthand disease-processes that are characterized by local and dynamic differences in the various intestinal environments. The use of laboratory animals, such as mice, rats and pigs, is neither painting a fully representative picture of the human situation as significant differences exist in terms of gastrointestinal physiology, dietary composition and microbe-host interactions. In addition, the ethical concerns make that Europe is striving as much as possible to refine, replace and reduce animal testing. This is where our in vitro technology platforms come in,” says Van de Wiele.
“We usually start from complex human microbiota samples – saliva and/or feces – to inoculate our reactors with. Using a multi-parametric control, we can mimic the different physiological, enzymatic and biochemical gradients that prevail in the different gut regions, and after a certain adaptation time this results in microbial communities that are representative in composition and function for each of these human gut regions. The experimental setup is very versatile and can be adapted to mimic different individuals ranging from newborns to elderly and from healthy persons to patients. Following a careful validation of our in vitro model against human in vivo observations, we can use our model systems to conduct mode-of-action research and support clinicians, nutritionists and pharmaceutical scientists in better understanding diet-microbe or drug-microbe interactions with the host interphase.”
The possible applications of the technology platform are numerous and range from nutritional and pharmaceutical to translational clinical research. “We have been using the in vitro technology platform to unravel that there is a differential colonization and function of gut mucosal microbiota in patients with inflammatory bowel disease, chronic inflammation of the joints and of children that are malnourished. We also demonstrated that the microbiome is involved in the etiology and aggravation of cancer therapy induced mucositis, while other projects led to the identification of microbes with specific metabolic properties that support gut barrier integrity. With respect to nutritional research, we showed that the presence of wheat bran as an insoluble dietary fibre is an important driver of microbiome function and colonization. Other findings include a more accurate characterization of new classes of probiotics and live biotherapeutics. A study with Akkermansia muciniphila in the SHIME for example showed that this promising bacterium combines its preference for


mucin degradation with the potential to strengthen the gut epithelial barrier, a finding that nicely confirms in vivo research. In addition, we can investigate to what extent an active pharmaceutical ingredient (API) is released from its matrix and becomes available for intestinal absorption. This delivers important insights for drug dissolution and drug bioavailability research.
But the applications extend beyond human health research. “Because of the multi-parametric control, we even succeed in mimicking the digestion of certain animals. This can be important for studies on pets such as cats and dogs, and for production animals such as chickens or pigs. It can also be a lot more exotic: together with scientists from the Faculty of Veterinary Sciences at UGent, an in vitro model for the cheetah was developed.”
More recent developments include the use of the model in personalized nutrition and personalized drug research. The group showed that the unique features of a person’s microbiome can be a determining factor of the health benefits that can be obtained from consuming fruits or vegetables or from specific drug treatments. “For instance, the blood pressure lowering effect from pomegranate consumption is primarily driven by the ability of a person’s microbiome to convert elagitannins (a compound in pomegranade) towards the bioactive urolithin type A,” says Van de Wiele. “This knowledge on the interindividual variability of the microbiome’s metabolic potential allows to screen patients and stratify them to offer a personalised and hence more efficient nutritional or pharmaceutical therapy.”
The technology platform is in constant development. The etiopathology of many gastrointestinal diseases can often be located in the small intestine, a highly dynamic region of the gastrointestinal tract where food digestion and nutrient absorption takes place, but also a place of immense immune interactions and a possible site of several enteropathogenic infections. “Our most recent developments therefore include the study of duodenal, jejunal and ileal microbiota and the role they potentially play in the occurrence and severity of small intestinal disorders such as small intestinal bowel overgrowth and short bowel syndrome,” says Prof. Van de Wiele. More recently the group also succeeded in simulating the microbiome from other body sites such as the oral cavity, the upper respiratory tract and skin.

Center for Microbial Ecology and Technology
Frieda Saeysstraat 1 B-9052 Gent
Tel.: +32 (0)9 264 59 76
Email: Tom.vandewiele@ugent.be www.cmet.ugent.be


The Alain Goossens Lab is a research unit within the VIB-UGent Center for Plant Systems Biology. Presently, a staff of 14 people is working there. It includes 6 postdocs, 7 Ph students and 1 technician, under the supervision of Prof. Dr. Alain Goossens. Currently, the lab specifically focusses on the phytohormone jasmonate.
Plants are metabolic champions. «We aspire to unravel the mechanisms that steer plant metabolism in fitness programs to find novel tools for plant metabolic engineering and synthetic biology,» says Alain Goossens. «The plant kingdom synthesizes thousands of unique and bioactive specialized metabolites that have important roles in plant survival and often can offer valuable applications for humans.»

«Yet, this impressive metabolic machinery is still hardly exploited, mainly because of the limited molecular insight. Understanding the biosynthetic networks and biological functions of plant chemicals is a major objective in current plant science. Nature has invented strict, yet not fully understood, regulatory networks that control plant metabolism. These networks safeguard plant fitness in a continuously changing environment. By investigating the reprogramming of plant metabolism by developmental and environmental cues, we aim to advance our fundamental understanding of the mechanisms that steer plant metabolism,» he explains.

“Jasmonates are phytohormones that steer the delicate balance between growth and defense programs in many species of plants, including the production of bioactive specialized metabolites. Plant cells are capable of producing an overwhelming variety of specialized metabolites, both in terms of complexity and quantity. These small organic molecules allow plants to cope with various types of stresses but often also have biological activities of high interest to humans,” Goossens explains.
The most well-known function of jasmonates is to signal attacks by insect herbivores or microbial pathogens, both locally and systemically, leading to mounted defences, including the activation of specialized metabolism. The central module of the jasmonates is conserved across the plant kingdom.
«Understanding when, where and why the JA signal is produced in planta, how it is perceived, how it interacts with other environmental and developmental cues, and how it is transduced to the onset of specialized metabolism will allow to capture the regulatory networks that steer the plant metabolic networks. This will enable to unlock plant specialized metabolism for numerous human applications
given that our findings serve simultaneously as a novel resource for innovative engineering tools. These tools will facilitate the creation of plant-based synthetic biology platforms for the sustainable production of high-value plant metabolites. Another target is to increase crop productivity by improving plant growth, defense and fitness in a changing environment.»
Resource for new engineering tools
«Using cutting-edge functional genomics tools, in combination with reverse genetics screenings, we try to identify the essential components acting in the jasmonate signalling network and to characterize the molecular mechanisms driving plant natural product biosynthesis in crop, medicinal and model plants. Besides increasing fundamental knowledge, our gene discoveries serve as a novel resource for (metabolic) engineering tools.»
Plants are continuously challenged by fungi, bacteria and other microbial organisms living in their biosphere. «We try to protect the plants by metabolic reprogramming, both within the plant and the attacker. Within UGent-funded collaborative projects, we are using our various omics platforms, including those to detect and quantify transcripts, metabolites and interactions among proteins and between proteins and metabolites, to map the determining network.»


In this the Goossens Lab also employs two types of plant-microbe combinations known to modulate plant metabolomes. «At first, we study the interaction between tomato and rhizogenic Agrobacteria, which proliferate ‘hairy roots’ on infected plants. Hairy root cultures are proven attractive and cost-effective options for the mass production of high-value plant metabolites. They can be grown in contained conditions, hence they fit to our general research mission. We particularly focus on the ‘oncoproteins’ encoded on the T-DNA of the Ri plasmid of various rhizogenic Agrobacteria strains, and assess how they reprogram both root metabolite and biomass production.»
«In the second, we study the interaction between tomato and a set of fungi with different lifestyles. The chemical communication between fungi and plants is determined by specialized metabolites. Just like plants, fungi possess a metabolite treasure trove, with potent applications for agriculture and human health, yet the vast majority awaits discovery, typically because their biosynthesis is silent in lab conditions. Within this project, we will establish an innovative plant-based platform to discover, study and produce yet unknown fungal metabolites. The plant-based platform will be designed based on novel, paradigm-shifting insights acquired during our earlier research on plant defense. As such, we expect it will offer unprecedented possibilities to activate and study fungal metabolism.»
The Goossens Lab also participates in several international research projects. Amongst them is InnCoCells, an EU funded Horizon 2020 research and innovation project to prospect aquatic and terrestrial natural biological resources for biologically active compounds. This four-year project was launched in 2021. It aims to develop safe and sustainable plant-based cosmetics with scientifically proven effects. The 17 InnCoCells consortium partners all are European academic institutions and industrial enterprises, representing eleven countries.
Alain Goossens obtained both his Master in Biology-Plant Biotechnology and PhD at Ghent University. During his PhD, he has also acted as a visiting researcher at CIAT in Cali (Colombia). Afterwards, as a Marie Curie EU postdoctoral fellow, he moved to the lab of Ramón Serrano at the IBMCP-UPV in Valencia (Spain) to work for 2 years on yeast salt tolerance. Returned in Belgium in 2000, he became group leader at the Flemish Institute for Biotechnology (VIB). In 2003, he started his own research group within the VIB-UGent Center for Plant Systems Biology, focusing on phytohormone signalling, gene discovery in plant specialized metabolism and metabolic engineering. In 2022, he was appointed Senior Full Professor at Ghent University. In 2020 he was elected as an EMBO fellow.



Alain Goossens Lab
VIB-UGent Center for Plant Systems Biology
Technologiepark 71 - B-9052 Zwijnaarde
Tel.: + 32 (0)9 331 38 51
Email: alain.goossens@psb.vib-ugent.be www.goossenslab.be










At the Faculty of Bioscience Engineering on Campus Kortrijk of Ghent University, the research group VEG-i-TEC has built up extensive expertise in food microbiology, plant (water) process technology, and fermentation technology.

VEG-i-TEC’s mission is to provide pilot infrastructure and scientific expertise to the vegetable and potato processing industry and its suppliers, conducting research in an academic environment. By bridging the gap between laboratory-scale research and industrial practice, VEG-i-TEC aims to support and stimulate innovation in product and process development within this sector. VEG-i-TEC serves as a living lab for vegetable and potato processing companies seeking to innovate and optimize their production processes. It acts as a central hub for training and demonstrations, offering a distinctive and unique platform for the incubation of novel technologies and innovations. This collaborative space fosters the convergence of industry expertise and research advancements, driving the evolution of processing practices within the vegetable and potato sector.
“We translate process innovations that companies and research groups develop at lab level to a scale representative of the vegetable and potato processing industry. We can simulate individual processes, or even complete production lines, at pilot level,” explains principal investigator Prof. Dr. Imca Sampers. Since mid-2021, VEG-i-TEC is operating from its own research building, equipped with three pilot halls. One hall focuses on process and wastewater treatment for the (agrifood) industry, while the other two specialise in the processing of vegetables and potatoes, from just after harvest to the final packaged product. The pilot halls are supported by analytical and microbiological laboratory facilities. Additionally, the facility includes storage areas with various temperature settings and a fermentation room for solid-state and (fed-)batch fermenters and extraction technology.
“At VEG-i-TEC, we can investigate the impact of different washing and processing techniques across the entire chain: on the products themselves as well as the loss and waste streams. Furthermore, attention is paid to the byproducts generated during processing, and how added value can be generated of them in different applications.”“When focusing on evaluating new technologies, in addition to water management and cleaning and disinfection, we also work on energy management and hygienic design, always
in perspective to the food quality and to chemical and microbiological safety for the consumer. We build on our extensive experience in the processing of vegetables and how this processing affects their quality,” says Sampers. This establishment was made possible with the support of, among others, VLAIO (Flanders Innovation and Entrepreneurship Agency), ERDF (European Research and Development Fund) and the province of West Flanders.
The process and water treatment hall contains several zones for hire, including necessary utilities. “Not only for water, but also for electricity and gases, to facilitate a wide range of test setups. There are connections to various water sources: hard and softened tap water, shallow groundwater, rainwater, surface water and demineralised water. We also have water tanks for the storage of externally provided and treated process and wastewater, for interim storage of water for further treatment or to feed directly to the various food processing halls.”
Furthermore, the VEG-i-TEC laboratory has a wide range of analytical techniques for the identification and quantification of extracted components. Identification and quantification of these (bioactive) components often require advanced analysis equipment. Thanks to the ERDF project ‘Open testing and research facilities for top sectors in the West Flemish food industry,’ we also have high-end equipment to perform this, such as liquid chromatography, ion chromatography, gas chromatography and high-resolution mass-spectrometry.”
Graaf Karel de Goedelaan 44 B-8500 Kortrijk
Tel.: +32 56 29 26 00
Email: vegitec@ugent.be www.ugent.be/vegitec


VIB, nestled in the heart of Flanders, Belgium, is dedicated to pioneering life sciences research across a myriad of disciplines. The scientific journey, however, does not stop with the publication of academic papers; VIB is committed to translating this knowledge into concrete solutions for patients and agriculture.
Over 1,900 scientists from more than 75 countries work at VIB, which is distributed across ten research centers embedded in the five Flemish universities: Ghent University, KU Leuven, VUB, University of Antwerp, and Hasselt University. VIB’s research covers several areas in the life sciences, notably bioinformatics, cancer, inflammation and immunity, microbiology, neuroscience, plant biology, proteomics, structural biology, systems biology, and computational biology.
To address the increasing demand for specialized infrastructure, VIB partnered with PMV to build a new incubator that was officially opened in April 2024 and is strategically located at Tech Lane Ghent Science Park campus ‘Eiland’. The state-of-the-art VIB Bio-Incubator houses VIB’s headquarters and with a capacity to accommodate 10 to 15 biotech companies, it aims to be a beacon of growth and opportunity in the sector. The incubator acts as a launchpad for biopharmaceutical and agro-biotech ventures, supporting both local biotech start-ups and international biotech companies looking to enter the European market.
VIB researchers continue to push the frontiers of life sciences.
Researchers from the team of Bart De Strooper (VIB-KU Leuven Center for Brain & Disease Research) revealed how brain cells die in Alzheimer’s disease (AD). One of the key challenges in understanding AD has been connecting its defining hallmarksamyloid plaques, tau tangles, and death of neurons - to each other. The De Strooper lab created a new model by implanting both healthy human and mouse neurons into the brains of AD mouse models. Using this model, the team revealed a critical breakthrough: neurons initiate a programmed form of cell death called necroptosis when exposed to amyloid plaques and tau tangles. In a landmark achievement, the research team also managed to prevent neuron death, suggesting new pathways for future treatments. In a technological breakthrough, the lab of Rouslan Efremov (VIB-VUB Center for Structural Biology) tackled two major bottlenecks of time-resolved cryo-electron microscopy (trEM), a technique that helps observe different stages of protein processes. The researchers developed a microfluid device that encapsulates proteins in small droplets in which a reaction is initiated. A laser then creates tiny bubbles to spray the samples onto the imaging grids. With the help of their new microfluid device, the team could successfully study the protein reaction with a time resolution of 5 ms while consuming less than 100 nanoliters of protein solution. This is a massive, almost tenfold improvement over the earlier trEM technologies, while the low sample consumption makes the new trEM device potentially applicable for studying scarce proteins.

Meanwhile, the team of Dirk Elewaut (VIB-UGent Center for Inflammation Research) and Gert Van Isterdael (VIB Flow Core Ghent) used flow cytometry - a technique to detect and measure the composition of a population of cells - to gain a better understanding of drug delivery in inflammatory conditions. Drugs are transported through the body in various ways, one of which is with liposomes, nanoscopic sphere-shaped structures. In a mouse model of arthritis, the researchers found that specific immune cells (myeloid cells) play a key role in liposome transport. These myeloid cells engulf the liposomes and carry them to inflamed areas. This new insight into how drugs are transported in the body could significantly enhance the effectiveness of treatments for various inflammatory conditions.
At the end of 2023, VIB launched the spin-off Tanai Therapeutics, dedicated to developing first-in-class treatments for obesity. The company acquired additional funding in 2024. On a global scale, obesity and overweight conditions account for an estimated four million deaths annually. As such, addressing obesity presents an unprecedented opportunity with societal impact.


Entering the obesity treatment arena, Tanai Therapeutics adopts an entirely new therapeutic approach. Unlike current treatments that replicate GLP-1 hormone effects, like semaglutide, Tanai Therapeutics is exploring targeted fat-loss methods that conserve muscle mass.
Other spin-offs attracted both funding and attention. Aphea.Bio secured 70 million euros in a Series C round, supported by the Bill & Melinda Gates Foundation, among others. The funding will allow the company to advance its research and development in biologicals, scale product launches, expand market reach, and commercialize product offerings.
Dualyx raised 40 million euros in a Series A financing round, enabling the company to progress its lead autoimmune program as well as its pipeline of Treg candidates. To date, Dualyx has observed promising results on its DT-001 program, offering a game-changing treatment option for a broad range of autoimmune diseases.
MRM Health attained additional financing from existing investors while welcoming the Belgian Sovereign Wealth Fund, SFPIM, to the table. To complement this, the company was also awarded two million euros in funding from the Flemish Agency for Innovation and Entrepreneurship, VLAIO. The funds will be allocated towards expanding its clinical and preclinical pipeline and accelerating its preclinical program in Parkinson’s Disease.
ExeVir announced that it was awarded a two-year R&D grant of 1.6 million euros by VLAIO. The grant will allow the company to conduct preclinical research toward both preventive and therapeutic solutions for dengue.
Also, after a successful first year, the biotope by VIB program launched its third and fourth calls in 2023. The need for a tailored incubator program could once again be illustrated by an impressive number of applications from 37 different countries, showing that the biotope by VIB model has garnered a solid reputation across borders. In 2024 two cohorts of eleven start-ups joined the program.
The VIB Grand Challenges program, which aims to fund interdisciplinary projects with high societal impact, supported three new projects that kicked off in December 2023: BIOPET aims to revolutionize pet food sustainability by producing animal lipids from yeasts; BE.amycon is setting up a Belgian consortium to tackle amyloidosis, a rare disease caused by abnormal protein deposits; and Pointillism 2.0 builds on the original project by validating biomarkers to improve immune therapy predictions.
The VIB Conference Series continues as a strong international brand. A scientific organizing committee, with both internal and external experts, defines the program of each conference. Starting in 2023, great efforts were made to improve the events’ sustainability by collaborating with eco-friendly caterers and reducing printed materials, which fits into a greater sustainability mission. To further support its sustainability efforts, VIB appointed a sustainability officer to guide the institute toward more sustainable operations and goals, for example, by promoting eco-friendly mobility and prioritizing clean energy. Redoubling its dedication to diversity, equity, and inclusion (DE&I), VIB has taken specific, measurable, and sustainable actions to counter systemic barriers, explicit and unconscious biases, and inequities. As part of this effort, it has hired a dedicated Diversity, Equity, and Inclusion officer to lead its work in creating a more inclusive, diverse, and safe workplace.
As an institute that evolves and adapts, VIB stays true to its original mission, creating significant impact by enabling scientific research and contributing to society. VIB researchers engage in groundbreaking work across diverse fields to transform their discoveries into impactful benefits for society.



Tight barriers form the major protection for the brain against external insults such as toxins, infectious agents and peripheral blood fluctuations. In her lab, Roosmarijn Vandenbroucke and her team study the role of brain barriers in physiological and pathophysiological conditions, including neurological disorders such as Alzheimer’s disease.


These barriers are a central part of the brain homeostasis mechanism and assure a balanced and well-controlled micro-environment in the central nervous system (CNS),» Prof. Vandenbroucke explains. «You can compare it to a firewall. It has to stop potentially toxic substances that might disrupt the functioning of the brain. While the presence of this barrier is essential, our brain also needs specific substances to reach the brain cells. Thereto, the brain barrier contains specialized transporters that decide which molecules can get through the barrier, which, by the way, loses strength as we get older. While very small molecules such as alcohol and e.g. painkillers can penetrate the barrier, most medicines are unable to reach the brain.»
One of the brain barriers is called the blood-cerebrospinal fluid (CSF) barrier, formed by a single layer of choroid plexus epithelial cells. «The main topic of our research is the central role of the blood-CSF interface in the transfer of peripheral inflammation (e.g. sepsis and gut inflammation) to the brain and in the initiation and progression of neuroinflammation (e.g. multiple sclerosis, Parkinson’s disease and Alzheimer’s disease) and the possible application of this barrier as a gateway for the delivery of drugs to the brain. While curing these diseases might be too ambitious, slowing down the progression of such diseases would already be a major breakthrough.»
«Subtle changes at this blood-brain interface have wide-ranging effects on the brain. Consequently, understanding blood-CSF barrier functionality under physiological and pathophysiological conditions might open up new therapeutic strategies to treat neuroinflammatory diseases,» says Vandenbroucke.
«We focus on tightness of the barrier, leukocyte infiltration, and extracellular vesicle (EV) production. We already identified several alterations at the blood-CSF barrier in both systemic inflammation and neuroinflammatory disorders. For example, we identified a new communication mechanism between blood and brain via the secretion of EVs by the blood-CSF barrier into the CSF, through which a pro-inflammatory message is transmitted from the body to the brain.»
«While the presence of barriers protects our brain, they also hinder therapeutic delivery to the CNS, leading to higher failure rates of CNS drugs in Phase III clinical trials compared to non-CNS drugs. Delivering therapeutic molecules to the brain remains a significant challenge. To address this, we aim to leverage the natural transport mechanisms at the blood-CSF barrier to transport drugs across the blood-CSF barrier into the brain. Currently, this strategy of hijacking these transport mechanisms is being explored with support from my recently granted ERC Consolidator grant.» Roosmarijn Vandenbroucke was awarded the Baillet Latour Biomedical Award in 2017 for initiating this research.



Introducing stool from healthy people through a nasal catheter into Parkinson’s patient’s small intestine can help treat the symptoms of the disease. This is the conclusion of the year-long groundbreaking study Gut-Parfect, conducted by researchers from the Center for Inflammation Research (IRC), Ghent University Hospital and Ghent University, coordinated by Roosmarijn Vandenbroucke, Patrick Santens and Debby Laukens. After twelve months, the participating patients showed a significant improvement in their motor score, the most important measurement for Parkinson’s symptoms. This improvement became more pronounced between the sixth and twelfth month after the transplant of fecal microbiota transplant (FMT), indicating a possible long-term effect. In addition, the participants suffered less from constipation, a common and troublesome complaint for many people with Parkinson’s disease.
In Parkinson’s disease (PD), the alpha-synuclein protein misfolds and clumps together. Those clumps then damage dopamine-producing nerve cells in the brain, which leads to the typical PD symptoms. Current treatments, primarily medications that replace dopamine, often have side effects and lose effectiveness over time. “The protein clumps are believed to be formed in the gut wall at a very early stage of the disease, from which they reach the brain cells via the vagus nerve, which connects the gut and the brain. This process can be influenced by gut bacteria. Emerging research suggests a link between PD and the gut microbiome, the trillions of bacteria residing in our intestines. Patients with Parkinson’s often have an altered gut microbiome compared to healthy individuals and they often show more (intestinal) inflammation and a disrupted intestinal barrier.
«The clinical study showed that twelve months after the FMT transplant, the actively treated group showed significantly more improvement in motor symptoms compared to the placebo group. Stool transplantation has the potential to improve the quality of life for millions of people worldwide with Parkinson’s disease. We will now determine which specific bacteria in the stool give a positive effect, and which patient will be most responsive to this treatment. This could lead to the development of a bacteria pill or other targeted therapy that could replace stool transplantation in the future,» says Prof. Vandenbroucke.
“An important part of our research focusses on the gut-brain axis and how the microbiome can have an impact on the brain and the development of brain diseases,” adds Roosmarijn Vandenbroucke. “In light of this, we performed a successful clinical trial on Parkinson patients. Currently, we aim to get a closer look at the mechanisms that might play a role in this gut-brain axis. In the VIB Grand Challenge project, we also plan a new clinical trial on Parkinson patients in collaboration with neurologists at Ghent University and Ghent University Hospital (Profs Patrick Santens and Dr. Arnout Bruggeman), KU Leuven and Leuven University Hospital and Leiden University Medical Center, and together with microbiologist Prof. Jeroen Raes (REGA Institute, VIB and KU Leuven) and gastroenterologist Danny De Looze (Ghent University Hospital).
Roosmarijn Vandenbroucke
In 2008, Roosmarijn Vandenbroucke obtained her PhD in Pharmaceutical Sciences at Ghent University. She then worked for seven years as a postdoctoral fellow in the group of Prof. Claude Libert. In 2015, she became professor at the Faculty of Sciences (Ghent University) and in 2018 group leader at the VIB Center for Inflammation Research (IRC) at the Technology Park of Zwijnaarde (Ghent). Her team includes six postdocs, ten PhD students, four lab technicians, a bioinformatician and an administrative collaborator. Their areas of expertise include blood-brain (BBB) and blood-cerebrospinal fluid (CSF) barriers, gastro-intestinal barriers, the gut-brain axis, sepsis, neuroinflammatory disorders (including Alzheimer, Parkinson and multiple sclerosis) and extracellular vesicles. The entire VIB Center for Inflammation Research has no fewer than 350 employees.

Roosmarijn Vandenbroucke Lab
VIB-UGent Center for Inflammation Research
Technologiepark-Zwijnaarde 71
Fiers-Schell-Van Montagu building
B-9052 Zwijnaarde
Tel.: +32 (0)9 331 37 30
Email: Roosmarijn.Vandenbroucke@irc.vib-ugent.be https://vandenbrouckelab.sites.vib.be/en

With more than 3,000 patients a day and more than 6,500 employees, Ghent University Hospital (UZ Gent) is one of the largest and most specialised hospitals in Flanders. Patients can go there for a full range of highly specialised, high-quality care. The hospital has extensive facilities and more than 1,000 beds for one-day and multi-day admissions.

Quality customer-friendly service is central to the care provided. As a university centre, UZ Gent also invests in scientific research and training. To this end, the hospital works closely with the Faculty of Medicine and Health Sciences of Ghent University. Doctors and physician-specialists are trained there, and researchers work on new techniques for diagnosis and treatment in numerous services. The hospital campus is currently undergoing major renovation. The UZ aims to be a contemporary, accessible and sustainable health campus that meets the needs of all users by 2029.
The UZ Gent has pursued a scientific spearhead policy since 2009. Together with Faculty of Medicine and Health Sciences at Ghent University, four research domains were selected that receive extra funding to further expand their position: oncology, genetics, immunology and neuroscience.
The choice of these four domains was made on the basis of objective criteria: leading position recognised by peers, number of A1 publications, current trends in epidemiology and care needs. The translational character and social valorisation of the research were also decisive factors. The spearhead research should quickly lead to research results that allow patients to be treated better. Today, UZ Gent already has a leading position in each of these four research domains.
Research at UZ Gent is carried out by the Ghent Healthcare Knowledge Centre (KCGG) and the Health, innovation and research institute (Hiruz) which is structured in five units: Clinical Trials Unit, Data Management Unit, Contract Unit, Innovation & Valorisation Unit, and the Biobank.
A research team from Ghent University Hospital, Ghent University, the city of Ghent and imec started an unprecedentedly large and long-term study in 2024. “With Health Monitor we will monitor 20,000 Ghent residents for 20 years to investigate the influence of genes and environment on their health,” says lead researcher Professor Marthe De Boevre. “By 2050, 1 in 3 Flemish people will be 65 years or older. If we want to be able to cope with the aging population and have our healthcare evolve accordingly, we must focus on prevention. We want to improve future care with the data of the Ghent residents. By combining the results of genetic and environmental factors, we gain a unique view of risk factors for diseases and learn how we can grow older more healthily. This gives us new insights, treatments and perhaps even medicines.”
In total, the research will yield 400,000 questionnaires and 180,000 samples of blood, urine, hair, skin, stool and saliva. The Ghent residents followed were at least 45 years old at the start of the research. They live in sub-municipalities of Ghent. The city centre of Ghent has not been included in the test area for the time being, partly because it is less representative of the average Western European citizen.
The Health Monitor encrypts the identity data. Data from the questionnaires, physical tests and biological samples are stored in the biobank of Ghent University Hospital and the university server. “The research will last 20 years, but to accelerate progress in scientific research on this topic, we will regularly share results with participants and other researchers,” says De Boevre. “We always provide individual participants with a report of the physical test, so they can discuss it with their trusted GP if desired. We also inform participants who gave prior consent about significantly deviating results if we suddenly notice a condition that the participant is not yet aware of, but which is treatable.”

A team of Flemish and Canadian researchers led by professors Piet Ost (Cancer Research Institute of UZ Ghent) and Alex Wyatt (University of British Columbia) analysed 600 pieces of cancer tissue from patients with metastatic prostate cancer.
“After analysing various biopsies, we got a clearer picture of the disease and we can treat it more specifically,” says radiation oncologist Piet Ost. “In 5 to 10% of men who are diagnosed with prostate cancer, the cancer had spread. This concerns approximately 1,500 men annually. It is no longer possible to remove from them all the cancerous tissue. That is why doctors usually take a biopsy of the prostate and start a specific hormone or chemotherapy regimen as soon as possible. But that one biopsy tells them little about the origins of the aggressive cancer and how it spreads in the body. Different tissue samples tell more.”
The researchers analysed cancer tissue from the prostate of 43 patients with metastatic prostate cancer. “To our surprise, we found different types of cancer cells through multiple biopsies within the same prostate. Only some of them had spread throughout the body. This discovery taught us that with multiple biopsies we can paint a clearer picture of the disease and adjust the treatment accordingly. The more targeted and personalized the treatment, the greater the chance of success.” One or more biopsies of the prostate make little difference to a patient. All biopsies are performed at the same time and are not more invasive. It just takes a few minutes longer.
The researchers hope to work in the future with a blood sample instead of biopsies. Because all body cells release genetic material into the bloodstream, they are looking for a way to also detect the various cancer cells in prostate cancer in the blood.

Neurogeneticist Professor Bart Dermaut from the Centre for Medical Genetics at Ghent University Hospital, together with the Ghent PrOZA team (Program for Undiagnosed Rare Conditions) of Professor Bruce Poppe and international researchers, has discovered a new form of lipodystrophy, a metabolic disease that originates in fatty tissue. “This condition is very rare, but this discovery provides a new piece of the puzzle to gain knowledge about metabolic problems in obesity, a major and increasing problem worldwide,” says Dermaut.
“The cause of the new metabolic disorder lies in the Plaat3 gene,” explains Dr. Nika Schuermans (Centre for Medical Genetics). Plate3 is a protein that is mainly present in fat and nerve tissue. An error in the gene causes a shortage of fatty tissue, which means the body can store less energy. The patient experiences an abnormal accumulation of fats in, among other organs, the liver and in the muscle tissue, resulting in diabetes and fatty liver disease, just as with obesity.”
“Patients also always show pronounced neurological symptoms such as neuropathy and intellectual disability. It will be quite a challenge to further investigate and understand the mechanisms of this,” explains neurologist Dr. Dimitri Hemelsoet. The consequences of an error in the Plaat3 gene have not previously been identified by anyone as the cause of these symptoms, nor attributed to another disease. “To help patients in the future, it is very important to make the link between their symptoms and the genetic error. We do this now by collecting them under the name of this new rare condition,” says Dermaut. The researchers hope they found a new target for a possible treatment of lipodystrophy and obesity.



-In recent years, the food packaging value chain has been characterised by a never-ending stream of innovations. In Belgium, Pack4Food is the driving force behind the optimisation of packaging for the food industry. The cross-sectoral approach in which all stakeholders throughout the whole value chain bundle their knowledge and expertise, proves particularly efficient. Thanks to Pack4Food, Belgium plays a leading role in the international research on food packaging.
Pack4Food is a consortium of research institutes and companies throughout the food and packaging industry (food producers, packaging materials producers and converters including printing, equipment manufacturers,…). «They join forces to stimulate innovation in food packaging and processes,» says director Peter Ragaert. «Pack4Food acts as a bridge builder and communication channel. An important task for our six-person team is to initiate and coordinate research and development projects with added value for companies and other stakeholders in the food packaging value chain as it is based on their needs. Our ambition is to formulate answers to real food packaging challenges from an unbiased vision and approach.»

Pack4Food, celebrating its 20th birthday in 2025, also has earned its spurs internationally. The organisation is increasingly involved in European research projects and is putting Belgium on the map as a leader in food packaging innovation. On top, Pack4Food is leading, with support of Flanders’ FOOD and NATUREEF ASSOCIATION, the European S3 Partnership Food Packaging, a European collaboration platform with 18 clusters from 11 countries, representing more than 2000 companies. The aim is to facilitate the exchange of know-how
along the whole food packaging value chain. This will accelerate the introduction and implementation of new sustainable and/or smart food packaging technologies and innovations in the food packaging industry on an international level. The S3 partnership also aims to develop a network of ‘living labs,’ to support companies in testing their packaging for e.g. shelf life, recycling potential, intelligence, etc.
Roadmap Food packaging of the Future as a foundation
The fact that Pack4Food is participating in several national and international research projects, leading to improved packaging concepts for food, has everything to do with the vision of the organisation. In cooperation with the Belgian spearhead clusters Flanders’ FOOD, Catalisti, SIM and VIL, this vision was translated into the innovative cross-sector Roadmap ‘Food Packaging of the Future.’ Peter Ragaert: “This roadmap formulates answers to the packaging challenges of 2030. The roadmap is based on three pillars: circular packaging, smart packaging and packaging & logistics with an overarching pillar: packaging and digitalisation.”


European collaboration is key!
To achieve the current (and upcoming) European legislation related to food packaging by 2030, industrial stakeholders have a strong need for innovation and investment througout the entire food packaging value chain, in which interregional cross-sector collaboration is imperative. Therefore, the S3 Partnership initiated the Interregional Innovation Investment (I3) project Value4Pack. Value4Pack aims to bolster the capacity, competitiveness, and resilience of European food packaging stakeholders in addressing key societal, environmental, and economic challenges tied to the 4Rs - Refuse, Reduce, Reuse and Recycle. In its first year, Value4Pack analyzed the food packaging value chain in 30 regions of 11 European countries. Subsequently, this analysis led to an interregional assessment which identified over 50 opportunities for interregional business and investement collaboration. These opportunities were compiled in an interregional report, followed by a call for cooperation proposals to make them concrete. Within 3 months, more than 60 ideas were submitted, with 30 selected for further support. Ultimately, these ideas will evolve into at least 10 concrete interregional business projects.
The research area of Pack4Food is very broad. Nevertheless, the emphasis in recent years has mainly been on sustainability. “It is true that we always approach this theme from the point of view that packaging must first and foremost ensure the required shelf life of food products,” says director An Vermeulen.
In the Tactic research project, multiple tools for assessing the sustainability of food packaging are tested and evaluated on aspects like scientific integrity and methodology. Additionally, communication strategies are being tested to inform consumers about sustainability choices. Companies participating in Tactic are therefore supported in selecting the right sustainability tools to improve their packaging design and in effectively communicating their packaging choice –with consumers. At the end of the project (December 2024), all lessons and practical insights are published in two best practice guides, focusing respectively on tools and communication.
The Multi2Recycle project addresses how multilayer polypropylene food packaging foils can become recyclable whilst maintaining their optimal barrier properties for food shelf life. It specifically evaluates the balance between packaging composition and mechanical recyclability, aiming to recycle these foils for secondary or tertiary food packaging, as well as primary non-food applications. Additionally, the project also assesses the recyclability of mixed polypropylene streams, while ensuring key packaging functions like barrier properties and transport resilience remain intact. Based on the insights from Multi2Recycle, the follow up project BeFore will start in 2025 and will look into the influence of processing on innovative recyclable high-barrier materials for plastic and paper packaging.
Moving further towards the future in food packaging
Next to the focus on 100% recyclable packaging materials, major trends are oriented towards renewable and/or reusable materials, in which digital technologies and data also provide an important transformative driver for the food packaging industry.
“For example, together with Flanders’ FOOD and Imec and with the financial support of EFRO, we have been investigating in Vision2Reuse how smart camera technologies and AI can be used for quality control of reusable food packaging,” says An Vermeulen. “In a next project, we want to dive deeper into the microbiological
and chemical food safety of reusable plastic-based packaging focussing on applications with extended contact time between the food and the packaging material such as in case of ready-to-eat meals with shelf-lives of 1 to 2 weeks.” Several challenges will be tackled such as optimizing the washing process to avoid biofilm formation and investigating the factors influencing the uptake of odours into packaging materials. “With regard to renewable materials, we work with several renowned research institutes from the CAPTURE-platform on the PROMIPOL project on developing sustainable novel biopolymers derived from CO2 and CO building blocks, like ethanol and methanol.” In this project, with financial support of FWO, we assess how these materials are converted by microorganisms into proteins and polyhydroxyalkanoates (PHA), into potential new food packaging materials of the future.
Pack4Food does not only make a difference by initiating and partnering in research. The organisation also ensures a flow of information to the field. Peter Ragaert: “Together with various research partners, we provide practical training on a regular basis to companies, in Dutch or English. Our offer ranges from packaging technologies such as packaging under modified atmosphere (MAP) over packaging materials such as biobased and compostable plastics, to new technologies such as active and intelligent packaging. Because we are close to the innovation sources, we constantly optimise the training courses with the latest information obtained from various research projects or the academic world.” And last but not least, to support its members, Pack4Food provides an international network and actively promotes cooperation through several events.



Pack4Food vzw
Coupure links 653 – B-9000 Gent Tel.: +32(0)9 264 61 33
E-mail: info@pack4food.be https://pack4food.be/en


-Inagro is a leading centre of applied research and dissemination for agriculture and horticulture with a diversified range of expertise and services. Its focus is on supporting farmers and providing future-oriented perspectives for primary production.


To achieve this optimally, we collaborate across the entire agrifood chain – from suppliers to the processing industry and retail – both domestically and internationally,» says business developer Katrien De Dauw. «We prioritize diversity in research themes and expertise to adapt flexibly to changes and transitions in the sector.»
Since its inception as a research centre, Inagro has been committed to improving cultivation techniques through trials on a practical scale. Its 240 employees, mainly scientific and technical experts, conduct practice-oriented research on farms and within Inagro’s own extensive research infrastructure. Examples include 35 hectares of trial fields, pilot scaled research facilities for mushroom and Belgian endive production, aquaculture, insect breeding, and a plug-and-play biogas installation.

For fast-growing crops and when weather conditions change rapidly, it is crucial to be on the ball. Fast, high-quality analysis is therefore of great importance. For this purpose, Inagro has its own independent and accredited laboratory. As well as our own project researchers, farmers and horticulturalists can go there to have their soil, crops, manure, water and fodder analysed. The lab also supports R&D and quality control for external users. Among them not only the frozen vegetable industry – which the Roeselare region is reputed for –, but also e.g. wine producers and hop cultivators.
The ISO 17025 certified lab is equipped with various state-of-the-art equipment for sample preparation and different measuring devices for a wide range of analyses. Every year, it analyses about 70 000 samples, mainly soil samples. Customers can deliver samples 24/7 via the refrigerated night safe.
«This makes Inagro a key R&D partner for farmers and technology providers in the transition to a more sustainable society,» says deputy director and research manager Greet Ghekiere. «Our research agenda focuses on developing solutions to meet the goals of the European Farm to Fork strategy. We aim to quickly implement research findings into practice within the shortest possible time, by conducting our validation and demonstration projects in real-life environments, such as our Future Farming Hub and our research greenhouse Agrotopia.»
«We’ve always kept an eye on new trends, not just in agriculture and food, but also in broader social contexts,» says Ghekiere. «This includes finding solutions to mitigate farming’s impact on the climate, particularly regarding livestock farming. Inagro focuses on developing technological solutions and management practices to reduce greenhouse gas emissions, such as methane from cows. Solutions are based on resilient soil management and fine-tuned water and food management.»
Inagro’s researchers experiment with soy, quinoa, chickpeas and even duckweed, crops that could provide locally produced protein sources. In collaboration with a major retailer, Inagro has even developed Belgian chickpea-based hummus and falafel.


In 2021, Inagro opened Agrotopia. This rooftop greenhouse contains a wide range of state-of-the-art hydroponic growing systems for both leafy crops and fruit vegetables, and different types of vertical farms. Agrotopia is also a pilot for food production in highly urbanised environments, in which a more circular economy is put into practice by e.g. access to a heat network and use of waste water from food processing industries.
Vertical farming is an innovative method to grow crops in vertically stacked layers, often in controlled indoor environments. The layers usually consist of trays or gutters, and do not contain soil. Instead, they are fed with nutritious water solutions, which ensures efficient use of resources such as water and space. Currently, Inagro has three vertical farms. The most recent (2024) system consists of three 10-meter-high towers, each with 18 rotating tables. Unlike fully closed systems, this one uses natural sunlight.
«The main challenge in current vertical farming systems is the energy requirement for lighting and climate control. This system benefits from natural light, as it is placed in Agrotopia’s facade greenhouse,» says De Dauw. «We believe that vertical farming can be a valuable addition to the current horticultural practice, e.g. for the production of qualitative plantlets and cuttings. The fully controlled environment also allows for targeted research into, among other things, light recipes and the effect of biostimulants.»
Research into professional insect farming for alternative protein production shows promising results. «Our focus spans the entire food chain,» explains Ghekiere.
Inagro is advancing nature-based solutions to reduce chemical pesticide and nutrient use in primary production. «Within our Future Farming Hub, we’re developing production practices for the future in conventional, organic, and agroforestry farming systems,» says De Dauw. The hub tests the effectiveness of biopesticides and biocontrol agents, while also developing smart, data-driven decision support systems for crop protection. These systems are designed to improve integrated pest management and prevent nutrient and pesticide leaching into the environment.»

Within Inagro’s system approach of the agribusiness chain, cooperation with a broad range of stakeholders is pursued. Business developer Katrien De Dauw illustrates: «Private companies can participate in Inagro’s research in different ways. We offer confidential R&D, demo trials, and participation in research projects. This way we can be a partner in development, validation and demonstration of the companies’ innovations.»
Inagro’s practice-oriented expertise comprises a diverse range of topics. These can be applied to a broad variety of crops, such as open field vegetables, arable crops (e.g. grains, potatoes), greenhouse vegetables, mushrooms, strawberries, and more. Circularity is a hot topic, but we bring it into practice by applying it to both inputs and outputs. Water, energy, cultivation materials, valorisation of waste streams, and more are comprised in many projects. Digitalization is another important factor of modern horti- and agriculture, both in the field and the greenhouse. Inagro’s smart farming department incorporates robotization and precision agriculture.
«Sensors help us to ‘hear’ the plants’ needs. Challenges concerning climate change or diseases and pests can be tackled by developing new cultivation techniques. IPM and sustainable crop protection are intertwined in many of the previously named topics. And we explore and optimise the cultivation of new crops, such as protein or fibre crops, and diversification of the existing vegetable assortment.»
«We consider multi-actor working as an essential part of our approach,» Inagro director Mia Demeulemeester adds. «We prefer to work in co-creation with not only the agro-industrial chain, but with all relevant stakeholders. We offer them to participate in our research projects. Significant for this approach is that Inagro manages two ENOLL approved living labs, one for greenhouse agriculture and the other dedicated to the development of concepts for the circular use of water, energy, biomass and nutrients.»

Inagro Ieperseweg 87
B-8800 Rumbeke-Beitem
Tel.: +32 (0)51 27 32 00
Email: info@inagro.be
https://inagro.be/eng

KU Leuven was founded in 1425. In addition to being one of the oldest universities, it is also the most innovative university in Europe (Reuters). With more than 65,000 students from over 140 countries and - the university hospital included - more than 20,000 employees, it is also the largest university in Belgium. 15 faculties offer bachelor’s and master’s programmes at 10 locations in Flanders. The programmes are based on the research of more than 8,000 researchers.
KU Leuven is ranked 43th in the Times Higher Education rankings and 63th in the QS World University Rankings and remains the highest-ranked Belgian university. It also hosts several important international networks, such as the League of European Research Universities (LERU). KU Leuven is a co-founder of this organisation. Its members are leading European universities such as Cambridge, Oxford, Heidelberg, Sorbonne and Zurich.
In recent years KU Leuven has invested in joint doctoral programmes. “Such programmes not only lead to an expansion of our own research capacity, but also play an important role in the further development of research, innovation and international anchoring of the Flemish region,” says Jan D’hooge, Vice Rector Research Policy. Currently, research at KU Leuven was the source for 861 patents –and 184 spinoffs. During the period 2002-2023, these spinoffs collected more than 2.1 billion euro in external investment money.

“We focus our research on scientific excellence and at the same time aim for the research results - possibly in the long term - to have a positive impact on society, especially on the major challenges of our time such as health issues, energy consumption, climate change and food supply. These wicked problems can only be effectively tackled through a multidisciplinary approach. In order to build bridges between different scientific disciplines, we have created 21 thematic ‘KU Leuven Institutes’.”

“To address the wicked problems of today and anticipate the unknown challenges of the future, we advocate for a balanced approach to funding, ensuring an even distribution between fundamental and applied research, as well as between curiosity-driven and application-driven studies. Ideally, this balance should be approximately 50/50. When research results are translated into applications for the market, the respective researchers play a very active role, which also helps them understand the challenges faced by both industry and society. These insights, in turn, enrich and inform their fundamental research lines. Of course, not every faculty has the same possibilities to translate research into economic applications. But examples do exist across all faculties. For example, in the Faculty of Arts, we work on a valorisation programme aimed at improving the management of museums.”
Key to the success of the university is the autonomy and creativity of the researchers. “As university board, we therefore do not impose strategic themes on our researchers, but we try to support what is starting to grow. This bottom-up view does not mean that we do not have a number of flagships, linked to for example ERC grants or Methusalem funding by the Flemish government. Only absolute top projects and researchers with a strong proven track record are eligible for these programs.” Over 100 ERC grants for example involve KU Leuven researchers, who are creating value for society with their groundbreaking discoveries.
“We are making grants of 30k euro available internally for initiating international collaborations. A research council decides whether or not to award them. The successful applicants can use this money to organize workshops, conduct pilot experiments or buy off employees’ time.” The judging is no longer based on purely quantitative metrics such as the number of publications. “We are now adding more nuances to the evaluation. Our HR department is working on implementing this new approach. In doing so, we also look at - amongst others - whether the applicant can provide sound leadership and is a good team player.”
KU Leuven has been highly successful in obtaining funding from Horizon Europe, the European framework programme for research and innovation. It is the highest ranked university in Horizon

Europe and the first university to succeed in securing more than 250 million euro in funding. “The Flemish research and innovation policy provides the necessary support. Flanders makes research budgets available that allows universities to develop policies and support researchers. In this context, we have created the necessary internal structures to encourage our researchers to submit proposals that qualify for European subsidies and to help them write their proposals. From the resources that we are allowed to use ourselves, we give an extra 50,000 euro to researchers who coordinate European multi-partner project as a top-up,” explains D’hooge.
Dynamic Leuven researchers can enjoy more incentives. “25% of European grants go to the institution where the research is done, to cover the so-called indirect costs. We apply the policy of allocating 8% of the direct cost as free resources to the research group after successful completion of the project in question. With this, they can, for example, start a follow-up study or initiate a new study. This can incentivize researchers to apply although it implies a financial contribution to the project of the university as the total amount of indirect costs is more than the 25% of the EU grant’s direct cost”.
“For project calls issued by the internal funds of the university as provided by the Flemish government, we employ a highly systematic approach. A group of excellent researchers and innovators within the university serve as members of evaluation councils, the Research Council and Industrial Research Council. These councils review all research proposals, usually assisted by external reviews, and provide feedback to applicants, so that people who apply for research grants receive valuable guidance and are better informed about the expectations of funding bodies.”
“Our researchers have to tackle various obstacles in their day-to-day activities and are increasingly confronted with red tape because of new regulation imposed by governments and/or funding agencies. Many of them have to combine their research with sometimes quite large teaching assignments. Compiling the necessary files to apply for projects and grants and to report on their research, give presentations and lectures increases their workload further. To reduce this pressure, we have started an internal service

in 2024 to evaluate which project calls are best suited to which researchers, then pass on that information in a targeted manner and assist in drawing up the necessary applications. We are experimenting with artificial intelligence in this regard. In this way, we also limit the tendency of researchers to outsource these types of tasks externally.”
Investigating crime scenes is essential for police services to determine exactly what happened. Unfortunately, this often involves manual work that takes a lot of time. KU Leuven has developed a new tool called HemoVision that, using smart algorithms, can analyse a blood spatter pattern in less than fifteen minutes and display the possible impact on the victim in 3D. The technology was optimised and tested on real crime scenes.
“With the help of smart algorithms, we trained our tool to generate various impact possibilities based on a particular blood spatter pattern. Detectives can use these to test and, if necessary, exclude their various hypotheses. With the expertise of the UZ Leuven department of forensic medicine and through collaboration with the Federal Judicial Police, we were able to test HemoVision on real crime scenes and adapt it to the needs of future users,” explains researcher Philip Joris, who founded Forentrics, the spinoff behind HemoVision. “The advantage of HemoVision is that the tool not only works quickly but also very accurately. This saves detectives a tremendous amount of time and effort,” adds cofounder Ruben Moermans. The KU Leuven researchers hope to convince various international players to use HemoVision.

KU Leuven
Oude Markt 13 - B-3000 Leuven
Tel.: +32 (0)16 32 40 10
Email: ask@kuleuven.be www.kuleuven.be/english/kuleuven






What are your priorities for the new term of office of the Brussels-Capital Government?
The priorities of the next Brussels Government are not yet known at this stage. However, my wish is obviously to see the major guidelines that we have set over the last 5 years continued and even strengthened.
The Region is a trailblazer, particularly when it comes to social innovation. Several support programmes enable the ecosystem to address and explore in greater depth the societal issues specific to a City Region like Brussels, and to propose and test innovative solutions. We have also adapted the regulatory framework to ensure that each research project supported by the Region is part of a trajectory that guarantees consideration of the social and
environmental impacts generated by its implementation or by the expected results. In practical terms, a project that has undesirable social or environmental effects is simply not eligible for public funding.
For me, this is a real step forward that I hope will be perpetuated in the field of research, development and innovation (R&D&I), but also beyond.
What do you see as the strengths of scientific research in the Brussels region?
There are a lot of them! I will limit myself to 3 exemplary areas. Firstly, health research: in addition to the many university hospitals, which are an undeniable asset for Brussels, our approach aimed at encouraging a global and integrated approach to health and social issues seems to me to be particularly relevant. The development of organisational solutions at the level of the healthcare system in its broadest sense and a particular focus on prevention are also a strong point for Brussels. Secondly, I would mention circularity: the various calls for projects have highlighted an important emerging dynamic for achieving regional emission reduction targets and creating high-quality local employment. Finally, I’d like to mention social innovation. We have a unique co-creation programme that brings together researchers and players in the field with a view to meeting the challenges of societal transitions in the service of sustainable development in the Brussels-Capital Region. The Pysi (Prove your social innovation) programme is also remarkable. It helps to validate the feasibility and viability of a new socially innovative product, process or service that meets a clearly identified social need. It has been so successful that it is generating significant social economy activity in Brussels.
How does the Regional Government support scientific research?
First of all, it should be remembered that regional support for scientific research is aimed at applied research. In other words, projects must be able to demonstrate their relevance to the Brussels context, as well as their potential for practical applications. The government has an annual budget of around €50 million to fund research, development and innovation projects through Innoviris. Priorities are set out in the Regional Innovation Plan. There is also support for certain structures that play a strategic role in strengthening the R&D&I ecosystem (e.g. Buildwide or Sirris) or disseminating results (e.g. the online journal Brussels Studies).
Could you give us a few examples of research projects supported by the Regional Government?
I’m thinking first of all of an inter-university and inter-hospital project on Alzheimer’s disease, which has been supported since 2024. It is unique in that it brings together an enormous amount of expertise and highlights a desire to pool approaches and

extend collaboration across networks. It also has significant potential for dissemination and structurally integrates the involvement of the primary care sector.
The Brussels Region has also been supporting Solvay for a number of years as part of a European ‘IPCEI’ project on 4th generation batteries. Solvay is working in Brussels with a wide range of academic teams on this project, which ultimately aims to develop and relocate value chains in support of the energy transition.
Finally, Casa Legal is a good example of a dynamic player in the field of social innovation. It received initial support in 2021 and has just introduced a project to spin off its model. Casa Legal is the first organisation in Belgium to integrate an interdisciplinary approach into legal aid. It offers holistic care integrating several areas of law as well as psycho-social support.
Could you remind us what the Shifting Economy is all about? Where are we two years after its launch?
The Brussels economic transition strategy, the ‘Shifting Economy’, is a global reorientation of all the economic and R&D&I tools in Brussels. This reorientation aims to respond to the social, environmental and climate challenges - in particular the decarbonisation of our economy. In concrete terms, these tools are: support,


accommodation and financing for businesses. The reoriented economic and R&D&I aid therefore supports players in either integrating transition processes or developing them.
For the past 2 years, we have been working to amend the legal bases in this direction, in continuous discussion with the economic players. The administrations that manage this aid are now fully operational to make this transition a reality. We are confident that the next government will continue this momentum.
How can scientific research contribute to economic transition? What current projects illustrate this contribution?
We have chosen to base our R&D&I strategic priorities on the major societal challenges facing Brussels. Insofar as the economic transition responds to these challenges, we now find ourselves with a majority of research projects, whatever the players behind them, that contribute to the transition.
The Circular Innovation programme has seen the emergence of many projects that illustrate this in an ‘obvious’ way, but it is really a cross-cutting dynamic that can be found in all types of projects. Environmental and social issues are increasingly being taken into account by project promoters, who generally welcome the importance attached to these issues by the Region.

An interview with Ms Julie LEROY, President of the Science Policy Council of the Brussels-Capital Region (CPSRBC), Innovation expert at Agoria
What are the missions of the CPSRBC?
The CPSRBC is an independent advisory body to the Brussels government which brings together experts in research and innovation in the region: universities, colleges, research centres and social partners (Agoria, Essenscia, BRUXEO, trade unions, etc.). It advises the Brussels government in the preparation of its science policy and keeps a critical, constructive eye on this policy. A true forum for exchange between all its members, the CPSRBC formulates advices and recommendations at the request of the regional government or the cabinets of Ministers like Minister Barbara Trachte, responsible for science and innovation. For instance, Ms. Trachte presented us her “Shiftingeconomy. Brussels” initiative and suggested that the issue of gender equality in the RDI area could be the subject of an advice. Requests for advice by the government or cabinet are usually made for the implementation of new legislations touching on RDI policy, as well as for the implementation of new political plans such as the regional operational planning for the European Regional Development Funds. Advices are often initiated by the CPSRBC itself.

How do you view regional policy on science, research and innovation?
Brussels-Capital is recognised by the European Commission as a European leader in innovation. Indeed, it excels by its vibrant innovation system in SMEs, a strong collaborative dynamic, a strong knowledge base and a very strong performing scientific fabric (highly cited publications and scientific collaborations). Furthermore, a

solid expertise base in ICT makes Brussels a digital capital. It must also be said that Innoviris (the Brussels-Capital Region’s innovation funding agency) plays a central role in granting aid to innovative companies. It is a very efficient, available and competent player, who manages the available resources well. I would, however, have three reservations: the difficulty of putting the results of research into industrial use, which limits the creation of potential jobs; the difficulty for start-ups to move on to the next stage of scaleup in the production sector and to become international; and finally, the difficulty for companies to retain talent and recruit the right people. On all these points the CPSRBC is working with Innoviris to move things forward.
What advice have you given recently?
We have worked on a memorandum to address our concerns to the politicians and the future Brussels government. Other recent advices concern comments on the preliminary draft of the 2021-2027 ERDF programming in the Brussels-Capital Region, as well as on the 2021- 2027 Regional Innovation Plan (RIP) and the Smart Specialisation Strategy. For the latter, the council also contributed to the development of the monitoring tool. In addition, Advice 58 on regional gender equality policy in the field of RDI made recommendations to improve the gender balance in the evaluation panels of research programmes and within these programmes themselves. In total, the CPSRBC has issued almost sixty opinions since 2001.
How are Agoria and the Brussels-Capital Region working together to further encourage scientific research and innovation in Brussels?
As a federation of technology companies, Agoria is actively involved in promoting innovation and works with the training organisations Technicity and Digitalcity to develop their offer in accordance with the challenges of the Brussels region. Agoria also participates in the “Sustain.Brussels” project (“European Digital Innovation Hub” call for projects) which supports companies in the optimal use of artificial intelligence to develop their business. What is more, Agoria has a board of directors for the Brussels based members headed by René Konings to help these companies face their various challenges.
We also support our industry with studies: “Digital4Climate” has established that 5G increases the level of data processing but the average impact of the 5G application will drastically reduce our energy impact; “Be the change”, which looked at the jobs of the future and the skills to be developed in this context, was taken into account by the two training organisations mentioned above. Ultimately, Agoria is acting to guide the decisions of the Brussels government in the interests of businesses, which in turn will be better able to help the region’s development. A virtuous circle!
An interview with Dr Marius GILBERT, Vice-rector for research and development, ULB FNRS Senior Research associate
What are the key figures and the strong points of research at ULB?
ULB represents more than 4,000 researchers and professors, 2,000 PhD students, 230 theses defended each year, and over 200 research units and interdisciplinary research institutes. By 2023 the university had obtained 53 ERC grants and prestigious scientific prizes such as the 2013 Nobel Prize in Physics for François Englert, several Francqui Prizes and Wolf Prizes as well as 21 FNRS five-year prizes; and 5 Highly Cited ResearchersTM which rank in the top 1% by citations for their field(s) and publication year in the Web of Science™ over the past decade. Focused on scientific quality, ULB’s research strategy provides a fertile environment for the research community by helping them to seek funding, contributing to the administrative management of projects, promoting independence and academic freedom, and providing support infrastructures. In addition, ULB occasionally offers internal funding (theses, equipment) to encourage the exploration of certain very early ideas and facilitate the subsequent obtaining of external funding.

Could you give us some examples of ongoing research projects in the field of human health?
ULB develops a “canceropole”, a hub of scientific and clinical expertise with 27 research units, H.U.B-Bordet and H.U.B-Erasme aimed at improving patient survival, cancer treatments, screening and diagnostic techniques, and ensuring optimal care and a better quality of life for patients. ONCO.CARE is one of their ongoing projects: it aims to develop an integrated and personalized survivorship program for adult patients at the end of their oncology treatment. ULB inaugurated the European Plotkin Institute of Vaccinology (EPIV) in 2023. Supported by the federal funds and patrons, this institute works on the molecular mechanisms underlying the development of vaccines and carries out clinical research for the evaluation of vaccines in collaboration with UAntwerpen. The ULB Center for Diabetes Research (UCDR) is also internationally recognized: it studies the various aspects of the disease and participates in therapeutic and disease prevention projects.
Could you present some examples of European ongoing projects?
ULB leads or collaborates on various European projects in fields as varied as health, IT, sustainable development or humanities. In particular, in collaboration with VUB, Brussels Capital Region and Europe (FEDER), ULB created Usquare.Brussels. This hub aims to bring citizens, the city and knowledge closer together; it is home to USET (Urban and Socio-Environmental Transformations Research Hub), FabLabs, Openlab, BrIAS (Brussels Institute for Advanced Studies) and Europe’s Civic University Alliance, CIVIS. Also with VUB, ULB develops FARI, AI for the common good Brussels: FARI brings together world-leading researchers and experts in the
field of AI (Explainable and Trustworthy), Data (Open) and Robotics (human-centric) to meet challenges at local level.
Could you give us some recent examples of the valorisation of ULB’s research work?
Valorisation of research can take multiple forms, including collaboration between laboratories and industries, the transfer of intellectual property to partners, the role of experts or the creation of spin-off. I can highlight the activity of 5 recently founded spinoffs. Founded by Prof. Benoit Vanhollebeke, NeuVasQ Biotechnologies works on neuronal development, mechanisms linking the vascular and nervous systems, and the restoration of lost nervous system functionality through innovative therapies.
Santero Therapeutics SRL is a spin-off biotech founded in 2021 by Profs. Cédric Govaerts and Abel Garcia-Pino. The company is anchored in more than a decade of fundamental research carried out in the labs of the Founders. Santero Therapeutics aims to deliver innovative drugs with new mode of actions that target highly antibiotics-resistant pathogens. Founded in December 2021, Snellium has been dedicated to innovating the design of laboratory and production line devices, integrating cutting-edge solutions for optical quality inspection and analysis. Rehal-IT is a company founded in 2022 and aims at providing therapeutic virtual reality softwares (“serious gaming”) for the assessment and rehabilitation of patients with cognitive disorders. Finally, the Secoya technology is based on the integration of the most efficient microfluidic technologies in a robust stainless-steel equipment. This allows the pharmaceutical industry to improve its production processes.

Brussels has set up a new Hospital Innovation Centre within the Brussels University Hospital (H.U.B). The aim is to help the hospital identify its innovation needs and provide concrete solutions by creating a tailor-made pilot solution with healthcare professionals, patients and businesses. It’s time to take stock of this project, which has been running for two years in collaboration with hub.brussels, the Brussels Agency for Entrepreneurship.

Following a call for applications issued to Brussels hospitals in February 2022, it was the Brussels University Hospital (H.U.B) that was selected to develop this pilot project, led by lifetech.brussels, the hub.brussels cluster dedicated to health, with the support of the ERDF (European Regional Development Fund - www.feder.brussels). The project is designed to respond to a twofold observation: the world of business and the world of hospitals do not speak the same language, yet they need a direct connection if they are to develop innovation within hospitals.
Thanks to an unprecedented 24-month collaboration around this new Hospital Innovation Centre, we have been able to develop a win-win innovation process, enabling companies to co-create and test in situ solutions that meet the needs of hospitals, carers and their patients. In this way, we have been able to reduce the gap between the innovations produced and those that are actually integrated into healthcare institutions.
The center is pursuing two key objectives: fostering a culture of innovation within the hospital and developing a sustainable innovation process. To achieve this, we designed a 2035 Vision of Innovation document for the hospital and an action plan to put it into practice. We then tested the innovation process methodology through a pilot study focused on reducing the number of monitoring wires and cables for patients undergoing lung resection or esophagectomy.
The RDS solution, which won the contract, was implemented in the relevant H.U.B unit , on a sample of 25 patients. This initiative improved patient mobility, facilitated post-operative care and optimized nursing time. Additionally, it enabled remote monitoring of patients’ vital signs, providing greater responsiveness and more accurate tracking of post-operative developments.
Throughout this period, specific support was provided by lifetech. brussels and its partners in terms of project management, contacts with the business world and innovation strategy.
This first trial was accompanied by the broadcasting of 10 inspiring videos on innovation in healthcare institutions filmed in 4 countries and the publication of a practical step by step guide on how to innovate in healthcare institutions (available on www.lifetech. brussels/en/innovationcenter/).
‘In Brussels, the health sector stands out for its high and growing indicator values in the dynamics of entrepreneurship and employment. So it’s natural that hub.brussels should develop projects that support its deployment, especially as these have a direct impact on the people of Brussels. This sector is one of the biggest providers of jobs in our region. It’s up to us to support these players so that this remains the case, while helping to ensure that healthcare remains high-quality and accessible through innovation and contacts between practitioners and healthcare entrepreneurs’, explains Isabelle Grippa, CEO of hub.brussels.
This Innovation Centre at Brussels University Hospital is a pioneering initiative; it aims at inspiring other hospitals to develop both a genuine culture of innovation and a sustainable innovation process. This initiative is also contributing to establishing the Belgian capital as a center of excellence in healthcare.

An interview with Prof. Barbara CLERBAUX, Professor, FNRS Research Director (emeritus), Director of the Elementary Particle Physics Department at the ULB Faculty of Science

Could you tell us about your university career?
I am working in the field of particle physics, which studies the elementary blocks of matter and the fundamental interactions between them. This requires large infrastructure, typically particle accelerators. The particles (electrons or protons) are accelerated and are colliding at various interaction points where complex detectors are located. Researchers study the particles in the final state created by the interactions. During my carrier, I participated in four large experiments. I did my PhD (19941998) at the ULB studying the structure of the proton in the framework of the H1 experiment at DESY (an electron-proton collider located at Hamburg in Germany). I then moved to CERN in Geneva for a postdoctoral research stay within the ALEPH collaboration at the LEP (Large Electron Positron) collider. I analyzed the ALEPH data searching for new particles predicted by the supersymmetry theory. These particles were not observed, and strong bounds were put on their masses and on parameters relevant to this theory. In 2002, back at ULB at the IIHE, I started my permanent FNRS position, joining this time the CMS experiment at the Large Hadron Collider (LHC) at CERN and later the JUNO experiment in construction in China.
Could you tell us more about the IIHE?
The Inter-university Institute for High Energies IIHE (ULB-VUB) combines the experimental particle and astroparticle research groups from both Brussels universities, ULB and VUB. Created in 1972, it has about 100 physicists, engineers, IT and support staff contributing to world-leading international experiments probing the universe at the largest and smallest scales, such as CMS, IceCube, NRO-G, AUGER, JUNO and Solid experiments. In addition, it has a strong R&D division
based on detector development, data acquisition systems, and electronics. The IIHE deployed a large computing cluster that supports the processing of the vast amount of data produced by the experiments. I’ve been running this institute since October 2021.
What is the CMS Experiment?
CMS is a 15-meter diameter experiment consisting in a series of shells of complementary detectors that surround the LHC beam collision point. The IIHE, together with its Belgian colleagues from UAntwerpen, UCLouvain and UGent, was responsible for the construction of part of the tracker detector. The proton beams are accelerated at high energies and collide at the center of the detector. The most famous achievement of the CMS experiment is the discovery of the Brout-Englert-Higgs boson in 2012. At the IIHE, the CMS group is active in key research domains: precise measurements of the standard model particles, study of the BroutEnglert-Higgs boson, search for new particles and dark matter signatures. Right now, the IIHE is actively participating in the upgrade of CMS tracker detector. This upgrade is necessary in order to gather data at higher rates during the high-luminosity LHC (HL-LHC phase 2 upgrade), planned to start in 2030. A total of 1,600 silicon modules with on-detector data processing capability are being build and tested at the IIHE in a 120 m2 clean room.
What about the JUNO experiment?
In construction in China, this experiment will consist of a 35-m diameter acrylic sphere filled with 20 kton of liquid scintillator and instrumented by 18,000 large photomultiplicator tubes (PMT). The aim is to study the elusive neutrino particles (with very small masses and oscillations among their three flavours) and to measure some of their parameters with sub-percent level precision. The IIHE was responsible for the design, test, and construction of the backend cards for the electronics readout system. The group is also involved in various sensitivity studies using simulation data. The start of the JUNO data collection is expected in summer 2025.

An interview with Mr. Stefaan SONCK THIEBAUT, Managing Director of Innoviris

Could you present the missions and ecosystem of Innoviris?
Our principal mission is to support and strengthen applied research and innovation in our local companies (start-ups, scaleups, SMEs and large companies), the research centers (such as the universities), the non-profit sector and the public sector. Because innovation is crucial for the development of our local economy, our region and our society. A complementary mission is the promotion of science. This is especially geared towards young people: to make them understand the importance of science in meeting societal challenges and to encourage them to pursue a career in STEM (science, technology, engineering or mathematics). Finally, Innoviris represents the Brussels region at the national and European level. We encourage local companies and research centers to participate in national or European projects and to take advantage of European funding.
What financial aid is available to support the RDI projects of Brussels’ academic actors and companies?
The Regional Innovation Plan 2021-2027, with a budget of €400M, allows Innoviris to co-finance research and innovation projects. Innoviris has put in place several programs that respond to the needs of innovators along their journeys: from getting access to experts, cooperating with research centers, validating technologies or innovative business cases to applying for patents. Some programs are open programs, which means that we accept applications continuously, others take the form of project calls around more specific topics that have been identified as strategically important for Brussels. Each application is analyzed according to several precise criteria: the scientific or innovative quality, the feasibility, the economic value and the potential social and environmental impact on the region. In case of a positive evaluation, we propose that the Brussels-Capital Region government grant a subsidy to the project. We receive around 700 applications each year out of which close to half are financed, but the success rate depends a lot on the individual program.
© Innoviris
Could you give us some examples?
“Research & Development Project” is our largest program. It is an open program which co-finances industrial research, experimental development or process innovation within a company, potentially in cooperation with a research center. In general, smaller companies, cooperative projects and early phase projects benefit from a higher co-financing rate which can go up to 80%. “Innovative Starters Award” is a yearly program that I am particularly proud of. Three of our most promising young innovative start-ups receive up to 500,000 euros each to implement their strategic innovation plan. For the 2023 edition, 13 candidates competed for this prize with their ambitious projects. One of the winners in 2023, Sentometrics, was created through a R&D project supported by Innoviris, followed by a spin-off project carried out by the VUB. Sentometrics applies AI to the field of corporate social and environmental responsibility. The company specializes in monitoring the Belgian media landscape to detect ESG (Environmental, Social, and Governance) events. But our programs are not only about technology. In recent years, Innoviris has been paying more attention to innovation in the social economy: for example, we recently introduced the program “Prove Your Social Innovation” to help small companies to validate the viability of a socially innovative project. Some of our programs are oriented more towards research centers. “SPIN-OFF” finances research centers on their path towards creating a local spin-off valorizing the results of academic research. And through the program “Research Platform” we encourage cooperation between local research centers around critical topics such as new approaches in health.
In 2023, the Brussels-Capital Region launched a new tool to facilitate financing and support for innovation to entrepreneurs. Could you tell us more about it?
The new concept is called Innovation Journey (innovationjourney. brussels). It is a comprehensive, integrated and coherent offering pooling the expertise of 10 partners in Brussels. Its aim is to make it easier for businesses to access regional aid for research, development and innovation. Aid includes not only financial support but also other forms of free guidance and support. It is part of the regional “Shifting Economy” strategy, which aims to direct aid towards economic, social and ecological transition. Companies are supported in their research and innovation efforts to meet the societal challenges Brussels is facing. Developing a new idea, getting it validated and scaling it up: all these stages are covered.
© NOOSA®

NOOSA®’s circular fiber can be used for different applications such as apparel, activewear, upholstery, workwear, and many more.

Three sectors have been identified as part of the Innovation Journey... That’s right. They are advanced digital technologies (including, of course, AI), circular economy and social innovation. Health will be added soon. But that’s not all: we have identified certain gaps and decided to fill them by launching new programs and initiatives. For example, SustAIn.brussels now provides free help to enterprises that want to use digital technologies in a sustainable way. It was launched in May 2023 and is part of the new network of European Digital Innovation Hubs dedicated to facilitating business access to new digital technologies. SustAIn helps businesses to choose the best technologies, to access the right training, to find investors and partners in our local eco-system. It is a free service coordinated by business specialists (Sirris and Agoria), BeCentral, the digital campus located at the Brussels Central Station and academic partners (the Vrije Universiteit Brussel - VUB- and the Université libre de Bruxelles - ULB). It is funded 50% by the European Commission and 50% by the Brussels-Capital Region via Innoviris. In addition, SustAIn is working closely with FARI, an inter-university institute, run by VUB and ULB, that aims at enabling the use of artificial intelligence for the common good.
Any other initiatives to highlight?
We need to adapt continuously to the quickly changing innovation landscape. AI will no doubt play an important role. With FARI and sustAIn, Brussels now has a central hub around this important technology. In addition, Innoviris has adapted its own programs. We have recently launched a call that supports cooperation between companies and research centers around the application of Artificial Intelligence to physical systems. We will facilitate and fund the access of small companies to AI experts and will soon launch a program that will help companies to analyze the feasibility of generative AI technologies in their products or services. We talked a lot about digital and AI, but I want to highlight that Innoviris is financing other organizations that provide free support to our innovative companies in other domains: this includes Buildwise in the construction sector, SIRRIS in technology and CoopCity in social innovation. Innoviris is also committed to supporting research into Brussels...

Absolutely. It is important that we help our local policy makers to make informed decisions about the Region: this is Science for Policy. Innoviris funds two important initiatives and has a specific program funding research into the Region. Brussels Studies is an open-access scientific journal with original research on Brussels-related issues, published in French, Dutch, and English. It is quite unique. The journal also aims to be accessible to a broad audience, providing them with the analyses and tools necessary to understand Brussels’ societal challenges. It contributes to the promotion of solid and original knowledge about the Region, enabling a better understanding of its dynamics and offering insights for improved governance. The Brussels Studies Institute coordinates the scientific research on Brussels and unites five important academic institutions. It also forms the link between the academic and public ecosystems. In addition, Innoviris has a funding program aimed at research about Brussels: “Prospective Research Brussels” can finance academic research projects that apply the prospective approach to urban issues in our Region. Finally, Innoviris works on linking researchers in Brussels with other urban areas in Europe. The “Driving Urban Transitions to a sustainable future” European partnership addresses key challenges of urban transitions, engaging and collaborating with the many urban actors to share experience and expertise.
And how to work with Innoviris?
We want to be easily accessible to businesses. To this end, we have created a single access point called “Test your idea”: companies are invited to fill in a two-page document to find out whether their project has potential for Innoviris financing or whether they should be redirected to another funding agency. Having been an entrepreneur myself, I can tell you that this is highly appreciated!


Funded by Innoviris and scheduled from December 1, 2024 to December 1, 2027, a study on Alzheimer’s disease entitled «Translate AD» brings together three academic partners (UCLouvain, ULB, VUB), involved in collecting patient data, and three “industrial” partners Cliniques universitaires Saint Luc (CuSL), Erasme Hospital, UZ Brussel), responsible for creating the common database. Its objective: to pool patient data, evaluate new diagnostic and prognostic methods and thus improve their overall management.




Atthe beginning were three neurologists: Prof. Bernard Hanseeuw (ULouvain), Prof. Sebastiaan Engelborghs (UZ Brussel) and Professor Xavier De Tiège (ULB). They shared the same basic observation: the difficulty of collaborating in the “small world” of Brussels. It must be said that the acquisition of very different data on similar patients does not facilitate the sharing of said data. The fault lies in different expertise from different technologies, not to mention the ban on sharing data between colleagues. “It was urgent to come together to improve the clinical care of patients,” emphasizes Prof. Hanseeuw. This involves sharing processes, expanding patient recruitment and combining cutting-edge technologies to perform examinations that differ from standard clinical practices - technologies whose relevance and complementarity should be assessed. It is also a question of developing an IT system for exchanging research data and clinical data to enable hospitals to comply with the GDPR. Hence the involvement of the IT departments of the three partner hospitals.
At ULB, the project is led by Prof. Xavier De Tiège, director of the laboratory of translational neuroanatomy and neuroimaging. Two cutting-edge pieces of equipment are used there: the MEG (magnetoencephalography), unique in Belgium, and the PET-MRI, which combines positron emission tomography (PET) and 3-Tesla magnetic resonance imaging (MRI). Added to this is cutting-edge expertise in terms of sleep disorders, electrophysiology (long-term EEG - 24 hours) and magnetoencephalography (MEG) for in-depth analyses, including that of the hippocampus, with a view to predicting how patients are likely to progress. Patient’s recruitment will involve Dr Jean-Christophe Bier, while sleep investigations will involve Pr Mélanie Strauss. Prof. De Tiège highlights the two challenges to be met. The first challenge concerns the collection of a large number of patient
samples to gain efficiency and avoid the problems inherent in small groups. “The second challenge is linked to the difficulty of mastering the large number of possible markers of Alzheimer’s disease”, he adds. The three partner hospitals are therefore pooling their respective expertise. Alongside the ULB, UCLouvain brings its mastery of neuroimaging (tau protein imaging, amyloid imaging, brain MRI) while the VUB brings its knowhow in neurochemistry (analysis of cerebrospinal fluid and blood plasma samples) and genetic analyses.
These technologies have a significant advantage: they represent an alternative to the diagnosis of certainty established by biomarker using a PET scanner, which is not very widespread in Brussels and even Belgian hospitals. “This alternative corresponds to a diagnosis of probability and should allow development on larger masses of more accessible indicators” Prof. Hanseeuw stresses. This is an opportunity for the three partner universities and hospitals to accumulate massive data while developing IT tools for their ethical analysis. The solution: aggregate the data of several patients into anonymized metadata. Hence the ongoing development of the OMOP (Observational Medical Outcomes Partnership) common data model to promote the exchange of hospital data that previously existed in different formats. “Each hospital transforms its data into the same format, the same vocabulary, the same standard, the same coding,” explains Dr. Joëlle Thonnard, Data capability project coordinator at CuSL. In doing so, the language barrier is abolished. Once standardized, these data remain within the three hospitals: only the aggregated data of at least 5 patients according to given variables (age group, monthly mortality rate, etc.) are distributed. At this stage, the GDPR does not apply since it is no longer personal data.

“With this new study, we are using federated learning (algorithms on data from different sources) to determine the best predictive markers for the evolution of Alzheimer’s disease at all stages of development, from the early phase to the acute phase,” adds Yves Thorrez, data project lead at UZ Brussel. This hospital brings the expertise of its IT department, which manages clinical data for research and innovation. Two previous projects have been driving forces in this area: “SPECTRE-HD Data Capabilities”, designed to improve data sharing in the hospital landscape, and “Dimentia”, which already used data from neuroscience and machine learning to predict the progression of Alzheimer’s disease in patients.
A total of 90 participants will be recruited from December 1, 2024 to December 1, 2027. They will be perfectly characterized from a clinical point of view – a rare feat, making this cohort particularly interesting. But the study will go much further. ULB has obtained additional funding from the Fonds Erasme to increase the patient population by 60. The aim is to include healthy people as a comparison group. “There are genetic mutations that increase the risk of developing Alzheimer’s disease,” recalls Prof. De Tiège. “Federate learning can therefore use this information to strengthen the effectiveness of prognostic and diagnostic markers.”
In addition, the OMOP standard will allow data from several thousand patients from the three hospitals to be shared in a federated way over 3 years. Of course, the study protocol has been validated by an ethics committee and the 90 patients recruited will sign a consent form for the clinical management and research components. By comparing the new diagnostic and prognostic methods and applying them to make them more standard methods, the three partner hospitals will eventually be able to benefit more patients.




Specialising in mass spectrometry and omics tools, the Analytical Platform of the Faculty of Pharmacy at the Université libre de Bruxelles (ULB) brings together 3 Faculties, 4 professors, 2 technicians, around 15 researchers and 5 mass spectrometers spread over 2 campuses. The applications are both multiple and promising.

From translational research to clinical practice, mass spectrometry and omics tools meet a wide range of academic and industrial needs. The expertise of the Mass Spectrometry and Omics Tools Platform, the dedicated platform within the ULB Faculty of Pharmacy, Medicine and Sciences, is therefore particularly appreciated. This expertise is based on the use of cutting-edge equipment for applications in the fields of metabolomics, proteomics and interactomics.
Analyses of complex mixtures are carried out in an unsupervised manner along 3 main lines: aspects related to proteins, small molecules and interactions between proteins and molecules on the one hand, and between small molecules on the other. All of this is based on a wide range of samples: biological fluids, plant extracts, bacteria, human or animal cells, etc.
Dedicated to gathering information in response to research questions, the Mass Spectrometry and Omics Tools Platform is developing numerous applications with hospitals and university research laboratories. It is currently conducting around thirty metabolomics and proteomics analysis projects for the treatment of diseases as diverse as rheumatoid arthritis, neurology and urology. For example, it uses a mix of proteomics and metabolomics for translational clinical applications dedicated to biomarker research. The complementary use of a lipidomic approach (at tissue level) also provides an overall view of the sample analysed. The Platform also offers its analysis services to companies, whether to provide information on synthesised molecules or to monitor industrial processes (by identifying impurities or faults, for example). Other applications are also possible, starting with legal cases and archaeology.


is therefore to develop multi-omics tools to combine the different sources of information on variations in proteins and metabolites and their mutual influences. This would make it possible to define the effect of the environment on a patient, a cell, a plant, etc. Another major challenge is the multiblock analysis of metabolic/protein data and patient data (age, sex, drug treatments, etc.) in order to obtain results that are consistent with the clinical picture. This would enable us to go much further in interpreting the data.
The Mass Spectrometry and Omics Tools Platform has no intention of stopping there: it is well placed to obtain European funding to create a multiomics platform to serve hospitals in the Brussels region. This platform will integrate research results from ULB and its sister university, the VUB. It is due to start operating in early 2025. This is a great opportunity to make the most of Brussels’ potential, with its 2 major university centres (ULB & VUB), the highest density of hospitals in Belgium and a very high number of hospital beds. And a unique opportunity to collect data to better understand and classify patients. This will lead to improved therapeutic prospects and a better quality of life.

Analytical Platform of the Faculty of Pharmacy - APFP
Université libre de Bruxelles
For the Mass Spectrometry and Omics Tools Platform, the main challenge is to refine its means of analysing interactions between proteins and molecules. Similarly, interactions with genes and gene transcription in complex systems represent a vast field of investigation. The challenge
Faculty of Pharmacy
Boulevard du Triomphe 2, CP 205/5 - B-1050 Brussels
Tel.: +32 (0)2 650 52 63 - Email: apfp@ulb.be
https://apfp.ulb.be/

Vrije Universiteit Brussel (VUB), this is over 22,000 students from 145 countries in over 150 programmes. Over 4,000 staff members contribute to the mission of the university. And over 70,000 alumni made and make a difference all over the world as motivated entrepreneurs, critical researchers, and engaged citizens.

In addition to over 2,600 academic staff, VUB also has over 2,100 PhD students, of whom just over half have foreign roots. Together they are responsible for over 3,300 publications per year. Almost 250 PhD defences take place annually, not including the dozens of Joint PhDs.
“Our own annual research budget amounts to almost 33 million euros,” says vice-rector research Pieter Ballon. “In addition, we have 18 million euros from the Research Foundation Flanders for fundamental and basic research and 13 million via collaborations with the private sector, for the development or further development of products. Furthermore, there is 80 million euros in public project funding. This is competitively acquired capital, from the European Union or the Brussels Region, in many cases with the involvement of the private sector. Incidentally, VUB scores in the top 20 in terms of funding from the EU programme Horizon Europe. In the period 2014-2020, our researchers secured 205 projects, together worth 103.8 million euros. During the current period, at the end of 2023 their number already reached 119, together worth 88 million euros.”
VUB research led to numerous patents. “Currently, we can describe these as 216 active patent families, of which 71 as the sole applicant and the others with partners, such as Imec and VIB,” says Ballon. “In 2023, we filed 29 new patent applications. Our research has also resulted in more than 49 spin-offs. We have set up a special team for the valorisation and scale-up of our research results and the protection of intellectual property.” The scale-up activities are mainly concentrated in the research park in Zellik, near Brussels Airport. “There, we collaborate with external partners. Our policy is to make the spin-offs independent and to retain a limited number of shares ourselves.” In terms of attracting funds for fundamental and applied research, VUB
occupies the twentieth place in Europe. “Taken in consideration the total number of students and full-time professors, we were even in first place last year.”
European university alliances are a new type of inter-institutional partnership, unconstrained by geographical or traditional learning environments, which can bring together diverse populations for teaching and research, and which can lend support and resilience to individual partners as they face new challenges related to or impacting on higher education. VUB is a member in the European university alliance Eutopia. “Currently, Eutopia includes 10 universities, which coordinate their research policies. Like the VUB itself, the other participants are relatively young universities. This made it easier to quickly focus on a multilingual offering and to attract both lecturers and students from multiple countries. A young university can also pioneer more easily in matters such as multidisciplinary research. For example, we are at the forefront in the chemical dating of archaeological material.”
“A number of research themes we consider as key points. Among them is artificial intelligence. In 1983 we were the first European university to set up a lab for AI. Our Institute for Decarbonisation currently has almost 300 researchers. It is part of a cluster that also includes energy, sustainability and electric mobility. In the near future, we will also focus more on IT, robotics and life sciences, with the embedding of biomedical applications.”


Biomedical technologies developed at the VUB are already leading to new drugs. In 2024, two leading researchers secured ongoing funding for their groundbreaking research as part of the Flemish government’s Methusalem programme. They have been awarded 2.1 million euros each, for a term of seven years.
“We aim to develop a new strategy to effectively cure life-threatening inherited muscle diseases,” says Prof. Thierry VandenDriessche (division of Gene Therapy and Regenerative Medicine). “We want to address the root cause of the problem. By effectively and safely transporting functional copies of healthy genes to the muscles and heart, we can reverse the disastrous effects of these diseases.” The goal is to develop a sustainable solution that not only improves patients’ quality of life but can alleviate the socio-economic burden on society. This innovative strategy can be widely used to treat other inherited muscle diseases, positively impacting the fight against disease and suffering.
Prof. Jan Steyaert (director of the VIB-VUB Centre for Structural Biology) takes a different approach. “Nanobodies, also called camelid antibodies, were discovered in our laboratories 30 years ago by Raymond Hamers. Subsequent work at the VUB is at the basis of a global revolution, in which conventional antibodies used in research and medicine are systematically giving way to nanobodies,” he says. “We want to develop new applications in immunotherapy. Specifically, we aim to develop drugs inspired by the natural function of the immune system to treat patients more effectively and with fewer side effects.” Steyaert also has the ambition to establish a pharmaceutical company based on these insights. “We are bringing together all the nanobody expertise developed over the past 30 years and will share it with the scientific community from 2025 via the global knowledge base NanoSaurus.”
The VUB research infrastructure is clustered in 11 core facilities and infrastructure platforms.
• The Brubotics Rehabilitation Research Centre (BRRC) is an interdisciplinary human movement analysis lab, focusing on robotic and technology-supported rehabilitation research.
• The In Vivo Cellular and Molecular Imaging (ICMI) core facility is specialized in nuclear and optical imaging of small animals. The lab is equipped with a myriad of multi-modality cameras and ex vivo analysis techniques. It is situated in a biosafety level 2 environment.
• The Flow Cytometr y core facility (FlowCore) has a variety of flow cytometry instruments. Users can be trained to utilize these instruments correctly to analyse and/or sort biological materials.
• The Materials Characterisation facility provides a collection of analytical tools, that makes the characterization possible of all types of materials.
• Microlab is a 300 m² class 100 cleanroom dedicated to advanced microfabrication of glass and silicon for microfluidics. It is an open access facility, supporting both the research community and industry.
• Square provides complementary support in statistics and methodology, for individual researchers and research groups.
• The Animalarium oversees the housing, care and management of animals used in research.
• The VSTA core facility offers in situ detection of DNA aberrations, multiplex RNA expression, point mutations (DNA/RNA/ Basescope) and multiplex protein expression with brightfield/ fluorescence whole-slide imaging and digital image analysis.
• The Social Sur vey (TSS) is an advanced data infrastructure co-owned by all Belgian universities and intended to boost and integrate interdisciplinary research in behavioral and social sciences. TSS fields a yearly core questionnaire to collect basic information.
• The Brussels Digital Text Lab (B-TXT) clusters and consolidates existing expertise at the VUB to support researchers in the social sciences and humanities and beyond in collecting digital, textual research data, in analysing digital corpora, and in archiving and preserving research data and results.
• The core facility Humanise (HUMan and ArtIficial miNdS and bodIEs) aims to make available expertise, experimental rooms and equipment for research on the human mind and body, to share and integrate expertise on methodology and use of advanced equipment.
What are the key numbers and areas of excellence in the field of research at UCLouvain Saint-Louis Bruxelles?
UCLouvain Saint-Louis Bruxelles excels in social sciences and humanities: law, political and social sciences, economics and business administration, philosophy, history, literature, translation and European studies. UCLouvain Saint-Louis Bruxelles has resisted compartmentalization, which at times may lead to differences in methodology and subjects between the various disciplines, and has acquired a widely recognized expertise in interdisciplinary practice, even in research, the originality of which makes its excellence. Whilst research contributes to opening new fields of knowledge, the interdisciplinary methods remain among the most efficient ones, due to their inherent creativity. The recent merger with UCLouvain does not change this dynamic in any way: the Saint-Louis campus will continue to develop these areas of excellence while enabling it to increase its international visibility. Finally, during my term of office, my team and I will be committed to directing the research produced on our site towards issues of inclusion. We will also ensure to deepen the Brussels roots of our work by collaborating, for instance, with local takeholders.
Could you cite a few examples of the current research programs at UCLouvainSaint-Louis Bruxelles?
Like the other universities of FWB (Fédération Wallonie-Bruxelles), UCLouvain Saint-Louis Bruxelles benefits from special research funds and manages to finance a great number of doctoral research fields We recently received a FEDER fund aimed to further increase Beamm, our fiscal micro-simulation research project originally funded by Innoviris (the Brussels Region Institute for Research and Innovation). The project started in September 2024 and will last until December 2029.Another Innoviris project also started recently is SOLIDHABRU, a research aiming to conduct an in-depth analysis of the legal model of the Community Land Trust (CLT) Brussels. It will examine the legal issues that may hinder its development and will provide insights to address certain gaps in its framework.
What research partnerships have you developed at a European level?
At UCLouvain Saint-Louis Bruxelles, we are particularly proud of the European dimension of many of our research projects. We currently have two ongoing ERC projects (Coaching Rituals, Bildung Learning), a Jean Monnet Centre of Excellence (EUNMUTE), and four Jean Monnet Chairs (EUGENDERING, EU Indo-Pacific, Regulating Africa-EU Value Chains and EUGlobal-Green). Last year, we also secured three Marie Curie Postdoctoral Fellowships: one in law, one in political science and one in philosophy.
Our research centres also develop international cooperation programs with a great number of European universities. Several transnational research projects involving the UCLouvain Saint-Louis Bruxelles have been funded by the European Commission under its Erasmus+ program. Among them, “RE-VISUALIZE: Gender and Islam in the Francophone Digital World” and “ARIE: Pour des Archives coloniales francophones appréhendées de manière Inclusive et Equitable” (For an Inclusive and Equitable Approach to French Colonial Archives), are still ongoing. Some of our researchers

in communication are also part of EDMO BELUX 2.0, a multidisciplinary hub that brings together fact-checkers, media, disinformation analysts, media literacy organisations and academics to monitor and mitigate disinformation in Belgium and Luxembourg. Our research administration has done a tremendous work in obtaining these grants.
How do you value the research work coming from UCLouvain Saint-Louis Bruxelles?
Our university has developed the valorisation of its research with the support of the Brussels Region (Innoviris). Our Knowledge Transfer Office (KTO) ensures the link between research at the university and the non-academic world. Its task consists in taking care of the diffusion, the mobilisation and the knowledge transfer to society, and in creating collaborations and exchanges between society and the university. In this regard, UCLouvain Saint-Louis Bruxelles recently launched a podcast aimed at promoting the research carried on by its researchers, with a special focus on Brussels. We are also an integrated member of the LIEU network, which gathers the KTOs from Universities within the FWB.
Although this type of research valorisation represents a quite recent development, let us stress that, for a long time now, some of our research centres have shown a keen interest in regional integration, particularly with regards to very advanced research on Brussels. Our Institute for Interdisciplinary Research on Brussels (IRIB) gathers these centres and hosts centres from other universities. We play a leading role in the Brussels Studies Institute (an interuniversity research platform on Brussels) and in the online magazine “Brussels Studies”. Thanks to our expertise, acquired through our research work on Brussels (particularly with regards to mobility issues), we have obtained many regional-funded research projects.

By Dr. Sébastien PENNINCKX, Head of Preclinical Radiobiology Research Unit, Radiotherapy and Medical Physics Department HUB
The Institute Jules Bordet (IJB), part of the Brussels University Hospital (HUB) is a leading oncology center in Europe, renowned for its comprehensive and multidisciplinary approach to cancer treatment. The primary mission of this institution is the delivery of effective treatments within a patient-centered framework. This mission is performed through a tripartite framework that integrates clinical care, research, and educational initiatives.
Within this framework, the Radiation Oncology Department at the Jules Bordet Institute stands out for its development in radiotherapy, a cornerstone treatment for nearly half of all cancer patients. The main focus of department’s research is related to the optimization of therapeutic ratio - a critical balance between maximizing tumor cell destruction and minimizing damage to surrounding healthy tissue. In recent years, one of the most promising developments in this area has been the emergence of FLASH radiotherapy (FLASH-RT), a groundbreaking approach that could redefine the future of cancer treatment.

FLASH radiotherapy is an innovative technique characterized by the ultra-fast delivery of ionizing radiation at dose rates thousands of times higher than those used in conventional clinical practice. Treatment can be delivered in a single session lasting just a few milliseconds, compared with daily sessions lasting several minutes. In addition to its rapidity of execution, FLASH-RT has demonstrated a similar efficacy in killing tumor cells as traditional methods, but with a marked reduction in radiation-induced damage to healthy tissues. This reduction in normal tissue toxicity addresses one of the major challenges of modern radiotherapy, offering the potential to significantly enhance patient outcomes and quality of life. The promise of FLASH-RT lies in its ability to overcome a key limitation of current radiotherapy practices. By minimizing the side effects typically associated with radiation treatments, FLASH therapy has the potential to revolutionize the field of radiation oncology, paving the way for it to become a new standard in clinical practice.
To fully unlock the potential of FLASH radiotherapy, the Jules Bordet Institute has launched a comprehensive research program encompassing physical, radiobiological and clinical developments,
all supported by our state-of-the-art facilities. This multidisciplinary approach aims at addressing the critical challenges in translating FLASH therapy from experimental settings to routine clinical practice. In this context, our medical physics team is focused on designing and testing new detectors specifically tailored for high-dose-rate beams in close collaboration with key industrial actors. These advancements are crucial for ensuring robust and reliable dosimetry during FLASH irradiations, which is essential for the safe and effective application of this technology in clinical settings.
On the radiobiological front, we are investigating the impact of beam structure (specific physical parameters of the irradiation) on the induction of the FLASH effect. This research involves a combination of numerical simulations and in vivo experiments across different animal models, including murine and zebrafish models. These studies are pivotal in understanding the underlying mechanisms of the FLASH effect, which remains a key area of interest as we strive to optimize treatment protocols.
Finally, the LANCE trial, set to be conducted in our hospital by Dr. Antoine Desmet, represents a significant step forward in the clinical application of FLASH therapy. This multicentric, randomized Phase II study will compare the efficacy and toxicity of high-dose rate FLASH radiotherapy against conventional radiotherapy in patients with localized cutaneous squamous cell carcinoma (cSCC) or basal cell carcinoma (BCC). Small lesions (T1) will be treated with a single 22 Gy dose of radiation, while larger lesions (T2) will undergo a fractionated schedule of 5 x 6 Gy. The outcomes of this trial will be pivotal in determining whether FLASH therapy can be safely and effectively integrated into a further standard of care.
This research program on FLASH radiotherapy is a representative example of the projects undertaken at the Jules Bordet Institute, where multidisciplinary collaboration is the heart of our innovation program. By integrating expertise across multiple scientific and medical field, the Institute steadily advances cancer treatment and remains committed to developing therapies that enhance patient care. This approach reflects our ongoing dedication to improving the effectiveness and safety of cancer treatments.





as the energy transition,
An
How do you view the current state of the Walloon economy, and what are your priorities in this area?
We need to ensure that our economy develops further. Despite our strengths, the indicators are not good. An employment rate of just 66.2% is too low.Wallonia’s economic situation is closely linked to the qualifications and training of young people, which are not up to the needs and expectations of our businesses. Our priority is to focus our policy on training and education. It’s also about responding better to employers’ skills needs, and even anticipating them, with a view to economic development.
In Belgium and Wallonia, we have an exceptional fabric of businesses and talent. However, it has to be said that the training on offer does not always match the needs of businesses, which can lead to shortages of the kind we are currently experiencing. Simplifying and rationalising the institutional and educational landscape, as well as the training and employment landscape, would help to make these sectors clearer, more efficient and more coherent.

Administrative simplification is clearly a priority. The watchword is efficiency! Rationalisation and simplification are ways of achieving this. We’re going to refocus resources and efforts on measures that promote economic recovery and meet current challenges and needs.
How are you working with the Government of the Wallonia-Brussels Federation to ensure a continuum between the research activities funded by the two institutions?
Dialogue and collaboration are essential if our investments in research and innovation are to bear fruit. This synergy is now reinforced by the dual role of Minister-President Adrien Dolimont, who is in charge of research for both the Wallonia-Brussels Federation and the Walloon Region. This facilitates close and coherent coordination of strategies between the two entities.
The aim is to build bridges between the different levels of government, encouraging practical collaboration and fluid exchanges. The aim is to ensure that scientific advances and funding are not compartmentalised, but complement each other. This involves shared mechanisms for supporting research, from the fundamental phase to industrial application, to encourage continuity of funding and support for projects throughout their development cycle.
These shared priorities enable us to coordinate our actions to better support researchers, universities and businesses in the development of projects, while strengthening our region’s capacity to innovate and position itself as a major player in Europe.
What role do you intend to give to research and innovation in stimulating the economy, employment and industry in Wallonia?
Research and innovation play a central role in the strategy to revive and transform the Walloon economy. However, to maximise their impact, an in-depth reform of the innovation landscape is needed.
In particular, this reform must involve streamlining the competitiveness clusters, clusters and incubators, with the aim of achieving efficiency. It is essential that this reorganisation is guided by the concrete needs of businesses. By putting businesses on the front line, we can better tailor public support to their realities and day-to-day challenges.
Another fundamental aim is to create an environment where innovative businesses can develop rapidly, without being held back by excessive bureaucracy. Flexibility and responsiveness must be at the heart of our approach, because they are essential if innovation is to really bear fruit.
To make the system easier to understand and simpler, we need to reduce administrative obstacles and make the processes for accessing support clearer and more straightforward. By streamlining procedures, we will enable innovation to grow unhindered, thereby helping to boost employment and strengthen industry in Wallonia.

How do you plan to facilitate the transfer of research results to businesses?
The reform of the research and innovation landscape aims to reorganise the operation of the competitiveness clusters, whose very purpose is to facilitate these transfers. By improving coordination between research and industry players, we are ensuring that scientific discoveries find their way to industrial application more quickly.
We want to promote access for businesses to research infrastructures, as this remains a major obstacle, especially for small structures. By supporting initiatives that enable these companies to work more closely with research centres, we are facilitating their access to cutting-edge technologies.
We are also working to encourage the creation of spin-offs from research. This means providing greater support for funding, incubation and mentoring mechanisms, to make it easier for researchers to become entrepreneurs. These spin-offs are often key vectors for technology transfer.
Finally, promoting a genuine culture of innovation is essential. We need to make researchers more aware of the value of their work and encourage them to explore collaborations with industry. This requires a change in mentality, with training and mentoring programmes to help them develop a more entrepreneurial approach.
What sector-wide research projects do you intend to support?
To support the competitiveness of our economy, we need to encourage research projects that are fully consistent with our industrial and economic policies, targeting each link in the value chains. The idea is to maximise the impact of innovations by ensuring that the results of research are transformed into concrete applications for our businesses and key sectors.
We will therefore continue to invest in strategic sectors such as the energy transition, digital technologies, health and industry. In the digital field, projects linked to artificial intelligence, cybersecurity and the digitalisation of industrial processes will also be a priority, as these technologies are transforming our industries and strengthening their competitiveness on an international scale.
Finally, it is vital to strengthen partnerships between businesses, research centres and universities to encourage open innovation and the emergence of new solutions in these sectors. By ensuring coherence at all levels, we are enabling these projects to develop harmoniously and have a significant impact on our economy and society.
What are the strategic sectors identified by the Walloon Government?
Wallonia needs to establish itself as a dynamic and innovative player, capable of meeting technological challenges. It’s time to reinvent our economic model by incorporating the latest technological advances and supporting businesses in the digital and industrial sectors.
We have a fabric of dynamic SMEs, and sectors such as aerospace, healthcare and agri-food are growing fast, not to mention biotechnology, aeronautics, cybersecurity, artificial intelligence and defence.
It is essential to focus our resources on initiatives with high potential. We need to give these companies the means to grow rapidly and connect to international markets. We want a Wallonia that

stands out for its boldness, its spirit of innovation, and that creates an environment conducive to the development of businesses, be they start-ups, scale-ups, SMEs or multinationals.
What are your industrial strategy and the opportunities offered by European regulations on state aid to support the development of Wallonia’s industrial capacity?
Our strategy is based on the ambition to strengthen Wallonia’s industrial capacity while remaining competitive at European level.
One crucial point is not to impose additional constraints on our companies that would not be required at European level. We note that some companies, whether French, German or from other neighbouring countries, comply with European regulations to the strict minimum. Why, in Wallonia, should we add extra layers of constraints? This could penalise our companies by creating a form of unfair competition.
We want a strong and dynamic industrial policy. It is not by being overcautious or asking too many questions that we will succeed in supporting the development of our economic fabric. Other countries do not hesitate to make full use of the room for manoeuvre offered by the European Union, and we must do the same. We must not be ‘more Catholic than the Pope’ by applying stricter rules than those imposed by Europe, because this unnecessarily handicaps our businesses in relation to their competitors.

The Institute of Pathology and Genetics (IPG) is a non-profit association founded in Charleroi, Belgium in 1958. It has 350 highly specialized and dedicated staff. Each year it carries out more than 450,000 analyses.
The IPG’s activity is based on 3 essential pillars: anatomic pathology, the molecular biology laboratory and the human genetics centre, one of 8 such centres in Belgium. In anatomic pathology, the pathologists use conventional and digital microscopy, immunohistochemistry with PDL1 markers, the latest generation sequencing as well as quantitative and digital PCR in order to carry out examinations in fields as varied as pneumology, gynaecology, haematology, dermatology, neurology, surgery and cytopathology.
In the field of human genetics, a double-specialized team of paediatricians and nephrologists with super specialization in genetics carry out supervised laboratory tests and family consultations for patients with rare diseases: diagnoses and prescriptions for innovative treatments are planned in this framework. Finally, the molecular biology activities bring together technologists, scientific experts and bioinformaticians highly specialized who carry out tests for constitutional and genetic diseases in order to guide diagnosis and define targeted oncological treatments that can increase patient survival.

The IPG carries out genetic consultations on its site but also on those of partner hospitals in Wallonia, collecting samples from them in order to carry out the three main types of examination mentioned above. In addition, its anatomopathologists participate in multidisciplinary oncology consultations in order to define targeted diagnoses and treatments. It is also an official research institute with an annual budget reserved for this activity. 25 projects are underway in order to improve the understanding of rare diseases and upgrade the multidisciplinary management of patients.
In 2024, the IPG took over the activities of the pathological anatomy laboratory at HUmani (17,000 histological analyses, 15,000 cytological analyses, 4 doctors, around ten technicians), providing it with a welcome regional consolidation. Similarly, the new head of the IPG’s pathological anatomy department has developed a 4-year institutional project (April 2024 - April 2028) that includes digital pathology, AI and technical consolidation. In addition, the new biobank manager has launched a strategic review to increase the number of tissue samples included in the biobank that can be offered to commercial companies or other laboratories for technical development purposes. The aim is also to achieve a clear structuring of the data associated with the samples kept in the biobank.
At the same time, IPG is consolidating its operations into medical centres with a cross-disciplinary, integrative approach. Two new divisions have been launched in 2024: the cancer pole and the prenatal and preconceptional genetics pole. The Institute’s visibility was also raised by the Belgian Presidency of the Council of the European Union, which led to several visits to its premises in the BioPark Charleroi: EU journalists, donors from the Foundation against Cancera Mexican delegation, representatives from the ERDF, etc. The IPG was also recognised as a high-volume institution under the

new NGS agreement for onco-haematology, which means that NGS analyses in oncology - an increasingly important activity for the Institute - will continue to be reimbursed by the INAMI.
In 2024, IPG has pursued the operationalization of its first strategic plan, entitled “Move Up”, with the advancing of several institutional projects, such as the implementation of a new electronic health record, development and validation of the optical genome mapping platform and extension of activities in molecular microbiology.
The outlook for the IPG is exciting, including the recruitment of two new paediatricians recognized as medical geneticists. The Institute is actively working on structuring its oncology genomics data to make it interoperable. It is also involved in the primary screening project for cervical cancer using HPV molecular testing and is re-equipping itself to anticipate the replacement of cytology by molecular biology from 1 January 2025. A proactive approach indeed!

Avenue Georges Lemaître, 25 B-6041 Gosselies
Tel.: +32 (0)71 47 30 47
Email: secretariat.direction@ipg.be http://www.ipg.be

Seqalis, spin-out of the Institut de Pathologie et de Génétique, IPG, in Gosselies, embodies in its very core the concepts of Services, Sequencing, Quality and Life Sciences. Seqalis aims at becoming a key long-term and trustworthy Contract Research partner of pioneering biotech, pharmaceutical companies and leading academies.

These last 2 years turned out to be a transitional period for Seqalis busy in implementing the new company strategy figured out in 2022 to access the 3 highly appealing markets selected by the management, Immuno-oncology, ATMPS (Advanced Therapy Medicinal Products) and Microbiology/microbiome. The results are globally positive in terms of Seqalis’capacity to generate promising market traction from biotechs and pharma companies with its enabling analytical platforms such as the qTCR seq (study of the adaptive immune response to immunotherapies by NGS approach) and cytogenomics.
Seqalis devoted a lot of its time to increase its market visibility and market presence by carrying out numerous and varied marketing actions such as the attendance at different types of national and international conferences. These conferences happen to be either scientific or business oriented. One can quote the 2024 Immuno-Bio series in Freiburg where we had a Seqalis booth and a first ever TCR seq talk given by our COO, Jean-Luc Henrioul and entitled: “ Seqalis’ qTCR seq platform, an unbiased and quantitative enabling platform to unlock the immune repertoire diversity”and the Bio-Europe Spring in Barcelona.
Now one needs to progressively go to the bigger picture in the sense that from a current marketing positioning in preclinical and early clinical trial phase, Seqalis ought now to expand its footprint both upstream and downstream from this position on the pharmaceutical value chain. That strategy considerably increases the chance to build long term partnership alongside the value chain and ensure bigger market value capture. This is what happened with our year-long collaboration with the Belgo-French company PDC*Line Pharma that is developing a therapeutic vaccine for lung cancer with dendritic-derived cells loaded with various cancer antigens. Seqalis started out its collaboration a few years back with basic qTCR seq analysis of some of their patients in phase 1 and then followed up by assisting them in developing an immune-monitoring strategy which will hopefully be implemented in the future in further downstream clinical trials. PDC-Line and Seqalis presented a common poster at the CIMT conference in
May 2024 in Mainz summarizing this very fruitful partnership so far. The poster is entitled:”Evaluation of the immune response using TCR repertoire analysis in patients with non-small cell lung cancer treated with a PDC*line cell-based cancer vaccine in combination with or not with an anti-PD-1”
Thanks to the IPG cytogenomics game-changing new analytical platform, the Bionano Optical Genome Mapping-based instrument Seqalis is currently finalizing service contracts with 2 top 10 pharmaceutical companies worldwide leader in Cell therapies for the control of the genomic stability and cellular integrity of their candidates.
Following up on the visit of M. Elio Di Rupo in 2023, Seqalis and the Institut de Pathologie et de Génétique were honoured in 2024 by the visit of M. Thomas Dermine, State Secretary for Economic Recovery and Strategic Investments, in charge of Science Policy. M.Dermine was presented with the wide range of state-of-the-art analytical services proposed to patients and to the healthcare community as a whole.
During this transitional period Seqalis has been confirming its bright short- and longer-term perspectives in developing its activities throughout Europe. The 2023 AWEX grant allocated to Seqalis in the scope of the first edition of the AWEX call for Internationalization Strategic Program.will certainly help in successfully setting foot in new strategic geographical markets in the near future.
The company is more than ever eager to grasp any new market opportunities taking advantage of its unique know-how and expertise in order to carry on helping its clients improve the daily quality of life of patients.


Seqalis
25, avenue Georges Lemaître
B-6041 Gosselies
Tel. : +32 (0)71 347 898
Email : info@seqalis.com https://www.seqalis.com

An interview with Mr Jean-François HEUSE, Public Service of Wallonia Economy, Employment, Research, Department of Research and Technological Development
What are the missions of the Department of Research and Technological Development?
With a budget of nearly 500 million € in 2023, the department is the main provider of funds in Wallonia for R&D units: companies, whatever their size, research centres, universities and university colleges.
To do this, we have two mechanisms, within a general system called ‘Win4research’: ‘window’ aid (which are our own programmes) or collaborative programmes (those in which Wallonia participates with other funding agencies, especially in an international framework).
I would also add the financing of projects of competitiveness clusters when the latter launch their own calls.

In addition to this first mission, we also accompany these research players. How do we do this? We help them, for example, to file a patent, to promote their research...
And thirdly, there are awareness-raising actions and public understanding of Science through the Science, Technology, Engineering, Arts and Mathematics (STEAM) strategy supported by the Walloon Government, competitions such as L’Odyssée de l’objet, CANSAT or the publication of a magazine for 40 years, Athena.
Could you tell us about the research support mechanisms for these Walloon research actors?
As I was saying, on the one hand, there is the “window aid”. This aid takes the form of a grant or a repayable loan and varies in intensity according to the size of the company and the qualification of the research (industrial research or experimental development). Unlike universities, which are financed at 100%, or research centres (75%), the regulations on State aid do not allow us such rates for companies. In concrete terms, this means that a company that has a project to finance submits it to us, we analyze it and, if relevant, grant financial aid.
On the other hand, there are calls. These are of two types: regional and international. In this case, the department launches, alone or with the support of the European Commission, calls for proposals. They can be thematic or non-thematic. A timetable is set: a launch date, a cut-off date and the evaluation and ranking processes are specified.
The international calls allow, as their name indicates, Walloon R&D actors to have an opening towards external markets and collaborations that they might not have internally.
Finally, I would also like to mention more specific aids, such as those which allow the creation of spin-offs, or which offer companies the possibility of hiring a (post)doctoral student.
That’s true! During the first half of the year, Belgium chaired the Council of the European Union. The last time was in 2010 and the next one is not planned until 2035 or 2036! For the first time, Wallonia had the lead in Research. This means that the department, in collaboration with other relevant administrations, participated in the intra-Belgium discussions, led by the Belgian Permanent Representation to the European Union and the ministry of Foreign Affairs, but also took part in ad hoc inter-ministerial committees. Many working groups were set up and, here again, the department chaired them.
And concretely, what are the results of this Belgian presidency in terms of R&D or the points you want to highlight?
The conclusions of the European Council on the exploitation of research results and on the report of the Horizon 2020 framework programme, drawn up by the officials of the Public Service of Wallonia, were adopted by the Research Working Group in March and then officially at the formal Council in May, by the European research ministers. We can be proud of it! It was a huge work…


During the month of April, several major events of the presidency took place. The European Research and Innovation Area (ERAC) Committee meeting took place in Namur to discuss their views on the next research framework programme. In parallel to this meeting, the European research attachés also met in Namur.
Later in April, the Marie Skłodowska-Curie Actions 2024 conference was held in Mons. The theme of this conference was the different careers that researchers can pursue. Many experts in the field shared their advice and experiences with researchers, representatives of the public and private sectors, policy-makers and stakeholders present during these two days, through round tables or parallel sessions. In the end, the conference was a real success: 252 participants from all over the world and all sectors, against 150 initially expected.
Finally, in June, another major conference, INDTECH2024 (Conference on Industrial Technologies), organized by the SPW Research and co-financed by the Commission, saw over 450 participants from stakeholders from research organizations, industry, SMEs, but also academic representatives to discuss the latest developments, technological challenges and future trends in industrial technologies.
In parallel to the conference, two other venues in Namur were used as exhibition spaces for Belgian or European research organizations and EU-funded projects so that they could present their activities and results in a pleasant setting.
What are the projects for 2025?
First, we will contact our new cabinet from the elections of June 2024. We will then present various notes of intent, including on the European partnerships in which we would like to get involved. Then the course of things will resume, interrupted by this presidency that I have just mentioned.

The Walloon Recovery Plan aims to strengthen the attractiveness of job-creating sectors, trades, skills, and study disciplines associated with STEAM (Science, Technology, Engineeering, Arts, Mathematics) and digital. The aim is to help reduce shortages and increase the employment rate. This project focuses primarily on STEAM, but also on the social benefit business sector and health companies.

Interview with Mr Jean-François DELAIGLE, President of the Science Policy Pôle (PPS), Wallonia
What are the missions of the Science Policy Pôle?
The Science Policy Unit is a consultative body whose main mission is to provide advice on science, research and innovation policy. Bringing together players from different backgrounds who are keen to work together, the PPS adds real value to Wallonia’s RDI policy through its work, studies and opinions. Charged with evaluating Wallonia’s science policy every two years, it publishes a report that carries out an in-depth examination of the Walloon research and innovation system, highlighting its strengths and weaknesses and making recommendations.
What is your assessment of the Walloon Government’s R&D&I policy?

The PPS has analyzed the Regional Policy Declaration 20242029. It found that many of the Walloon Government’s priorities coincide with those highlighted by the PPS in the CESE Wallonie memorandum.
Among these priorities, three seem unavoidable as they respond to challenges that the Walloon R&D&I system must take up:
- Restructuring the innovation landscape by improving the coordination of players and instruments in order to make the ecosystem clearer and simpler;
- Strengthening value-adding through better coordination of players, actions and stabilized funding, and improving the research continuum (fundamental, applied, development, innovation);
- Further digitalization and administrative simplification.
The Government’s program is also based on a desire to evaluate support measures and certain structures, which is essential if an efficient R&D&I policy is to be put in place.
On what topics do you plan to submit own-initiative opinions?
At the end of 2024, the PPS formulated proposals to enhance the value of R&D&I in Wallonia. These proposals focus on five areas: continuing to improve the functioning of the intermediation system, strengthening listening and dialogue in order to develop collective intelligence, encouraging more SMEs to innovate, facilitating market entry and strengthening the entrepreneurial spirit. The PPS will continue its work to refine the proposals put forward.
The PPS will also be paying close attention to the future of the regional R&D&I ecosystem, particularly in view of the end of the financial resources earmarked for innovative projects under the Recovery Plan.
Finally, at the start of this legislature, the PPS will also analyze the concrete measures that will be taken by the Walloon Government to operationalize the objectives of the DPR.
What other challenges does Wallonia face in terms of R&D&I?
In addition to the challenges identified above (restructuring of the landscape, reform and simplification of the policy mix, strengthening of exploitation), two others should be highlighted. The first is the need to increase the participation of Walloon players in European research programs, and the second is the need to attract more young French speakers to the STEAM (Science, Technology, Engineering, Arts and Mathematics) professions.
Participation in European programs has positive effects on Walloon players and on the regional R&D&I system as a whole, particularly through integration into international networks and access to additional funding. As part of the Horizon Europe program, complementary and coordinated actions should be implemented to further strengthen the participation of Walloon stakeholders and increase their success rate.
The participation of young Walloons in STEAM fields has been identified as one of the weaknesses of the regional R&D&I system and of the regional economy as a whole. It is therefore essential to continue the momentum by going beyond coordinating synergies between the various STEAM promotion structures and implementing a genuine regional strategy bringing together the various STEAM stakeholders and supporters under a single umbrella.


What are ISSeP’s four key areas of expertise?


ISSeP has four main missions: monitoring the quality of the Walloon environment (i.e. water, air, soil, sediments and waste), preventing risk and pollution, acting as the Walloon reference laboratory, and research and technological development. It draws on the scientific expertise of 300 agents in domains like field sampling, laboratory analysis, numerical modelling, geostatistical analysis, and Earth observation. Environmental monitoring activities cover the ambient air quality network, emissions control at 53 industrial facilities, physicochemical, microbiological and ecotoxicological surveys of surface and groundwater as well as sediments, and monitoring of contaminated sites and landfills. Risk and pollution prevention studies involve, for instance, the simulation of forecasting models and the assessment of accidental and chronic risks, the assessment of impacts on ecosystems and of human health exposure through biomonitoring projects and geostatistical approaches, as well as the monitoring of land use change using Earth observation methods. As you can see, ISSeP covers a wide range of activities related to protecting the quality of the environment and human health!
Could you tell us about the preliminary results of the PFAS-specific human biomonitoring (BMH-PFAS) for the Chièvres and Ronquières areas presented last June?
At the request of the Walloon government, following pollution by PFAS (perfluorinated and polyfluorinated alkyls) found in certain water supplies, blood samples were taken in 2024 by ISSeP from volunteers living in the Chièvres and Ronquières areas. Initial results

showed that residents in the areas studied had higher levels of impregnation with certain PFASs than the general Walloon population, indicating overexposure. To date, however, there is no scientific evidence to suggest that the water supply alone is responsible for the overexposure of residents in the areas concerned. Once finalised, this human biomonitoring will be a first step towards a better understanding and management of the risks associated with exposure to PFAS in Wallonia. Analyses and recommendations will be refined as new data become available and studies continue.
Could you give us a few examples of ‘upstream’ and final research projects financed from your own funds?
Among recently finalised projects, let’s pin four of them: CARIBOUH, which dealt with the risks associated with the spreading of sewage sludge on agricultural soils ; STEP-PE, which studied the impact of sewage plants on endocrine disruption in aquatic environments in the Walloon Region; MICROPLAST, which analysed the accumulation of microplastics in aquatic environments and BASILIC, which assessed the hazardousness of residual benzene associated with sites from the coal industry.
The Microcapteurs project (Walloon Environmental Health Plan) aims at improving air pollution mapping. Walloon municipalities will be provided with a mini-station to record concentrations of four atmospheric pollutants (NO, NO2, O3, PM2.5)and noise levels. In a later step, the recorded data will be used to developand apply algorithms for measuring noise levels, assessing data quality live and combining different data sources to improve air pollution mapping.



What examples of international research partnerships have you developed? I’m going to take one angle as an example. ISSeP is involved in several development cooperation projects in Rwanda and Cameroon, funded by the Agence Universitaire de la Francophonie (AUF) and the Académie de Recherche et d’Enseignement Supérieur (ARES). The common themes of these projects are medicinal plants, the quality of phytomedicines produced from them and the preservation of these resources, from a ‘One Health’ perspective combining human and environmental health. These projects are coordinated by the University of Liège. In Rwanda, the ULB and the University of Rwanda are also partners, as are two state agencies responsible for analysing phytomedicines (NIRDA and Rwanda-FDA). In Cameroon, our partners are the University of Yaoundé I, the Institut de Recherches Médicales et d’Etudes des Plantes Médicinales (IMPM) and the Institut National de Cartographie.
Another example is the tragic flooding in July 2021 in Belgium and Germany, which highlighted the vulnerability of these regions and the increased risks to the population by climate change. These events have highlighted the importance of having Earth observation data to better manage flood-related crises. These events gave rise to the project XXX funded by BELSPO (Belgian Federal Science Policy) in collaboration, VITO, IGN, UGent, UNamur and DLR in Germany.
Finally, the RTC2 project aims to strengthen the resilience of territories to natural disasters, particularly floods, by reducing risks, improving preparedness and integrating geographic information systems (GIS) for appropriate planning and management. The project is funded by Wallonie Bruxelles International in collaboration, the University of Namur, SPW-ARNE and Hassan II University in Mohammedia, Morocco.
How can you further strengthen your dual role of providing scientific and technical support to public authorities and anticipating future issues?
I will illustrate this dual role of ISSeP through the Air Quality Unit. Air pollution remains the main environmental threat to public health. Air quality data from our monitoring network are available on www.wallonair.be, which is the reference for information on air quality in the Walloon Region. This website provides citizens, scientists and local authorities with continuous monitoring of pollutants regulated by Europe. It also publishes scientific reports produced by ISSeP, forecasts and interpolations. It also includes a warning system in the event of ozone or smog (fine particles) peaks. At the political level, this tool can be used to check the effectiveness of the actions taken to reduce air pollution. Recently, www.wallonair.be has also included the publication of measurements from the mini-stations from the Microcapteurs project mentioned above in Walloon municipalities. These indicative measurements complement the reference data measured by the ISSeP’s air networks.
The website is continuously updated as new reference stations are deployed or other pollutants are measured by the mini stations, or in line with new European directives.

ISSeP
Liège Headquarters
Rue Chéra, 200 - 4000 Liège
Tel.: +32 (0)4 229 83 11
Email: direction@issep.be
http://www.issep.be



Unlocking opportunities: the services of NCP
The National Contact Point (NCP) Wallonia serves as a crucial gateway for researchers, businesses, and innovators in Wallonia, Belgium, to access the vast array of opportunities offered by European research and innovation programs, particularly Horizon Europe. As part of a network of National Contact Points across Europe, NCP Wallonia plays a vital role in bridging the gap between local stakeholders and European funding schemes. By providing expert guidance, support, and resources, NCP Wallonia empowers the region’s scientific and innovation community to thrive on the European stage.
Horizon Europe is the largest research and innovation funding program in the world, with a budget of €95.5 billion for the 2021-2027 period. It is a continuation of the successful Horizon 2020 program and aims to tackle global challenges such as climate change, digitization, and health, while ensuring the EU’s competitiveness in the global market.
The role of NCP Wallonia: NCP Wallonia is designed to facilitate access to European funding programs, focusing mainly on research, innovation, and technological development. It provides free services to organizations looking to participate in EU projects, particularly within the framework of Horizon Europe, the European Union’s
flagship program for research and innovation. By connecting local actors with international networks, NCP Wallonia helps Wallonian businesses and researchers to collaborate on innovative projects that have a global impact.
Key roles of NCP Wallonia include:
• Guidance on European programs: Navigating the rules and criteria of European funding programs can be complex. NCP Wallonia simplifies this process by offering clear explanations and guidance on eligibility requirements, submission procedures, and evaluation criteria.
• Personalized support and advice
One of the core services of NCP Wallonia is providing personalized support to researchers and organizations interested in applying for European funding. This includes:
• Tailored consultations: NCP Wallonia offers one-on-one consultations to help stakeholders refine their project ideas, align them with European priorities, and develop competitive proposals.
• Proposal review and feedback: To enhance the quality of submissions, NCP Wallonia provides a proposal review service. This involves detailed feedback on draft proposals, identifying strengths and areas for improvement to increase the chances of success.
• Information on calls for proposals: NCP Wallonia keeps stakeholders updated on the latest calls for proposals under Horizon Europe, ensuring they are aware of the opportunities that align with their expertise and interests.
• Partner search: One of the crucial aspects of European-funded projects is collaboration. NCP Wallonia helps organizations find international partners for research consortia, ensuring that local businesses and research institutions can work together with global leaders in their field.
• Training and workshops: NCP Wallonia organizes events, workshops, and training sessions on various topics related to European funding, proposal writing, and project management. These events are crucial for building the necessary skills and knowledge to succeed in securing EU funding.
From the conception of an idea to the final submission of a proposal, NCP Wallonia provides continuous support throughout the process. This includes feedback on projects proposals, legal and financial advice, and ongoing consultation during the project’s execution.
NCP Wallonia is driven by a small, dedicated team of seven experts who work tirelessly to provide personalized support to local businesses and research institutions. Despite its small size, this team brings together a wealth of experience in European funding, research, and innovation, ensuring that the advice and services they offer are of the highest quality.
Each team member has a specific area of expertise, allowing them to offer targeted support for different sectors and project types. Whether you are in biotechnology, digital technologies, sustainable energy, or healthcare innovation, NCP Wallonia has the knowledge and connections to help navigate the complex landscape of European funding.
Thanks to their compact size, the team maintains a highly collaborative and flexible approach, which allows for a personalized touch when assisting organizations. This close-knit structure ensures that each project receives attention tailored to its specific needs, creating a more effective and responsive support network for applicants.
Aligned with the Wallonia strategic priorities in R&D
Working closely with regional authorities and stakeholders, NCP Wallonia ensures that its activities align with Wallonia’s strategic priorities in research and innovation, fostering sustainable regional development.
With EEN (European Enterprise Network), a special focus is given to supporting small and medium-sized enterprises (SMEs) and newcomers to European funding programs, helping diversify and strengthen Wallonia’s participation in Horizon Europe.
Supporting the Smart Specialization Strategy (S3)
NCP Wallonia actively supports the region’s Smart Specialization Strategy (S3), a policy framework designed to focus regional innovation efforts on areas of competitive advantage and potential growth. By aligning its services with the S3 priorities, NCP Wallonia ensures that local stakeholders are well-positioned to leverage European funding to drive innovation in key sectors such as advanced manufacturing, digital technologies, and sustainable energy. This targeted approach helps enhance the region’s economic development and innovation capacity, ensuring a strategic use of resources and maximizing impact.
NCP Wallonia plays a critical role in disseminating information about European research and innovation programs and promoting local success stories through:
• Publications and Newsletters: Regular updates, newsletters, and publications keep the community informed about upcoming calls, success stories, and tips for navigating EU funding programs.
• Digital Presence: Through its website and social media channels especially on LinkedIn and on YouTube, NCP Wallonia provides easy access to resources, news, and updates, helping stakeholders stay informed and engaged.
NCP Wallonia prides itself on transparency and the celebration of the successes of the organizations it supports. Many of the success stories, detailing how local businesses and research institutions have leveraged European funding, are well-documented on the NCP Wallonia website. These stories highlight the diversity of projects, ranging from biotech breakthroughs to sustainability initiatives, showing how Wallonian companies are driving innovation.
In addition to written case studies, videos featuring these success stories are available on NCP Wallonia’s YouTube channel. These videos offer a more dynamic and visual insight into how companies and research centers have benefited from European funding, bringing real-world examples to life and offering inspiration to other potential applicants. These resources serve as a valuable tool for organizations considering applying for European funding, providing concrete examples of how to successfully navigate the process.
To further enhance its support to local actors, NCP Wallonia has launched a series of podcasts where advisors explain the latest European open calls and provide insights into how to successfully apply. These podcasts serve as a valuable resource for businesses, researchers, and institutions interested in European funding but unsure about the processes or opportunities available.
In each episode, the experts from NCP Wallonia break down the complex requirements of open calls, share tips on writing strong proposals, and offer practical advice on navigating the application process. The podcasts cover a wide range of topics, ensuring that whether you are a seasoned applicant or new to European funding, there is useful guidance to help you succeed. This accessible format allows users to gain critical insights at their convenience, whether during a commute or in the office. By leveraging these digital platforms, NCP Wallonia ensures that essential information about European funding opportunities is available in a user-friendly, engaging way, broadening their reach and impact across the region.
NCP Wallonia is an invaluable resource for the region’s researchers, businesses, and innovators, providing a range of services designed to maximize their success in European research and innovation programs. By offering expert guidance, personalized support, training, networking opportunities, and proactive information dissemination, NCP Wallonia empowers Wallonia’s scientific community to leverage European opportunities and drive regional growth and development. Whether you are a seasoned participant in EU programs or exploring these opportunities for the first time, NCP Wallonia is here to support and guide you every step of the way.
Could you tell us about the research and innovation promotion actions carried out by AWEX and WBI? Wallonia Export & Investment Agency (AWEX) and Wallonia-Brussels International (WBI) have developed a joint strategy for French-speaking Wallonia and Brussels innovation actors: universities, research centers, innovation clusters and companies. To do this, they rely on several networks active abroad, namely a network of academic and scientific advisors and a network of economic and commercial advisors as well as several strategic partnerships with foreign ecosystems, allowing technology and innovative companies to rapidly access markets with strong potential growth. Furthermore, WBI negotiates and activates bilateral research agreements in order to support international research and innovation projects as well as to promote the international mobility of researchers.
AWEX and WBI carry out various promotional and support activities. For example, each year the two administrations have a joint stand at the Hannover Messe, the world’s largest industrial technology fair. This major event allows us to present the entire innovation value chain with university spin-offs, start-ups, applied research centers, etc. The international visibility of our skills is thus reinforced, as are the opportunities for international collaboration. In addition, AWEX and WBI participate in various economic missions, technological missions, state visits, etc. Since 2016, we have also been collaborating with the French-speaking Belgian online media Daily Science: our science articles promote the scientific know-how of our ecosystem. Since 2021 and the renewal of the Wallonia Smart Specialization Strategy, we have also been supporting a range of strategic innovation initiatives led by our research and innovation stakeholders. A great example is the organization of an annual summer school by the TRAIL institute through our international networks. This event took place in Berlin in 2022 and in Nantes in 2023, allowing us to connect with other AI excellence ecosystems and position ourselves in European projects. This type of event is set to be developed and amplified along with other strategic innovation initiatives in the coming years.

With this in mind, AWEX’s annual action program, which includes 150 to 180 actions depending on the year, will increasingly specialize in these international technological missions, beyond the promotion of “pure” exports. We can also count on WBl’s Research & Innovation Unit, which, with the support of our network of academic and scientific advisors, promotes the excellence of our innovative ecosystems internationally and strengthens the presence of our players in international research cooperation programs and networks.
How does the One Stop Shop service help foreign companies wishing to set up research activities in Wallonia?
We capitalize on a legislative and fiscal environment that is favorable to such establishments, both at federal and regional level: this is demonstrated by the numerous incentives and tax deductions.
But that is not all: the attractiveness of our ecosystem based on a strategy of smart specialization is just as important. Innovation clusters, companies and universities offer an interesting network of academic, industrial and financial partners. In addition, we have concluded soft landing agreements with WSL, located in Wallonia and considered to be the 6 th largest technological incubator in the world. WSL does a fantastic job of welcoming and supporting innovative start-ups. Finally, AWEX has set up dedicated and specialized teams to monitor projects, to stimulate exports and to attract foreign investment.
How do you support the revival of Walloon companies active in the research and innovation sector?
How do you support the export activity of innovative Walloon companies? We accompany them through technological missions that meet their needs in terms of commercial accessibility to major international markets. These needs include on-site technological validation (with connection points for this validation), connection with local accelerators, acquisition of industrial property, and preparation of fundraising, access to local innovation or demonstrators. We rely on strong innovation ecosystems with trusted partners for companies to grow and develop their innovations.
The health crisis has highlighted the creativity and innovation of our ecosystem. All the technological sectors were mobilized to provide rapid responses to various issues: the production of personal protective equipment and parts for respirators, the transformation of production lines, collaboration with research centers, etc. It is this dynamism and reactivity that we want to encourage by informing all R&D operators of international missions, European programs through Horizon Europe, etc. We also make sure to identify local partners abroad in order to create connections for future research partnerships. This dynamic is already well underway with Brazil and Quebec. The support we provide for the mobility of our researchers and entrepreneurs is also part of this approach. Finally, we are keen to make companies aware of the importance of sustainable transition: it is crucial that they integrate this parameter into their DNA if they want to succeed in relaunching their activity and to convince their stakeholders of their commitment to social responsibility.
Agoria is the Belgian Federation for Technology industry. Together with its members and through technology, Agoria wants to make a significant, sustainable, and successful impact on economic and societal challenges.
Telecom & industrial industries, manufacturing & process technology, aerospace manned & unmanned, energy technology, building technology, safety, security & defence technologies, mobility & vehicle technology and co-creation, contracting & materials.
It is to these high-tech industries that Agoria devotes its energy. In these sectors, in Wallonia, Agoria represents the interest of 570 companies that employ almost 37.000 people in Wallonia and have a combined turnover of 15 billion Euros, two thirds of which are exported.
From day one Agoria has supported the setting up of a strong industrial policy in Wallonia. In this context, Agoria Wallonia facilitates sustainable collaborations and supports local ecosystems such as A6K, The PoD, La Grand Poste,… where businesses, governments, knowledge institutions, and citizens cooperate and build expertise around a specific technology or societal issue.
Digitalisation is, at the same time, a major challenge but also a great opportunity for our society and our industry. The health crisis of 2020-2021 has also reinforced our belief that technology, and particularly digital technology, is the source of many solutions to improve our way of life. Through its study “Shaping the future of work”, Agoria has analysed the impact of digitalisation on the job market in Belgium and proposes concrete actions to shape the response to these major challenges. Digitalisationespecially with the rise of generative artificial intelligence and Web3 technologies - will impact the content of almost all jobs, and skills will need to be updated to ensure job sustainability (https://bethechange.agoria.be/en/). In Wallonia, this will concern 1,200,000 professionals.
Another issue of concern to Agoria in Wallonia involves preparing manufacturing industry for the future and enabling it to be firmly rooted in Belgium in the long term. This is the objective of Make The Future, the programme wich offers the manufacturing industry a support based on the 7 pillars transformation methodology. The aim is to transform our companies into Factories of The Future. The Make The Future support programme starts with a scan of seven areas of transformation, focusing on making companies aware of their current status so that they can see where they stand with respect to other companies. The transformation phase can then begin.
Around 800 companies from all over Belgium have embarked on this phase up to now. These companies include, in addition to Agoria members, an increasing number of businesses from the food, textile, biotech and timber sectors. The programme’s success has not gone unnoticed at European level either. For

several years now, the programme has been deployed in other European countries, in addition to Belgium, through the European ADMA TranS4MErs Project.
By assisting industry in addressing the challenges of human Capital and digitalisation, Agoria is a crucial component in underpinning the sustainability of our industry and its development.
















For 40 years, Wallonie Entreprendre (formerly known as S.R.I.W. Société Régionale d’Investissement de Wallonie or Regional Investment Company of Wallonia) has been contributing to the development of the economy in the Walloon region of Belgium. It financially supports projects of companies located in Wallonia that are active in a wide range of sectors (aerospace, digital, environment, agro-food, chemistry, energy, biotechnology/life sciences,…).
he strategy of Wallonie Entreprendre in the life sciences sector is based on qualitative excellence, from the investment decision process to the follow-up and support of portfolio companies. This contributes to the development of an ecosystem in the biotech field that generates jobs, creates value and is attractive to foreign investors. The role of Wallonie Entreprendre as a risk capital provider in the life sciences sector is crucial, considering its capital-intensive nature and the high degree of risk associated.
The investment criteria that have been applied over the past decade in that specific sector, were defined and implemented to build and manage a balanced portfolio in terms of financial performance, risk and liquidity.
These can be summarized as follows:
- significant activity/added value creation and employment in Wallonia;
- investments under the form of equity in pre-revenue companies;
- investments under the form of equity or debt in commercial companies with recurring revenues;
- maximum investment depending on the maturity, the size and the specific activity of the company;
- minority investments with private investors, the role of lead being performed by a specialized investor with proven track record in pre-revenues companies;
- validation of human, technological, commercial, legal and financial risks.
The current composition of the portfolio is very diverse. It includes companies active in the development and/or commercialization of:
- therapeutics, diagnostics and services (CRO’s, CDMO’s, …);
- drugs (small molecules, biologics, cell therapy, vaccines, …), medical devices and e-health;
- specialized investment funds.
Investment funds and ecosystem-related companies appear indeed essential to the proper functioning and sustainability of the biotech sector within the region.
In addition to the investments, Wallonie Entreprendre is also aiming:
- to foster the networking of companies, in por tfolio or not, with all the identified added value professionals;
- to share the experience of the Wallonie Entreprendre Life Sciences team with companies, in portfolio or not, with the same expectation to provide them with added value.
Wallonie Entreprendre Life Sciences Facts & Figures (06/30/2024)
evergreen fund investing in Wallonia
60+ companies in portfolio
235 million € invested
network of > 1.500 experts, managers, consultants…
+140 million € cumulated return on investments.
https://www.wallonie-entreprendre.be/fr/expertises/life-sciences/

What is the importance of research and innovation for Wallonia at the start of this new regional legislature?
The new Regional Policy Declaration (DPR) places innovation at the heart of Wallonia’s economic transformation. Today, research and innovation are not just engines of growth, but essential tools for strengthening the resilience and competitiveness of our businesses in the face of current challenges, particularly the digital and low-carbon transition. The Walloon government has therefore put forward an ambitious industrial policy aimed at strengthening strategic autonomy and accelerating the development of innovative sectors such as artificial intelligence, the circular economy and technologies linked to decarbonisation. However, for this ambition to become a reality, it is crucial to strengthen the links between the various economic and research players. Close collaboration between the private sector, academic institutions and research centers is fundamental if Wallonia is to maintain a dynamic of continuous innovation.

Which of the research and innovation priorities supported by the DPR stand out?
Rationalising the regional ecosystems that support research and innovation is a key element of regional policy. We need to be bold enough to tackle their complexity and lack of synergy. In addition, the revision of the decree on support for research and innovation will also need to be closely monitored, in order to better respond to current needs and ensure a continuum between research activities funded by the Wallonia-Brussels Federation and those supported by the Region. Across the board, however, all public and private action should be guided by the need to enhance the economic value of research results.
How is AKT for Wallonia supporting companies in this new innovation dynamic?
We are fully committed to this dynamic, actively supporting companies in their innovation initiatives, whether large or small. The National Contact Point for Wallonia (NCP Wallonia), one of our entities, is committed to helping businesses maximise their participation in European programmes such as Horizon Europe.
Walloon businesses need to seize these opportunities, and I want to send out a simple message: call on our services, our experts are there to help you through the often complex stages of these programmes. In addition, we are working closely with the Government to strengthen local research ecosystems, in particular by improving the coordination of support schemes and streamlining aid to make it clearer and more effective.
Is collaboration between the private sector and universities still a priority?
Absolutely. Collaboration between businesses and universities is essential to stimulate innovation. In addition, the transfer of research results to businesses is a priority, particularly in terms of intellectual property and economic development. AKT acts as an intermediary to promote these synergies, ensuring that companies, including SMEs, benefit from the academic expertise available.
What role does taxation play in the R&D performance of Walloon companies?
Taxation remains a fundamental lever for supporting innovation and research. Measures such as exemption from withholding tax for researchers and deductions for income from innovation are essential to encourage companies to invest in R&D. The Walloon Government has announced its intention to argue in favour of maintaining these measures at federal level in order to preserve the competitiveness of Walloon companies and attract foreign investment. We can only encourage it to do so, and even advocate the reinstatement of schemes repealed by the previous federal government.
What are the challenges for the coming years?
There are many challenges. The cost of the ecological and digital transition, integration of AI solutions, budgetary pressures and the scarcity of talent in STEM fields are all obstacles to be overcome. But I am deeply convinced that innovation remains the key to overcoming these challenges. Let’s give the region a clear objective: by the end of this legislature, Wallonia should have entered the category of Europe’s most innovative regions in the European Commission’s rankings. I’m convinced that, collectively, we have the ambition. Once we get our act together, we’ll get there.




What are the key figures for the biotech and medtech sectors in Wallonia?
Belgium, and more specifically Wallonia has a rich and significant history in the field of life sciences, dating back centuries. The presence of industry leaders like UCB, GSK, Takeda and IBA has further solidified the country’s position in the life sciences sector. Belgium is one of the most advanced hubs of excellence for biopharma and healthtech technologies today.
Compared to our neighboring countries, Belgium is by far the country with the highest per capita investment in biopharmaceutical R&D in Europe. While Belgium only represents 2.6% of the EU population, the biopharmaceutical industry accounts for 7.8 % of jobs, 18.7 % of exports and 19.3 % of research and development expenditures within the EU. This puts Belgium in third, second and first place respectively in Europe1. Zooming
into BioWin’s 139 industrial members located in Wallonia, the health ecosystem has been steadily growing since 2013. Over the last 10 years, average annual employment growth has been 5.3%. Employment in our member companies has doubled in 17 years.The added value of member companies amounted to €5.9 billion (member companies developing R&D or industrial production activities). There is no doubt that this is one of the most important sectors in the Walloon economy.
Could you tell us about BioWin’s strategy?
BioWin’s role is to accelerate innovation to address the public health challenges of the future and to develop knowledge, employment and the competitiveness of everyone involved in the health sector ecosystem in Wallonia. The mission of BioWin is to drive the growth of the health innovation ecosystem in Wallonia and to become the leading health ecosystem in Europe, bringing together biopharma and healthtech technologies for a greater economic and societal impact.
BioWin will continue to follow its strategy that was deployed at the outset: supporting the emergence and development of R&D projects; developing talents; integrating companies in international markets; forming and nurturing networks and supporting the growth of companies.
BioWin is focusing on internationalisation and interdisciplinarity in order to achieve its goals for the next 4 years. BioWin will offer its members new opportunities for R&D collaboration with the best ecosystems in the world, near or far and will provide help to set up European projects.
To add to the value chains and nurture the health sector ecosystem, BioWin in close collaboration with AWEX will reinforce its efforts to attract foreign investors. And as part of the smart specialization goal in Europe2, BioWin will be prioritising those areas of activity and technology in which Wallonia has a competitive edge. Our strategy is to build on the excellence in our 2 main strategic domains: (bio)pharmacy and healthtech technologies with a specific focus on advanced therapies, nuclear medicine and health data.
What services does BioWin offer its members?
BioWin brings together 90% of the health- biotechnology- and medical technology players in Wallonia. The cluster therefore has a clear view of the technology value chains and an in-depth knowledge of the stakeholders in the region. This allows BioWin to
(1) cf. report published by Pharma.be chrome-extension://efaidnbmnnnibpcajpcglclefindmkaj/https://pharma.be/sites/default/files/2023-11/pharma_figures_eu_en.pdf (2) cf. S3 Wallonie https://s3.wallonie.be/home.html

offer its members the most appropriate services in terms of R&D, internationalisation, skills development and support for company growth. From early development in R&D to commercialization, BioWin provides support for projects arising from regional and international calls, and one-off assistance to SMEs and start-ups to support their economic development.
At the international level, BioWin works with the world’s most innovative regions to help its members identify the best partners for business and research collaborations. BioWin’s main focus is on networks and partnerships, forging links with key clusters and science parks.
Together with AWEX, BioWin helps Walloon companies increase their international activities by facilitating their visibility at key events in Europe, North America, South-East Asia and China. Together with other clusters in Europe, BioWin helps companies identify relevant gateways to enter key markets.
BioWin works to develop human capital, with a strategic focus on promoting innovation and growth in companies by (a) contributing to the forward management of skills and talents, (b) encouraging uniformity in the region’s training initiatives, (c) expanding and enriching the pool of regional skills and talents, (d) helping to create bridges between university
courses and industry. In addition, BioWin supports company growth by facilitating SME access to private sources of funding and by creating a favourable environment to attract and identify the best talent and expertise.
How does BioWin support its members in developing innovative projects and securing public funding?
BioWin initiates three calls for projects per year and offers sustained support in the development of the project proposals for participating consortia. For this support, BioWin’s R&D team help identify the required skills, facilitate the creation of the proposal and provide critical input. Furthermore, the R&D team supports a consortium by optimizing the procedures that are required to obtain the public funding. BioWin also monitors all funded projects with a particular focus on the results generated. The R&D project portfolio includes 71 innovative projects, with 49 completed and 22 ongoing. 87% of the projects have short to medium time to market.
Can you elaborate on the strategic initiative BioWin is leading in the field of Advanced Therapies and how it is contributing to the region’s ecosystem?
Belgium, and particularly Wallonia, have an ATMP ecosystem that is unique in Europe. BioWin, and its members, have been working for months on a strategic initiative focusing on advanced

therapies, disruptive approaches that open new fields in the history of medicine by enabling patients to be cured – and no longer just treated. In collaboration with the SPW-EER, we contributed to setting up and selecting the ATMP-PIT3 research and innovation portfolio. This portfolio is made up of 3 thematic pillars, each comprising 4 collaborative work packages, and bringing together a total of 26 partners in the field of Advanced Therapies. Public funding accounts for around 60% of the budget, which totals nearly €82m. The success of this project illustrates the interest of large public-private technological partnerships and opens the door to the construction of additional portflolio projects in other domains of excellence in the region.
What partnerships have you developed in Europe and abroad? BioWin is in contact with the world’s most innovative regions to help our members to connect with the best possible partners. We offer global networking events by making extensive use of our networks and partners (hubs, clusters, science and technology parks). By working closely with AWEX (Wallonia Foreign Trade and Investment Agency), we accompany delegations at international
(3) More information on the ATMP collaborative project https://biowin.org/2024/01/17/walloon-government-launches-innovation-partnership-with-e81-million-budget-over-three-years-dedicated-to-atmps-in-collaboration-with-biowin-and-the-public-service-of-wallonia/

Biopharma and Healthtech trade fairs (BioWin/ AWEX programme). We also organise first-class matchmaking events to help members in their international development with different objectives (R&D, strategic or business partnerships), always focused on specific topics based on our Smart Specialisation Strategy (S3). Our international strategy targets the following geographic areas: Europe, North America (USA, Canada), Asia (Japan, South Korea).
What are BioWin’s objectives for the next three years?
We are driving the development of three major sectors. The first, our ‘historic sector,’ which has been evolving for over 60 years in Wallonia, is the biopharmaceutical sector, encompassing vaccines, biomedicines, and advanced therapy medicinal products (ATMPs), including gene, cellular, and tissue therapies.
Simultaneously, we seek to consolidate the emerging and less structured medtech sector in Wallonia. This sector faces numerous challenges, particularly with respect to the European directive on medical devices, which significantly hampers its growth. However, we are beginning to reach a critical mass in the field of radiopharmaceutical products and the development of associated equipment. Lastly, we are promoting the e-health sector, focusing on digital solutions and AI applied to health data. We are collaborating with our Flemish counterparts to raise concerns with federal authorities on a range of issues, especially the secondary use of health data for research purposes, and to align ourselves with the European health data space.
How does BioWin envision its future role in expanding collaborations and evolving its strategy to strengthen Belgium’s position in the health and biotech sector?
We are poised to expand our outreach, particularly towards Flanders, fostering enhanced collaboration opportunities for our members. Through the unveiling of a comprehensive joint

action plan with our Flemish counterpart, MEDVIA, we aim to cultivate strategic alliances with this esteemed ecosystem, further solidifying Belgium’s as the « Health and Biotech Valley of the future ». Secondly, by leveraging the insights gleaned from the ATMP-PIT project, we will forge additional transformative public-private partnerships. Given the sector’s pivotal role, the convergence of private enterprises and public authorities around impactful research and development endeavors holds immense potential for our region, for the benefit of the patients. And furthermore, BioWin is steadfast in its commitment to evolving its revenue model, charting a course towards greater financial autonomy by introducing a set of innovative services for our partners and members. This strategic endeavor will not only augment our financial standing but also will enable us to present even more opportunities for our members and partners. ©

Key figures for the BioWin cluster (2023)
- 139 Industrial companies of which 11 large companies; - 86 service companies and partners;
- 5 universities;
- 11 Research & training centers;
- 5 Foundations, federations and other regional public entities ;
- 5 Investment companies and bioparks;
- 19K direct jobs in Wallonia.

With 2000 scientists in Belgium and a total of 9.000 employees, 19 candidate vaccines in the pipeline and 1.5 billion € of R&D expenditure in 2023, GSK is the largest pharma company in Belgium. GSK’s Wavre site is also the largest vaccines manufacturing center in the world with a total of 550,000m², which is more than 70 football (soccer) fields combined. This key player relies upon global vaccine R&D centers in Europe (Rixensart in Belgium and Siena in Italy) and in the United States (Boston). An interview with Phd Jamila Louahed, Vice President, Head of Therapeutic Vaccines R&D and the Rixensart R&D site Head at GSK.
What are your R&D priorities?
Our R&D focus is to deliver new vaccines and medicines, using the science of the immune system, human genetics and advanced technologies. Our vaccines innovation strategy focuses on 3 priorities.

First, we apply our platform technologies to focus on developing new vaccines and medicines with high impact to prevent or treat infectious diseases. Having an industry-leading broad portfolio of platform technologies, including recombinant protein subunits, mRNA, adjuvants, live attenuated viruses, toxoids, generalized modules for membrane antigens (GMMA), monoclonal antibody, and structural antigen design, is at the heart of our strategy to deliver against this ambition. We apply these technologies - sometimes in combination - based on scientific insights on pathogens and diseases to create tailored solutions.
Second, we want to broaden the impact of our existing vaccines to protect more people through lifecycle management and innovation based on our leadership in meningitis, shingles, RSV and pediatric immunisation (e.g., label expansion, new formulations, development of “next generation assets”).

Mrs Jamila Louahed,
VP Head of
Therapeutic Vaccines R&D and the Rixensart R&D center at GSK
Finally, we connect experts across a wide range of science and technology areas to push the boundaries of innovation. To deliver new and improved vaccines, we leverage our expertise in multiple disciplines (e.g., immunology, virology, bacteriology, structural biology, vaccinology) and breakthroughs in life sciences, artificial intelligence, machine learning, and data analysis.
We are fortunate to access huge capabilities and resources within the global GSK R&D organization (encompassing vaccines and medicines), and we complement it with external collaborations and acquisitions that help us deliver the vaccines and medicines of tomorrow. We currently have more than 150 external scientific collaborations globally (20 with Belgian academia and research centers), and our 2022 acquisition of the Boston-based biotechnology company Affinivax is a good example of this approach.
Could you tell us about the vaccine candidates in development?
We have promising vaccine and anti-infectious candidates in various stages of development for diseases with high unmet medical need. Our candidates for bacterial infections such as pneumonia could help reduce the use of antibiotics and play a role in the global response to anti-microbial resistance (AMR), which is a growing public health problem and contributes to approximately 700,000 deaths annually around the world.
Additionally, we have several vaccine candidates for viral infections with high disease burden.
Could you tell us about your research in the field of mRNA vaccines?
Advanced platform technologies are central to creating innovative, effective, and bestin-class vaccines, which is core to GSK’s R&D strategy. The COVID-19 pandemic delivered a proof of concept for mRNA vaccine technology, ushering in a new era of vaccines R&D across industry. We are leveraging GSK’s long history in mRNA research and significant capabilities in mRNA to make the platform technology suitable for infectious diseases with existing unmet medical need, such as influenza and COVID-19. Using different modalities and technology advances compared to the current standard of care, we aim to improve the efficacy and reactogenicity profiles of mRNA vaccines and continue developing our in-house mRNA and synthetic biology capabilities.
What is the contribution of digitalisation, artificial intelligence and machine learning to the design of vaccine antigens?
Advances in artificial intelligence (AI) and machine learning are playing a significant role in accelerating or simplifying vaccine development. As an example, we have partnered with other companies to pilot a Digital Twin, a complete and real-time simulation of the entire vaccine manufacturing process of one of our adjuvant’s components. The benefits of this technology are numerous, including speed (it can run simulations in hours instead of having to build a test plant), sustainability (it reduces the amount of materials and energy required for real experimentation activities), safety (assurance of quality


and yield predictions improve the reliability of supply), manufacturing agility (automation makes process robust and transfer between sites simpler), and education (off-line version of the Digital Twin can be used as a simulator for training). The potential is huge: GSK next plans to expand and replicate this model for the production of all future new vaccines and in some of its discovery activities. Ultimately, the goal is to deliver more vaccines and medicines faster to people who need them.
What do you see as the main challenges and opportunities in vaccine research?
There are still many diseases and conditions for which we do not have vaccines and where the scientific challenge remains. However, the acceleration of scientific discoveries and applications of new technologies present many opportunities to make progress and deliver for patients.
For example, the lead times and investments required to develop new vaccines is challenging. By applying innovative approaches to help validate our targets at an early stage, we can focus on developing our most promising assets and mitigate risks. In addition, combination vaccines for respiratory diseases hold great potential to improve protection, increase coverage, and reduce the burden of diseases like COVID-19 and the flu in older adults.
Another challenge in vaccines R&D involves the use of biological components which can be quite complex to produce at large scale. We have developed strategic collaborations to help optimize our production processes, like the Digital Twin pilot or nanotechnology to automate and improve control processes in biomanufacturing of our vaccines, including those in development phase. This continuous improvement contributes to consolidate Belgium’s strategic role in vaccine R&D and make Belgium the Health and Biotech valley of tomorrow.


GSK
Avenue Fleming 20, 1300 Wavre
Contact us at elisabeth.e.vandamme@gsk.com (external communication GSK in Belgium) or for scientific partnering at vaccinespartnering@gsk.com. https://be.gsk.com


CODIBEL, a family-owned Belgian company founded in 1964, has established itself as a prominent player in the health and beauty industry, specializing in cosmetics, medical devices, and biocides. With a commitment to high-quality, sustainable product development, CODIBEL continues to innovate and adapt to emerging trends and regulatory requirements. Positioned at the crossroads of science and nature, CODIBEL blends traditional values with a modern approach to create and nurture products that prioritize both consumer well-being and environmental sustainability.




CODIBEL’s journey from a small family business to a renowned European manufacturer is rooted in its dedication to quality, innovation, and environmental stewardship. It has developed a broad portfolio that includes emulsions, gels, pastes, and surfactant-based formulations for hair care, skincare, and oral hygiene, distinguishing itself with ISO 22716 and ISO 13485 certifications. These certifications underscore its adherence to high-quality manufacturing practices and stringent medical device production standards. CODIBEL’s proactive approach to regulatory changes, especially in the medical device and cosmetics sectors, positions it as an industry leader. The company anticipates and integrates environmental considerations into product development, a strategy that has become increasingly crucial as the regulatory landscape evolves.
CODIBEL’s mission aligns with its vision of “conscious beauty,” which emphasizes the health and beauty of both individuals and the planet. This approach underscores every facet of the company’s operations, from product development to final disposal. The concept of conscious beauty at CODIBEL embodies a journey toward reducing environmental impact while enhancing customer satisfaction. The company’s values—quality, family, commitment, sustainability, and authenticity—guide its actions and define its brand identity. The sustainability framework at CODIBEL is broad and encompasses environmental, social, and governance (ESG) aspects. This holistic approach is reflected in its dedication to supporting the United Nations Sustainable
Development Goals (SDGs), with a focus on direct positive impacts on goals like clean water, gender equality, affordable energy, and responsible consumption. CODIBEL also acknowledges areas where it can improve, such as reducing its indirect negative impact on marine life through thoughtful packaging choices.
CODIBEL’s sustainability report outlines significant progress in various areas, from raw material sourcing to energy consumption, water use, waste management, and more.
1. Sustainable product design and raw materials: CODIBEL’s Research and Development (R&D) team actively seeks to create environmentally friendly formulations. Its commitment includes a target for new in-house products to contain over 95% natural-origin ingredients. By 2023, the company achieved this goal, boasting a portfolio of products certified by the UK Vegan Society, COSMOS, and ECOGARANTIE. In addition, CODIBEL has pioneered anhydrous (water-free) and concentrated products, thereby reducing water use and minimizing waste.
2. Ethical sourcing: CODIBEL has developed a rigorous sourcing strategy that prioritizes suppliers who demonstrate clear sustainability practices. It sources from the EU wherever possible and demands adherence to environmental and ethical standards. For instance, CODIBEL uses certified sustainable palm oil and fair-trade castor oil and has developed internal standards for evaluating suppliers to ensure alignment with its sustainability values.


3. Packaging innovations: CODIBEL employs a “4Rs” approach - reduce, replace, remove, and rethink - to minimize packaging waste. Its packaging solutions include renewable or recycled plastics and large refillable containers to reduce single-use plastics. In 2023, it converted its “Color Defence” brand packaging to 100% recycled polyethylene, showcasing its dedication to eco-conscious packaging.
4. Energy and carbon emissions: CODIBEL’s manufacturing facility in Seneffe, Belgium, was designed for energy efficiency. The company has installed photovoltaic panels to meet 50% of its energy needs and aims to achieve carbon neutrality in 2025. Its energy policy emphasizes renewable sources, and the company plans further expansions to its solar energy infrastructure.
5. Water management: Recognizing water as a precious resource, CODIBEL uses a closed-loop system for water cooling and rainwater collection for non-potable uses, which reduced municipal water consumption by over 55% in 2023. CODIBEL has set a goal to minimize reliance on municipal water by transitioning to a sustainable water management system by 2030.
6. Waste and pollution reduction: CODIBEL’s waste management approach focuses on reducing, reusing, and recycling. Through these efforts, it increased its recycling rate to over 72% in 2023. The company strictly controls any potential pollutants, with measures in place to prevent contamination of soil and waterways.
7. Social responsibility and employee well-being: As a family-owned company, CODIBEL places high importance on
employee welfare and inclusivity. Over half of its workforce is female, including a significant proportion in management roles.
CODIBEL’s path forward: challenges and ambitions
As it looks to the future, CODIBEL is prepared to meet the dual challenges of regulatory compliance and environmental responsibility. CODIBEL views these as opportunities to enhance its position in the global marketplace, even as the evolving landscape places increased demands on small and medium-sized enterprises. Despite these challenges, CODIBEL remains dedicated to creating health and beauty products that harmonize scientific innovation with natural integrity.
By consistently prioritizing sustainability and adapting to regulatory changes, CODIBEL exemplifies how a business can thrive by balancing consumer demands, environmental stewardship, and economic viability. Through its partnerships and innovation-driven mindset, CODIBEL continues to lead the charge toward a sustainable and conscious beauty industry, setting benchmarks for both quality and ecological responsibility.

Codibel
Rue Jules Bordet 998/Y B-7180 Seneffe
Tel.: +32 (0)64 665 092
Email: mk@codibel.be https://www.codibel.be/

As an interdisciplinary biomedical research centre at the University of Liège, the GIGA is structured around 4 key areas: research, technology platforms, training and the hosting of biotech companies. Its researchers develop advanced medical solutions based on cutting-edge university research, with the aim of improving research and having a real impact on health.


Located within the University Hospital on the Sart-Tilman campus, the GIGA has more than 600 scientists specialising in the development of healthcare solutions for the benefit of patients. GIGA scientists include molecular and cell biologists, physicians, pharmacists, veterinarians, psychologists, chemists, physicists, mathematicians and engineers.
GIGA researchers are grouped into 5 domains: cancer, immunobiology, neuroscience, metabolism & cardiovascular biology and molecular and computational biology.
GIGA members strive for academic excellence to foster groundbreaking medical innovations. The GIGA has the highest concentration of ERC (European Research Council) recipients in the Walloon Region. GIGA members publish a peer-reviewed article every day, including in the world’s leading scientific journals. GIGA members have filed over 100 patent applications for medical solutions.
The GIGA comprises around fifty laboratories working in the 5 main areas.
The cancer cluster comprises 12 laboratories (Metastasis Research Laboratory, Human Genetics Laboratory, Medical Chemistry Laboratory, Cancer Signaling Laboratory, Conjunctive Tissue Biology Laboratory, Experimental Pathology Laboratory, Gene Expression Molecular Analysis Laboratory, Tumour and Development Biology Laboratory, Tumour Cell Stem Cells Laboratory, Molecular Angiogenesis Laboratory, Zebrafish Development Laboratory, Cellular and Molecular Epigenetics Laboratory), 19 PIs, 3 clinicians, 18 seniors and postdocs, 84 PhD students and 18 technicians.
The cancer division’s discoveries advance therapeutic prospects. Published on 20 August 2024 in the journal Cell Reports Medicine and entitled ‘In vivo vulnerabilities to GPX4 and HDAC inhibitors in drug-persistent versus drug-resistant BRAFV600E lung adenocarcinoma’, a ‘multi-approach’ study conducted by researchers from the Tumour and Developmental Biology Laboratory, in collaboration with their local and international partners, has highlighted new therapeutic vulnerabilities in BRAF mutated lung adenocarcinoma tolerant and resistant to targeted therapy. This discovery paves the way for better patient management and enables new treatment options for this highly aggressive cancer to be considered and tested. In another study published in the journal Nature Cell Biology on 7 June 2024 under the title ‘Valine aminoacyl-tRNA synthetase promotes therapy resistance in melanoma’, an international research team

led by GIGA scientists has discovered an interesting new therapeutic target for the treatment of melanoma resistant to targeted therapies. Inhibition of the VARS enzyme could prevent this therapeutic resistance by resensitising tumours resistant to these targeted therapies.
GIGA-Immunobiology brings together basic researchers and clinicians involved in fundamental, clinical and translational research in all areas of immunobiology (immunity, infectiology, inflammatory disorders). It comprises 9 laboratories (Cellular and Molecular Immunology Laboratory, Haematology Laboratory, Molecular Immunology and Signal Transduction Laboratory, Immunometabolism and Nutrition Laboratory, Translational Gastroenterology Laboratory, Pneumology Laboratory, Immunophysiology Laboratory, Rheumatology Laboratory, Inflammation and Rehabilitation Improvement Laboratory, Virology and Immunology Laboratory), 9 PIs, 9 clinicians, 19 Seniors & Postdocs, 34 PhD students and 17 technicians.
In a recent publication (‘Recruited atypical Ly6G+ macrophages license alveolar regeneration after lung injury’, Science Immunology, 2024), a team of researchers from the University of Liège identified a new population of macrophages, innate immune cells, which arrive in the lung following damage caused by respiratory viruses and play a crucial role in repairing the pulmonary alveoli. This discovery promises to revolutionise our understanding of the post-infectious immune response and paves the way for new regenerative therapies. Another publication (“External validation of serum biomarkers predicting short-term and mid/long-term relapse in patients with Crohn’s disease stopping infliximab”, Gut, 2024 Aug 12) validated blood biomarkers predicting recurrence of Crohn’s disease.
This research cluster comprises 5 Laboratories (Translational Nephrology Research Laboratory, Cardiology Laboratory, Molecular
Biomimetics Laboratory, Immunometabolism & Nutrition Laboratory, Surgical Research Centre - CREDEC), 2 PIs, 10 Clinicians, 4 Seniors & Postdocs, 7 PhD students and 7 Technicians. In 2019, the team led by Cécile Oury and Patrizio Lancellotti, directors of the Cardiology Laboratory, discovered that the drug used to prevent cardiovascular disease, ticagrelor, also had antibacterial properties against Gram-positive bacteria, including the most resistant. In a study published in the prestigious journal JACC (‘Protective Effect of Ticagrelor Against Infective Endocarditis Induced by Virulent Staphylococcus aureus in Mice’, Volume 8, Issue 11, November 2023, Pages 1439-1453), the same team described the drug’s remarkable activity against infective endocarditis.
Another study, published in 2023 (‘Targeted deletion of vonHippel-Lindau in the proximal tubule conditions the kidney against early diabetic kidney disease’, Cell Death Dis. 2023 Aug 26;14(8):562) targeted diabetes in relation to the kidneys. Diabetes attacks these organs by creating a lack of oxygen.
A new therapeutic strategy, based on the results of an international consortium co-directed by Prof François Jouret (Liège University Hospital), suggests acclimatising the kidneys to this lack of oxygen in order to prevent diabetic kidney disease.
This research area brings together 13 laboratories (Human Genetics Laboratory, Gene Expression and Cancer Laboratory, Digital Therapies Laboratory, Radiochemistry Laboratory, Animal Genomics Unit, Biomechanics and Computational Tissue Engineering Laboratory, Molecular Pharmacology Laboratory, Molecular Biology and Functional Evolution of Sensory Systems Laboratory, Fundamental Research in Intensive Care Laboratory, Zebrafish Development Laboratory, Functional Genetics Laboratory, Viral Interactome Networks Laboratory, Systems and Modelling Laboratory - BIO3), 17 PIs, 2 Clinicians, 34 Seniors & Postdocs, 33 PhD students and 11 technicians.
Recent publications include ‘GWAS reveals determinants of mobilization rate and dynamics of an active endogenous retrovirus of cattle’, Nature Communications 2024 Mar 9;15(1):2154): Doctoral student Lijing Tang and colleagues from the Animal Genomics Unit have developed a molecular method for quantifying the transposition rate of DNA sequences in bovine semen. Using this method, they have also been able to pinpoint the cycle of endogenous retroviruses. This provides a better understanding of the birth, expansion and self-programmed death of endogenous retroviruses in cattle. Following this discovery, Lijing Tang initiated a collaboration with a Swiss group (Dr Etienne Bucher’s team, Agroscope) to apply this method to transposable elements that

are still active in certain wheat varieties. In addition, ULiège and the CHU de Liège are jointly conducting the ENSEMBLE project, which has a threefold aim: to initiate the deployment of P3 (Preventive, Personalised, Precision) medicine in the Walloon Region, improve polygenic risk scores and adapt them to the specific profile of the diverse Walloon population. To this end, by mid-2025, 10,000 patients being monitored at Liège University Hospital will be included on a voluntary basis. By analysing and comparing the genes of individuals in a given population on a large scale, the aim is to assess, using a score, the risk of certain common and complex diseases (breast cancer, colon cancer, etc.) and, consequently, to step up screening and prevention of these diseases. This represents a new paradigm in prevention and medical monitoring over the next few years.
Another source of pride for the Molecular Biology and Computational domain, Grégory Fettweis was awarded a prize in April 2024 by the King Baudouin Foundation for his project entitled ‘Targeting 3D chromatin architecture as a new therapeutic avenue in Ewing Sarcoma’: as part of this project, he proposes to study the molecular mechanisms that establish genome architecture in Ewing sarcoma, a paediatric bone and soft tissue cancer caused by a chromosomal translocation leading to the fusion of 2 genes. In addition, he will characterise the impact of this DNA reorganisation on the gene expression programme characteristic of Ewing’s sarcoma and on its development. It will also carry out screening to identify small molecules capable of inhibiting this restructuring of the genome. More broadly, this project aims to explore the role of the 3D structure of the genome in paediatric tumorigenic and metastatic processes with a view to establishing their therapeutic potential.
This research cluster comprises 14 laboratories (Neuroendocrinology Laboratory, Anaesthesia and Intensive Care Laboratory, Ageing and Memory Laboratory, Physiology of Cognition Laboratory, MOVERE Laboratory, Coma Science Group, Evolutionary Neuroethology Laboratory, Developmental Neurobiology Laboratory, Clinical Neuroscience Laboratory, Molecular Regulation of Neurogenesis Laboratory, Data Acquisition and Modelling Development Laboratory, Nervous System Diseases and Therapies Laboratory, Neurophysiology Laboratory, Sleep and Chronobiology Laboratory, Sensation and Perception Group), 20 PIs, 13 Clinicians, 39 Seniors & Postdocs, 82 PhD students and 16 Technicians. In terms of publications, the study ‘Stress during pubertal development affects female sociosexual behavior in mice’ (Bentefour Y, Bakker J. Nature Communications 2024 Apr 30;15(1):3610) focused on puberty, a crucial phase in the development of female sexual behaviour (reproductive cycle and sexual performance). It is increasingly clear that exposure to major stresses during this period can lead to lasting sexual dysfunction. Hence the interest in studying the effects of chronic stress during the pubertal period on the neural circuitry regulating female sexual behaviour. The results of this study, conducted on female mouse models, demonstrate the importance of nitric oxide-producing neurons, which are crucial in processing the olfactory signals required for the expression of female sexual behaviour. Just as important, an international study launched in 2008 by Dr Nicholas Schiff (Weill Cornell Medicine), Steven
Laureys (Université de Liège) and Adrian Owen (University of Cambridge, now at the University of Western Ontario) has recently shown that patients with severe brain damage can show clear signs of consciousness when examined by brain imaging and asked to perform a complex mental task, even if they are unable to move or speak. The study was published in the New England Journal of Medicine (‘Cognitive Motor Dissociation in Disorders of Consciousness’, N Engl J Med. 2024 Aug 15;391(7):598-608). This is the largest study ever carried out on the prevalence of this condition, known as cognitive motor dissociation. Of the 353 adults with consciousness disorders recruited for the study, 241 patients were unable to follow bedside commands (for example, ‘open and close your hand’ or ‘imagine opening and closing your hand’). Yet 25% of these 241 patients were able to perform these cognitive tasks, as shown by patterns of brain activity measured by EEG and/or fMRI, comparable to those observed in control subjects. This suggests that many apparently unconscious patients may in fact be conscious and possess cognitive faculties. The results of the study should lead to new avenues of research, in particular the development of more accessible methods for detecting this dissociation, which, unlike task-based fMRI and EEG, could be used in a greater number of clinical centres. Ultimately, the absence of a response is not synonymous with unconsciousness and is much more frequent than the researchers in the study initially thought. It’s easy to imagine the ethical implications of this type of discovery, with its expected repercussions on the treatment of patients suffering from disorders of consciousness.
GIGA researchers are also involved in numerous European projects (ERC, Horizon 2020, Feder). For instance, Francesca Rapino has been awarded an ERC-Starting Grant for her ‘tRNAtoGO’ project (2020-2024). The aim was to understand the silent conditions (tRNA) that induce a population of healthy cells to become tumorigenic. The use of cutting-edge technologies was used to profile, genetically screen and physiologically test the role of different tRNAs in the establishment of cancer stem cells (CSCs). In the near future, the researcher hopes to generate a new technology to improve the early diagnosis of highly incurable cancers such as lung and intestinal cancer.
Head of the biomechanical engineering laboratory, Liesbet Geris has been awarded an ERC Consolidator Grant for her ‘INSTant CARMA’ project (2022-2027). This grant will enable her to continue her research into the development of new cartilage regenerative medicine techniques to treat osteoarthritis. Similarly, an ERC Consolidator Grant has been awarded to Thomas Marichal, Director of the Immunophysiology Laboratory and Welbio investigator, for his ‘MoMacTrajectALI’ project (20242029). This funding will enable him to continue studying the mechanisms of lung regeneration following respiratory infections such as Covid-19 or influenza, ultimately leading to the development of new therapeutic strategies to counter excessive damage and avoid severe forms of the disease.
The team led by Laurent Nguyen, Scientific Director of the GIGA, is taking part in the UNFOLD project (ERC-Synergy Grant 20242029), which is tackling the question of the mechanisms of folding
of the cerebral cortex from all angles, with a particular interest in understanding its complexity with a view to gaining a better understanding of the development and formation of our brains.
Finally, as part of the Horizon 2020 programme, Liesbet Geris is also involved in two projects: IN SILICO WORLD - Lowering barriers to ubiquitous adoption of In Silico Trials (2021-2024) and ONTOX - Ontology-driven and artificial intelligence-based repeated dose toxicity testing of chemicals for next generation risk assessment (2021-2026). These are all examples of research based on a commitment to scientific excellence, serving the patients of today and tomorrow.

An interview with Prof. Marie-Pierre HAYETTE, ULiège Faculty of Medicine, Department of Biomedical and Preclinical Sciences, Bacteriology, Mycology, and Parasitology, Interdisciplinary Drug Research Centre (CIRM)

Could you tell us about your expertise?
A pharmacist and clinical microbiologist by training, I hold a doctorate in biomedical sciences and combine three domains of activity: managing the clinical microbiology laboratory at CHU Liège, teaching at the University of Liège and conducting research in medical mycology and parasitology. As far as mycology is concerned, my laboratory is a National Reference Centre (NRC) for mycoses in collaboration with the KU Leuven. In Liège, we are specialized in superficial mycoses, and particularly in dermatophytes, which cause infections of the nails, hair and skin and affect 20-25% of the world population. We currently pay particular attention to the emergence of resistant dermatophytes strains which are currently emerging in Europe. We also focus our attention on Candida auris, a multi-resistant yeast causing nosocomial infections that can be serious, with risks of sepsis and death. In terms of parasitology, my laboratory focusses on malaria and echinococcosis. Malaria has been the subject of two 5-year research projects (development of a molecular detection assay to detect Plasmodium strains resistant to antimalarial drugs in Republic Democratic of Congo (DRC) and feasibility of systematic screening of patients by studying mutations in the malaria genome producing resistance to treatment). Finally, we are a reference laboratory for echinococcosis, transmitted to humans by foxes and dogs with tapeworm-infected intestines and whose alveolar form, is endemic in Wallonia, the Southern part of Belgium.
Could you give us a few examples of current research projects?
Following on from the two malaria projects mentioned above, a third 5-year project is looking at the risk of resistance of Plasmodium falciparum, the lethal species of the malaria-causing parasites, after exposition to long-term use of artemisia-based herbal teas by African populations. This project, in collaboration with the University of Kinshasa (Unikin) in the Democratic Republic of Congo, also includes a pharmacological study of the plants grown on site (Artemisia annua versus Artemisia afra) and an anthropological analysis including
populations who take it versus populations who do not. The results will show whether there is a proven risk of the emergence of resistance in P. falciparum, so that the WHO recommendations in this area can be refined. Considering echinococcosis, we launched a regional project about the detection of asymptomatic carriers of cystic echinococcosis, in Belgian residents originating or regularly visiting endemic countries like Marocco, Turkey or the Balkans. Regarding alveolar echinococcosis, we recently conducted a study comparing EsmB microsatellite genotypes from humans and animal hosts, such as foxes and rodents, to gain a better understanding of transmission dynamics in Belgium.
What research collaborations are you involved in?
As part of the CEDAR project, we are working in collaboration with other European reference centers for dermatophytes, under the coordination of the Danish one. The aim of this project is to characterize strains of Trichophyton indotineae, a species of Indian origin, which is emerging in Europe and the USA. This species is causing extensive skin lesions, can be transmitted from person to person and is difficult to treat because of resistance to terbinafine. This project follows another study which validated a standardized microdilution assay for susceptibility testing of dermatophytes strains to antifungal agents. Another project concerns dermatophyte strains transmitted by sexual intercourse in the homosexual male population, in collaboration with the Saint-Pierre Hospital in Brussels and the Hôpital La Pitié-Salpêtrière in Paris. The aim here, is to collect as many strains as possible over the course of a year to characterize them, inform clinicians and define the determinants of the affected population using a specially designed questionnaire. Finally, we are participants of a Franco-Belgian research group on dermatophytes, made up of members from my laboratory, Sciensano, and the Hôpital Saint-Antoine in Paris. This group is discussing the scientific studies to be carried out, trends, emerging strains or infections. It has even decided to offer lectures on dermatophytes at the next Trends in Medical Mycology (TIMM) conference, which will be held in October 2025 in Bilbao.
What are the main challenges in your field of research?
In microbiology, the major challenge is the development and spread of multi-resistant bacterial strains: according to various modelling studies, deaths linked to infections by multi-resistant bacteria should exceed those due to cancer by 2050. Yet there are few new antibiotics on the market, and even then, resistance develops rapidly. We therefore need to find another way for therapy, such as to combine antibiotics with enzyme blockers to inactivate bacterial enzymatic inhibitors, while we need also to improve hygiene conditions and prevent hospital-acquired infections. Other challenges include the control of malaria resistance, particularly important for Africa. It is important to control antimalarial drug delivery (quality of the drugs delivered, respect of the posology and duration of administration). These are all concerns that need to be passed on to the public and to decision-makers.
An interview with Prof. Dr. Arjen F. NIKKELS MD, PhD, ULiège Faculty of Medicine, Department of Clinical Sciences, Department of Dermatology and Vererology
What are the key figures for the Dermatology Department?
The Department of Dermatology monitors 45,000 patients a year, thanks to its team of doctors (11 FTE), nurses (4 FTE) and secretaries (3 FTE). Over the last 10 years, it is also involved in more than 60 clinical trials and has over 230 scientific publications listed on PubMed, with an H-index of 30.
What are the Dermatology Department’s main areas of research?
We have three main areas of research.
In the field of allergology, we are developing tests to detect allergies to contrast products used for radiographic imaging, to drugs as well as for food allergies.

In the field of dermato-oncology, we are studying viro-oncogenesis and in particular the beta papillomaviruses: our aim is to understand the role played by this virus in the development of squamous cell cancer, the second most common form of skin cancer after basal cell carcinoma.
In the field of cutaneous infectiology, we are working on diagnostic tests for herpes simplex and varicella-zoster viruses, in particular for their atypical manifestations.
Could you give us a few examples of current clinical trials?
A clinical project evaluates the role of teledermatoscopy, which allows us to ‘zoom in’ on suspicious pigmentary lesions to determine whether an urgent treatment is required.
Another study involves the transcutaneous administration of a chemotherapeutic agent, methotrexate (MTX), for the treatment of patients suffering from different forms of superficial cutaneous cancers. The aim is to couple MTX with hyaluronic acid, enabling it to be administered topically in high doses while remaining in the skin - a valuable asset to avoid any systemic repercussions.
What research collaborations have you developed?
Our various research projects involve collaboration with other departments at ULiège: the ENT, Pneumology, Paediatrics, Oncology as well as the Pharmacy and Galenics departments.
We also collaborate with the Universities of Maastricht and Aachen on the ‘oncology’ aspect of our research.
What do you see as the main challenges in dermatology research?
We’d like to be able to study more easily diseases that are neither rare (0.1 per 1000) nor frequent (>10% of the population), but still affect between 1% and 5% of the population. I’m thinking in particular of pityriasis rubra pilaris (PRP), lichenoid pityriasis, lichen planus, etc. So it’s important to have easier access to investigational medicines, even if the pharmaceutical industry considers these diseases to be of little financial interest.
Another challenge is the development of gene therapy for dermatological diseases whose gene origin has been demonstrated. We hope to see rapidly solutions for this, drawing on the ease of access afforded by the skin. In all cases, we are striving to meet unmet medical needs in dermatology.

Clinical aspect of a large sBCC (1a), aspect under occlusion directly after treatment (1b), aspect one month after last treatment (1c), total histological clearing after OFA-LP3-MTX3% (1d) (H/E, x10, scale bar = 140 microm), and persistant sBCC nests (yellow arrows) after LP3-MTX3% (1e)(H/E, x10, scale bar = 140 microm). (J Invest Dermatol 2020 Mar;140(3):583-592). ©

Biopharmaceutical company based in Liège, Dendrogenix is dedicated to developing “New Chemical Entities” (NCE) named Dendrogenins till early clinical development. These small molecules produced by the cholesterol metabolism stimulate cellular differentiation and promote neuronal survival. Dendrogenins are designed to address important unmet medical needs in the field of neurological disorders resulting from synaptic neuronal deficiency, such as “Hearing Loss” and more specifically presbycusis or age-related hearing loss. A first drug is expected to be on the market before 2030. We met with Stéphane Silvente, CEO and co-founder of the company.
Stéphane Silvente, since 2018, Dendrogenix develops first-in-class molecules, Dendrogenins, to address high unmet medical needs in hearing loss and neurology?
Dendrogenix currently employs around 20 people, including doctors in chemistry and biology as well as consultants who are experts in preclinical and clinical pharmaceutical regulatory development. Our company is active in the deafness market, for which there are no approved drugs yet and only hearing aids that amplify sound are available. The World Health Organization (WHO) estimates age-related hearing loss, regrouping people aged 60 and over, is the most common cause of hearing loss in the world and will reach more than 500 million people by 2025. Dendrogenix is also a promising company in neurology.

In this second area, Dendrogenix launched its R&D program called “STROMA” in September 2022. This ambitious program covers the indications of ischemic stroke and trauma brain injury (TBI). The STROMA project is financially supported by the Department of research and technological development of the Walloon Region which provided a grant of 1.5M€
During the SFN 2024 edition in Chicago in october, Dr. Quentin Marlier, head of biology at Dendrogenix, presented the promising results of the first two years of the preclinical data in mice treated with his novel first-in-class compound regarding its lead compound DX243 in stroke and TBI model. The presentation of these results was a great success with certain key opinion leaders who will allow Dendrogenix to rely on their expertise in this area.
2024 has been a pivotal and important year for Dendrogenix. You launched at the end of 2023 the first clinical trial on Dendrogenins to tackle age-related hearing loss?
Indeed, in the field of deafness, we initiated a monocentric first-in-human (FIH) clinical study in Belgium and this phase 1/2a study was able to start on October 2, 2023, at the INOKURA clinical center located within the SART TILMAN University Hospital in Liège. The phase I is subdivided into two parts. Part A consists of a single ascending dose study and during this phase A, no adverse systemic effects were observed, which will allow Dendrogenix to continue its phase B with confidence. Based on the results of the part A, Dendrogenix will define both doses: the low and the high doses used in the part B of the study. Part B will consist of a multiple ascending dose study with a maximum of 24 healthy volunteers included. Based on the results of the part B, Dendrogenix will assess the tolerability of multiple dose administration of the DX243. The phase IIa will consist in a multiple ascending dose study, with a maximum of 24 patients administrated by the DX243. This second part of the clinical study will provide Dendrogenix with preliminary efficacy results, required to design the phase 2b study.
For this development project, you can count on the financial support of key-partners?
This clinical phase 1/2a is financially supported by the Department of research and technological development of the Walloon Region (Wallonia research SPW - CLINEAR project) which provided 2.5M€ as financial support. Two fundraising events have already been successfully completed, involving several investors such as NOSHAQ & WE, as well as the private company MED-EL, specialized in electronic hearing aids.
Your company can also rely on a strong Scientific Advisory Board?
Dendrogenix’s expertise is centered around the chemistry and biology of Dendrogenins, a new class of molecules, and their innovative mechanism of action, which has already made an impact on the minds of leading experts in the field of deafness. Some of these experts sit on the company’s Scientific Advisory Board, which regularly calls on them to continue its clinical work at their best. In parallel, Dendrogenix has developed international research partnerships with leading players in the field of deafness and neurology, including world-renowned academic centers such as the GIGA-Neurosciences at the University of Liege, and the University of Tübingen in Germany.
In addition to the clinical development platform, Dendrogenix has developed a technological platform? Dendrogenix has developed expertise in the production process of the Dendrogenins thanks to its Medicinal Chemistry and Biology innovative Technological Platform which makes it possible to generate new


molecules. In addition to our Clinical Development Platform which draws on the expertise of our internal clinical team, Dendrogenix has developed a Technological Platform. Its main objective is to synthesize new molecules derived from Dendrogenins (analogs and prodrugs) and assess the therapeutic effectiveness of these new drug candidates in neurological diseases. This platform has therefore set up several in vitro and in vivo models of neurological diseases, enabling us to file patents, carry out proofs of concept, screen the effectiveness of their portfolio of chemical structures and discover by what mechanisms of action they work. Thanks to the technological platform, Dendrogenix has filed one family of patents for the past 4 years. Dendrogenix can be proud of its performance!
The strength of Dendrogenix also lies in this forward-looking potential? Definitely! Our company is watchful to market developments and wants to focus primarily on the area of auditory degeneration, while remaining open to other potential applications in various neurodegenerative diseases such as brain damage due to failure, and other neurodegenerative diseases related to mitochondrial dysregulation. In this regard, our company’s chemists and biologists are continuously working on the development and protection of the intellectual property resulting from new generations of Dendrogenins, as well as their therapeutic applications in new indications in neurodegenerative diseases.
Stéphane Silvente, it’s clear that the staff and scientists behind Dendrogenix are essential, but for you, investors are equally important to the development of your company?
Since our primary goal is to sell products, we want to take them as far into clinical development as feasible, at least to the end of phase II.
As a result, rather than picturing a single transaction including all our IP’s, our strategy is centered on fostering the development of different indications through various partnerships.
This plan of action relies on a well-structured investor syndicate. I have to say that I’m highly satisfied and proud of the composition of our board, which includes sovereign investment funds such as NOSHAQ as well as influent people like Dr. Ingeborg Hochmair, founder and CEO of MED-EL, famous for creating the first micro-electronic multi-channel cochlear implant in the world.


What are Dendrogenix’s long-term goals?
Dendrogenix can rely on its academic partnerships and its well-advanced clinical trial projects to confidently look forward to its medium-term development prospects. Dendrogenix also aims to extend its expertise in Dendrogenins to other families of derivatives or molecule analogs from the first generation. To do this, we can count on our experienced team to enhance our performance, through the extension of our initial patents and a new generation of Dendrogenins covered by the transformation of Belgian patents into international patents.

- Biotech company dedicated to the development of Dendrogenins till early clinical development
- CEO: Stéphane SILVENTE
- Areas of research: hearing loss and neurology
- 20 collaborators based in Liege, Belgium
- Ongoing clinical trial: DX243 in the indication of presbycusis - phase I
- Ongoing preclinical trial: STROMA - DX243 for stroke indication

Dendrogenix
11, avenue de l'Hôpital - 4000 Liège
Tel.: +32 (0)437 844 94
Email: contact@dendrogenix.com https://www.dendrogenix.com/

CM4CURE: We develop new high-efficiency antimicrobials combined with advanced polymer chemistry for simultaneously preventing thrombotic and infectious complications of coated medical devices.
Formerly known as CMD-COAT (until January 2025), CM4CURE is a spin-off company of Liège University, Liège, located in Sart-Tilman. We are dedicated to developing antimicrobial compositions and advanced polymer formulations to prevent infection and thrombosis of coated catheters and implantable medical devices. In addition, our antimicrobial compositions will be used in topical formulations to treat skin and mucosal infections.
The company addresses important medical, economic and societal needs related to the two most frequent complications associated with devices routinely used in medical practice and to resistant superficial infections, for which there are no specific or efficient medical treatment. The unique quality of simultaneously preventing infections and thrombosis represents an acknowledged significant breakthrough for the safety of medical device usage.

Thestory of CM4CURE was established in March 2021 with the creation of the CMD-COAT spin-off by Profs Cécile Oury (Head of Cardiology Lab at Liège University and renowned expert in platelet biology & thrombosis), Patrizio Lancellotti (Prof. at the Medical Faculty, Liège University, Director of Cardiology Department, CHU-Liège and globally recognized MD and researcher in cardiology) and Alain Nchimi (a radiologist, and expert in cardiovascular imaging). Profs Oury and Lancellotti have collaborated on a number of medical/scientific endeavors since 2011.
With the support of ULiège (via GESVAL), NOSHAQ and Walloon public investment funds, CM4CURE’s initial goal is to bring to market a brand new antithrombotic and anti-infectious coating for venous catheters. Its patented technology confers surface desired features such as antifouling, antiadhesive, antimicrobial and antithrombotic properties that will guarantee longer clinical performance than currently available catheters.
CM4CURE holds 2 patent families (granted in 33 jurisdictions) and has registered two trademarks in Europe and US: COATI-X® (that refers to the coating technology for venous catheters) and Fluometacyl® (the antithrombotic and antimicrobial active substance).
Antimicrobial resistance
The development of new Fluometacyl ®-based antimicrobial combinations has already given rise to 3 CM4CURE-owned patent applications targeting antibiotic-resistant bacteria and fungi. These three patents relate to further improving the coating technology and to develop a new broad-spectrum antimicrobial pharmaceutical composition based on Fluometacyl® - active against gram + and gram - bacteria and fungi. This is a welcome offer when considering antibiotic-resistant bacteria such as methicillin- and vancomycin-resistant Staphylococcus aureus, carpabenem-resistant Pseudomonas aeruginosa and certain fungi, starting with Candida albicans, can cause hospital deaths.
CM4CURE is involved in CLEAR (Cell Envelope Anti-bacterials, 01/01/2024 - 31/12/2027), an EU-funded Marie Sklodowska Curie European Training Network aiming to train 10 PhD students
to become outstanding researchers in the field of antimicrobial resistance (AMR).
CLEAR brings together 10 partners with strong expertise in microbiology, including 8 universities and two companies. Its plan is to develop new antibacterial agents against antibiotic-resistant Staphylococcus aureus. It exploits a discovery made by Prof. Cécile Oury’s team for a new use of the antiplatelet drug ticagrelor for the prevention and treatment of bacterial infections. More specifically, the aim is to gain a better understanding of the mode of action of ticagrelor and to develop new molecules derived from it as new antibiotic and antimicrobial candidates.
To lead the transformation of medical device safety
The CM4CURE team has been built on complementary and multidisciplinary knowledge and skills. It uniquely combines expertise in clinical practice in cardiology, and research in cardiovascular sciences and polymer chemistry. The company currently employs 9 staff, including PhDs in chemistry, biology


and biomedical engineering for developing the coating technology, the coating process and testing biological performance of coated devices. In the field of intellectual property, the company continues to file additional patents and trademarks to expand its intellectual property portfolio.
On April 1, 2024, CMD-COAT and FRESCI (our chosen business strategy partner), were proud to announce the launch of Coati-X, a groundbreaking project funded by the European Innovation Council. In the framework of the Coati-X project, CM4CURE and FRESCI aim to accelerate the development and validation of the COATI-X® coating technology, bringing this innovative solution to market readiness.
The first application of COATI-X® will focus on central lines and peripheral access venous catheters, which are commonly used in medical practice and associated with high risks of infection and thrombosis. CMD-COAT is currently in partnership with the largest global manufacturer of venous catheters to execute a rigorous joint testing plan, partner on an FDA approach and access commercial production considerations. This may lead to a full commercial collaboration for the launch of a new generation of COATI-X ® coated catheters.
COATI-X® possesses 4 key technical features. Anti-Thrombotic: it prevents blood clots from forming on the device surface, reducing the risk of thrombosis. Anti-Microbial: it provides effective protection against a wide range of harmful microorganisms, preventing infections. Environment-friendly: it utilizes a water-based, non-toxic formulation that does not degrade the medical device material. Biocompatibility: it ensures compatibility with human tissues, minimizing adverse reactions and ensuring safe integration with the body. In addition, COATI-X® employs a unique layer-by-layer assembly of cross-linked nanogels that can be loaded with anti-thrombotic drugs and antibiotics. This innovative design allows for controlled, localized release of bioactive agents, significantly enhancing the device’s performance and durability. The nanoreservoir created by these nanogels can entrap multiple bioactive molecules, combining several biological activities in a single coating. This technology is adaptable to various biomaterials, including metallic, biological, and polymeric surfaces.

©

Beyond venous catheters, CM4CURE is currently targeting other catheter markets, e.g., urinary catheters hemodialysis catheters and implantable ports. In the longer term, any type of medical device to which its technology could be effectively applied such asheart valve prostheses, either mechanical or biological, or even breast implants will be candidates with the aim to improve their durability and safety. Targeting implantable ports and breast implants, CM4CURE will definitely play a major role in improving cancer patient’s care.
Given that 50% of hospital-acquired infections are caused by medical devices, there is an urgent need to develop an anti-infectious coating that discourages the emergence of new bacterial resistances. Preventing thrombosis of devices in contact with blood is key to improving their durability but simultaneously reduces the likelihood of infection risks.
Reassured with these promising achievements and secure prospects, CM4CURE is preparing its next round of funding for the first half of 2025. Additional funding will enable it to develop new applications for its coating technology, as well as new pharmaceutical compositions.
This extension of its field of action is the reason behind its name change to CM4CURE. The CMD-COAT brand has been retained, continuing to target its original purpose: to offer a technology suitable for all types of medical device, with applications targeting the risks of infection and thrombosis. Don’t change a winning formula !

CM4Cure
11, avenue de l’Hôpital B-4000 Liège
Tel.: +32 (0)4 378 88 64
Email: cecile.oury@cmd-coat.com https://cm4cure.com/ https://coati-x-cmd-coat.com/

Part of the ARCh research unit (Analysis of adaptation, resilience and change processes for clinical and societal applications) at the Université de Liège, the Clinical Psychology of Delinquency (PsyCrim) department is headed by Prof. Fabienne Glowacz. It develops its research, teaching and clinical activities with a view to integrating scientific knowledge and field practice.
The first area of research is criminological psychology, focusing on the analysis of developmental processes leading to the emergence of interpersonal violence (intra-family violence, domestic violence, maltreatment and sexual abuse, juvenile delinquency, sexual delinquency, homicide, female criminality, terrorism, etc.).
Desistance


The processes of desistance and resilience are particularly studied in order to integrate them into psycho-legal and social interventions. The department offers psycho-legal assessments and psychological follow-up. A number of studies on the desistance process have been carried out with various populations: juvenile offenders, sexual offenders (Glowacz, F., Puglia, R., & Devillers, B. (2020). Minors in court for sexual offences: support for desistance through the Good Lives Model. Criminologie, 53(1), 127-149, Puglia, R., & Glowacz, F. (2021). Understanding the desistance trajectory of juvenile offenders: A case study. Revue québécoise de psychologie, 42(2), 193-217.), minors who have participated in terrorist activities (Glowacz, F. (2020). Récits de désistance de jeunes radicalisés et impliqués dans des activités de groupes terroristes. Criminologie, 53(1), 281-304.) and perpetrators of domestic violence (Dziewa, A., & Glowacz, F. (2024). From violence to desistance: a qualitative analysis of intimate partner violence perpetrators’ narratives. Current Psychology, 43(11), 10292-10305.) Doctoral student Lucie Pelz won an award for her dissertation entitled ‘Processus de désistance, quelle place pour la religion et la spiritualité?’ Produced under Prof. Glowacz’s supervision, it won the Prix de la thèse 2022 awarded by the General administration of the houses of justice of the Fédération Wallonie Bruxelles (Wallonia-Brussels Federation).
Prof. Glowacz is also supervising several joint theses on street children and juvenile delinquents in Haiti, Burundi and the DRC, in the context of developing countries.
Another subject with far-reaching societal implications: ‘Regards croisés sur la violence entre partenaires intimes. A propos des résultats de la recherche ‘Violences entre partenaires: impact, processus, évolution et politiques publiques’ (IPVPRO&POL)’, Editions Politeia, Brussels, 2022. This study was carried out by an interdisciplinary and inter-university research team, including researcher Amandine Dziewa from the PsyCrim department, with Fabienne Glowacz, Catherine Fallon and Charlotte Vanneste as promoters. This inter-university research was developed and funded by BELSPO (Federal Science Policy) as part of the BRAIN.BE project. Its aim was twofold: to understand the phenomenon of domestic violence from the point of view of its impact and the underlying processes, as well as the public policies developed in this area. It involved 3 partners: the Institut National de Criminalistique et de Criminologie (promoter: Charlotte Vanneste), the Vrije Universiteit Brussel (promoters: Gily Coene and Sophie Withaeckx) and the Université Catholique de Louvain (promoters: Xavier Rousseaux and Thierry Eggerickx). This work was carried out using a multi-sectoral approach: medical, psychosocial and legal. In conclusion, the authors recommend an ecosystemic approach to ending partner violence. A second study on partner violence during and after the COVID pandemic crisis, funded by BELSPO and coordinated by Prof. Glowacz (IPV DACOVID conducted from 2021 to 2023), assessed the changes and evolution of public policies and actions involving multiple areas and players: police, justice, health and associations, during and after the Covid-19 crisis, but also the impact of the Covid-19 crisis on the dynamics of violence (emergence, exacerbation of existing violence), forms of violence (bidirectional, intimate terrorism) and exits from violence. Authors: Fabienne Glowacz (ULiège) (Editor), Catherine Fallon (ULiège), Charlotte Vanneste (INCC & ULiège), Gily Coene (VUB), Amandine Dziewa (ULiège), Aline Thiry (ULiège), Luce Lebrun (ULiège), Kaat Poels (VUB).


Violence between intimate partners is at the heart of current research and doctoral theses. Anthony Depireux (Depireux, A., & Glowacz, F., Intimate Partner Sexual Violence in Emerging Adulthood; Exploring Sexual Consent Attitudes as a Target for Sexual Coercion Prevention. Archives of Sexual Behavior, 1-22.) is looking more specifically at sexuel coercion within relationships, Nell Oger at the impact of children’s exposure to domestic violence and Amandine Dziewa (PhD) is continuing her work on the discharge and care processes for perpetrators of domestic violence.
Close collaboration has been developed with research teams in Quebec (RAIV - Recherches Appliquées et Interdisciplinaires sur les Violences Intimes, Familiales et Structurelles) and more specifically with Prof. Geneviève Lessard (Université de Laval), Audrey Brassard (Université de Sherbrooke), Valérie Roy (Université de Laval) and CRIPCAS. Prof. Glowacz gave a lecture and presented her work on violence against women on 6 December 2024 in Montreal, the day of the commemoration of the 35th anniversary of the shooting that killed 14 women at the Ecole Polytechnique de Montréal. Collaborations with numerous practitioners working with perpetrators and victims of intimate partner violence and domestic violence support collaborative research with services such as PRAXIS supporting perpetrators, or multi-sectoral projects with police and psycho-social services such as the SECOVA project (STOPP VIF - field services working to prevent and deal with domestic violence).
BEHAVES: Well-being, harassment, sexist and sexual violence in higher education
The BEHAVES study (Bien-être Harcèlement et Violences en Enseignement Supérieur - Wellbeing, Harassment and Violence in Higher Education), directed by Prof. Glowacz, was funded by the Fédération Wallonie Bruxelles (FWB). Its aim was to take stock of situations of harassment and violence in full-service higher education establishments (EES): universities, colleges of higher education and higher arts schools recognised by the French Community. It looked at discrimination and all forms of harassment and violence, whether moral, sexist, sexual or discriminatory, between all persons affiliated to an institution of higher education, whether students or members of
academic, scientific, administrative or technical staff, whether on campus, off campus or online. The BEHAVES study, conducted from December 2022 to December 2023, is based on a mixed sequential methodology (quantitative and qualitative). An extensive online survey of students and staff at the FWB’s 41 higher education institutions (HEIs) was launched on 15 February 2023. Its aim was to assess perceptions of the institutional climate, the prevalence of violence, the context in which it occurs, disclosure and follow-up of such situations, as well as knowledge of existing mechanisms and proposals for prevention. A more qualitative approach was adopted to complement the quantitative survey data, with focus groups for male and female students, and a Delphi survey, which asked a panel of experts and key stakeholders in HEIs to make recommendations in this area. A major research report was published in March 2024 (Glowacz, F., Fallon, C., Babic, A., Thiry, A., Goblet, M., Dardenne, B., Huynen, R., Simon, J. (2024), ‘Behaves Research Report “Wellbeing, Harassment and Violence in Higher Education in FWB”.
In collaboration with the KULeuven, PsyCrim has conducted cutting-edge research into front-line psychological care in Belgium. This work resulted in the publication of a bilingual French-Dutch book: ‘La psychologie de première ligne en Belgique - Eerstelijnspsychologische Zorg in België’ by Dr Leontien Jansen, Prof. Fabienne Glowacz and Prof. Ronny Bruffaerts, Academic & Scientific Publishers, 2024. The book includes a scientific assessment and recommendations for sustainable integration into the Belgian healthcare system. Three research questions are addressed: (1) what specific patient profiles are admitted to primary psychological care; (2) what is the place of the contract psychologist/orthopedagogue in the organisation of care, i.e. the network; and (3) what proposals can be formulated, on the basis of the study, to provide a sustainable policy framework for primary psychological care in Belgium?
In particular, the characteristics of treatment trajectories in conventional primary psychological care are studied using baseline data as well as longitudinal data at 3 and 6 months after the start of treatment. In addition, the qualitative part of this study made it possible to formulate four essential conditions for viable working models for referral to effective treatment: (1) clarifying the role of primary/front-line psychological care; (2) establishing viable partnerships between networks; (3) reviewing the purpose and function of functional assessment; and (4) guaranteeing the quality of treatment within the framework of the agreement. All in all, the scientific data accumulated as part of the EPCAP project clearly show that, with almost 150,000 patients treated annually, the framework of the primary psychological care agreement is in the process of being socially validated.
The ultimate aim is to create a new intervention framework for psychologists that values early intervention, with satisfactory levels of accessibility and proximity for patients, as well as a highly valued - and appreciated - community dimension. A new research project (EPCAP3) will continue the evaluation of new front-line psychology practices.
Pre Fabienne GLOWACZ
Service psychologie clinique de la délinquance (PsyCrim) - ARCh - ULiège
Bât. B33 - Quartier Agora
Place des Orateurs 1 - B-4000 Liège
Tel.: +32 (0)4 366 22 71
Email : Fabienne.Glowacz@uliege.be www.psycrim.uliege.be


Created on 15 September 2021, RUCHE is an interfaculty structure gathering a team of researchers who take complementary views on individuals health and education at all stages of life. Embracing domains such as e-health, speech therapy, physical activity promotion, or educational sciences, this multidisciplinary team adopts a holistic approach to individuals, whether their development is typical or atypical, in various contexts.

Virtualreality (VR), mobile applications, high performance tools and know-how for treating, optimizing, promoting oral communication, physical activities, mental health, and supporting childhood and families. Many different care methods for different populations. RUCHE is well aware of this: with 79 members including PhD students, academics, assistants and clinicians, this research unit specializes in technological innovations for health and education at all stages of life. They stand out in particular by the following projects. In the voice and speech domain, the VirtuVox project gave rise to a virtual classroom to train teachers’ oral communication skills, whereas the Speak in VR project aims to design a virtual environment to improve public speaking. Together with health psychologists, the potential of VR to encourage trans people using their harmonized voices in their daily life is explored. In the health domain, some researchers assess VR biofeedback-assisted relaxation in the management of pediatric headaches or its usefulness in adults’ emotional regulation. Another project aspires to individualize functional management of post-intensive care syndrome using biomarkers. In addition, an important area of research concerns the early childhood (e.g., children’s motor behaviour) and childcare professionals’ perception on gender issues in an intercultural context. A series of experimental protocols focus on marital and family relationships (with mixed protocols combining large-scale quantitative and qualitative research).
Finally, the research unit advocates a physically active and healthy life style through research conducted in the field of Movement Sciences. Employing concepts such as physical literacy in educational or paramedical contexts, the physical care of healthy or chronically ill participants, at every stage of life, is optimized. Some research is conducted in a cross-disciplinary approach. For example, a project aims at reducing pre-competitive anxiety in athletes by immersing them in a relaxing VR environment. Psychology, Sports Sciences, and new technologies are thus combined to benefit the performance of athletes.
In April 2024, RUCHE organized its first congress - ‘Health and education at all ages of life. Transdisciplinary approaches to quality of life’-, proving its ability to bring together researchers from different fields around a unifying theme and to place its work within a broader human and societal framework. This is the whole point of the ‘one health’ concept, which makes it possible to reflect on the impact of the methodology used. Which methodology is the most environmentally-friendly possible and the most effective? Not forgetting the context in which the patient is evolving and the integration of Evidence-based practice into clinical practice.Through its various activities, RUCHE is following a common thread: enabling everyone to find the resources they need to cope with their difficulties and improve their quality of life, taking account of an eminently complex framework by bringing together a range of expertise to map out therapeutic pathways that are better adapted to the needs of patients and users. There are a number of challenges to be met: getting e-technologies recognised in care plans, improving how carers take account of the values and preferences of any people considering their diversity.



ULiège - Rue de l’Aunaie, 30 (B38) - B-4000 Liège - Sart Tilman
Tel.: +32 (0)4 366 51 76
Email: dominique.morsomme@uliege.be www.ruche.uliege.be

Founded in the early 1990s and taken over in October 2018 by Prof. Gauthier Eppe, the MSLab, with its forty or so members, is Belgium’s largest mass spectrometry platform for fundamental research, development and analytical technologies.
The group is made of mainly chemists, bio-chemists, pharmacists, computer scientists, engineers and about 20 PhD students to cover the required expertise in instrumental developments, in sophisticated hyphenation in separation techniques with MS, in physical-chemistry of ions in gas phase, in development of new concept in analytical chemistry and omics methods. The MSLab structures its activities on five main areas: MSLab-Analytics (analytical strategies to monitor emerging contaminants); MSLab-Biology (understand the properties of animal venom toxins); MSLab-Fundamentals (understand physico-chemical properties of ions in liquid and gas phases); MSLab-Vib (vibrational spectroscopy, infrared and Raman); MSLab-Omics (Single cell proteomics, spatial omics and metabolomics). On a cross-disciplinary basis, the laboratory is developing molecular mass spectrometry imaging to obtain spatial information for characterization techniques (brain slices, biological tissues, bacterial chemical communication, etc.). To do this, it uses an exceptional array of the latest technologies and prototypes to develop innovative analytical chemistry workflows. This is a major asset in meeting current and future analytical challenges in the fields of the environment, food safety, biotechnology, materials science and physical chemistry.


More specifically, G. Eppe developed skills in accurate trace analysis by MS, in ion mobility-mass spectrometry hyphenated with GC and LC, with a particular emphasis on non-targeted analysis in the field of ultra-trace analysis of environmental contaminants entering the food chain (food safety). New topics such as collision induced unfolding (CIU) for high order structural characterization of biomolecules and in developing new supports (SALDI and LDI) for mass spectrometry imaging have led to several significant publications in this field. He is also director of the Centre for Analytical Research and Technology (CART), an ISO 17025-accredited analytical platform recognised as Belgium’s national reference laboratory for halogenated persistent organic pollutants (POPs) and food process contaminants.
The MSLab applies its expertise to numerous projects at regional, federal, European and international level. At regional level, it is contributing to the FoodWal project (www.foodwal.be) by coordinating the PeptiBoost project, a project which is developing breakthrough methodological, technological, scientific and digital innovations in response to the issues and challenges facing Walloon companies involved in the production of functional foods and, more specifically, bioactive peptides, prebiotics and probiotics. G. Eppe is also coordinating
the PHENIX project (Plateformes tecHnologiques et aNalytIques d’eXcellence wallonne en agro-alimentaire) a structuring, multidisciplinary project to group together analytical platforms and technology platforms in the Walloon region in the field of agri-food and innovative biotechnologies. These two pillar projects are part of the FoodBooster IIS (www.foobooster.org) where the objective is to make Wallonia, a hub for prebiotics, probiotics and bioactive peptides. The aim is two-fold: to bring high added value to biomass, thereby reinforcing circularity through the use of co-products as raw materials, and to develop a critical mass of players in Wallonia covering the entire value chain. This strategic innovation initiative is managed in close collaboration with the accredited research center CER groupe in Marloie, Dr N. Gillard.
Beyond Belgium’s borders, MSLab participated in the European FT-ICR-MS network, dedicated to large mass spectrometry instruments (Horizon 2020 program). It is also taking part in Horizon Europe and Interreg projects. And that’s not all: it works closely with the University of North Carolina in the United States on the timely issue of PFAS. Other collaborations, this time in the field of teaching, include a doctoral student exchange program with Vietnam and involvement in an international master’s degree at the University of Ho Chi Minh City in environmental science and management - a course set up in 2011 and which has proved to be a long-lasting success. Fundamental research, support for business innovation, mentoring for future researchers: mass spectrometry has a bright future ahead of it!

University of Liège
Institut de Chimie, Bat. B6c B-4000 Liège (Sart Tilman)
Tel.: +32 (0)4 366 34 22 - Email : g.eppe@uliege.be https://www.mslab.uliege.be/cms/c_6417994/en/ mass-spectrometry-laboratory


As an integral part of CESAM (Complex and Entangled Systems from Atoms to Materials) research unit and of the department of chemistry of the University of Liège, the CERM develops proven expertise thanks to its academic strength in the development of biodegradable, bio- and CO2 sourced materials answering the actual challenges of personalized medicine and eco-conception.



As an international team of chemists, CERM is active in fundamental and applied researches focusing on the development of innovative polymers for biomedical and healthcare applications and eco-strategies of polymer synthesis contributing to a safer environment.
It specializes in the synthesis of polymer materials along two main lines: the development of innovative biodegradable materials (ring-opening polymerization, step-growth polymerization) and sustainable polymerization processes. CERM also owns a unique platform (FRITCO2T) in Europe that is dedicated to the transformation/valorization of carbon dioxide into low carbon footprint materials (coatings, adhesives, foams and biomaterials).
The CERM enjoys a wide range of research partnerships, starting at European level with the INTERREG IN FLOW project (flow formulations of biodegradable materials for food, biomedical and healthcare applications). It is also very active in the field of medical devices. In this context, it recently participat-

ed in the ERC “PV-Coat” European project on the coating of heart valves and in the INTERREG PolyValve project targeting the development of new materials for heart valves leading to the creation of CMD-Coat SME.
CERM is also involved in MSCA European Join Doctorate networks, such as EJD NIPU and D-Carbonize. The first one deals with the development of new chemistries to prepare non-isocyanate polyurethanes (NIPUs) from carbon dioxide for the production of low carbon footprint and recyclable foams, coatings, adhesives and 3D printing inks. The second one has the ambition to merge the carbon dioxide chemistry with bio-based products for the next generation of greener, circular polymer materials.
CERM is also involved in the FEDER project UP-PLASTICS for the development of NIPU foams for the construction sector (sound and thermal insulation), and a WEL-T Advanced Grant project financed by the WEL Research Institute for

developing new strategies for producing recyclable self-blown NIPU foams from room temperature formulations.
The CERM can capitalize on important industrial partnerships with Solvay, Solvin, ArcelorMittal, Saint-Gobain, UCB, Dupont, Bayer, and recently Chanel, so as a great number of SMEs. Particularly, the CERM co-conceived a patent intended for the development of a biomedical implant eluting a contraceptive agent (the patent is being exploited by Mithra), it ensured the preparation of one of the components of intraocular yellow lenses produced by BVI (previously PhysIOL), develops new hydrogel-based medical devices and elaborates new trends for future products on the basis of patents against royalties. Incidentally, the CERM initiated startups such as EyeD Pharma based on the development of drug-eluting implants for ocular pathologies.
CERM patented the various facile, up scalable production modes of recyclable self-blown non-isocyanate polyurethane foams, as well as their related products, with the ultimate objective to bring the technology/products to the market in collaboration with industrial partners.
The CERM currently remains involved in many collaborative research projects related to the implementation of biomaterials which have already passed clinical tests, as well as the development of new processing methods such as electrospinning and 3D printing to design scaffolds stimulating cellular regeneration or various medical implants. Finally, the CERM goes into greater depth on the green technology of supercritical CO2 to design sterile medical devices (suture threads or implants) with anti-inflammatory properties.



Doubtless, the CERM stands well equipped and ready to address the five major challenges which confront it, from developing synthesis techniques to implementing greener processes (organocatalysts, solvent-free processes, chemical reactions based on atom economy), to help advanced chemistry, and develop recyclable polymer materials as foams or multifunctional coatings with aqueous processes or without solvents, or develop competitive biomaterials.
CERM, with its unique expertise in polymer chemistry, its state-of-the-art equipment for polymer characterization, processing and formulation, and its CO2 valorization platform, is a partner of choice for boosting the competitiveness of companies active in the healthcare and biomedical sectors, and for supporting companies in the ecological transition. Its CO2 platform enables to produce kilograms of products needed to realize prototypes to be tested by industrial partners.

Center for Education and Research on Macromolecules (CERM)
Université de Liège (ULiège)
Institut de Chimie (B6a)
Agora, Allée du 6 Août, 13 - B-4000 Liège
Tel: +32 (0)4 366 34 91
Email: c.jerome@uliege.be http://www.cerm.ulg.ac.be/


Created in 2016, the Chemical Engineering Research Unit comprises 80 members including 7 academics, 5 permanent scientists, 20 postdoc or senior researchers and more than 40 PhD students. Chemical engineering and process engineering are applied to design sustainable processes for transforming material, energy, microorganisms and living cells.


With an annual operational budget of € 4-5 million (with 50% coming from public research contracts and 17% from services provided to manufacturers), the Chemical Engineering Research Unit relies on its 2 founding groups (NCENanomaterials, Catalysis, Electrochemistry -, and PEPs - Products, Environment and Processes) to carry out its work around 4 main themes: energy, the environment and natural resources, engineering innovative materials, and health. These research activities are further supported by the CARPORVISU platform, specifically dedicated to the Multi-scale Characterization and Visualisation of Porous Media. CARPORVISU offers researchers from both academia and industries a panel of complementary techniques allowing for the characterization of materials porosity from the nanometer to the millimeter scale (gas adsorption, mercury intrusion porosimetry, gas pycnometry), evaluating thermophysical properties (thermogravimetry-differential scanning calorimetry) and humidity behavior (moisture analysis and dynamic water vapor sorption), as well as the visualization of materials with different techniques such as tomography, Particle Image Velocimetry, Planar Laser Induced Fluorescence...
The Chemical Engineering Research Unit is very active in the field of environmental transition as demonstrated by the FRITCO 2T (Federation of Researchers in Innovative Technologies for CO2 Transformation)
Platform: four research laboratories at ULiege joined their forces to accelerate the development of new technologies/products enabling the capture and re-use of emissions. In addition, the PROCURA project (Power to X and Carbon Capture & Utilization Roadmap for Belgium), a Belgian Energy Transition Fund project implying 6 Belgian partners, relies on the ULiege to evaluate the potential for CO2 capture in Belgium and draw a roadmap for this purpose. CO2 and H2 technologies are also dealt with in the TRILATE project: this project from the Belgian Energy Transition Fund targets an integrated analysis of energy infrastructure at industrial clusters level. The team is also active in several projects related to the Resiliency and Recovery Fund of the European Green Deal: Saturn (study of CO2 capture technologies in a consortium with 4 major Belgian industrial players), and NKL (study of CO 2 conversion towards e-kerosene, with a special focus on the reverse water-gas shift reaction). Significant experimental equipment for CO2 capture and re-use is also under development, funded by the Walloon-Brussels Federation Resiliency and Recovery Fund. This equipment concerns CO2 capture by absorption in amines (capture of 1 ton/day) in the fumes of biomass cogeneration, and the conversion of CO2 into e-kerosene in order to meet the growing demand for e-fuels imposed by the European Union on the aviation sector (0.7% in 2030, 28% in 2050).


With its expertise in (bio)reactors design, the Chemical Engineering Research Unit brings its expertise to the design of new bioreactors for the large-scale culture of stem cells for therapeutic applications in the frame of some collaboration with industries like GSK and Silox.
The Chemical Engineering Research Unit is involved in (photo) catalysts and inorganic (nano)structures development and use. The PhotoTex2 project (WIN2WAL Programme of the Walloon Region) deals with the development of textile films with permanent antimicrobial properties by grafting ZnO-based photocatalysts for the manufacture of uniforms and protective textiles in hospitals. Furthermore, the Walloon project Win2Collective MICROECOTEX aims to produce antimicrobial textiles and coatings for medical (treatment of burns and wounds) and agri-food (food preservation) applications. These textiles and coatings are developed from a silica-alginate composite which will contain polylysin, an antimicrobial agent of natural origin, which will be released in a controlled and sustainable manner over several days/weeks. The team is also part of the new GreenWin projects MultiO “Functional and modular swimming pools for optimized management of water and energy in the sustainable habitat of tomorrow” and DELFICAR “Biocid filter with managed CO2 capture”. The project MultiO targets an innovative system that will allow the safe reuse of treated wastewater and rainwater in residential uses (including that of the swimming pools). In this project, the Chemical Engineering Research Unit will develop an electro(-photo)chemical unit for the degradation of pollutants, and the disinfection of rain waters. The project DELFICAR aims to create filters for air handling units which will integrate several functions (biocide and CO2 management) to improve indoor air quality.
In the field of development of microbatteries, the Chemical Engineering Research Unit is active in different projects like M-Era. net PLASMANODE “Plasma-modified powder materials for Li-ion battery anodes processable by water-based techniques” at the European level, and in the regional project Win4Doc CATHOPLASM “Plasma treatment of materials for the manufacture of positive electrodes of Li-ion batteries by environmentally friendly processes”.
More recently, the Chemical Engineering Research Unit has been selected to participate in three major research projects of the European program Horizon Europe (Sustainable, Secure and Competitive energy supply). For these projects focusing on photovoltaics (PV), the Research Unit will deal with aspects related to eco-design and the analysis of the life cycle of materials implemented in this field with the aim to

develop a sustainable, secure and competitive energy supply and alternative, innovative photovoltaic technologies. These projects are called PILATUS, PEPPERONI and VALHALLA.
Another hot topic concerns the reduction of the environmental impact in the building sector, either by promoting recycling of demolition waste or by finding alternative materials during the production of cement or concrete. The Chemical Engineering Research Unit is in charge of the environmental aspects of several projects in this field, applying Life Cycle Assessment (LCA) in an eco-design approach (REMIND « Reverse MINeral INDustry in Wallonia » in the Walloon recovery plan; Greenwin projects“Geoslags: Formulation of mineral foams” and “Recob2: Formulation of recycled plaster panels”; Win4collective project “Sare4Be: Valorisation of sand from recycling in concrete”.
In the new project CISTEMEEC, part of the Reverse Metallurgy+ portfolio deposited by the Reverse Metallurgy platform as part of a call launched by the Walloon Government for the implementation of the Circular Wallonia strategy, the Chemical Engineering Research Unit, in partnership with two other laboratories from the University of Liege (GeMMe and GREEnMat), operates in the Li-ion battery recycling sector. Currently these batteries are collected and sold at negative cost to processing centers outside the Walloon Region. Also, this project works in the copper sector, and in the chain of rare earth elements contained in the permanent magnets of electric motors and lost in the flow of scrap metal reaching the steel industry. The team is also part of Phos4You, a North West Europe (NWE) INTERREG project, during which the PULSE pilot for phosphorus recovery in wastewater sludge was designed.


Quartier Agora - Allée du 6 Août 11, B6
B-4000 Liège (Sart Tilman)
Tel.: +32 (0)4 366 44 36
E-mail: secretary.chemeng@uliege.be
https://www.chemeng.uliege.be/cms/c_2275100/fr/ chemical-engineering-portail
CARPOR Platform - UR Chemical Engineering - ULiège
https://www.carpor.uliege.be/cms/c_14238965/fr/carpor


The ULiège Laboratory of Medical Chemistry team currently comprises 8 researchers (PhD students and post-docs) from China, Ukraine, France, Morocco and Belgium. It is directed by Prof. Alain Chariot who also supervised PhD thesis of some former students who since established their own laboratories. As a result, the network in which the Laboratory of Medical Chemistry is currently working includes 4 Principal Investigators and a total of 35 collaborators, all essentially dedicated to biomedical research.
The ULiège Laboratory of Medical Chemistry is funded by the WELBIO (now the WEL Research Institute), the FNRS, TELEVIE and the Belgian Foundation against Cancer. It is also supported by fundings from both the University of Liège and the Léon Frédéricq Foundation (Faculty of Medicine). All this financial support, which reaches more than half a million euros a year, helps to cover researchers’ salaries as well as both operating and equipment costs of the laboratory.

The Medical Chemistry and Medical Oncology Laboratory was run by Profs Jacques Gielen and Vincent Bours with Dr Marie-Paule Merville until 2004. Following Jacques Gielen’s sudden death and the creation of the GIGA, the team moved to a new tower. Since 2007, Prof. Chariot has been in charge of the GIGA’s Medical Chemistry Laboratory.
The laboratory has developed expertise in the dissection of molecular and cellular mechanisms underlying tumour development, primarily in the intestine. To do this, the team combines multiple experimental approaches, including murine models that mimic tumour development in Homo Sapiens as closely as possible. Its researchers are also interested in the molecular mechanisms through which patients develop resistance to anti-cancer treatments. Finally, they are also generating ex-vivo ‘mini-guts’ which they use as experimental models to better understand how intestinal epithelial cells differentiate from stem cells.

One project in the Medical Chemistry laboratory explores the role of Elp3 in cancer. This candidate regulates the production of proteins from RNAs and has been shown to play an essential role in the development of intestinal tumours. The researchers are now exploring the extent to which Elp3 is also involved in the development of liver tumours.
More recently, the laboratory’s researchers have also been looking at the role of Elp3 in the differentiation of adipocytes, the cells that store fat. It turns out that Elp3 is also involved in this process. We are all aware of the link between obesity and cancer, and taking an interest in Elp3 also enables researchers to better understand why being overweight is a risk factor in tumour development. Elp3 is part of a large family of enzymes that chemically modify some RNAs: the Medical Chemistry laboratory is starting to address the roles of other members in cancer as well.
These projects focus on ‘translational reprogramming’ occuring in cancer cells, i.e. the way these cancer cells express the right cocktail of proteins to ensure tumour development. Beside Elp3, researchers in the Medical Chemistry laboratory are looking at another protein, Lepre-1, whose expression increases in many human tumours and which modifies collagen. Understanding how Lepre-1 regulates tumour development is a project currently supported by the WEL Research Institute.
Most of the laboratory’s work focuses on gaining a better understanding of tumour development in the intestine. Its researchers are identifying new players involved in cancer and determining to what extent these players could be defined as new therapeutic targets. More specifically, they are looking at candidates that control the production of proteins in cancer cells, enabling them to proliferate more, survive longer and, in some cases, become invasive and ultimately generate metastasis. They are also studying proteins that are essential to the immune response to infections, bearing in mind that these same proteins can contribute to tumour development when constitutively active.
The latest publication from the Medical Chemistry laboratory focuses on elucidating the role of Elp3 in intestinal tuft cell differentiation. These rare cells are essential for the immune response triggered by parasitic infections in the intestine. Researchers demonstrated that Elp3 is not only important for tumour development in the intestine, but is also essential for the immune response against intestinal parasites by ensuring proper production of tuft cells.


Another publication focused on elucidating mechanisms by which oestrogens induce the proliferation of mammary epithelial cells and contribute to the development of breast tumours. The team identified a protein, COP1, as a new player required for the proliferation of mammary epithelial cells. Researchers have also shown that this same COP1 protein can also limit the invasiveness of cancer cells. COP1 therefore has a dual role: it promotes breast cancer cell proliferation but limits their invasiveness.
The Medical Chemistry laboratory has many collaborations within the University of Liège with its expert colleagues in Immunology (B. Dewals, C. Desmet) and Neurosciences (L. Nguyen) and of course in Cancerology (P. Close, A. Blomme, F. Rapino, A. Noël). The team also maintains close links with its clinical/ research colleagues at Liège University Hospital (A. De Roover, P. Delvenne and others soon). The Medical Chemistry laboratory also collaborates with the University of Ghent and the VIB (G. van Loo, L. Vereecke), with the ULB (F. Fuks) and the UCLouvain (P. Cani). Its researchers still have very close contacts with certain colleagues at the KUL (J-C. Marine, for example). Internationally, the Medical Chemistry laboratory collaborates with the University Hospital of Cologne (R. Buettner) and with the University of Luxembourg (E. Letellier). Finally, it maintains close contacts with former doctoral students who have now set up their laboratories abroad (P. Viatour in Philadelphia and M. Bentires-Alj in Basel).
A twofold challenge
Researchers in the Medical Chemistry Laboratory are currently faced with two major research challenges: firstly, to gain a better understanding of how many proteins with little-known biological functions contribute to tumour development. They also want to contribute to a better understanding of resistance to targeted therapies. Why do patients develop this resistance? How can they be circumvented? What therapeutic combinations should be proposed to ensure prolonged tumour regression? These are all crucial questions that will improve patient well-being.




Laboratory of Medical Chemistry
GIGA - ULiège
CHU - B34
Quartier Hôpital - Avenue de l’Hôpital, 11 - B-4000 Liège
Tel.: +32 (0)4 366 24 72
Email: alain.chariot@uliege.be https://www.gigamedicalchemistry.uliege.be/cms/c_4227926/en/ gigamedchem?id=c_4227926



Founded in 2006, the NanoChem group has 8 PhD students (more to come by the end of 2024), 4 post-docs and 1 senior researcher. Its fundamental research work is supported by 7 customized atomic force microscopy facilities and one optical tweezer. A rarity for this research group, which has a total of 7 ongoing projects.
Physical chemists, organic chemists, physicists, biophysicists and engineers: the NanoChem group team is resolutely multidisciplinary. Its annual budget is funded entirely by programmes of fundamental research run by the FNRS, the European Commission, EOS and ARC. It is one of the few laboratories in the world to use and develop a specific technique: force spectroscopy on a single molecule. The aim? To trap and stretch a molecule using an atomic force microscopy device or optical tweezers in order to probe mechanical forces in real time in a defined medium (a liquid where the environment is controlled, for example). It is even possible to induce chemical reactions and molecular processes, such as changes in the conformation or nature of the bonds involved, movements or the production of forces. NanoChem was the first to succeed in probing small synthetic molecules, as small as 1 nanometer long.
Drawing on this unique expertise, NanoChem is developing four areas of research: molecular recognition (between chemical species or between partners with a view to measuring interaction forces), the mechanics of molecules (following the example of helices in proteins or folds whose properties are being studied), mechanochemistry (study of how mechanical forces and chemistry affect each other) and molecular machines: for the past 15 years, the NanoChem group has been conducting research projects in this last area, with funding from the FNRS and the European Commission (FET-Open and Marie Curie-Skłodowska doctoral networks). The aim is to understand the basic operating mechanisms of synthetic molecular machines (analogous to natural machines such as those governing muscle contractions, ATP synthesis, etc.) and measuring the forces they generate.
The originality of NanoChem’s research has earned it the prestigious International Feynman Prize in Nanotechnology in 2021 and an ERC Advanced Grant for a major 5-year research project in mechanochemistry. The aim of this project is to study the mechanics of basic chemical bonds that have hitherto been known only from a thermodynamic point of view. In the case of molecular stretching, bonds that are strong from a thermodynamic point of view are not necessarily strong from a mechanical point of view, and vice versa. We are therefore witnessing a veritable paradigm shift thanks to mechanochemistry, which is making it possible to study with fresh eyes the influence of the environment and the geometry of molecular bonds on their strength, resistance and even their ability to reform. In the long term, this work should make it possible to design much stronger and more resistant materials. Another possible area of application is biotechnology and medicine.

Our cells are subjected to a great deal of stress in the form of multiple forces, deformations and strains. We therefore need to take greater account of the mechanics of the bonds that underlie their constituent molecules.
The NanoChem group has developed numerous international academic collaborations. The universities of Manchester (United Kingdom), Northwestern (United States), Groningen (Netherlands), Toulouse, Paris, Bordeaux and Strasbourg (France), Bologna (Italy), Madrid (Spain), Munich, Dresden and Aachen (Germany), Graz (Austria) and Fudan in Shanghai (China) regularly call on its expertise. Thanks to single-molecule mechanochemistry, the NanoChem group has access to information that is inaccessible using classical ensemble techniques and can therefore ask and answer new questions about reactions and processes in chemistry. New concepts are emerging to address this disturbing reality: the laws of thermodynamics are no longer valid on a molecular scale. A very promising new field of research!

University of Liège - Quartier Agora
Allée du Six Août 13, B6a (+4)
B-4000 Sart Tilman
Tel.: +32 (0)4 366 34 82
Email : asduwez@uliege.be
https://www.nanochem.uliege.be/ cms/c_9148355/en/nanochem




Could you tell us about your expertise in the field of equine medicine?
As the head of the equine surgery, anaesthesiology, and post-operative care section at the ULiège Faculty of Veterinary Medicine, I spent much of my career treating horses and teaching equine surgery to veterinary students.
Could you tell us about the activities of the Equine Teaching and Clinical Department (DCE)?
In terms of teaching, the Equine Teaching and Clinical Department receives horses on referral for the treatment of serious and severe pathologies requiring surgery most often under general anaesthesia. These include traumas such as wounds, pathologies of the locomotor system and intestinal pathologies such as colic. Colic is a major cause of death in horses and requires an emergency response, as septic shock can lead to death if surgery is not performed. On average, we carry out 150 operations a year for colic alone.
In the field of clinical research, our work aims to gain a better understanding of the triggering factors of these pathologies, and to reduce their consequences and incidence. Our projects focus mainly on myopathy, particularly post-anaesthetic muscle necrosis, the locomotor system (laminitis, orthopaedic pathologies linked to growth in collaboration with the European Horse Centre at Mont-le-Soie in the Ardennes) and osteoarthritis.
Could you give us a few examples of fundamental research projects within the FARAH Unit?
I’m working in particular with a centre specialising in the study of activated forms of oxygen (oxidative stress), generated by violent inflammatory reactions or mitochondrial dysfunction (Center for Oxygen Research and Development). The aim is to understand their roles in myopathies and intestinal pathologies. In fact, it was while taking muscle microbiopsies that we discovered a
new population of stem cells: we are currently studying their secretum, i.e. their mechanism of action, in order to explore their therapeutic potential.
What do you see as the main challenges in improving the clinical and surgical management of equidae?
For me, the main challenge lies in exploiting the university patent filed following the discovery of this new stem cell population and to offer innovative treatments for severe conditions in horses. The patent consists of a minimally invasive sampling method: muscle microbiopsy. This method, which aims to stimulate the production of stem cells, has been licensed exclusively to the Revatis spin-off. Developments in veterinary and human medicine already look promising.


Created in 2014 to exploit a university patent filed the same year by Prof Didier Serteyn of ULiège, the Revatis spin-off benefits from an exclusive operating licence. Its objective: to develop cell therapy products that comply with GMP standards.

The manufacture of drugs is inconceivable in a university environment, so it was necessary to create a GMP-approved production unit for the manufacture of stem cells for clinical batches for the entry into clinical phase of drug candidates, first for veterinary medicine and then for human medicine. The indications selected are pathologies of the locomotor system in horses (tendonitis, osteoarthritis), often linked to excessive effort and training. Torn tendon fibres carry a risk of frequent recurrence. Hence the interest in providing stem cells to promote healing.
Two clinical studies, one for tendonitis and another for osteoarthritis, were conducted over a two-year period on around fifty horses and the data has now been collected. A report is currently being written with a view to applying for marketing authorisation for two cell therapy products. This is a major achievement since the initial patent was filed in 2014, and has been granted in nearly 40 European countries since 2018. In the meantime, the spin-off has filed 4 patents of its own - industrial property that it is working hard to develop.
For Revatis, a major turning point is expected in 2025 with the extension of its field of action to human medicine. Since 2022, the spin-off has been authorised to produce human clinical batches from 40 healthy male and female volunteers of various age groups. Revatis is now looking to develop partnerships with key opinion leaders in human research. Neurology, ophthalmology, cardiology, immunology: the potential therapeutic applications are numerous. And partnerships are an excellent way of reducing the risk associated with investment in research.
Revatis already intends to use the results of preclinical studies in veterinary medicine to obtain authorisation for clinical trials in human

medicine in the field of tendonitis. An agreement has been reached to conduct a phase II trial on sportsmen and women suffering from tendonitis, with the trial due to start in 2025 or 2026.
The spin-off is also keen to expand internationally. It has already entered into three collaborations: with a stem cell production centre in the UK, where autologous therapy products are not considered to be drugs, in the United Arab Emirates and in Australia (with a team from the University of Queensland’s School of Veterinary Science). For Revatis, these collaborations are interesting for three reasons: they generate income linked to the operating licence, they facilitate technology transfer and they allow culture media to be marketed at the same time as cell therapy products according to the standard operating procedure (SOP).
For obvious reasons of sovereignty, Revatis aims to maintain production, intellectual property and research activities in Europe (with numerous collaborations, notably in France). Ultimately, the spin-off is banking on developing a structure for conducting clinical studies, obtaining marketing authorisation and marketing cell therapy products for veterinary and human medicine. Three good reasons to look to the future with confidence.

Revatis
Rue de la Science, 8 - B-6900 Aye
Tel.: +32 (0)84 840 230
Email: info@revatis.com https://revatis.com/en
Specializing in the development and manufacture of advanced industrial laboratory instruments for characterizing powder behavior, Granutools boasts an impressive 3-digit percentage growth and an installed base across 25 countries on 4 different continents.
Providing accurate and reproducible measurement techniques for powders: that’s Granutools’ goal. Founded in 2016 to bridge the gap between complex systems and manual devices, the company offers a range of instruments and services to help industries handle and process powders efficiently.
With numerous customers worldwide, a team of scientists and experts, and numerous research projects in various industries, Granutools has solid expertise in the field of powder flow characterization. This expertise is demonstrated by a series of five complementary instruments. Instruments renowned for their innovative character, high reproducibility, precision and ability to operate independently of the operator. What’s more, Granutools regularly updates its software to adapt to customer feedback and market developments, ensuring that its products remain at the cutting edge of technological innovation.
Granutools therefore offers a set of five instruments - complementary tools that address specific powder analysis challenges. GranuFlow measures powder vertical flow rate, GranuHeap automates angle of repose and static cohesion measurements, GranuDrum evaluates cohesive index and dynamic angle of repose, GranuPack measures tapped density and packing dynamics, while GranuCharge quantifies electrostatic charges before and after powders pass through different materials. In addition to these instruments, Granutools is actively developing software tools to help industry and academia better understand their powders.
Recently, Granutools launched an innovative new measurement of permeability at various consolidation with the GranuPack Permeability. It features a measuring cell specially designed to assess the permeability of powders. The ability of air to pass through a powder is essential in various applications such as silo operations, compression processes and dry powder inhalers. By measuring airflow velocity and pressure drop, the GranuPack Permeability instrument enables powder permeability


to be assessed. This new addition to Granutools’ product range offers a versatile solution for measuring physical parameters related to powder packing dynamics and fluidization.
A great example of collaboration is the one between Granutools and the University of Bolton/Centre for Advanced Manufacturing (CfAM) which represents a significant step in advancing research and industrialization of additive manufacturing (AM). The University of Bolton, with its expertise in AM, is focused on redefining the approach to AM design, characterization, and production. The CfAM acts as a bridge between academic research and industry, offering a wide range of AM capabilities and educational programs. The integration of Granutools’ instruments into their laboratory provides invaluable tools for powder flow characterization, a crucial aspect of AM. Granutools’ instruments enable rapid and cost-effective analysis of powders, aligning with the CfAM’s goal of supporting AM growth and optimizing processes. Granutools’ commitment to similar collaborative endeavors extends across a diverse range of applications, spanning from battery manufacturing to pharmaceutical projects.
Granutools also offers services in its own fully-equipped laboratory. Its team of particle scientists offers customers a comprehensive, discussed and explained analysis of test results. In addition, its experts deliver webinars, courses and training on powder behavior to enhance industry knowledge.
In the last months and years, Granutools has seen a marked increase in demand for powder characterization. Proof, if proof were needed, of the value and relevance of its offerings to the market. Similarly, the strong interest shown by companies involved in energy and battery manufacturing augurs well for future expansion. All the more reason to be optimistic for Granutools, a resolutely agile company, on the lookout for market dynamics and emerging opportunities. A company confident in its solution. And rightly so!

Rue Jean Lambert Defrêne 107B-4340 Awans
Tel.: +32 (0)4 384 00 74
Email: info@granutools.com
https://www.granutools.com/en/

Created in 2000, GRASP brings together some twenty researchers, including five senior researchers, in a rapidly expanding field of research: soft matter. Each year, it publishes about ten scientific articles in high-impact journals and has about fifteen ongoing research projects.
They are said to be fragile, elastic, flowing, and can fracture or fragment: these representatives of soft matter are the subject of a recent field of research initiated by Nobel Prize winner Pierre-Gilles de Gennes. Unlike hard matter, which is at the origin of the development of electronics and micro-computing, soft matter is characterized by its elasticity and flow properties, with numerous potential medical applications: flexible sensors embedded in patches to take a patient’s temperature or programme the injection of Medicines at regular intervals, implants, surgical micro- or nanobots, etc.
GRASP participated in the PowderReg project (Interreg Grande Région Sarre - Lorraine - Luxembourg - Wallonie): completed in 2022, this project led to the development of an industrial demonstrator at the University of Nancy to study the physical properties of powders whose flow modalities, which vary greatly depending on the material, have major consequences for industry. This is the case for the pharmaceutical industry, where the challenge is to guarantee an optimal mixture between the 98% of lactose and the 2% of powdered active principle found in capsules. This is also true for the agricultural sector, where the study aimed to improve the flow and transport of grains. Ultimately, 80% of materials and finished products are at some point in powder form in all industries. Moreover, 10% of the world’s energy consumption is linked to the transport, processing and handling of grains (concrete, deposits, etc.). This shows the importance of optimising industrial processes to reduce their energy consumption.

Another project benefits from GRASP’s knowhow: Spacegrains. Funded by ESA, this project is dedicated to research on powders and grains in the context of future expeditions to the moon and Mars. Lunar soil, composed of regolith (a combination of grains and dust), generates a sticky, cohesive and abrasive powder that gets stuck to astronauts’ equipment and suitswith the risk of lung problems that this entails. And the Martian soil is just as dusty. It is therefore important to understand the behaviour of grains and dust in a low-gravity environment. This should eventually facilitate the exploitation of the mining resources of iron asteroids, which are rich in rare earths. An experiment will be conducted on board the International Space Station in 2026 to better understand how to handle granular materials in the absence of gravity.
GRASP’s expertise has led to the invention of instruments for characterising soft matter. This invention led to the creation of the Granutools spin-off in 2015, with the aim of valorising these instruments in the agri-food and pharmaceutical industries. The spin-off, which has 20 employees, has convinced Nestlé, UCB and BASF to use its instruments. This dynamism has been rewarded by the Deloitte Prize for the fastest growing company in Wallonia.

Today, GRASP is teeming with ideas to use soft materials for tomorrow’s solutions: the capture of water from the air using cloud nets to supply drinking water to villages in arid areas, the combination of elastic materials and magnetism to control their folding (imagine a stent that can be activated remotely by a magnet!), the development of centime sized robots that cooperate to perform complex tasks… A real revolution for classical engineering!

GRASP, Institute
Building B5a
Sart Tilman, University of Liege - B-4000 Liege
Tel.: +32 (0)4 366 37 03
Email : nvandewalle@uliege.be https://www.grasp.uliege.be


-Based at ULiège, the Center for Integrated Technology and Organic Synthesis (CiTOS) and the FloW4all platform (Flow Technology Resource Center) combine fundamental academic research with services for industry. Their specialty: performing organic synthesis using continuous flow reactors.
It all began in 2013 with the creation of CiTOS by Prof. Jean-Christophe M. Monbaliu. On his return from the United States, he was determined to develop his own research using micro- and mesofluidic reactors to enable new chemical transformations. In less than ten years, the laboratory has acquired an international reputation and has brought together a team of 25 researchers.
The research performed at CiTOS has resulted in new methods for the efficient, safe, cost-effective, and versatile production of high value-added organic compounds. The use of bio-sourced starting materials plays an important role in many of the projects. For example, procedures to use CO2 and glycerol, both of which are industrial waste products, to prepare green solvents or fuel additives have been developed. Another project, funded by the US FDA, aims to manufacture medicines produced entirely from biosourced materials (i.e., derived from biomass) using a small, flow production unit.

The laboratory favors quantum chemistry and artificial intelligence approaches to accelerate the development of new micro and mesofluidic processes, while reducing the waste associated to trial-and-error optimisation. The use of computer simulation tools to suggest optimal conditions for new reactions is a trademark of the research developed in the group.
Since its inception, CiTOS has aspired to conduct fundamental research with extremely practical applications, therefore placing a strong importance on the scalability and potential industrialization of its results. Two milestones have contributed to make this aspiration a reality.
First, in 2017, CiTOS became the first European Corning Qualified Laboratory, associating itself with one of the most important manufacturers of micro- and mesofluidic reactors for industrial


applications. This partnership reinforced the laboratory’s access to industrial equipment and strengthened its range of services for industry.
Secondly, in 2022, the FloW4all Resource Centre was established, made possible by funding from the Walloon Region (Belgium). The FloW4all platform specializes in the use of fluidic reactors to solve challenges in the field of industrial chemical synthesis, integrating the fundamental research knowledge developed at CiTOS with practical knowledge of the industrial sector. The platform relies on dedicated personnel, highly qualified in continuous flow reactors and pilot-scale equipment.
FloW4all has a large inventory of chemical synthesis and flow chemistry equipment to address a large variety of applications. Not only does the platform continue to provide services as a Corning Qualified Laboratory, but it also includes reactors from other leaders in industrial flow equipment. Another major advantage is the presence of dedicated in-house analytical facilities, including both in-line and offline equipment, which allows to immediately assess results.
Its wide variety of equipment makes FloW4all an excellent partner to develop processes under continuous flow from lab scale up to pilot scale conditions. Partnerships with the most important manufacturers of industrial flow reactors expedite the transposition of the processes to industrial scale. In addition, the platform benefits from several licences from the Federal Medicines Agency, enabling it to legally produce psychoactive pharmaceutical compounds, hormonal compounds, and narcotics precursor compounds.


FloW4all is active in flow chemistry training, providing both theoretical and practical sessions on the use of flow chemistry. This training has enabled various companies to initiate their own explorations of flow chemistry. However, most of the activities of the platform focus on the development of protocols for chemical synthesis under flow conditions. Over the past 7 years, around twenty industrial collaborations have been established. Examples of projects include being part of the development of the contraceptive active ingredient estetrol (E4). The collaboration resulted in a new continuous flow protocol for the preparation of a critical intermediate as a cost-reducing alternative to the original methodology. For another partner working in the field of polymers and catalysts, the goal is to increase the efficiency of the catalyst preparation, as well as on-demand customization of the product. Another important collaboration involving an American company aimed at developing high value-added molecules derived from glycerol.
The exploration of flow reactors for industrial applications is of particular interest when promoting the repatriation of production facilities to Europe. The advantage of continuous reactors in terms of safety and environmental friendliness may provide a way to re-design chemical processes to make them compatible with current European regulations. Perhaps the most pressing challenge remaining, however, lies in raising awareness of the potential of flow chemistry. Chemical manufacturers and reglementary agencies benefit from familiarity with this new field to accelerate the widespread incorporation of flow reactors in chemical processes. With the support of collaborations and partnerships, and through ongoing research efforts, CiTOS and FloW4all ultimately aim to support this goal and make the advantages of flow chemistry available to the chemical manufacturing world.



FloW4all | Flow technology Resource Center
B6a, Room 3/16a
Allée du Six Août, 13 - B-4000 Liège (Sart Tilman)
Tel.: +32 (0)4 366 35 10 - Email: jc.monbaliu@uliege.be www.citos.uliege.be - https://flow4all.uliege.be/


What are the key figures for GreenWin?
With 220+ members including over 150 businesses, the innovation cluster has given its label to 97 projects for a budget of € 307+M. GreenWin has been the coordinator of 2 European projects and is a partner in 4 others. GreenWin is supporting 9 Strategic Activity Areas covering the Chemistry, Construction and Environmental technology sectors. GreenWin is the leader of 2 inter-cluster research themes: circular economy and carbon neutrality. Moreover, the cluster is supporting five structuring partnerships:
> RENO+ (dedicated to the deep housing renovation) > HECO2 (aiming at decarbonating the Walloon heavy industry)
> REMIND Wallonia (for mineral ecocircularity solutions)
An interview with Mr Dominique PIERARD, Managing Director (a.a.) of the GreenWin innovation cluster

> Cleantech District Charleroi Porte Ouest, which aims to foster sustainable innovation and economic growth by creating a collaborative ecosystem for cleantech companies and research institutions on a brownfield based at the West end of the city.
> Construction du Futur: a Walloon cluster of organisations dedicated to construction & building sector’s innovations and digital transformation.
GreenWin is a member of 5 international networks. It has also concluded 4 international partnerships (not forgetting the 800 contacts of its international network) and an interregional partnership with Flanders and Brussels. The most recent partnership was signed with Cambridge Cleantech. Thanks to its activities, GreenWin stands

at the heart of a network of businesses with a job growth rate of 25+% and an added value growth rate of 42+%.
Could you present GreenWin’s industrial sectors to us?
GreenWin has significantly contributed to the economic landscape of Wallonia from 2019 to 2023, demonstrating a remarkable value addition of over 63% among its member companies. The number of jobs within these industrial members has more than doubled, showcasing the initiative’s impact on employment across various sectors. Furthermore, GreenWin has facilitated the successful launch of over 50% of its projects’ innovations into the market, highlighting its role as a pivotal player in promoting CleanTech innovation despite challenges such as the COVID-19 pandemic and rising energy costs due to geopolitical tensions.The organisation’s strategic roadmap for 2020-2025 continues to yield positive results, affirming that investment in CleanTech innovation serves as a crucial lever for both economic growth and societal advancement.
Could you talk to us about the cluster’s strategic activity areas and themes?
GreenWin is organised into 3 main areas of activity: chemistry, construction materials and environmental technologies. In addition, the cluster deploys in 9 strategic activity areas concerning the following sectors: green chemistry, the transformation of CO2 (CCU), biotechnologies, sustainable materials, energy storage and efficiency, construction systems, recycling, soils and sediments, sewage and sludge, air and sediments.Two transversal areas (the


circular and digital economy) are added to this. These various activities have openings in three application sectors: chemistry, construction and environment. Our 2020-2025 roadmap has set up 11 priority themes we aim at developing with targets we want to reach by the end of tha period. In 2022, we have already reached our target in terms of number of projects in our portfolio. Our roadmap was cogenerated with our members and was the first Walloon innovation clusters roadmap. It happens that it perfectly matches the European Green Deal that was released only few months after we unveiled our roadmap. We are now working on an even longer run strategic and technological roadmap, which will feed the public authorities with targets to be reached within between 10 to 15 years.
Could you talk to us about your members and the services that you offer them? GreenWin members, above all a network of SMEs, large businesses, universities and colleges of higher education, Certified Research Centres (CRAs) and training centres… are among the best performing in their field and produce the most impressive results. The cluster’s businesses generate job growth of 23+%. Lastly, the cluster is made up of a network whose individual members are highly inspirational: we call them GreenWinners.
What partnerships have you developed?
More than 150 innovation partnerships have been developed in our strategic sectors. We work tirelessly on “interoperability” with other clusters, in particular in the field of the circularity of polymer production and construction building materials and processes. 6 years ago, we signed an interregional Memorandum of Understanding with our Flemish alter ego Catalisti, and this agreement has itself generated an agreement between the Walloon, Flemish and Brussels administrations to facilitate putting interregional projects together, whatever the size of the consortium partners. This was and still is an historic first in Belgium. The goal is to allow for smoother innovation opportunities and to stimulate the creation of direct and indirect jobs within the interregional projects. In 2022, we have signed a
new MoU, with the highly regarded Cambridge Cleantech innovation cluster, that is endeavouring cross-Channel cooperation with both our memberships, despite BREXIT, which has been renewed in 2024.
Could you give us a few examples of projects bearing the cluster’s label in R&D and training?
We have several success stories of which we are very proud, and here are two examples (but you can find many more on our website greenwin.be):
- REPLIC is one of the circular economy success story of Green-Win. It was focused on the development of an industrial unit for the treatment of post-consumption gypsum, with an initial capacity of 12.000T/year and capable of treating waste of various origins (recycling centres, deconstruction,…) to produce high quality gypsum. The innovative aspect of this project comes from the novel combination of mineralurgical techniques which makes for a process that is solid and versatile. A new industrial line and a dedicated new enterprise have been inaugurated in 2020.
- MEDIX focuses on micropollutants in effluents from the hospital and pharmaceutical sector, with some success. This project led by JOHN COCKERILL Group brings together a company active in sewage treatment and one active in ecodesign, hospitals, cutting edge expertise that is the result of European projects involving some Universities and CRAs. All our success stories and projects are published on our website www.greenwin.be.
What do the Walloon projects BATILOOP, WaloSCRAP and Wallace consist of?
These two projects are linked to the identification of deposits of recyclable materials in Wallonia, which combine several characteristics:
> A challenge for industries given the volumes concerned;
> The characteristics that allow for the deployment of a “self-carr ying” business model;
> Their capacity to generate activities and income. BATILOOP and WaloSCRAP have made it possible to build innovation partnerships in the field of recycling for plaster, flat glass, automotive glass etc.

WaloSCRAP has opened up the path to a new agreement with Wallonia, WALLACE, which aims at setting new value chains for plastic and construction building wastes and make sure they are re-used and valorised as proper resources. It is now a very important part of Circular Wallonia, the Walloon strategic plan towards a circular economy and circular industries. As an expert in circular economy transition, GreenWin takes an active part in the implementation of Circular Wallonia, the Walloon strategy to turn our economy into a circular one.
GreenWin is also one the founding members of the RENO+ structuring programme partnership, together with Embuild Wallonie (previously known as the Walloon Construction Confederation or CCW) and Buildwise (previously known as CSTC or the Certified Research Centre dedicated to Construction & Building). It has a threefold objective:
> RENO+ is a Research-Action initiative suppor ted by regional authorities that will facilitate the access to new technologies and the relationship between suppliers and final customers, in an organised and pre-scheduled manner.;
> ensuring the rapid star t-up of concrete projects - via the pooling of skills and equipment and a direct connection between the research players and industry;
> accelerating the bringing to market of competitive industrialisable solutions, by allowing industries in Wallonia to access a regional skills pool via a platform that groups together several Approved Walloon Research Centres working in partnership on project guidance and feasibility.
This project is reaching its deadline with excellent track record and inspiring results to be exploited in further renovation massification initiatives.
Could you tell us about the LCiP project? How do you rate it as regards the Walloon SMEs involved?
LCiP (Life Cycle in Practice) was a European project, which the cluster has been a partner of. Its goal was to make life cycle analysis (LCA) accessible to SMEs. 8 Belgian SMEs have played the game
and benefited as pioneers from customised tools as well as being able to take strategic decisions to adapt their business model to the LCA principles. These are businesses such as PREFER, MOBIC, PCIM, ISOHEMP, RUBBERGREEN, PUR VER, BIOWASTE RECYCLING and PAN-TERRE. In addition, the cluster has put in place a resource centre articulated around 3 of our members: Buildwise, MATERIA NOVA and ULiege-PEPS. It is consequently perfectly possible for any interested SME to contact the cluster in order to access the services of this resource centre. Ever since, all GreenWin projects must include a LCiP before, during and at the end of their implementation. Another European project for which we have been a coordinator is remarkable for its pioneering status and high involvement: SCOT, the number 1 European initiative in the field of capturing and using CO2, which has generated and promoted the notion of carbon neutrality and/or carbon circularity. This project brought to the table clusters and universities from France, Germany, the Netherlands and the United Kingdom and defined the European strategic agenda in this regard. And for the continuation of this project, GreenWin has been commissioned to establish a lasting European structure carried by industry in a number of different sectors: CO2 Value Europe. SPIRE, a Public-Private Partnership between industries and the European Commission, has for that matter integrated the lessons from SCOT into its strategy and in its priority areas. This is also the case for the BBI JU (Joint Undertaking), now named CBE JU (Circular Biobased Europe Joint Undertaking).
What calls for projects are planned for 2024 on the cluster’s themes? Two calls for projects should be organised with the projects to be submitted in March and June 2025 respectively. They always follow the same procedure: starting with handing in a letter of intent and holding an orientation meeting with the cluster’s operational team, and ending with a validation of the file with the GreenWin technical-economic panel of experts. After that comes the submission of the full project to the Walloon Government which will then decide which of the projects will be retained for the label. Lastly the completion of the consortium agreement will open up the path to the grant agreement and project start-up.
GreenWin has produced a 2020-2025 Road Map, in which a list of 11 specific themes are added to the regular strategic fields of action. Because a goal without a plan is just a wish, eventually. More than ever, and in a very volatile global context, agility is a factor of survival and resilience. GreenWin has therefore produced a second Road Map for the period running from 2025 to 2030, in wich 5 major topics have been listed as priorities for that time bracket.
GreenWin aims at optimising all opportunities, setting up unlikely but complementary alliances, reinventing adapted actions and potential interactions to back up its Members and help them cope with the new, circumstantial challenges. GreenWin has set up a steady link with its Members and Partners, which enables to support our ecosystem. This tool will follow and back up the steady work of strategic analysis and adaptations which Green-Win already set up a while ago, leaning on an effective community that is used to cooperate and work within a collaborative innovation approach. We will of course try and help our members to cope with the impact of the energy crisis due to the war in Ukraine: business networking and energy production solutions awareness and R&D will be at the core of our actions. “Union is strength” is the Belgian national motto, and it is not a vain leitmotiv as far as GreenWin is concerned.
What activities are you developing internationally?
GreenWin takes part in international official missions organised by the Belgian government and/or the Walloon Export & Investment Agency. In 2024, our mission to UK, Canda and USA enabled us to set up connections with credible local partners. We also took part in the famous IFAT tradeshow in Germany, in which GreenWin’s skills and experience with EU funding were shared and acknowledged.
What are the main challenges that have to be overcome in the next few years by players in sustainable chemistry, materials, sustainable construction and environmental technologies?
The COVID-19 crisis and the consequences of the war in Ukraine had highlighted pre-existing challenges we knew we had to face, only with more accuracy and adding a sense of emergency to several of them. Agility, adaptability, keenness to cooperate and reconsider usual production processes will be, more than ever, key factors to be enhanced and encouraged, within our eco-system. Setting up value chains in the field of ecocircularity remains a top priority. GreenWin’s steady exper-

tise in that matter is a plus and its contribution to the Walloon Strategic Plan Circular Wallonia is therefore even more meaningful. The challenges in our fields of action are in truth cross-disciplinary but our areas of activity are at the heart of the solutions to be developed and deployed to overcome them on a broader stage, that of society.
Chemistry is faced with a threefold challenge:
> The challenges linked to climate change;
> Vulnerability of access to resources;
> Access to energy. Limitation to access to resources and impacts of climate change will lead to the emergence of tensions and geopolitical pressures from which no one is able to escape. The very nature of our planet is circular and finite, and the increasing rarity of resources will pose problems. Green chemistry will therefore be a crucial key to reduce these pressures and risks of tensions.
Construction for its part is faced with a twofold challenge:
> In the ver y short term, the digital tidal wave that is washing over the links of the production chain and its impact on the creation of new jobs, all the contours of which it is currently impossible to fully imagine, as well as on employment in this sector with the risk of crisis that this implies;
> The calling into question of business models and flexibility, which will increasingly be key factors in the industrial prosperity of the Belgian construction sectors.
There is also a need to take waste management more into consideration, both at industry and consumer level. In this respect, “cradle-to-cradle” is increasingly imposing itself as the solution but it implies the changing of the entire sector of recycling which needs to become a partner and not an adversary of “zero waste” by agreeing to call into question its mode and type of functioning according to Lavoisier’s universal principle which retains its full force today: nothing is lost, nothing is being created, everything is being transformed…
Another aspect that takes a growing importance, in a very swift manner, is the role of AI to optimise the efficiency of production processes and reduce waste (of material, time, energy…) to the maximum. GreenWin is fully embracing the Industry 5.0 targets of the European Commission on that matter, and will do so specifically through to applied AI programmes: ChiMérique (for Chemical industry) and Dig’Easy and EDIH Connect (for the Construction and Building sectors).

What are the key figures and areas of competence of CAP Construction?
CAP Construction has about 200 members, including designers (architects, engineering offices), producers and suppliers of materials, construction contractors and system installers, developers and building managers. In order to enable our members to acquire new skills, develop their business and collaborate to anticipate tomorrow, the cluster has defined a strategic action plan with 5 objectives: to accelerate energy renovation, to promote the reduction of the sector’s environmental footprint, to support the players in the digital transition, to adapt buildings to changing needs and to increase skills while promoting business opportunities and collaborative projects.
What services do you offer to your members?

We organize various types of events, typically consisting of conferences followed by cocktail parties, in order to strengthen cross-industry cooperation. Amongst our most successful events, you can find the ‘Positive Waves Evenings’ (presentations by projects leaders looking for potential partnerships) and our ‘Garden Party’ (featuring a presentation by a renowned international speaker). Open to both our members and people from the sustainable building sector, these events are dedicated to creating highly valuable networking and business opportunities.
To increase the skills of our members, we also organize “Members” Activities, reserved for a limited number of participants in order to boost exchanges. The Decision-makers’ Lunch and Afterwork create exclusive interactions between our members and political decision-makers. But we also promote macro-economic conferences, round-tables, webinars and meetings on various themes.
CAP Construction has also set up thematic networks (energy renovation, silver economy, circular economy, wood construction, special techniques, new technologies) to enable its members to discover new market opportunities, to receive strategic information, to communicate with the other members of the network and to be consulted on opinions or actions. Finally, CAP Construction offers its members a communication platform (website, newsletter, social networks, reports, guides and articles, new markets, exemplary projects, innovative products, job offers).

Could you tell us about your main projects?
The cluster is participating in the Walloon project “Objectif Réno Copro” which started in January 2024 and aims at developing and testing an integrated support service specifically for the renovation of condominiums. The purpose of this integrated service is to guide co-owners and their decision-making bodies through the various procedures (administrative, financial and technical) at each stage of the project, while taking an overall view of the renovation project.
CAP Construction is also participating in the Walloon project Construction du Futur (2024-2026) to support economic development and digital innovation in the construction sector. The ambition of this project is to help the construction sector meet the challenges related to employment, economy and environment. CAP Construction’s mission is to raise awareness by identifying and mobilizing the major players in the sector to create a knock-on effect through the exchange of good practice.
The cluster is also part of 3 INTERREG projects. The goal of Senior Activ’2 (2024-2027) is to provide cross-border response to home support and loss of autonomy. The Greater Green+ (2024-2028) project aims to make the Greater Region (GR) a European leader in the ecological transition towards a circular economy and sustainable development, focusing on five themes: energy, sustainable construction, recycling, water and the environment, and bioeconomy. W.A.V.E. (2024-2027) aims to increase the proportion of local wood, develop concerted cross-border strategies and common tools, enable greater fluidity in trade between wood players in the GR, strengthen cooperation within and between sectors, support businesses through innovation and digital technology, and ensure the relocation of processing and the use of wood in construction.
What is the role of innovation and new technologies in promoting sustainable construction?
Technological innovations are sources of disruption and creation of new business models; technologies such as BIM and new concepts like modular construction will encourage actors to move towards greater collaboration and integration. The green transition requires a new mindset and a complete paradigm shift, bringing innovation to the construction value chain by emphasizing the renovation wave and the application of circular concepts to buildings. All these innovations are promising to save time, optimize resource use and ultimately minimize the environmental impact of construction and renovation sites.

An
What exactly is eco-construction?
Eco-construction is an approach that aims to build or renovate healthy, comfortable and energy-efficient places to live and work, from the design stage right through to the end of a building’s life. Eco-construction combines building design with the use of eco-materials to reduce carbon footprint and the consumption of natural resources. The materials used in eco-construction are biosourced, geosourced (little processed), recycled or reused.
So eco-construction isn’t just a wooden house insulated with straw bales?
First and foremost, it is a building designed according to its environment: its position, the amount of sunlight it receives, the local climate, the nature of the soil, etc. Secondly, this design takes into account adaptation to climate change, in particular by integrating elements that will provide shade in the summer and others that will provide natural heat in the winter. Eco-design also aims to limit the amount of impermeable soil, so as to reduce the risk of flooding. In general, we will take care to reduce soil alteration, for example by building on stilts rather than concrete foundations, where possible. In addition, eco-construction professionals use materials that, by their very nature and/or the way they are processed, consume less energy and pollute less than commonly used products. Natural materials include wood, hemp, straw, grass, wool, paper, cork, cotton, stone and raw earth, all of which are used in the construction or renovation of homes, schools, offices, theatres and more. Wallonia has around fifty producers of eco-materials and construction systems.

tests and certifications that are unaffordable for some companies.
What are you doing to remove these barriers?
The main challenge is to change mindsets and convince clients, architects, contractors and public authorities to favour eco-materials. This involves raising awareness and providing support, from the Eco-construction Cluster. For example, before the recent European, legislative and regional elections, we met representatives of all the political parties to demonstrate the potential of the sector and the importance of supporting it in the context of reducing greenhouse gases, protecting resources and preserving the environment. Our voice was heard, and support for the eco-construction sector is explicitly mentioned in the Walloon government’s Declaration of Regional Policy.
Do your activities extend beyond Belgium?
Yes, because we work on European Interreg projects, in particular Build Value, for which we are the lead partner. This project involves the border region between Wallonia, Flanders and France. It aims to strengthen the region’s ability to adapt to climate change. This will involve promoting eco-materials, whose carbon footprint is favourable to reducing the greenhouse gases emitted by the construction sector. The use of eco-materials will be encouraged by drawing up an inventory of existing products and characterising their potential in situ and in the laboratory. These solutions will be promoted through training and support for players in the sector, to accelerate the decarbonisation expected by 2050.
Most of these companies are SMEs or even very small businesses. Are they capable of meeting demand?
Many of the companies in the sector are self-employed, working alone or with a small team, but there are also industrial structures employing up to 120 people, such as insulation or wooden structures manufacturers and builders. These manufacturing companies do not produce at their optimum. In fact, they are only working at 20% to 40% of their potential, due to a lack of demand. Some Walloon production companies are more successful abroad than in Belgium (Gramitherm, Woolconcept, Stabilame, etc.). These local producers could quickly provide over 85% of the insulation materials needed to meet the 2050 targets. More than 300 companies can implement them and are just waiting for us to call on their expertise.
What are the obstacles to the development of existing solutions?
The main obstacles are psychological: habits, preconceived ideas about durability, fire safety and price. The sector also has to contend with the powerful lobby of conventional construction. Some obstacles are more prescriptive, such as the requirement for


An interview with Mr. Jean-Philippe PARMENTIER, Director of the INFOPOLE ICT Cluster
ould you present your network and the technological skills of your members?
The cluster has been in existence for about twenty years and brings together about 150 digital players: companies, of course, but also research centres, skills centres (training organisations) as well as research and higher education players (universities and colleges). The member companies are of all sizes, from very large companies such as NRB (Network Research Belgium) and NSI IT to SMEs employing a few to a few dozen people. In 2020, these companies represented 7,000 full-time equivalents. Their technological skills are just as diversified, from first step technologies (software development, etc.) to cutting-edge technological advances in cybersecurity, via the development of CRM or ERP applications (for the initial structuring of good databases) and the integration of solutions based on artificial intelligence (AI) and the Internet of Things (IoT). Our network covers the entire value chain and the players concerned in all their diversity: innovative players, advanced technology players, players resolutely focused on exporting to Benelux, France, other European Union countries and even beyond... This diversity is a source of wealth.
How does the cluster participate in the implementation of the Digital Wallonia strategy?
We ensure the operational aspect of this strategy by getting involved in various programmes such as “Industry of the Future”. In this context, we are participating in the ChiMérique project with the Greenwin competitiveness cluster and the Plastiwin cluster: the objective is to raise awareness among green chemistry and plastics companies and to help them to jump on the bandwagon of the “Industry of the Future” thanks to the development of new digital tools adapted to their needs. Our collaboration with the Walloon clusters is also reflected in the organisation of cross-sectoral meetings for industry in the broad sense (with MecaTech) or the Building sector: we run workshops to enable companies to express their needs and to propose appropriate digitalisation solutions. In addition, we relay the calls for projects launched within the framework of Digital Wallonia and organise


meetings between the various players to help them submit projects. For example, in this respect, we work with the CAP Construction and TWEED clusters on circular economy projects (Digital Wallonia 4 Circular).
What services do you offer to your members?
As a cluster, we are like a hub for the Walloon digital sector. We connect companies and digital players. In addition to the above-mentioned calls for projects or workshops, we offer dedicated and personalized services to connect our members with companies looking for digital partners. Moreover, we are keen to see how to make two competing companies complementary, in the field of IoT for example, and how to transform them into sources of innovation for a product or service at the intersection of their respective activities. Furthermore, we help our members grow by developing their business, by proposing collective visits to international fairs and exhibitions to make technology watch or be inspired. Finally, we offer them a showcase and put them forward to promote their companies, use case and business in Wallonia.
In your opinion, what are the major challenges in your field of expertise?
The major challenges concern both the digital sector and companies in need of digital tools (data analysis and enhancement, AI, cybersecurity, etc.) in various sectors such as construction, logistics or even industries undergoing relocation. Digital technologies have serious advantages in meeting the challenges of labour shortages, competitiveness, market changes, cost pressures, etc. Entire sectors are being transformed, encouraged to reduce their energy consumption and greenhouse gas emissions, and to produce goods and services differently at a time when customisation is booming. This transformation is closely linked to the issue of the professional skills to be acquired between now and 2030: it is important to know that 30 to 40% of professions will evolve, that others will disappear and that digital technology and AI will play a greater role. Production operators and laboratory researchers alike will have to train to stay in the race. It is therefore urgent to develop the digital skills of Walloons: specialized skills that will benefit the entire regional economy.
Approved and supported by the Walloon Region, Plastiwin is a network of companies that brings together players specialised in polymers and biopolymers, elastomers, composite materials and synthetic textiles.
Plastiwin has three missions. First mission: to promote business development and innovation. To do this, the cluster brings out innovative projects, supports the marketing and promotes the plastics industry. Second mission: to stimulate ideas. This involves creating a dynamic exchange between members to enable technology and skills transfers. This is key to bringing out the ideas of tomorrow and making the plastics industry more sustainable and eco-circular. Third and last mission: to inform. Plastiwin facilitates access to contractors by increasing the visibility of the value chain and by communicating the technological potential of Wallonia. The cluster also prepares the future by informing its members about technological trends and growth markets. Finally, it raises public awareness of the innovative, sustainable and circular nature of the plastics industry, which is still not well known.
It must be said that this industry weighs heavily in Belgium with more than 30,000 jobs, 12.4 billion euros in turnover and 500 million euros in investment in 2023 (according to Plastics Europe and essenscia). And there are many application markets: the packaging industry, of course (39% of global plastics consumption), but also the construction sector (22.9%), the automotive industry (8.3%), the electrical and electronics sector (5.7%), households, sports and leisure (4.1%), agriculture (4.4%), etc.
In this context, Plastiwin has developed a 4-step strategy: to increase the competitiveness of companies thanks to its extended network and its partnership with AWEX (organisation of meetings, publication of promotional articles and videos on its platforms), to facilitate recruitment by developing and facilitating access to training and by relaying the job offers of its members, support businesses towards the circular economy through its involvement in Circular Wallonia (with an added value creation that could reach 488 million euros and the potential creation of 3,500 jobs) via 6 concrete actions, to strengthen the digitalisation and innovation of the plastics industry (transition to 5.0) in cooperation with all member research centres and universities. In this respect, a new collaborative project validated by the Agence du Numérique will allow Plastiwin to support its members in their digitalisation process for 2 years. The objective is to offer three types of turnkey solutions: the development of tools to identify needs and facilitate the digital transition, the establishment of a network to raise awareness through flagship events (GreenW’Innovation Challenge, Infopôle On Tour, etc.) and the personalised support of SMEs in their digitalisation process, from diagnosis to digitalisation itself. Plastiwin is also participating in the “Industry of the Future” strategy as part of the “Digital Wallonia” programme.
Plastiwin’s strategy is accompanied by three types of services. Networking is the first of these. The cluster uses its partnerships to put its members in touch with key players in the plastics industry, both locally and internationally. Participation in plenary meetings, working groups and other collective work or networking meetings within the framework of partner projects, development of a specific strategy with AWEX and EEN to ensure promotion abroad,

constant monitoring of the evolution of the international market and prospecting work by participating in key events linked to the plastics industry: all these avenues are designed to increase the growth prospects of companies in the sector. The second service is consulting. Plastiwin puts its expertise at the service of companies to support their projects towards more eco-circularity (development of offers, sustainable services and partnerships in line with Wallonia’s circular economy strategy), facilitate innovation (digitization of activities, orientation towards investment aid), but also to facilitate the recruitment of new talent and training (with a dedicated working group since 2020).
Storytelling is Plastiwin’s third mission. Telling the story of a company and that of the plastics industry: this is the ambition of the cluster, which wants to highlight those who today shape the plastics industry of tomorrow. There’s nothing like a great story to mobilize talent and encourage vocations!

What was the impact of the pandemic and subsequent crises on logistics activity?
The health crisis has demonstrated the vital importance of logistics activity for society. But while logistics chains have grown considerably over the past 40 years, they have proven to be less resilient and less agile. More broadly, successive crises are undermining the cost-optimisation logic of geographically dispersed production of the various components that our economy so badly needs. The war in Ukraine, geopolitical tensions, the semiconductor crisis: the international situation is a vivid reminder of this. Against this backdrop, logistics is a growing concern for industrial companies, and transport is at the heart of the sustainability agenda. Hence the importance of seeking alternative solutions and innovative initiatives to achieve this.
What are the key figures for Logistics in Wallonia?
In 2023, Logistics in Wallonia recorded 37 letters of intent (a record in the cluster’s history), 3 approved projects and 7 projects in progress. The cluster also organised 39 networking events, bringing together more than 1,200 people. In addition, the cluster now has 318 member organisations. This is a very positive development, and the new Walloon government should renew its confidence in regional competitiveness clusters, including ours.
Could you tell us about the contract with the Walloon government and your new service offer?
While awaiting the next five-year contract of objectives and means, which should be signed with the new Walloon government, I can already announce that the implementation of our renewed service offering is complete. All the cluster’s member companies are now included in our new offering, and it’s a
success: 90% of them have chosen to renew their membership, even though some rates have risen considerably. As a result, our members’ contribution has doubled. This transformation of our internal organisation - the most radical since the creation of the cluster - has enabled our team to acquire complementary skills. What’s more, the Walloon government has asked us to take on an additional mission: identifying and supporting scale-ups, companies in a phase of accelerated growth. We have also produced 3 technological and strategic roadmaps on three major trends in the sector: connected mobility, low-carbon mobility and biologistics dedicated to the pharmaceutical industry. These roadmaps include the definition of actions to be taken to set up projects by the players concerned. Finally, as part of the Walloon Recovery Plan, the Ministry of Mobility has asked us to organise a call for projects as part of the regional mobility strategy. As a result, we identified and selected 8 smaller-scale projects.
That said, our package of services includes BOOST, dedicated to organisations with a role in supporting the transformation of transport, logistics and mobility activities, IMPULSE, which is aimed at those who are mobilizing in favour of this transformation, PERFORM, which targets those who wish to inspire the ecosystem active in this field, and SHINE, which is intended for those who specifically support the cluster’s activities and associate their image with that of the cluster. This is the case of Alstom, MG Real Estate, Deloitte, TotalEnergies, VPD, Eiffage, Citymesh, Orange Belgium, Intraco Consulting, DSV, Liege Airport and AISIN.


Could you present some of the cluster’s projects? Three projects have been approved for 2023. IsoSpec aims to develop software distributed in SaaS mode and dedicated to the management of specifications exchanged internally between a client and its suppliers within industrial supply chains. The challenge is to digitise heterogeneous ‘specifications’ (standards, technical specifications, material certificates, security) in a single structured generic model. IsoSpec will make it possible to speed up, centralise and secure exchanges between principals, suppliers and subcontractors; to compare actual production data with predefined tolerances; to translate measurements and standards according to the company’s own semantics for a better understanding of the specifications received or to be sent. In this way, IsoSpec will play an active role in improving the competitiveness of industrial companies.
The DACS project aims to improve the efficiency of the hospital medication circuit. It began with an observation made by the CHU de Liège: almost 3 million nominative unit doses are prepared each year by the pharmacy, but more than 20% of them, i.e. more than 600,000 doses, are not administered to patients in the hospital’s more than 1,000 beds. These medicines have to be returned to the hospital pharmacy, but many of them get lost, while others cannot be reused and are therefore thrown away or destroyed. What’s more, the 2 pharmacy robots only cover 80% of prescriptions, while 20% of the medicines prepared go unused. This represents a financial loss and an ethical problem in times of shortages. The ambition of the DACS project is therefore to develop and market a software platform that will optimise hospital drug preparation schedules, reduce the rate of unadministered drugs and thus improve the efficiency of hospital pharmacy operations.
Finally, the EcoSource project aims to develop digital tools to support the implementation of the European Union’s new regulation against imported deforestation (EUDR), for European companies importing wood, cocoa, coffee, rubber, palm oil, soya and cattle. This tool has been developed by 4 Walloon partners: BFConsult, a forestry and environmental engineering consultancy; Deuse, an IT development company; the QuantOM and CES research centres at HEC-Liège, which are working on sustainable supply chains; and the Earth & Life Institute research centre at UCLouvain, which is working on the detection of deforestation using satellite images. This 36-month project, developed in close collaboration with professionals from the sectors affected by the new regulations, is supported by the German Ministry for Economic Cooperation and Development via the KFW and the Programme for the Promotion of Certified Logging. The results of the project will include web and mobile digital tools, meeting the needs of European importers and producers in terms of supply chain


modelling, risk analysis and management, document management and satellite deforestation analysis. The project will also help to strengthen the position of Walloon research centres and businesses in the fight against deforestation and in supporting the establishment of sustainable supply chains.



How does the cluster support its members in their transition to multimodality and the reduction of their transport-related CO2 emissions?
We use the Lean & Green Europe programme to support companies wishing to draw up an action plan to reduce their CO2 emissions by at least 20% in a maximum of 5 years. The cluster also offers an analysis of companies’ flows in order to formulate solutions to reduce their dependence on road transport. Finally, it works with municipalities wishing to invest in the optimization of urban logistics. This is a necessity with the explosion of online commerce and the free deliveries (an abuse of language!) offered by many websites. To remain sustainable, such traffic must benefit from innovations such as cargo bikes or solutions such as Rayon 9: this small structure based in Liege employs couriers who are part of a reintegration programme, in line with the logic of the social and solidarity economy.
What are the main challenges to increasing the adaptability of logistics supply chains?
The dual digital and environmental transition concerns all sectors of activity, and of course logistics. Since 2024, companies have to carry out scope 3 reporting of their CO2 emissions generated by the volumes transported. Furthermore, the fragmentation of the supply chain continues, in a period of economic contraction whose end is difficult to predict. The fact remains that the world economy remains based on international flows: we will always need transport. In my opinion, the future of the sector lies in a mix of different motorisation technologies. What remains to be done is to make this energy mix operationally manageable, so as not to slow down companies’ activity or put a strain on their profitability.
What is more, fossil fuels will not disappear completely. It’s up to us to adapt our lifestyles and consumption patterns. Let’s not wait for political decisions to be taken before we adopt new solutions!
An interview with
What are the MecaTech cluster’s international missions?
The MecaTech cluster’s mission is to create an industrial dynamic that generates jobs by supporting technological innovation projects for Walloon companies, research centres and universities. The emphasis is on developing collaborative industrial and commercial projects with an international dimension. The MecaTech cluster’s international positioning reflects this objective. Its international actions aim to increase the value of approved innovation projects outside the borders of Wallonia, to create opportunities for international partnerships for its members, to mobilise international financial resources for their projects and to contribute to the establishment or strengthening of foreign investment in Wallonia, all in partnership with AWEX.
What are the MecaTech cluster’s priority areas of expertise?

The engineering sciences encompass a wide range of cross-disciplinary technologies and know-how affecting almost every sector of activity: consumer products, medical equipment, industrial machinery and processes, energy production, etc. However, over the last few years, lines of force have emerged, and certain themes have achieved significant critical mass, which is reflected, among other things, in the size of the MecaTech cluster’s portfolio of innovation projects in these fields. 5 non-exclusive industry ecosystems have been selected by the MecaTech cluster to tailor its expertise to the needs of its members: MedTech, Sustainable Energy, Circular Economy, Defence & Security and Industry 5.0.
An innovation-friendly ecosystem for a better international visibility
With a network of over 400 members, the MecaTech cluster stands out for its ability to build bridges between Walloon innovation and international ecosystems. Its International Unit, dedicated to support and networking, makes it a privileged partner for companies wishing to innovate and develop on European and world markets.
The MecaTech cluster: a Belgian pioneer in European ‘Cascade Funding’ projects for Walloon SMEs
Since its creation, the MecaTech cluster has been actively involved in promoting Walloon innovations in Europe and beyond. Its actions are aimed at establishing strategic international partnerships enabling Walloon SMEs to integrate into European ecosystems and access funding opportunities. Today, the MecaTech cluster is a key player in cascade financing, a European model for providing financial support for local innovation projects through simplified calls for projects for SMEs. This model has already benefited numerous companies, notably through the IoT4Industry, DREAM and GEMSTONE projects.
The role of the MecaTech cluster’s International Unit
The cluster’s International Unit is dedicated to supporting Walloon companies in their internationalisation drive. Its mission is to offer personalised support in obtaining European funding and to help SMEs integrate into European innovation networks. Thanks to a constant watch on innovation and funding opportunities and tailor-made assistance in
preparing applications, the Unit also facilitates strategic international collaborations.
The MecaTech cluster is a partner in two European ‘Cascade Funding’ projects: DREAM and GEMSTONE DREAM project: adopting digital technologies for the manufacturing industry.
The DREAM (Digital Resilient Europe for Advanced Manufacturing) project, launched in 2022, has brought together several European clusters, including the MecaTech cluster, to promote digital technologies in the manufacturing industry. This project has funded 35 innovation projects aimed at accelerating the adoption of AI, intelligent robotics and cyber security in industrial processes. Nearly a third of these projects (11 projects involving 12 Walloon companies) came from the Walloon ecosystem, testifying to Wallonia’s significant involvement in the digital transformation of industry. DREAM officially ended in August 2024.


GEMSTONE project: direct support for green and sustainable industry GEMSTONE, launched in September 2023, is coordinated by the CIMES cluster (Rhône-Alpes, France) and brings together clusters from several European countries, including the MecaTech cluster. This project focuses on ‘Green Manufacturing’ and directly supports SMEs through lump-sum funding to encourage the development of environmentally-friendly solutions. In 2023, four cascade funding calls have been opened, including:


- GREENINNOV for the prototyping of green manufacturing solutions (€60,000/SME); three Walloon companies have received funding.
- GREENADOPT for the adoption of green solutions by industry (€40,000/ SME consortium), with the selection of three Walloon companies.
- TRAIN for training in Green Manufacturing (€2,000/SME) and EXPLORE for international exploratory missions (€1,500/SME), both open until 31 December 2024.
A strategic roadmap and a catalogue of events and training courses related to Green Manufacturing are also available to partners, facilitating access to essential resources for launching green projects.
WALHUB: accelerating the digital transformation of Walloon manufacturing companies. An EDIH for Wallonia!
WALHUB, the European Digital Innovation Hub for Wallonia, helps manufacturing companies with their digital transition by providing access to technology demonstrators, Living Labs and networking events between technology providers and industry. The MecaTech cluster plays a central role in coordinating the funding and coordination activities of the ecosystem. This project, launched in 2022, complements the ‘Digital Wallonia’ strategy by strengthening the digital skills of Walloon companies in the manufacturing sector.
The MecaTech cluster’s International Unit offers much more
The International Unit goes beyond traditional support missions by helping member companies to develop international relations and attract European funding. It organises and participates in strategic international trade fairs and events, enabling Walloon SMEs to meet potential partners and boost their international profile. The Unit’s activities also include finding partners for collaborative projects and supporting the integration of European innovation networks. Through these actions, MecaTech enables its members to seize growth opportunities in foreign markets. In 2024, the International Unit continued to expand its international network for the benefit of its members by organising missions abroad, particularly in France (Paris, Lille), Germany (Würzburg, Berlin), the Nordic countries and Canada.
Commitment to greener industry: the HECO2 and Circular Wallonia initiatives
The MecaTech cluster is actively involved in strategic regional initiatives to reduce CO2 emissions and promote the circular economy, such as the HECO2 portfolio of projects and the Circular Wallonia initiative. These projects are in line with the guidelines of the Smart Specialisation Strategy (S3) and strengthen Wallonia’s positioning as an innovative and sustainable region.

Founded in Brussels in 1937 and based in Louvain-la-Neuve since the 1990s, JEMA combines more than 80 years of expertise in magnetic products (transformers, inductances) for railways and telecoms, 45 years in particle accelerators and 10 years in energy transition.



With a turnover that has more than doubled in 3 years and an orderbook that has multiplied by 6 in 2 years, JEMA has seen its workforce grow from around 30 people in 2019 to 70 people in Louvain-la-Neuve, not forgetting its 25 employees in Alsace (Haguenau) adding more expertise and innovation in power supplies as well as RF solid-state amplifiers.
In order to support this growth, JEMA has extended its facilities, with a tripled production and test capacity in Louvain-la-Neuve, to support more and larger projects, including full size container applications.
All systems are indeed assembled and fully tested in JEMA’s facilities, to improve the global quality delivered, and reduce potential risks and time losses on customer premises.
It’s a cascade of good news for this specialist in power electronics and DC converters. JEMA’s expertise is based on respect for customer requirements (its power supplies are custom-designed), the high precision and stability of its products dedicated to particle accelerators, and its ultra-fast high-power (high current, high voltage) management and control solutions for the industrial energy transition. For all applications, high efficiency is also critical for customers.
The technologies offered by JEMA cover high-performance AC/ DC converters: precision, stability, power (current & voltage), control speed, efficiency, etc. They are aimed at two main markets. The first is particle accelerators for medical applications (cancer
treatment or detection, medical sterilization) or advanced research (major international research centers). The second global market is the energy transition, with applications in the electrification of industrial processes (plasma torches, plasma furnaces and other electrical heating systems), energy storage (industrial batteries and industrial chargers), hydrogen production (electrolysers and pyrolysis), DC microgrids, high current / high voltage dedicated industrial processes (manufacturing of permanent magnets, e-kerosene manufacturing or other specific applications), etc.
In addition to the power systems themselves, JEMA is also extending its proposal to customers through containerized solutions, to reduce and limit the impact on industrial sites and operations, as well as simplify interfaces on existing facilities. These “plug & play” tailor-made solutions have a lot of added value for industrial customers, specifically for high power applications.
Another extension of JEMA competencies covers long-term services: remote monitoring, preventive maintenance, regular reviews and continuous improvement suggestions, etc. This supports very demanding customers, for which uptime, reliability and long-term operations are paramount.
In this growth change, JEMA is fully supported by the CE+T Group, and other “sister” companies. As a group, the idea is to keep getting the best of both worlds: more support and means through larger size organization, as well as agility and flexibility to move fast and support customers in their very specific needs and requirements. So through synergies, companies of the CE+T Group are


adding values to one another when need arises and when it makes sense for the customers and projects.
R&D is naturally at the heart of JEMA Belgium’s activities. A large portion of its staff are power electronics engineers and technicians, in charge of designing systems and supporting their production, testing, installation and long-term services all along systems’ life. In addition to the specific needs of its customers, JEMA is looking for specific solutions to facilitate the energy transition in terms of interactions with public networks. Major industrial projects are likely to cause major disruption (in addition to the huge demand for reinforcement of these networks). The company is therefore endeavoring to design topologies that will cause as little disruption as possible, and that are best adapted so as not to slow down this transition.
Other research projects include specific cooling techniques for high power electronics. With the increased power density required for high power applications, dedicated cooling is often required, generally handled by water cooling. But high purity water in industrial environments can be problematic for a project, so JEMA is developing with partners closed loop systems for these specific power electronic topologies.
Finally, digital applications, including automatic test benches, remote monitoring for distance services and support, or additional embedded tools within JEMA control systems are also in the research portfolio, once again with different partners to gather expertise around JEMA’s customer’s needs.
As well as working with the aerospace industry (by supplying test benches to simulate, validate and test the batteries that activate the electric actuators), JEMA continues to strengthen its in-house skills through training and to push the envelope of technologies and topologies further. As part of this, the company is taking part in R&D projects with universities (UCLouvain, UMONS, ULiège) and other companies (Engie Laborelec, Calyos, CE+T) to limit yield losses, reduce the impact on networks for high-power systems (industrial electrification projects and hydrogen production), encourage the digitalization and industrialization of processes, etc.
These projects offer a wealth of development opportunities for JEMA, which sees its future in both particle accelerators for the medical sector and energy transition in the broadest sense. For example, the company is being asked to design systems for
producing organic fertilizer from liquid manure using renewable energy. This would solve the problem of manure disposal and avoid the need for chemical fertilizers. A virtuous circle!
Finally, and in parallel to the benefits of all these innovation projects for JEMA and its customers, it also feeds employees bringing new, exciting and demanding activities, fueling learnings and growth on exciting developments. In addition, all activities are in positive field on the societal aspects fueling even further motivation and purpose for all.


JEMA Belgium
8, rue de Rodeuhaie B-1348 Louvain-la-Neuve
Tel.: +32 (0)10 45 43 33
Email: nicolas.bronchart@jema.be https://www.jema-power.com/

An interview with Mr. Étienne POURBAIX, Managing Director of the Skywin competitiveness cluster
And Mr. Stéphane GUALANDRIS, Project Manager at Skywin
Anew chairman for Skywin ! In September 2023, François Lepot (SAB) succeeded Jacques Smal as Chairman of Skywin. François Lepot, CEO of Safran Aero Boosters, has been appointed Chairman of the Skywin Wallonie competitiveness cluster. A civil engineer with a degree in electromechanics and aerospace engineering from the University of Liege, Lepot spent a year working for Cockerill-Sambre after graduation. He then devoted his entire career to one of Wallonia’s leading aerospace companies, Techspace Aero, now Safran Aero Boosters.
More specifically, the future CEO started at Herstal in the Design Office in 1993, before becoming Project Manager for the development of the CFM56-7 engine two years later, and then moving on to General Electric (US) and Snecma (France). In 1998, he became Technical Brand Manager for the General Electric and Pratt & Whitney engine programmes. In 2006, at the age of thirty-six, François Lepot was appointed Director of Operations, in charge of production, supply chain and investments. Finally, in 2019, he succeeded Yves Prete as CEO of SAB.

The Skywin cluster’s strategy has been completely overhauled for 2022. Could you tell us more about it?
Étienne Pourbaix (E.P.). In 2022, the Walloon government reviewed its relationship with the 6 regional competitiveness clusters with the implementation of a multi-year contract of objectives and means that defines five missions. This was important for two reasons: the sustainability of the cluster is guaranteed in the medium term and its activity is both formalised and clarified. The conclusion of this contract was accompanied by internal reflection within the cluster on the technical axes.
What are the 5 missions of the Skywin cluster?
E.P. The first mission is to support the government’s regional strategy by producing among others technological and strategic roadmaps for the sectors that are relevant to our cluster. We will come back to this. The second mission is innovation, based on two main areas: ensuring a technological watch for members
(seminars, participation in fairs, etc.) to make them proactive, and organising two calls for projects per year in order to launch collaborative R&D projects to develop new technologies.
Third mission: to ensure the economic growth of the sectors covered by the cluster through scaling-up: this involves enabling SMEs that have been established for 2 to 3 years with a marketable product or service and a small number of employees to move up a gear by acting on several levers simultaneously (commercial aspect, marketing, personnel management, innovation, new financial resources from the Walloon Region, etc.) We are keen to act as growth accelerators for potential future “nuggets”: we target them, define together the points to be improved and establish an appropriate action plan.
The fourth mission concerns the development of talent and training along two lines: the reduction of labour shortages in the sectors concerned and the technological innovation generated by R&D projects. Design offices should not be the only beneficiaries of these advances: it is also in the interest of industry to make use of them in their production processes.
Finally, our fifth and last mission relates to internationalization in close cooperation with AWEX. It is crucial to increase the visibility of our four sectors, which are international by definition. This requires the use of digital tools but also, and above all, in-person participation in the largest specialised trade fairs throughout the world. To conclude this subject, let us specify that each of these five missions has been broken down for each sector.
E.P. The Skywin cluster has identified four sectors: aeronautics, space, drones and defence. In 2022 and 2023, we have produced the roadmaps for space, civil and military aerospace as well as drones. The aeronautics sector covers aircraft structures and engines thanks to the presence of a very dense industrial fabric in Wallonia. I am of course thinking of the two world

leaders, Sonaca, which manufactures the leading edges of wings, and Safran Aero Boosters, which produces 60% of the boosters for the first stage of air compressors in aircraft. But there are also a great many SMEs, active in subcontracting or in direct access with the major contractors.
Skywin has defined 5 technological axes… E.P. Indeed. These five technological axes or DAS were determined internally, in consultation with the project managers and member companies, and then approved in December 2021 by the cluster’s board. The first axis is that of flying substructures and subsystems to provide global solutions to be integrated into an aircraft, a launcher or a satellite. It also includes new types of fuel (synthetic or hybrid fuel - combining paraffin for propulsion and electricity for air conditioning, cockpit lighting, etc. - and hydrogen), whose effects on structures are far from negligible. The second DAS includes innovative

materials and processes for the use of these materials, whether they are composite, hybrid (electronic equipment and composites using carbon fibres to make different layers of structures) or metallic (with lighter alloys). Mixed solutions are increasingly envisaged with the electrification of materials for control purposes but also to prevent the appearance of cracks or to calculate the resistance and wear of materials.
The third technological area is embedded and communicating systems, with a focus on the cyber security of systems communicating with the ground. The more intelligent and communicating the systems are, the higher the risk of cyber-attack.The fourth axis includes the data economy and artificial intelligence: more and more satellites, drones and aircraft are generating data in real time. What remains to be done is to detect the relevant and useful information to be processed on the ground…
Finally, the fifth technological axis encompasses simulation and digital modelling (with the digital twin in particular). It is increasingly common to develop digital models before an initial prototyping. This fifth axis also aims to make the most of the very substantial physical testing facilities that we are lucky enough to have in the Walloon region. There is, of course, the Liege Space Centre (CSL), whose simulation system with vacuum tanks 6 m in diameter is used to reproduce the effect of the vacuum of space and is recognised by the ESA. I am also thinking of the cyclotron at UCLouvain, which is used to simulate the influence of cosmic radiation, which is very harmful, on satellites in orbit. And let’s not forget the private equipment, which can be used for R&D projects, such as test engine facilities from Safran in Liege to simulate the operation of aircraft engines or a large anechoic chamber from AGC Glass Europe group to simulate the electromagnetic environment and observe the reactions of antennas to electromagnetic disturbances. As you can see, we have a lot to offer!
The health crisis linked to Covid-19 brought the aeronautical sector to a sudden halt with a high risk: the erosion of R&D skills with the departure of engineers to other sectors. Following the example of the important aids granted by the French and German governments, the Walloon government launched the WINGS project in the summer of 2020 to support the regional aeronautical sector, and it is Skywin that was naturally entrusted with its implementation. I’ll let Stéphane Gualandris speak more about this. Now that activity has resumed, we are faced with another challenge: recruiting competent and qualified personnel to compensate for the departure of many people to other sectors.
Let’s talk about the WINGS project!
Stéphane Gualandris (S.G.). This is an aerospace technological innovation partnership that was launched in the last quarter of 2020 to respond to a double challenge: the health crisis and the grounding of the Boeing 737 Max.
It now brings together 19 partners for the third phase of the project:
- 3 three large companies: Safran Aero Boosters, Sonaca and Thales Belgium,
- 11 SMEs: GDTech - CAD and CAE engineering service, AnyShape - Additive Manufacturing, Calyos - Passive thermal management systems development and manufacture, Technochim,
- Sur face treatment of metals, V2i - Vibration testing and measurement, numerical simulations, control and monitoring of NDT, MachineSight - Integration into special machines, mechatronics engineering design office, Rovitech - Integration of inspection solutions, DELTATEC - Development and manufacture of electronic systems, thermal, IoT, AI and Coexpair –Net Shapes Composites Manufacturing Solutions, - 7 research centres: CENAERO - Aeronautical design, processes, spacecraft, buildings and smart cities, von Karman Institute - R&D fluid mechanics, CRM - Metallurgy, characterization of metallic materials, assembly, coatings, industrial processes, CETICSoftware engineering, communicating embedded systems, data science, Sirris - Composite materials, metals, modelling, digital simulation, industrial processes, Multitel - Applied photonics, Signal processing, Electronic prototyping, AI, Materia NovaPolymeric Materials, Surface Coatings and design of batteries.
How is this project organized in concrete terms?
S.G. WINGS is at this time a 56-month project with a budget of € 146 million, 75% of which is public funding. This is a colossal amount if you consider that a project labelled by Skywin generally has 3 to 5 M€. This public investment is important because it allows the private partners to take risks while keeping the work of the personnel assigned to aerospace research and thus avoiding the flight of talent to other sectors of activity. The Administrative steering of the project was entrusted to our cluster for the transition from phase 1 to phase 2. This steering is done in agreement with Safran Aero Boosters, in charge of coordination.
In addition, the project mobilizes now for the third phase 172 full-time equivalents. The objective of WINGS is to enable our aerospace industry to maintain its R&D efforts at low TRL levels (2, 3 and 4) with a view to designing a low-carbon aircraft by 2035 (which implies a 30% reduction in fuel consumption per

passenger) and a carbon-neutral aircraft by 2050, in accordance with the Paris agreements.
Could you tell us about the research themes of WINGS?
S.G. Six themes have been defined:
- Aerostructure, - Propulsion,
- Communication systems, - Materials and processes, - Digitalization and digital simulation, - Industry 4.0.
For example, the “propulsion” theme focuses on the development of new decarbonised modes with hydrogen or sustainable alternative fuels. Similarly, the “digitalisation and digital simulation” theme focuses on virtual testing and digital continuity. In 2024, the main activities of the WINGS project were presented at the JEC international trade show (March) and at the Aeromart Montreal event (May).
What about the future prospects for WINGS?
S.G. We are more than four-fifths of the way through the project, which will be completed by the end of June 2025 for phase 3. We’ll then be in the middle of the Paris Air Show 2025, where we’ll be presenting the entire WINGS project.
To date, the main results are as follows:
1 Company created 22 Projects submitted 29 Patent applications 20 Scientific publications.
Ultimately, we expect to have 700 deliverables and we expect to increase the TRL level of the research projects with a view to their subsequent integration into projects such as Clean Aviation, Horizon Europe or Regional projects in line with the six WINGS research themes. This is crucial to initiate R&D with a more industrial vocation for results expected by 2030-2035.
Let’s come back to the “space”, “UAV” and “defence” sectors… E.P. For more than 50 years, the Walloon space sector has been an important part of the Belgian sector, which ranks 5th in Europe in terms of investment both in research and in the space industry (305 million euros a year).
The Walloon space sector includes 40 active players who generated a turnover of 300 million euros in 2022 and provides more than 2,000 direct jobs.
The “space” sector is divided into seven main areas: the ground segment; launchers and space vehicles; satellites; instruments (for Earth observation); testing of space equipment; groundbased satellite applications; space science which covers scientific missions and exploration.
In 2022, our cluster has developed a roadmap to more actively support two major space value chains:
• The Earth Observation industrial chain (bringing together more than 25 actors) including the Upstream and the Downstream Segment and cybersecurity dimensions,

• The space transportation, in its “reusable launcher” segment which brings together more than 15 actors. Regional support and public funding are provided since 2023 to complement important industrial investments in these two sectors.
At the same time, Research Centres and Universities will be structured through the Joint Research Institute for Space (JRI4Space) to jointly develop these fields by pooling equipment and supporting more than 30 theses.
The results of these industrial and scientific projects are expected by 2025 to place our region among the most active European Regions in the field of New Space.
The “drone” sector is not yet in a mature phase from an industrial point of view. The cause is essentially regulatory: the public authorities have not yet completely transposed the relevant European regulations into local law, which is delaying the development of the professional drone sector. For example, it is not yet allowed in Belgium to operate drones that can be flown beyond direct vision. In the meantime, synergies should be developed between drones and satellites to cross-reference data at these two Earth observation scales.
Despite these legal and administrative issues, the drone sector is strongly growing in Wallonia. It mainly revolves around the following activities:
• Development of on-board applications, which can be closely linked to on-board applications in space;
• Development of ser vices of all types for industry and the public sector;
• Machine design for various applications;
• Design of on-board electronics;
• Autonomous flight;
• Pilot training;
• Diversified testing facilities.
For its part, the “defence” sector has once again become an essential sector with the war in Ukraine. This situation has cre-

ated a new dynamic and a renewal of the R&D projects devoted to it, some of which are supported by the European Commission. Furthermore, Skywin has concluded an agreement with the MecaTech Cluster to coordinate together this sector, whose increasingly complex weapons systems integrate land, air and UAV armaments.
The Walloon sector devoted to Defence and Security is a historical sector resulting from the metallurgical and mechanical skills acquired in the 20th century. It is still a growing sector in Wallonia. It brings together several large companies (Belgian and international) as well as an extremely dynamic network of SMEs that are constantly developing new skills.
The Defence and Security activity focuses on the following areas:
• Structures (metal and composite, shielding) for militar y aviation and land armored vehicles;
• Military aircraft engines (production and MRO);
• Maintenance for military aviation (planes and helicopters);
• Complex Systems integration;
• Militar y drone system (sensors, secure operating systems, remote control, etc.);
• Weaponry;
• Weapon boarding system on-board air carrier (pod) or ground (turret);
• Secure communication system for militar y mission aircraft (Awacs, maritime patrol, etc.);
• Embedded electronic systems according to militar y and civil qualification.
Key figures of the Skywin cluster
- 145 members
- 101 projects labelled since 2007
- More than 300 M€ of total project budget.

A research centre operated by the University of Liège, the Liège Space Centre (CSL) is employing 100 people and leading almost 60 projects for an annual turnover of €19 M. It has the advantage of being a non-profit research organisation, with a funding from industrial contracts and R&D collaborations.
Founded in 1959 as part of the Astrophysics Department of the University of Liege, the CSL owes its existence to its forerunner, the ESA, which wanted to have tests carried out and scientific optical instruments calibrated. Its reputation soon gained momentum and it became, from 1976, the chief centre for tests coordinated by the ESA. All scientific optical satellites had to undergo all their spatial qualification testing at CSL. These tests are carried out, specifically, in very large vacuum chambers that can reach up to 6.5 m in diameter, and even larger in a couple of years thanks to a major building extension! All large space integrators as well as numerous instrument primes are assigning to the CSL the responsibility to fully calibrate their instrument or to support them by providing Ground Support Equipment and facilities for the execution of qualification testing.

As a complement to these tests, the CSL designs optical instruments for use in space for ESA, NASA or JAXA with the support of BELSPO or through industrial contracts. It also develops thermal, mechanical and electronic engineering expertise in conjunction with the manufacture of these instruments. Finally, the CSL forms technological partnerships for R&D projects with Walloon and European industries as well as with other research centers. The aim of these upstream research projects is the development of technologies that can be used in space.
The CSL is involved in numerous scientific space missions, with a peculiar focus on ultraviolet imagers for heliospheric missions and for solar wind missions: a better understanding of our sun dynamics and the propagation of sun particles is the foundation of life on earth, summarized by the so-called space weather! The CSL has


indeed over the last decades developed a deep expertise in the engineering of sun-watching instrumentation and auroral imagers with the scientific expertise of the Royal Observatory of Belgium. Following the Extreme UV Imager (EUI) for Solar Orbiter, the CSL is now involved in the VIGIL ESA mission, with the NASA instrument called JEDI. JEDI (Joint EUV coronal Diagnostic Investigation) is a next-generation multi-thermal EUV Coronal Imager to study extreme space weather events and answer fundamental questions about the Solar Wind. The space weather forecasting is an essential tool for warning the astronauts against radiation flux but also the satellites offering daily services like navigation or telecommunication.
Amongst the skills of CSL, optical calibration plays an important role. CSL is highly involved in the qualification and calibration of JEDI in the extreme UV. Since a couple of years, CSL runs a suite of calibration for a very complex space instrument called 3MI, mounted on board MetOp Second Generation: a EUMETSAT’s, next generation of polar-orbiting satellites. The primary objective of the 3MI mission is to provide high quality imagery of aerosol variables for climate records, aimed at an air quality study!
Since more than 60 years, CSL improves his expertise to deliver space instrumentations that help understanding the universe, our planet earth, and its connection with the solar dynamics for a safer life on earth.

Centre spatial de Liège
Université de Liège
Liège Science Park
Avenue du Pré - B-4031 Angleur Tel.: +32 (0)4 382 46 00
Email: shabraken@uliege.be
http:// www.csl.uliege.be

Bridgestone Aircraft Tire Europe, a member of the Bridgestone Group, a global leader in tires and rubber building on its expertise to provide solutions for safe and sustainable mobility, employs 200 people in Belgium and generates annual sales of more than €120 million. The company is the market leader in commercial aviation in the Europe, Middle East and Africa region.
Created more than 55 years ago, the Belgian aircraft subsidiary of Bridgestone Corporation, supplies new and retread tires for the majority of the models of commercial aircraft. Aircraft tires perform under extreme conditions, repeating takeoffs and landings, supporting and enduring the heavy weight and high speed of the aircraft. What’s more, an aircraft tire can carry a load of more than 30 tons and has to withstand a speed of 350 km/hour on take-off. In other words, it has to meet the requirements of an F1 car and civil engineering. It is therefore a highly technical tire, and its robustness must be beyond reproach. When it’s worn, it can be retreaded multiple times: first the casing goes through various tests such as shearography, leak detection system, then it’s buffed, reinforced by fabrics and then fitted with a new tread. Each new life allows the tire to make between 300 and 400 additional landings.
Thanks to this exemplary recyclability, Bridgestone is developing solutions to support OEMs (Airbus, Boeing, Embraer…) and airlines (Qatar Airways, Emirates, Turkish Airlines, Lufthansa, Wizzair, Ethiopian Airlines, etc.) in maximising flight safety and reducing their CO2 emissions. Developed 100% in Frameries (Belgium), the easytrack solution uses the barcodes and QR codes attached to tires to locate them throughout their life cycle, eliminating all paper-based maintenance procedures and accurately tracking each tire part, which has a unique serial number. Another solution, the result of a collaboration with Japan Airlines, is a tire wear prediction model. An algorithm designed by Bridgestone uses data communicated by the aircraft to predict when a tire will need to be demounted. This has two advantages: it avoids overstocking and flight interruptions due to lack of foresight.
Bridgestone has also developed the FOD solution for foreign object damage. This refers to any foreign object such as a maintenance tool, an aircraft part, etc., with all the risks for the aircraft that a tear in the tread entails. This innovation is accompanied by training courses and consultancy services for airlines and airports on the risks associated with FOD. It has even drawn up a map of all the world’s airports to raise their awareness, and suggests they organize anti-FOD patrols and install sensors to detect and collect those foreign objects.

method, an AI system to improve the reliability of non-destructive tests using shearography, the use of digital twins to model tire behaviour, etc.


Today, Bridgestone enthusiastically promotes its E8 commitment based on 8 values: Energy (for a carbon neutral mobility society), Ecology (to advance sustainable tire technologies and solutions), Efficiency (to maximize productivity through the advancement of mobility), Extension (in favour of nonstop mobility and innovation), Economy (to maximize the economic value of mobility), Emotion (to inspire excitement and spread joy to the world of mobility), Ease (to bring comfort and peace of mind to mobility life), and Empowerment (to contribute to a society that ensures accessibility and dignity for all). Bridgestone Aircraft Tire Europe is setting an example: its CO2 emissions have been reduced by 50% compared with 2011, and 75% of its tyres are already sustainable, as they are made from recycled and renewable materials. Two concrete examples of its determination to make air mobility and society more sustainable.
Bridgestone is also working to reuse all end-of-life waste such as retread powders that can be reused under Belgian railway tracks. In addition, the Frameries plant is the Group’s pilot plant for most manufacturing innovations related to aircraft tire retreading: an ultrasound system for detecting micro-leaks, fully automatizing certain specific retreading processes, a new nitrogen curing

Bridgestone Aircraft Tire (Europe) SA
Route de Bavay
B-7080 Frameries
Tel.: +32 (0)65 61 11 00
Email: jean-philippe.minet@bridgestone-bae.com
https://www.bridgestone.aero

What are the key figures of the TWEED cluster?
Active for 15 years, TWEED created in 2022 the H2O cluster, which is complementary to our initial field of expertise: renewable energy. Today both clusters gather 244 members of the energy and water sectors in Wallonia & Brussels (industrialists, research centers, design offices, universities, etc.), with the mission to pave the way for the setting up and the implementation of high quality and industrial-size projects for sustainable production, exploitation and use of renewable energy & water.
Could you tell us about your priority innovation area devoted to hydrogen?
Launched in November 2022, the Belgian Hydrogen Council brings together the Belgian H2 ecosystem of TWEED (H2HubWallonia) and its Flemish counterpart, WaterstofNet, to create synergy between all regional and federal initiatives on hydrogen. Furthermore, TWEED signed a Convention with Morocco to gather competences around new alcalin electrolysers projects and factories. Eager to maintain Belgium’s competitive advantage in the development of a competitive green H2 value chain, we are considering partnerships between Colruyt BESIX and John Cockerill in HyOffWind, together with cross-participation in the boards of TWEED and Waterstofnet. TWEED is also part of the HYPOP, HYdrogen Public Opinion and acceptance project (2023-2025), which is supporting the hydrogen deployment in Europe, enhancing the involvement of citizens and providing guidelines to increase trust in hydrogen implementation. This axis of innovation is completed by three other axes: Energy Communities on smart grids, renewable heat and Circular Water.
Could you tell us about the SOCCER and AMORCE projects?
They are both subsidized by the Walloon Energy Administration as part of the Living Lab program and the CERACLE portfolio. AMORCE focuses on the pricing of 2 pilot communities (in
partnership with ULiège), their socio-economic Implications, the implementation of communication protocols, the activation of the electric discharge at the right time, business plans and business models according to the typology of the buildings and networks. A pilot was launched in summer 2023 in Liège. For its part, SOCCER aims to set up 3 social energy communities in Ans and Verviers and to measure their impact on the inhabitants of social housing. The goal is to make information accessible and to raise awareness about the proper use of energy. The first pilot is running in Ans.
What is the DIS axis 4 “Energy-Building” of the Walloon Smart Specialisation Strategy (S3)?
This axis aims to bring together all the actors concerned and to create a portfolio of projects (and actors) in order to meet the challenges facing the energy and building sectors. With this in mind, the Cluster manages, together with the MecaTech competitiveness cluster, the 4 Strategic Innovation Initiatives (SII) of the DIS 4, part of the 19 SII supported in 2023 by the Walloon Region. Our objective is to bring these 4 SIIs to life, each with a lead partner. This implies linking the priorities of Walloon industry for the next 6 years with future research programming, funding opportunities and calls of projects. These bottom-up methodology should be based on a common roadmap encompassing energy communities, hydrogen, district heating, mobility and building renovation as an integrator of technological solutions, in co-construction with the other four DIS of the Walloon S3 strategy.
What do you see as the main challenges in meeting environmental and sustainable development challenges?
As a key element of the energy transition, renewable heat distribution plays a strategic role in reducing CO2 emissions and improving the energy efficiency of European cities. Wallonia has a high potential for deep and medium geothermal capture. Following the 2022 call for projects launched by the Walloon Region (32 projects selected for an amount of €30 million), Wallonia launched another call for projects at the end of 2023 to support the deployment of ambitious district heating projects. 12 projects were selected for nearly €29 million and must be operational by the end of 2026. By the way, TWEED has launched a new ecosystem, Heat2Net, based on CERACLE’s portfolio management expertise. It will focus on the whole chain value, with an emphasis on the recovery of waste heat and thermal energy share within industrial sites. Moreover, green gas networks, renewable hydrogen, sustainable energy sharing and management of our water are also at the heart of the short-term issues. The players involved will have to create synergies in order to reduce by 55% our CO2 emissions by 2030, and by 100% by 2050. All innovations are welcome to make Wallonia and Belgium more autonomous and cleaner in energy, now!
What are the key figures for the WEL Research Institute?
Formerly known as Welbio (Walloon excellence in science and biotechnology), the WEL Research Institute added, in 2022, a second department to its historical department in life sciences to support strategic research in engineering sciences, chemistry and physics. It is an inter-university institute subsidized by the Walloon region, with 51 investigators and 350 laboratory members, which promotes scientific excellence and the translation of the results for a societal and economic impact in health and sustainable transition. Since 2022, its funding from the Walloon region was increased to €24.75 million annually. The international reputation of our investigators is illustrated by over 800 publications in prestigious journals and more than €40 million received in the form of prizes and European or international funding. Our investigators are also behind 42 patent applications with gross industrial income of €9.5m and the creation of 6 spin-offs that have raised €84m in funds and created 32 jobs (figures for 2022).

(ULB) for treatment of severe neurological conditions; and Santero Therapeutics, founded by Abel Garcia Pino and Cédric Govaerts (ULB) for the development of new antibiotics to address the emergence of antibiotic resistant bacteria.
What does the Bridge Fund programme involve? It concerns cases of intellectual property generated by our investigators that has not reached a sufficiently high TRL level. The aim is therefore to fund initial stages of development to attract the attention of an industrial company or investors. Since the creation of the institute in 2009, 7 projects have been supported by the Bridge Fund, with a total budget of €900,000. The coming years should see a significant increase in the number of opportunities to be supported, given the increased funding from the Walloon Government.
What partnerships have you developed to increase the number of opportunities?
How does the WEL Research Institute support strategic fundamental research in the Wallonia-Brussels Federation?
Strategic research aims at increasing knowledge and making unexpected discoveries, as well as translating results into beneficial societal and economic impact. That’s why our investigators can be allocated up to €1.4 million over 4-year periods to help them develop ambitious research programmes that address critical unmet needs in their fields and achieve scientific breakthroughs that can be socially beneficial.
What support do you offer researchers to help them integrate the industrial value-added approach into their work?
The WEL Research Institute provides researchers with a framework and support to help them transition their results from the laboratory to the marketplace - an uncharted territory for most of them. With this in mind, we organise several meetings a year to identify unexpected results that could be the subject of a patent application, and to develop strategies to transfer the results to industry, whether by creating a spin-off or granting an operating licence. For example, Pierre Coulie and Sophie Lucas (UCLouvain) developed a therapeutic antibody to boost the immune response against cancer which is now investigated in phase II clinical trial in solid tumours by AbbVie. I would also like to mention 3 of the most recent spin-offs: THERAtRAME, the result of work by Alain Chariot, Francesca Rapino and Pierre Close (ULiège) which develops new targets linked to transfer RNA for the treatment of cancers; NeuVasQ, based on the work of Benoit Vanhollebeke
Our core partnership is with the 5 universities in the Wallonia-Brussels Federation, whose investigators have a dual affiliation (university and WEL Research Institute), and with their KTOs (Knowledge Transfer Offices). We also maintain close links with the Walloon competitiveness clusters and with companies in Wallonia and beyond. Our aim is to sound out their needs and propose an appropriate technological offering based on the work of our investigators.


What are the key figures for research at UCLouvain?
The 3,600 researchers at UCLouvain, 30% of whom are international, represent an impressive pool of knowledge and skills. The ERC Grants that they win each year are a very good barometer of the quality of their research. Since the creation of these grants, 61 have been awarded to our scientists.
But research at UCLouvain also means that every year 300 doctoral students - half of whom come from abroad - defend their theses, testifying to the sustained activity in high-level research and advanced training. With its 23 research institutes, our university covers a wide range of scientific disciplines. These institutes are driving forces behind interdisciplinary and innovative research. The 51 technology platforms that these institutes manage are at the service of excellence in research, teaching and the regional economy. UCLouvain collaborates with more than 500 institutions around the world, further strengthening its scientific network and global impact. These collaborations cover a wide range of fields, from fundamental to applied research. Each year, UCLouvain is involved in more than 2,500 research projects and produces more than 3,500 publications, mainly in international peer-reviewed scientific journals.
These figures reflect UCLouvain’s importance as a national and international research university, as well as its role in training new generations of scientists and innovators. All this research and results are made possible by an annual investment of 316 million euros in research, from various sources such as European, national and private subsidies. But also, and above all, thanks to the investment of every member of our community, who work every day to make possible and push back the limits of research excellence at UCLouvain.
What are the areas of research excellence at UCLouvain?
As a comprehensive research university, UCLouvain develops research in a multitude of fields and societal challenges. What’s more, these
days, excellence is the key to obtaining research funding. Excellence is therefore omnipresent in our research institutes in the health sciences, science and technology, and the humanities and social sciences.
Sustainable development and the ecological transition are at the heart of our university’s concerns and therefore of its research activities. UCLouvain is proud to be ranked 67th (first Belgian university) in the latest Time Higher Education (THE Impact) ranking. This ranking assesses the performance of universities worldwide in relation to the United Nations’ Sustainable Development Goals (SDGs). UCLouvain’s spectacular leap (50 places) in this ranking illustrates the effectiveness of the university’s sustainable development strategies. One of the strengths of our university highlighted by this ranking is innovation and the development of our research (patents, spin-offs, etc.) in relation to transition. UCLouvain has a major ethical duty and societal responsibility to commit to a transition towards a sustainable society. It has a duty to be at the forefront of societal thinking in this area. This is what we are doing, with cutting-edge research that is having a positive impact on our society in transition.
Could you give us a few examples of research projects underway at UCLouvain? Among the many research projects being carried out at UCLouvain are the Horizon Europe projects under the European Union’s Framework Programme for Research and Innovation for the period 20212027. To date, we have obtained funding for the coordination of 7 projects of this type, which is also an excellent indicator of the quality of our researchers and the projects they are developing in the context of transition and service to society. To be selected by Horizon Europe, projects must contribute to achieving the United Nations’


sustainable development goals and stimulate competitiveness and growth in the EU. Two examples are DeepHorizon, which aims to improve soil quality, and BE-SAFE, an interdisciplinary, patient-centred approach to combating dependence on sleeping pills.
What are UCLouvain’s main research partnerships?
UCLouvain collaborates with more than 500 institutions worldwide. Each of the 3,600 scientists who make up our university is developing their network and generating new collaborations and partnerships with the aim of going ever further in the understanding of their field of research. It is therefore difficult to rank these numerous and complex partnerships in extremely varied fields. Examples include our partnerships with the Massachusetts Institute of Technology (MIT) and the European Space Agency (ESA). The MIT-UCLouvain Seed Fund supports exchanges of researchers, professors and research students between the two institutions. The agreement covers all faculties at MIT and all sectors at UCLouvain. With the ESA, we have several projects underway, including the SEN4STAT (Sentinels for Agricultural Statistics) project, which aims to improve agricultural statistics using satellite Earth observation.
Could you tell us about LouvainTRANSFER’s activities?
LouvainTRANSFER is the knowledge transfer arm of UCLouvain. Its raison d’être is to ‘connect Research and Society to build tomorrow’s world together’. Its mission is to offer a wide range of services and expertise, to create and strengthen the link between researchers and socio-economic players, and to support them in transforming their research results into a socio-economic impact, thus sustainably amplifying the virtuous circle of ‘research - valorisation - research’. LouvainTRANSFER supports the researchers from the identification of ideas through to exploitation of research results in the form of licenses, spin-offs or new research projects.
What are the most recent spin-offs created from the work of UCLouvain researchers?
UCLouvain’s two science parks, including the largest in Europe, are home to 282 companies, including a number of spin-offs based on the work of our researchers. Our university currently has 68 spin-offs in operation. Among the most recent are:
- Genko (Rombio) in the field of ar tificial intelligence, to increase effectiveness of the production of pharmaceutical products;
- NeGIO Therapeutics, which aims to develop treatments in the field of oncology;

- Stellaris, which offers an original method for screening small molecules and cellular markers;
- Biocsol, which is developing new-generation pesticides that are more effective and environmentally friendly;
- Thermo Power in the field of thermoelectricity;
- Balencio, a platform for managing the development of an organisation’s human potential.
What is your assessment of Louvain4: UCLouvain’s cross-disciplinary research initiative?
Aware of the need for a global and transdisciplinary approach to studying certain societal issues, UCLouvain launched the Louvain4 consortia in 2013. These consortia bring together researchers from all sectors of the university to focus on major contemporary issues such as energy, education, space, nutrition and migration. By crossing the boundaries between disciplines, they encourage reflection, debate and new collaborations. In 10 years, the number of Louvain4s has tripled, thanks to the initiative of researchers at our university who want to get involved and contribute to the implementation of strategies to meet today’s societal challenges. The Louvain4s greatly facilitate exchanges, both within the university and with external partners, who can clearly identify who to contact to collaborate on the theme that is at the heart of their concerns.
What awards have UCLouvain researchers received in 2024?
Our researchers are widely recognised and rewarded each year with numerous prizes and awards at both Belgian and international level. This year, for example, Profs David Alsteen and Tanguy de Wilde d’Estmael, and Profs Sandra Soares Frazao and Valérie Swaen were awarded the Royal Academy of Belgium Prize in Physics, Political Science, Engineering Science and Management Science respectively. Prof. Ralph Dekoninck, an art historian, was awarded the Francqui Chair at the University of Liège for his work on images and violence.
In the field of health, a young researcher from the Institut de Duve, Dr Jingjing Zhu, was awarded the Baillet Latour Biomedical prize this year for her work on improving the effectiveness of cancer immunotherapy. At the Institut de Duve, Prof. Miikka Vikkula and Prof.Laurence Boon were awarded the prestigious Gagna & Van Heck prize for their work on vascular malformations. As we celebrate the 50th anniversary of Christian de Duve’s Nobel Prize, these prestigious awards bear witness to his legacy and the synergy between scientific excellence and service to society that is so dear to UCLouvain.

As part of the Modelling division (MODL) of the Institute of Condensed Matter and Nanosciences (IMCN) at the Université catholique de Louvain (UCLouvain), the Gian-Marco Rignanese Research Group is using first-principles simulations and machine learning to investigate and design advanced materials for energy storage and production, electronics and optics.
The Gian-Marco Rignanese Research Group consists of approximately fifteen researchers from ten different nationalities. They typically publish between 10 and 15 scientific articles each year. On average, the group undertakes 5 to 6 projects annually. Their expertise lies in atomic-scale simulations based on first principles (Density Functional Theory, Many-Body Perturbation Theory, Density Functional Perturbation Theory, Car-Parrinello Molecular Dynamics) and machine learning. They are involved in the development of various open-source codes and tools, such as ABINIT (www.abinit.org), ATOMATE, JOBFLOW, and the PseudoDojo (www.pseudo-dojo.org).


In the last decades, the advancement of such codes and tools, coupled with the enhanced capabilities of supercomputers, facilitated the development of high-throughput simulations and the expansion of open databases. In that prospect, the Gian-Marco Rignanese Research Group is collaborating to Materials Project (USA, www.materialsproject.org), the Materials Cloud (Switzerland, www.materialscloud.org) and NOMAD (Germany, www.nomad-lab.eu). Gian-Marco Rignanese is also among the leaders of the OPTIMADE consortium (www.optimade.org) which aims at making materials databases interoperational by developing a common REST API. The common objective of the developers of these databases is to expand them further to train machine learning algorithms and improve their ability to predict the right materials for a given application.
At the time being, the Gian-Marco Rignanese Research Group is leading the Materials Informatics Active-Learning Platform for ElectroCATalysts (MIALP4ELCAT) WEL-T project which is driven by the urgent need for environmentally sustainable alternatives in chemical production. One potential solution would be to utilize abundant molecules like water, carbon dioxide, and nitrogen in a fossil-free circular system powered by renewable energy.
However, the development of highly efficient, selective, and stable electrocatalysts is essential to replace current methods reliant on fossil fuels. The MIALP4ELCAT project aims to address these challenges by creating a materials informatics active-learning platform for designing new electrocatalysts through accurate machine learning models trained on computational and experimental data.
The Gian-Marco Rignanese Research Group also collaborates with ABEE to improve the performance of batteries. The focus is on the interface between the battery electrodes and the electrolytes. The research combines multi-scale simulations, machine learning, and the collection of experimental data to develop a digital twin of the battery and of the production process.
The Gian-Marco Rignanese Research Group is also working with IMEC to design better absorbers for solar cells. Another field of investigation is material for non-linear optics. The field of optoelectronics, with applications in communications, energy production, and lighting, faces the challenge of covering the entire electromagnetic spectrum for various uses, including in the laser industry. Conventional devices are limited by the bandgap of the amplifying medium, leading to the need for materials that can convert frequencies through nonlinear optical processes. However, suitable materials are still lacking for parts of the spectrum like the mid- and far-infrared, hindering the development of technologies in these wavelengths.
For the Gian-Marco Rignanese Research Group, the main challenge in materials science lies in the ongoing revolution driven by AI and data management. In particular, generative AI (like ChatGPT) holds great promise for revolutionizing the field by enabling the rapid design and optimization of materials with tailored functionalities. Quite a programme!

Faced with growing demand from industry for services involving simulations and machine learning, Gian-Marco Rignanese co-founded the start-up Matgenix in 2020 following a First Spin-Off funding from the Walloon Region. It’s a great way of making researchers’ skills available without the usual publication constraints.
The traditional approach for designing materials has long relied on a trial-and-error approach where each step of the process, including synthesis, preparation, testing, and validation, is prone to potential failures. This approach not only consumes a significant amount of time but also incurs high costs, making it inefficient and unsustainable in the long run.
Recently, a paradigm shift has taken place with the advent of machine learning. Today, the development of materials, compounds, and molecules has reached new heights of speed and optimization. Matgenix leads the charge with a cutting-edge solution built on three core pillars: harnessing the power of artificial intelligence through machine learning, employing advanced data management techniques, and conducting high-throughput computer simulations rooted in real-world experimental data. These pillars seamlessly intertwine through automated workflows, driven by cutting-edge supercomputing technology. Matgenix delivers unmatched efficiency to clients in verifying operations and extracting invaluable data and insights through the deployment of these automation tools across diverse industrial sectors.
Matgenix supports its customers throughout the entire innovation process, starting from the idea to the concrete realization, production, and commercialization of their new materials and compounds. It helps its customers to define clear and precise specifications. It proposes tailored work plans matching their business goals and schedule. It identifies the best candidates by executing this work plan and continues to support the implementation and up-scaling of their new materials, compounds, and processes.
The development of in-house solutions is also part of the Matgenix service offering. The company develops tailored software solutions for its customers’ applications: machine-learning models, scientific workflows, automated simulations, ... It analyzes their needs during its align phase. It then designs the architecture of their solution with high-quality standards and finally, it implements the software into their systems. After the deployment of the software, it provides support and maintenance for using or improving their software. With this in mind, Matgenix has developed the open-source software turbomoleio in collaboration with BASF. This new tool facilitates the setup and analysis of quantum chemistry computations.
If Matgenix intervenes early enough, it can help its customers with the ‘design of experiment’ with AI and active learning. For example, Matgenix has developed machine-learning models for Cartier to predict variations in the color of gold and other resulting properties. Matgenix is also active in two Horizon Europe


projects. In NICKEFFECT, it uses active learning and simulation to optimize electrodeposition parameters for Nickel alloys as an alternative to Platinum-group metals. In AEMELIA, Matgenix supports the experimental partners to improve the performance of anion exchange membranes for fuel cells. Other applications are currently being explored: finding new materials-based hydrogen storage solutions for automotive applications using in silico techniques, developing innovative laminated materials for transparent electronics, speciality alloys, chemical and catalytic designs, biomaterials, process optimization, etc. A good way of saving its customers time and enabling them to concentrate on other business ideas.
For the time being, Matgenix’s main activity is service-based, but it has not given up hope of developing software that could be marketed. In addition, it has added a new area of work: extended virtual reality with the digital twin and large language models such as ChatGPT. What remains to be determined is the interface that will enable virtual interaction with generative AI...

A6K | Advanced Engineering Center Square des Martyrs, 1- B-6000 Charleroi Tel. : +32 (0) 479 575 708
Email : info@matgenix.com https://matgenix.com/

Professor at the Ecole Polytechnique de Louvain and President of the iMMC - Institute of Mechanics, Materials and Civil Engineering at UCLouvain, Prof. Aude Simar has set up her own research team to develop new materials using innovative manufacturing processes, in particular 3D printing. Her work should lead to new aluminium alloys that are widely used in the aeronautics and aerospace industries.

It all began in 2016 when Prof. Simar was awarded a prestigious Starting Grant from the European Research Council (ERC) for the ALUFIX project. The aim of this project, which was completed in 2022, was to develop new aluminium-based self-healing materials and to mitigate damage to existing aluminium alloys. Aluminium is the third most abundant material on earth after oxygen and silicon. It is also widely used in the manufacturing of complex parts for the aeronautics and aerospace industries, as well as road transport (truck parts) and satellites. However, the manufacturing of aluminium, the result of the transformation of bauxite, is very energy-intensive, even if some of the aluminium produced is recycled.

According to the Waypoint 2050 study, achieving the 0-carbon objective will not only involve replacing fossil fuels: we also need to take action on industrial processes and invent new technologies. That’s why Prof. Simar’s team is closely studying Laser Power Bed Fusion (LPBF), a technology that involves depositing a layer of powder and melting it with a laser in the required location - an interesting technology for the self-healing of high-strength materials that suffer from a large number of cracks and porosity. Here, the


© Prof. Simar’s research group
part healing acts as a repair process, avoiding the need to recycle the entire part produced. Just as the skin heals itself, this bio-inspired technology has been widely developed for polymer materials used in the automotive industry but is only in its infancy in what aluminium alloys are concerned.
Can metals be healed?
This is where Prof. Simar’s team comes in. The aim is to apply LPBF technology to metals by coupling it with 3D printing technology for non-destructive visualisation of the material being studied. The principle is simple: a material is deliberately damaged and then its behaviour is studied at the ESRF synchrotron in Grenoble, France. After an initial observation phase, it is healed by a heat treatment that allows the low melting point part of the aluminium alloy to turn to liquid keeping the part structural integrity. The cracks are then filled with just enough liquid to ‘seal the breach’.
Are these alloys strong enough?
Prof. Simar’s team is involved in a number of research collaborations, starting with HAMAAC, an M-ERA-NET project that began in 2023 with European industrial and research partners in the Czech Republic (CEITEC, CACTUX, Thermo Fisher), BordeauxFrance (Thermo Fisher), Belgium (Any-Shape, a company active in additive technologies for industrial applications). The aim of the project is twofold: to develop a high strength self-healing aluminium alloy and to develop a procedure and tools for observing at a large extend of scales this new self-healing aluminum alloys using tomography (3D imaging). This will make it possible to better characterise these new materials and facilitate their healing, down to a few micrometres.
Within this framework, Prof Simar’s team is working on the development of another innovative technology: the production of high-strength, light alloys. An initial material, developed from aluminium and magnesium, was the subject of the ERC-ALUFIX project. The only problem was that it was not strong enough, with a yield strength of only 150 MPa. In the framework of the HAMAAC project, a second alloy in which aluminium and magnesium are supplemented by zirconium was developed, called the “Almazium”. The result: increased strength equivalent to 400 MPa, with the similar healing capabilities. What’s more, this alloy loses none of its mechanical properties when heated for healed. A patent was filed in February 2024.



How can we make 3D printed larger parts healable? And from recycle chips? On the strength of these promising results, Prof. Simar has obtained funding from the WEL Research Institute for the RESSusCItAM project. Launched on 1 October 2023 for a period of 4 years, this project is based on 3D printing technology using friction. Its ambition is to apply the healable material strategy on a larger scale, replacing the powder used in LPBF technology. The LPBF process is limited to small parts (typically smaller than 500 mm) while the friction stir additive manufacturing process allows to build parts as large as any milling machine can build. The process would be greatly

©
improved because, at present, the melting of aluminium residues produces a floating part or “dross”, which generates 20% loss and requires a lot of heating for the melting stage. It would therefore be very interesting to be able to use parts with the dual advantage of being healable and produced from recycled chips. A virtuous circle for circular processes that are more bio-inspired and therefore more respectful of the environment.


iMMC - Institute of Mechanics, Materials and Civil Engineering
Place Sainte Barbe 2 - B-1348 Louvain-la-Neuve
Tel.: +32 (0)488 56 03 05
Email: aude.simar@uclouvain.be https://uclouvain.be/fr/repertoires/aude.simar
The Institute for Health Research at UMONS brings together researchers and practitioners from diverse scientific backgrounds. Biologists, clinicians, pharmacists, chemists, physicists, engineers, psychologists, and sociologists combine their expertise to advance research in the field. The goal? To improve human health, both on an individual and community level. This ambitious mission relies on strong collaborations with various stakeholders in the sector, creating a dynamic network dedicated to collective well-being.

Physical and mental health is crucial in today’s society. The increase in life expectancy, overweight issues, neurodegenerative diseases, human development, cancer, and well-being are all challenges we need to address.
In this context, scientific and technological development in the field of health requires enhanced collaboration between the various researchers at the UMONS Health Institute and operators in the hospital and industrial sectors.
The research focus areas of the institute are as follows:
• BRAIN DISEASES. Brain diseases are approached at the Health Institute in a multidisciplinary and intersectoral manner. Emphasis is placed on collaborations with academic, industrial, and hospital partners, combining cutting-edge technologies with preclinical, in vitro, in vivo, and clinical expertise.
• ORGAN CROSSTALK. The goal is to improve understanding of the dialogue between tissues and organs in a holistic approach to the functioning of an organism in both normal and pathological conditions. The research approach is translational and combines clinical, in vivo, and in vitro studies.

• STRESS & EMOTIONS. The objective is to link the human brainmind and health, investigating the consequences related to physical and/or psychological health or well-being issues on cognition.
• RESEARCH AND DEVELOPMENT OF BIOMARKERS AND DRUGS. The goals include identifying biomarkers for diseases and toxicities, developing tracers for diagnosis and monitoring, as well as creating medications for treatment.
• CANCER. This focus aims to foster collaboration among different research teams working closely or remotely on cancer-related themes, to share knowledge as well as technical expertise in both experimental research (cell biology, molecular biology, biochemistry, etc.) and human sciences (psychology and support for patients and their families facing illness, etc.).
The institute primarily develops its activities through collaborative research projects. These projects are based on interdisciplinarity and are structured around a partnership logic with all societal stakeholders (industries, services, research centers, local authorities, government institutions, etc.). These projects facilitate the establishment of partnerships at the provincial, regional, federal, European, and international levels.
Here are some examples of the Health Institute’s projects:
• PANOPP (Wallonia / Win2Wal)
Characterization of the epigenetic regulator Prdm12 in mature nociceptors to validate it as a target for developing new therapeutic approaches for pain.
• PROTHER-WAL (Wallonia)
Establishment of a proton therapy platform in Wallonia, which will serve as an internationally renowned inter-university research center, an effective care center, a training center, and a hub for technological and industrial developments.
• TRADIQUAL (FWB)
Improvement of the quality and safety of traditional medicine products sold in the markets of the three main cities of the Democratic Republic of Congo.
• CardiOnco (Wallonia / Win2Wal)
Development of a tool for early detection of cardiovascular complications induced by chemotherapy. The technology will combine recordings of kinesiocardiography (KINO, HeartKinetics) with continuous blood pressure measurement.
• FC-RELAX (EU, MSCA)
FC-RELAX aims to enhance understanding of field-dependent relaxation processes and to exploit the full potential of NMR relaxometry for various biomedical applications and material characterization.
• MS-DEV&MA (FWB/ARC)
During Alzheimer’s disease, knowledge related to the meanings of words and objects is also affected. MS-DEV&MA studies the underlying processes of semantic memory formation in childhood and its deterioration during Alzheimer’s disease. This project has strong theoretical and clinical applications.
• TRIAD (FWB-Excellence of Science)
Study of the transmission of resilience to stress within triads (mother, father, and child) to identify the biobehavioral dynamics and factors contributing to its transmission within families.

• URGENT (EU + FWB; EJP-RD rare diseases)
This project addresses the issue of gender in professions related to early childhood. It aims, on one hand, to understand the implications of fathers’ experiences on early child development, and on the other hand, to study fathers’ involvement in care settings and examine the relationship between professionals and fathers.
• PodoMITO (EU + UMONS/UNamur; MSCA Cofund C2W)
Study of the dysfunction mechanisms of podocytes in the context of glomerular diseases, specifically focusing on mitochondrial bioenergetic adaptation. This project will deepen the understanding of focal segmental glomerulosclerosis and improve its diagnosis.
>>> More information : https://web.umons.ac.be/sante/en/
UMONS & Health’s partnerships
UMONS is also active in the field of health, notably through teaching and research chairs. For examples:
- UMONS and “Centre Hospitalier de Wallonie-Picarde (CHWapi)’, Research Chair named “Hospital Transition”.
- UMONS and « Hôpital EpiCURA », Research Chair named “Innovation Health”.
- UMONS and iCare, the chair will be dedicated to predictive medicine.
- UMONS Chair on Ar tificial Intelligence, Digital Medicine, Innovation and Personalised Healthcare.
- UMONS and “Amis des aveugles”, Chair in the field of low vision.
UMONS also maintains close partnerships with a number of hospitals in Wallonia, including: Helora Mons Kennedy site, CHwapi, EpiCura, CHU de Charleroi... Finally, we can also mention the launch of the Master in Medicine, in collaboration with ULB, for the 2024-2025 academic year.


By Prof. Carine MICHIELS, Vice-Rector for Research and Libraries, University of Namur
At the Heart of Europe: an exceptional setting
Namur, the capital city of Wallonia, is a lively and multicultural city of around 110,000 inhabitants. It is Wallonia’s most accessible city located at the intersection of a large rail and road network and near three international airports. Namur sits at the confluence of the Meuse and the Sambre Rivers and is dominated by a 17th century citadel built by the famous military architect Vauban.
The university campus is a vibrant place only a ten-minute walk from the train station, ideally located next to the city’s pedestrian zone and high street with easy access to shops, restaurants, and cultural venues.

The University of Namur’s mission is to help its students to become responsible members of society. It encourages extra-curricular activities and social, humanist and civic projects that contribute to the development of a democratic, multi-cultural and supportive society.
The University of Namur promotes scientific research which combines excellence with a truly long-term vision. It encourages interdisciplinary approaches and a thorough comprehension of the human and social implications of science and technology.
The University also engages with society. The University of Namur aims to sow the seeds of the cultural, social, political and economic development of the region it is part of. It confronts and evaluates major social problems, especially those associated with inequality.
Meaning and a focus on the human person are the guiding principles at UNamur in order to give human-centered and ethical teaching. The students are trained to take responsibility. The commitment of the professors to their teaching role is a priority, hence, the students are central to their concerns.
With 40 different programs at the Bachelor, Master and Doctorate levels, the UNamur welcomes over 4,900 students in six Faculties: Arts, Law, Economics, Social Sciences and Business Administration, Computer Science, Medicine and Sciences. Its reputation is based on the quality of its education, the availability of its professors and sufficient resources to ensure maximum chances of success for each student: introduction to study techniques, preparation courses, small group work, course materials available on-line, personalized assessments…
The UNamur has redesigned its study programs in line with the European harmonization of Higher Education (“Bologna Process”). The UNamur has widened the choice of its studies to reconcile both specificity and openness to social and human issues. Quality of study in Namur is a first-class advantage for those who wish to discover a university on a human scale at the crossroads of Europe, as part of a study exchange program or to prepare to enter professional life.
The number of international exchange students hosted in Namur continues to rise. Most of these students come from our European partner universities but an increasing number of non-European students now choose the University of Namur as their destination.
Foreign students enrolled in an exchange programme can stay at the International House with our other international students, or share flats with Belgian students. Living and studying together facilitates the integration of the students and helps them to improve their French and other language skills.
In order to facilitate the integration of its international students, the University of Namur offers an intensive two-week programme to help students improve their French and English language skills. They get the opportunity to discover Belgium, Namur and the campus. These orientation weeks are organized before the beginning of each academic year in collaboration with Namur’s various post-secondary institutions, and are very popular.
Since 1989, UNamur students have been encouraged to take part in exchange programmes. At first, only a small number of partner universities were available as exchange destinations. But, over the years, the number of partners has increased considerably and now
includes a number of non-European destinations. Students can spend a term abroad to study in a partner university or take part in an internship, either in the private sector or in a research laboratory of prestigious universities, such as Harvard University, the University of California, Texas A&M, the University of Montréal…
Since 2015, the Erasmus+ International Credit Mobility Programme allows European HEIs to set up mobility agreements with partners from around the world that concern both students and staff members. Thanks to this programme, the UNamur has developed 20 new partnerships with Asian, African and Latin American universities and has organized many teaching and research missions. The University of Namur has received the European Commission “Good Practices” label.

Value-based research: interdisciplinarity as UNamur DNA in research
The mission of every university is, not only to diffuse knowledge, but also produce new knowledge, which requires providing an essential place for research. Our laboratories and research institutes aim to develop quality projects, by resolutely joining collaboration networks at the national and international levels. Whether this research is fundamental or more oriented, it is “meticulous in taking into account the human and social dimensions of science and technology”. Research in Namur aims at balancing ethics and excellence with an internationally recognized strength: the interdisciplinarity. The UNamur research institutes bring together and interweave various skills and expertise around a global topic. This way of functioning favors transdisciplinary collaboration and original approaches for research as well as for teaching. These research institutes are centers of excellence in their fields of expertise, including Energy and the Environment, Materials, Social Sciences and Humanities, Life Sciences and ICT.
Within the 11 transdisciplinary research institutes and the 7 faculties of the UNamur, the researchers develop their projects with numerous

other research teams coming from the 5 continents. Furthermore, UNamur is committed to international development cooperation. This is exemplified by the various research projects deployed with countries from the South.
In 2022, there have been 1089 publications, more than 1000 researchers, with a budget of more than 21 million euros for the newly financed research contracts. Five sectors of excellence have been delineated: Life sciences and health; Society, transition and digital; Heritage, culture and societies; social and economic vulnerabilities; Materials. These five themes gather outstanding researchers and lead the visibility of UNamur for all the research stakeholders, being partner universities and research centers as well as funding bodies.
The University of Namur invests in state-of-the-art equipment grouped in nine transverse technology platforms. These platforms are open to all researchers and to companies willing to perform measures or analyses and benefit from the skills of specific experts.
In November 2022, the University of Namur has become an official member of UNIVERSEH European University: “European Space University for Earth and Humanity”. UNIVERSEH is an alliance of seven young and mature universities from five European countries. It aims to create new higher education interactive experiences for the university community, teachers and students, and for the benefit of society as a whole. Such initiatives will enable broadminded, informed and conscientious European citizens to capture and create new knowledge and become smart actors of European innovation, valorisation and societal dissemination within the Space sector, from science, engineering, liberal arts to culture.

The UNIVERSEH partners are committed to securing new approaches for Teaching & Learning in an evolving world where knowledge and its transmission have never been so difficult to streamline to learners. Student-centered learning, peer-to-peer and collaborative teaching designs will be the cornerstone of UNIVERSEH educational endeavour. It comprises in-person, distance and blended learning within UNIVERSEH collaborative campus, including students’, teachers’ and researchers’ thematic and cultural European mobility. Innovative pedagogical approaches, interdisciplinary and cross-sectoral curricula are key components of our educational approach.
UNIVERSEH relies on a wide range of expertise and already acquired extensive contacts with the space industry and European Space Institutes to rapidly adapt and implement the most relevant Teaching & Learning environment to cover European needs in the area of Space.
UNIVERSEH has been awarded a second 4-year grant from the Erasmus+ programme in July 2023.
The SPACE researchers have an astronomical observatory at their disposal with state-of-the-art instruments such as a large-diameter solar telescope, unique in Wallonia, which allows the sun to be observed safely during the day, giant telescopes for visual observation, and a high-magnification telescope for observing the moon and stars at night.
The Namur institute for Complex Systems (naXys) mentioned above is home to a research pole (pôle de recherche) called ‘SPACE’. The SPACE researchers deal with the modelling of the Universe, on different scales: space debris, Solar System, extrasolar systems, up to the large-scale structures of the Universe. They focus on the non-linear interactions and chaotic dynamics of these physical and

mathematical objects, sharing the tools of celestial mechanics, cosmology, general relativity and modified gravity. Well-integrated into international networks, the SPACE researchers beyond any doubt have the potential to contribute in a complementary way to the further development of space-related research activities of the UNIVERSEH alliance.
Researchers active in both ILEE and NARILIS obtained ESA-funding for their project “Rotifers In SpacE” that aims at understanding how these very small animals can sustain different kinds of stresses such as dryness and high levels of radiations. They appear to be a suitable model system to study the impact of microgravity and ionizing radiation on living organisms in order to develop adequate solutions to the challenges space travelers face or will face in the future. For this purpose, the University of Namur, in collaboration with SCK-CEN (the Belgian nuclear research centre), has launched rotifers into two missions within the International Space Station. The results are still under investigation.
Even though the links with the space-topic might at first sight not be all that apparent, significant contributions to the alliance can also be made by UNamur researchers active in NISM (e.g. by the scientists who work on the development of new types of batteries and of new 2D and 3D coatings as well as nanomaterials with new properties that can be applied in different contexts), in NARILIS (e.g. by the scientists who seek to advance our understanding of the biological effects of radiations at molecular, cellular and whole organism levels), and by scientists active in the Espace philosophique namurois (ESPHIN). Typical of ESPHIN is that it unites natural scientists, life scientists and philosophers who not only deal with research ethics from an interdisciplinary point of view, but also focus on robotics from the point of view of philosophy and science and - not so long ago - were involved in an inter-university project on the life and work of Georges Lemaître, the Belgian physicist and priest known for his contribution to the Big Bang theory.
https://www.unamur.be/en















Created in 2000 in the heart of Namur, the URBM is made up of 5 teams from UNamur and one from ULB. It employs 50 researchers and has privileged access to a BL3 platform. Its basic research activities will generate applications for therapeutic and vaccine purposes.
The URBM focuses its research activities on molecular bacteriology. Caulobacter crescentus, Capnocytophaga canimorsus and Brucella sp. are used as working models to study the functions, structure and interactions of proteins involved in processes associated with the cell cycle, the regulation of gene expression, metabolism and, more specifically for Brucella and Capnocytophaga canimorsus, interactions with host cells and the modulation of the host’s innate immune response. Two groups are also involved in applied research into enzymatic engineering, dietary fiber production and environmental detoxification. More specifically, the URBM studies the functioning of bacteria at the molecular level: their adaptation to starvation and heavy metals, the homeostasis of the bacterial envelope in pathogens and that of environmental bacteria. The unit is also working on the discovery of new defense mechanisms against viruses that infect bacteria: phages.

Several research themes are currently being developed within 6 teams: Bioinformatics, Microbiome, Bacteriophages (Prof. Gipsi Lima Mendez); Brucella cell cycle and infection (Prof. Xavier De Bolle); Heavy metals and response to oxidative stress (Prof. Jean-Yves Matroule); Bacterial cell cycle and stress response (Prof. Régis Hallez); Envelope biogenesis and homeostasis in Bacteroidetes (Prof. Francesco Renzi); Host-pathogen relationship (Prof. Eric Muraille).
Prof. De Bolle’s research group is interested in pathogenic bacteria that use hosts as substrates for their proliferation. Over the course of evolution, they have therefore selected molecular


mechanisms that enable them to colonise, feed on and proliferate within host organisms. Some pathogenic bacteria (such as Salmonella or Shigella ) are very well characterised, but some bacteria responsible for global diseases are still poorly understood. This is the case with Brucella, a genus responsible for brucellosis, a major zoonosis affecting many mammals, including domestic animals such as sheep, goats and cows. Two research groups are working on Brucella , and more specifically on Brucella abortus (B. abortus), a species found mainly in infections of cows.
Important discoveries have been made in this context. B. abortus shares many cell cycle regulators with C. crescentus and other alpha-proteobacteria. B. abortus cells are asymmetric, with the two poles (new pole and old pole) able to recruit different proteins. When B. abortus enters a host cell in a simplified model of infection, one stage of the bacterial cell cycle (G1) is favored for internalisation, and the bacteria can remain in a non-growing, non-replicating state for several hours. During intracellular trafficking, B. abortus undergoes starvation, acid shock and alkylation stress. The outer membrane of B. abortus contains beta-barrel proteins that are covalently attached to the peptidoglycan by their N-terminal extension. The B. abortus envelope (comprising lipopolysaccharide, peptidoglycan and at least two outer membrane proteins) extends across the new pole and into the site of division. Finally, the lipopolysaccharide is decorated with an O chain (or O antigen) by a bifunctional O-antigen ligase in the periplasm and exported to the outer membrane and the new pole or division site by localised Lpt proteins (LptB2CFG) at these specific sites.


The current research of Prof. De Bolle’s group uses an integrated approach, studying the basic molecular biology of the Brucella abortus pathogen, including envelope structure, biosynthesis and its regulation during polar growth, but also aggression, feeding and starvation in culture and inside host cells.
To carry out some of its work, Prof. De Bolle’s research group uses a state-of-the-art research infrastructure: the Biosafety Laboratory Technology Platform at Level 3 (BL3). The BL3 is equipped with a fluorescence microscope that can be used to visualise the location of certain proteins (such as enzymes) inside a bacterium, for example when the bacteria themselves are inside host cells. Two pathogens are studied there: SARS-CoV2 (research carried out by the URVI and URPhyM, UNamur) and two Brucella species: B. melitensis and B. abortus. What is more, URBM researchers have the capacity to infect cells in culture to study the intracellular behavior of B. abortus inside human or animal cells. They also use mice to test potential vaccine strains and to develop a rational design of new vaccinal strains using a genetic approach.
Prof. De Bolle’s group is currently focusing on the main component of the outermost layer of the B. abortus envelope: lipopolysaccharide, or LPS. LPS is a complex molecule, with a lipid part and a polysaccharide part. We still don’t know which enzymes catalyse which stages in the biosynthesis of the longest polysaccharidic part, called the O chain. Not only is LPS of interest for understanding the fundamental biology of all bacteria, but it is also a key molecule in the interaction with the host infected by a pathogen, which is of interest from the point of view of vaccines. These are fundamental and applied research questions that benefit from numerous collaborations with groups in the USA (Wisconsin, Virginia and North Carolina), France (Lyon), Spain (Madrid and Pamplona) and Singapore.
For Prof. De Bolle, the main challenge is to enable researchers, after their time in a basic research laboratory, to move on to applied research in synthetic microbiology: just as enzymes naturally produce different molecular conformations, genetic engineers could use their talents to create complex molecules for vaccines or therapeutics (e.g. complex polysaccharides or
precursors for the manufacture of drugs). In the longer term, establishing a base of expertise in synthetic microbiology will open up new fields of investigation, such as the production of compounds that can be used for energy purposes (green hydrogen, for example). New materials could also be developed in this context. Even if we look 20 or 30 years ahead, these are exciting challenges for researchers in synthetic microbiology and for engineers keen to make the most of promising applied research. Let’s hear it...


Unité de recherche en biologie des micro-organismes –
URBM
Namur Research Institute for Life Sciences (Narilis) – Unamur Rue de Bruxelles, 61 B-5000 Namur
Tel.: +32 (0)81 72 44 38
Email : xavier.debolle@unamur.be www.urbm.be

Could you remind us of Wagralim’s key figures and strategy?
The Walloon agri-food competitiveness cluster Wagralim has 302 members, 85 projects approved by the Walloon Government, 259 products, services or processes and 21 patent applications. The cluster’s strategy is based on innovation and the construction of a strong collaborative network serving a majority of SMEs and a few big companies in the sector. Wagralim aims to support them in their development and transition. The challenge is to adopt a global vision of innovation: products, processes, raw materials, packaging... All these parameters will undergo major upheaval over the next 5 years. To have an impact and be relevant, we need to promote innovation that encompasses science, technology, sales, distribution, and even the way SMEs work with their partners, suppliers and customers.
What are the salient features of the agri-food industry in Wallonia?
In 2024 the Walloon agri-food market accounted for more than €10.5 billion in sales, including €6,47 billion in exports and €4,32 billion in imports, more than €499 million in investment, 25,906 direct jobs (or 20,960 full-time equivalents) and 1,615 employers. It’s a very open market: its players think far beyond the region’s borders. It’s also a sector that looks into the future. Wagralim and other players of the agri-food system in Wallonia have drawn up a strategic roadmap for the Walloon food system up to 2035 https://www.wagralim.be/a-propos/. Within this framework, 4 pillars have been highlighted. The first aims to support and strengthen our emblematic food sectors. The second one consists in preparing SMEs for the challenges of tomorrow, while the third is to accompany the transition to a new balance regarding proteins and rethink the sectors of tomorrow. Finally, the last pillar focuses on boosting technologies for food innovation. Don’t hesitate to scan our qrcode for more information on the roadmap!

efficiency of production https://www.wagralim.be/apropos/processes: that’s how an SME will judge the added value of an innovation and be inclined to adopt it. We are also working to make water use more circular. With this in mind, we are setting up studies that will enable us to establish the state of the art and propose concrete solutions for reducing the sector’s water footprint. For example, wastewater can be used as a source of energy or to irrigate crops. Similarly, Wagralim is very interested in recycling side streams into high added-value products with a high environmental value.
Could you give us a few examples of projects approved by the cluster?
Let’s focus on a brand new project : ABC to Food. The aim of the “ABC to Food” project is to develop outlets for 8 crops of interest that form part of a long and varied crop rotation providing ecosystem services to farms and, by extension, to the environment. To achieve this, the industrial partners Bionat, Copains, Puratos and Meurens Natural have committed to developing recipes based on these raw materials, the research centers to conducting agronomic trials in regenerative agriculture, the laboratories to supporting the research by characterizing the raw materials, and Farm for Good to testing large-scale feasibility in real time on the network’s farms. At the end of the 4-year project, distinctive food products derived from regenerative agriculture will be marketed, while impact measurement tools will demonstrate the relevance of the approach from an ecological point of view. The “ABC to Food” project aims to demonstrate that it is possible to relocate the supply of large industrial volumes produced according to ecologically responsible farming practices. The initiative encompasses research, product development and farm economics, focusing on innovation at every stage of the food chain.
What is the general objective behind all the projects awarded the Wagralim label?
Energy efficiency is a constant concern. It is no longer acceptable for a company to generate too much waste or emit too much CO2. digitisation and artificial intelligence need to be harnessed to improve the control and

Could you give us a few examples of companies recently supported by Wagralim in their innovation projects?
As part of the Delicen’s project, several companies were involved in improving the nutritional quality of the food offered to elderly people living in retirement homes: Copains (a bread manufacturer), Pasta della Mamma (a pasta manufacturer), Detry (a charcuterie and meat producer) and


Materne (which makes compote and jam). Several criteria specific to this age group had to be taken into account, including protein requirements and the need to make food attractive and easy to chew and swallow. Another project, Microbiostress, brings together three companies (Botalys, Lacto Research and Ortis laboratoires) alongside three Walloon universities (ULiege, UCLouvain, UMons). It stands out for its innovative approach to stress through the development of nutritional ingredients. The aim is to develop a natural, effective and safe-to-use solution, an innovative formulation based on solid scientific research that will combine ingredients targeting the mechanisms involved in the development of disabling symptoms generated by the stress factor. As these symptoms affect both young and old, the product developed will be suitable for a very wide range of people!
What European projects are you involved in?

The cluster is actively engaged in several European partnerships, such as European S3 community, CBE JU, EIT Food, FutureFoodS, European Bioeconomy Clusters Alliance, and others. These involvements have helped Wagralim gain valuable knowledge and experience on the European stage, which have contributed to the regional S3 strategies. As a result, Wagralim coordinated the Regional strategic innovation domain n°5 Agri-food chains of the future and innovative management of the environment with 6 Innovation initiatives under. Additionally, Wagralim has developed a roadmap outlining the regional Food System vision by 2035. In summary Wagralim is :
(1) leading a European S3 Partnership to develop innovative ingredients for the agri-food sector and valorising agri-food side streams for cross-sector applications while promoting circularity;
(2) part of the European partnership on food packaging;
Since 2018, Wagralim has strengthened its position on the European scene to create a meaningful impact in Wallonia. The strategy operates on two levels:
(1) the cluster itself responding to specific EU calls in order to bring knowledge and direct funding to research/economic actors in Wallonia and (2) catalysing the presence of Walloon research/economic actors on the EU scene by integrating them directly in the targeted calls.

(3) part of the European partnership on the digitisation of the agri-food system;
(4) part of the European partnership on food as a vector for health;
(5) part of the European Bioeconomy Clusters Alliance;
(6) member of CBE BIC JU;
(7) member of EIT Food;
(8) contributes to the FutureFoodS partnership; 9) etc.
The cluster is currently involved in 8 European projects, either as the main coordinator or as a partner. With this European development strategy, Wagralim covers essential cross-functional themes for the agri-food sector, making the cluster a key Walloon player in innovation.
What do you see as the main challenges facing the Walloon agri-food industry?
The main challenges for our sector are to create greater added value, resilience, and robustness in a sustainable manner while operating in an open economy. Innovation is essential throughout the entire value chain. We must prepare for climate deregulation by developing new value chains and reducing or replacing inputs in primary production. In industry and food processing, we need to implement solutions to minimize energy and water use, reduce waste and CO2 emissions, and enhance circularity. Addressing both priorities - fostering greater naturality and harnessing advanced technologies such as digitalization and biotechnologies - is crucial for sustainable progress. Of course, all improvements must be developed while ensuring quality, excellent taste, and high nutritional value.
With nearly 200 members, some twenty scientific publications, 600 requests from project leaders and some twenty projects monitored, Valbiom is actively contributing to the development of biomass production and processing sectors for non-food applications in Wallonia.

Valbiom’s mission is to valorise the biomass and its co-products and by-products for a more local and resilient economy. Specialised for 20 years in biosourced economy at the service of territories, municipalities, services of the Walloon Region, project promoters and industrialists, Valbiom combines scientific, technical and economic skills to guarantee a tailor-made response and a professional quality of service. It is responsible for innovative sector strategies integrated with global issues, prospecting and project support. For example, Valbiom can advise a territory on the merits of developing a biomethane production chain. Valbiom is also very active in training, information, awareness raising, technical monitoring and networking. This is evidenced by the 20 or so events per year (thematic conferences, field visits, including the tour of the biosourced economy and biomethanisation) and the 50 requests to speak as an expert at conferences and debates.
Approved for many years by the Walloon Region as a consultancy for UREBA and AMURE grants, Valbiom offers services to define a strategy, the elaboration of master plans and methods to reduce the energy and climate impact of a company, a district, a municipality or a city (POLLEC). A complete service is offered for the implementation of bioenergy solutions: diagnosis, territorial study, animation of local actors’ networks, elaboration of a master plan, supply plan, elaboration of a spreading plan, agronomic advice, technical and economic feasibility study, environmental assessment of a project (carbon assessment, life cycle analysis), administrative support, assistance to the financial set-up and communication plan are combined so that the project owner puts all the chances on his side.
At present, Valbiom is involved in many projects of the Walloon Recovery Plan, which concern in particular the development of

the extraction of molecules of interest from plant materials (wood bark, hemp inflorescence, etc.), the wool industry, oleochemistry or the development of the biogas production industry. Special mention to the European project Hemp4Circularity (Interreg NWE): it aims to implement an innovative, local and biobased ecological fibre - long hemp fibre - in the textile value chain of North West Europe, from growers to weavers/knitters, from field to designers, and recycling. It is implementing pilot actions at several stages of the value chain (cultivation, primary processing, data-driven agriculture, spinning, fabric production) to optimize all stages of sustainable production, from field to recycled fibre. In doing so, hemp becomes a driver of circularity in the textile industry.
Valbiom is well placed to know that the biobased economy allows the relocation of production and transformation channels since biomass grows everywhere and offers interesting alternatives such as wood wool or hemp for insulation. Moreover, the biobased economy is less energy intensive and facilitates CO2 capture. Its future is all the more promising as Wallonia benefits from all the necessary expertise: a long agricultural and forestry tradition, important research and training centres... not to mention the entrepreneurial spirit. A dynamic that Valbiom intends to support and stimulate.

Valbiom
Chaussée de Namur, 43 B-5030 Gembloux
Tel.: +32 (0)81 84 58 87
Email : info@valbiom.be
https://www.valbiom.be/


















